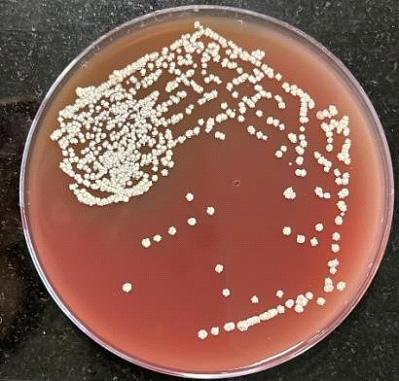

Congenital Hypothyroidism : Need for National Health Policy
Congenital Hypothyroidism (CH) is caused due to insufficient production of thyroid hormone at birth1. It is one of the most common treatable causes of mental and growth retardation2. Neurodevelopmental outcome is normal if CH is diagnosed and managed within two weeks of birth. If left untreated, it may cause lifelong suffering as a result of mental retardation and growth deficiency. Clinical presentation of CH is usually subtle and most newborns with CH appear normal at birth because some amount of thyroid hormone is transferred from mother to baby during pregnancy. Maternal thyroid hormone provides protective effect and masks clinical features of CH in newborns. Common forms of CH also have some functioning residual thyroid tissue, making it more difficult to diagnose at birth. Within few weeks of birth, clinical signs and symptoms of CH become evident due to deficiency of thyroid hormone production. Delay in diagnosis and management of CH causes permanent neurologic damage3. There is an inverse relationship between age at clinical diagnosis of CH and Intelligent Quotient (IQ) score4,5.
Newborn screening for CH is the most feasible and cost-effective way to detect CH at birth and to begin treatment immediately. It is one of the cornerstones of preventive medicine having proven benefits. Introduction of universal newborn screeninghas eliminated CH as a cause of mental retardation in developed nations6 However, it remains a problem in developing nations such as India where universal screening programs for detecting CH in newborns are not routinely implemented2
Epidemiology :
Globally, incidence of CH usually varies between 1 in 3000 to 1 in 4000 live births. Females are more likely to have CH than males. Infants with Down Syndrome are at increased risk of being born with CH3. Incidence rates vary due to differences in geography and ethnicity, iodine deficiency or type of screening methods used2. In India, the first newborn screening for CH was conducted in 1982 using cord blood Thyroid Stimulating Hormone (TSH) and then in 1984 using postnatal dried blood spot (DBS) T4. Prevalence was 1:2481 and 1:2804 respectively7. Studies also showed state-wise incidence to be 1:1985, 2.1:1000, 1.6:1000, 1:1700, and 1:1221in Hyderabad, Kochi, Chennai, Andhra Pradesh, and Uttar Pradesh, respectively8
Vol 120, No 12, December 2022Journal of the Indian Medical Association 12
Recent assessment by ICMR revealed a much higher incidence of congenital hypothyroidism all over India at 1 in 1172, particularly in south Indian population (1 in 727)9
Etiology :
CH may be primary due to thyroid gland dysfunction or secondary due to pituitary gland dysfunction. In primary hypothyroidism, there is deficiency of thyroid hormone at birth caused by abnormal thyroid gland development (thyroid dysgenesis) or disorder of thyroid hormone synthesis (thyroid dyshormonogenesis)1
Thyroid dysgenesis accounts for 85% of cases while thyroid dyshormonogenesis accounts for 15% of cases3. Secondary or central hypothyroidism at birth results from deficiency of thyroid stimulating hormone. It is usually associated with congenital hypopituitarism1,3
CH is further classified into permanent and transient CH. In permanent CH, there is permanent deficiency of thyroid hormone which requires life-long management. On the other hand, transient CH is characterized by temporary deficiency of thyroid hormone at birth, which slowly resolves with time1.
Clinical Features :
CH goes undetected in many newborns because clinical features are not apparent at birth. Symptoms appear slowly and are often non-specific. This indicates the importance of universal newborn screening programs to ensure diagnosis and prompt management. Presence of goiter, prolonged jaundice, birth weight more than 90 th percentile, delayed development, poor growth, poor feeding, hypothermia, bradycardia, large fontanelles, macroglossia and umbilical hernia are some symptoms of CH1,3,6
CH is associated with an increased risk of other congenital abnormalities or malformations, the commonest being cardiac defects. Other abnormalities may include hearing loss, genitourinary anomalies, interstitial lung disease, cleft palate, bifid epiglottis, spiky hair, neonatal diabetes, congenital glaucoma, and liver and kidney disorders6
Diagnosis : Universal Newborn Screening
Universal newborn screening is the most effective
method for detecting CH at birth. This is followed in most of the developing world, which has helped reduce incidence of CH in these countries. In absence of newborn screening, diagnosis is delayed which causes poor prognosis. Complete diagnostic evaluation should include detection of CH by newborn screening, confirmation by repeat thyroid function test, and determination of underlying etiology by diagnostic studies1,2
Newborn screening is usually carried out between two and five days of life, before discharge from hospital. Specimens collected before 48 hours of life may give false positive results. On the other hand, screening very sick newborns or screening after blood transfusion may give false negative results. Blood sample from heel prick or cord blood sample is collected on filter paper and sent to central laboratory for initial TSH or initial T4 test, with a follow-up TSH test3,6
Diagnostic Criteria :
According to the Indian Society for Pediatric and Adolescent Endocrinology (ISPAE)10,
Every newborn should be screened using heel prick method ideally within 48 to 72 hours of birth.
Newborns with TSH < 20 mIU/L for >48hours of birth or TSH <34 for sample taken between 24-48 hours of birth should be treated as normal.
Newborns with TSH > 20 mIU/L at > 48 hours of birth or TSH >34 mIU/L for samples taken between 24 to 48 hours of age should be recalled for confirmation within 1 week (by 7-10 days of life).
For screen TSH > 40 mIU/L, immediate recall for confirmatory venous T4/FT4 and TSH, and for milder elevation of screen TSH, a second screening TSH at 7 to 10 days of age, should be taken.
Sick babies should be screened at least by 7 days of age.
Management :
According to Indian Academy of Pediatrics (IAP) standard treatment guideline 202211,
As soon as diagnosis is made, treatment with levothyroxine should be started within first 2 weeks of life. Initial thyroxine dose is 10–15 μg/kg/day. Treatment is recommended for newborns with FT4 < 1.17 ng/dl or T4 < 10 μg/dl with the same dose.
Vol 120, No 12, December 2022Journal of the Indian Medical Association 13
Newborns with high TSH > 20 at less than 2 weeks and TSH >10 at more than 2 weeks are to be treated.
Newborns with low FT4 (1.1 ng/dl) or T4 (<8 μg/dl) with normal TSH and those with normal FT4/T4 with high TSH (>10 beyond 3 weeks) are to be treated. A single morning dose at the same time is to be taken every day on empty stomach by crushing with a spoon and mixing with few ml of breast milk.
Prognosis :
Timely diagnosis and management are essential for preventing long-term adverse outcomes due to CH. Universal newborn screening, along with repeated screening of high-risk infants, and diagnostic tests are required for appropriate diagnosis and management. Treatment with levothyroxine should be started within first two weeks of life to ensure normal thyroid function. Prognosis is excellent for newborns with CH when properly managed6
Conclusion :
Newborn screening program for CH must be established at national level in India in order to reduce morbidity by preventing mental retardation and physical disabilities. CH is easy to detect, and inexpensive to treat. Newborn screening programs should be aimed at detecting all cases as early as possible, with an acceptable cost-benefit ratio.
REFERENCES
1Rastogi MV, LaFranchi SH — Congenital hypothyroidism. Orphanet J Rare Dis 2010; 5: 17. doi: 10.1186/1750-1172-517. PMID: 20537182; PMCID: PMC2903524.
2Dayal D, Prasad R — Congenital hypothyroidism: current perspectives. Research and Reports in Endocrine Disorders 2015; 91. 10.2147/RRED.S56402.
3Agrawal P, Philip R, Saran S, Gutch M, Razi MS, Agroiya P, Gupta K. Congenital hypothyroidism. Indian J Endocrinol Metab 2015; 19(2): 221-7. doi: 10.4103/2230-8210.131748. PMID: 25729683; PMCID: PMC4319261.
4Klein AH, Meltzer S, Kenny FM — Improved prognosis in congenital hypothyroidism treated before age three months. J Pediatr 1972; 81(5): 912-5. doi: 10.1016/s00223476(72)80542-0. PMID: 5086719.
5Saran S — Congenital Hypothyroidism. Thyroid Disorders: Intech Open; 2019.doi: 10.5772/intechopen.81129.
6Wassner AJ — Congenital Hypothyroidism. Clin Perinatol 2018; 45(1): 1-18. doi: 10.1016/j.clp.2017.10.004. PMID: 29405999.
7Desai MP, Sharma R, Riaz I, Sudhanshu S, Parikh R, Bhatia V — Newborn Screening Guidelines for Congenital Hypothyroidism in India: Recommendations of the Indian Society for Pediatric and Adolescent Endocrinology (ISPAE)Part I: Screening and Confirmation of Diagnosis. Indian J Pediatr 2018; 85(6): 440-7. doi: 10.1007/s12098-017-2575y. Epub 2018 Jan 30. PMID: 29380252.
8Rama Devi AR, Naushad SM — Newborn screening in India. Indian J Pediatr 2004; 71: 157-60.
9ICMR Releases Results of Study on Congenital Hypothyroidism — Chennai Online News. Mht. 2013. Mar 15, [Last accessed on 2022 Sept 20]. Available from: http:// www.news.chennaionline.com/chennai/ICMRreleasesresults-of-study-on-Congenital-Hypothyroidism/ 58cca920-765d-492b-8fd3-9b34a8ac2351.col
10Léger J, Olivieri A, Donaldson M, Torresani T, Krude H, van Vliet G, etal—ESPE-PES-SLEP-JSPE-APEG-APPES-ISPAE; Congenital Hypothyroidism Consensus Conference Group. European Society for Paediatric Endocrinology consensus guidelines on screening, diagnosis, and management of congenital hypothyroidism. Horm Res Paediatr 2014; 81(2): 80-103. doi: 10.1159/000358198. Epub 2014 Jan 21. PMID: 24662106.
11Indian Academy of Pediatrics (IAP) — Standard Treatment Guidelines 2022. Congenital Hypothyroidism. Available from: https://iapindia.org/pdf/Ch-012-Hypothyroidism.pdf. Last accessed on December 02, 2022.
MBBS, MD, DM, FRCP, FACE, FICP, Sujoy Ghosh Professor, Department of Endocrinology, IPGME&R and SSKM Hospital, Kolkata 700020 and Hony. Editor, JIMA
Vol 120, No 12, December 2022Journal of the Indian Medical Association 14
Original Article
Association of Dietary Protein on Level of Anti Mullerian Hormone (AMH) and Antral Follicle Count (AFC) in Patients of Infertility
Poonam Singh1, Radhika Anand2
Background : “Infertility is defined as the inability to conceive within a year with normal frequency of sexual intercourse and no contraceptives.” Relatively little is known about the effect of nutritional content on fertility.
Objective : To study the correlation of level of AMH and AFC with dietary habits especially protein intake in patients of infertility.
Material and Methods : It is hospital based study.
Design of study : Cross sectional study.
Place of study : Teerthankar Mahaveer Medical College & Research Centre, Moradabad, India .
Number of Patients : 95 patients of infertility included in the study .Patients were between 30 and 45 years.
Time Period : 18 months from January 2020-July 2021.
Method : All cases underwent full history taking; clinical examination and all completed a questionnaire consisting of demographic characteristics, FFQ (Food Frequency Questionnaire).
Main Outcome Measures : Moderate to high protein intake in diet corresponds to those having met their more than 20% calorie intake by protein had a higher mean AMH as well as had a higher mean AFC.
Result : Based on the results of the current study the effects of higher protein intake was found to be significant on the level of ovarian reserve .
Conclusion : This study suggests that good and healthy Nutrition, rich in proteins , in fertility treatment is required for better outcome and also helps in limiting the financial burden.
[J Indian Med Assoc 2022; 120(12): 15-9]
Key words :Antral Follicle Count, Anti Mullerian Hormone, In Vitro Fertilization, Body Mass Index
On a global basis, roughly 15% of eligible couples experience infertility, which translates to about 60-80 million couples2. Infertility rates may differ by area3. According to the World Health Organization (WHO), prevalence of primary infertility in India ranges between 3.9 percent to16.8 percent. Lifestyle, diet, sexual health, substance abuse and psychosocial factors all have an impact not only on the outcome of fertility treatment but also on pregnancy health, which is essential in pre-conception care4-6 While it is well accepted that diet and modifiable lifestyle variables affect female 7-11 as well as male fertility 12-14 , knowledge in this area is sparse, which make planning of pregnancy limited with few evidence-based resources to aid with pre-conceptional nutrition and lifestyle advice. Relatively little is known about the effect of nutritional content on fertility .
The Antral Follicle Count (AFC) and serum Anti
Faculty of Medicine, Teerthankar Mahaveer University, UP 244001
1MBBS, MD (Obstat & Gynaecol), IVF Fellowship, fellowship in Laproscopy, FICMCH, FCGP, Professor, Department of Obstaetrics & Gynaecology, IVF Division and Corresponding Author
2MBBS, MS (Obstat & Gynaecol), Departmnt of Obstaetrics and Gynaecology
Received on : 11/11/2022
Accepted on : 12/11/2022
Editor's Comment :
Females with poor health due to unhealthy and unbalanced diet have poor fertility as is seen in many infertile ladies. A good and healthy Nutrition, rich in proteins is required for better fertility and also helps in limiting the financial burden.
Mullerian Hormone (AMH) are the most relevant indicators of ovarian reserve16 AMH and AFC have shown to be more accurate predictors of the number of ovarian primordial follicles
Although it is widely assumed that lifestyle variables have a detrimental influence on ovarian reserve and AMH levels17-20, not all research agree19 and the majority of studies do not examine the response of other contributing factors.
The purpose of this study is to examine the probable influence of dietary factors (proteins) in determining the level of both the mentioned markers of ovarian reserve in infertile patients.
As limited number of studies are available in India of regarding impact of dietary and lifestyle factors in patients of infertility. Therefore, this study would aim at studying the correlation of level of AMH and AMC with dietary habits.
Aims :
To Study the association of dietary proteins on level
Vol 120, No 12, December 2022Journal of the Indian Medical Association
15
of Anti Mullerian Hormone (AMH) and Antral Follicle Count (AFC) in patients of infertility.
Review of Litrature :
(Rich-Edwards JW, et al)28 Unbalanced meals high in carbs, fat, proteins constituents and other micronutrients negatively influence ovulation (Chavarro JE, et al)29 in their study “Diet and lifestyle in the prevention of ovulatory disorder infertility” concluded that in an otherwise healthy women, following a “fertility diet” plan may help them conceive.
(Chavarro JE, et al)29 , researchers at Harvard Medical School, found that carbohydrates influences ovulation and fertility in healthy women because it affects the metabolism of glucose and demand of insulin and its sensitivity (PCOD).
(Hohos NM, et al)32 stated that diet with high fat has ill effect on female fertility, having possible impacts ovulation. Similar findings were seen in a research done by (KaboodMehri R, et al) 33 studied the correlation between Anti Müllerian Hormone (AMH) levels and food consumption in Iranian females. Additionally, some have discovered diet rich in fat exacerbates atresia of follicles34,35
MATERIALS AND METHODS
Study Design : A cross sectional study
Study Setting : The Department of Obstetrics and Gynaecology, Teerthanker Mahaveer Medical College & Research Centre.
Study Population : Women attending the Department of Obstetrics and Gynaecology with Diagnosis of Primary or Secondary Infertility.
Study Duration : 18 Months
Sample Size : 95
To calculate sample size based on the prevalence we can use the following formula : Sample Size = (Z2 PQ)/ E2
Z = Standard Normal Variate
P = Prevalence of infertility
E = absolute error (5-10%) acceptable
Q= (100-P)
Z =2.58 at 1% type 1 error
Here
Z2 = 2.58 at 1% type 1 error
P=3.7%
E=5%
n = [(2.58)2 X 3.7X (100-3.7)]/ (52) =94.86 =95
Inclusion Criteria :
•Women attending the Department of Obstetrics and Gynaecology with diagnosis of primary or secondary infertility.
•Women between ages of 30-45 years, married
for at least 1 year and sexually active.
•Patients with both ovaries intact
•Patients ready to give consent to participate in the study
Exclusion Criteria :
•Patients <30 years and >45 years
•Patients with immune infertility
•Patients with male factors of infertility
•Patients with sexually transmitted infection
•Traumatic or congenital malformation in the genital systems.
•Endometrial cause of infertility
•Patients of primary amenorrhea
23040 number of patients attended the Gynaecology OPD during the duration of 18 months, 691 number of patients were patients of primary or secondary infertility anxious to concieve out of which 389 belonged to the age group of 30-45 years. After applying inclusion and exclusion criteria, we enrolled 95 patients in our study. All the participants were assesed on the basis of the prevalidated questionnaire to assess their protein intake .
Calculation of Antral Follicle Counts Using Ultrasound Techniques :
Each participant in the study underwent a standard infertility evaluation, that included determination of the AFC using the Siemens ACCUSON S2000 ultrasound machine on third day of an unstimulated menstruation or on third day of bleeding after progesterone withdrawal. One examiner performed all transvaginal ultrasounds. AFC was done on 1st visit of each patient in OPD, before starting any treatment so as to avoid any bias.
AMH Assessment :
A sample for AMH obtained for all subjects under aseptic precaution on the 1st visit of patient to OPD. The sample sent to Biochemistry Department.
AMH values differentiated according the normal value depending upon age group41
Value of Normal Range of AMH According to Age Groups
Ageng/ml pmol/L
Under 33 years old 2.1-6.815.0-48
33-37 years old 1.7-3.5 12.14-32.13
38-40 years old 1.1-3.0 7.8-21.42
41 + years old 0.5-2.53. 57-17.85
Statistical analysis : Data so collected was tabulated in an excel sheet, under the guidance of statistician. The means and standard deviations of the measurements per group were used for statistical
Vol 120, No 12, December 2022Journal of the
Indian Medical Association
16
analysis (SPSS 22.00 for windows; SPSS inc, Chicago, USA). For each assessment point, data were statistically analyzed using one way ANOVA. Difference between two groups was determined using student t-test and the level of significance was set at p<0.05.
OBSERVATION AND RESULTS
Table 1 — Co-relation of Age to AMH AgeGroup
Frequ- Percent MeanSTDFp ency
Deviationvaluevalue
Under 336366.34.661.11 37-4022.1 1.531.404.93 0.021* 33-3721 22.14.251.18 >4199.51.431.41
Table 2 — Co-relation of AFC to Age AgeGroup
Frequ- Percent MeanSTDFp ency Deviationvaluevalue
Under 336366.34.441.75 37-4022.1 2.500.713.08 0.042* 33-3721 22.14.331.76 >4099.54.781.59
The subject were classified according to their age corrected AMH groups.We found that a total of 31 subjects that amounts to about 32.6% had low AMH values while 24.3% had high AMH values while the rest 41% which was the majority belonged to the nomal range of AMH (Table 3).

We found that a total of 27 subjects that amounts to about 28.4% had low AFC values while 13% had high AFC values ie >10 while the rest 55% which was the majority belonged to the normal range of AFC ie 38 in each ovary (Table 4).

The majority of the participants 57.9% preffered mixed diet while 42.1 % prefered vegetarian diet. It was found that the mean AMH was higher in the patients
Table
Table 4 — Level of AFC
AMHFrequency (n)Percent (%)
Low2728.4 Normal55 57.9 High13 13.7
that were vegetarian as compared to the ones who prefered mixed diet but the p value was 0.653 so the relationship was not significant (Table 5).
Majority of the patients 69.5% had moderate protein intake that is about 20-35% of their calorie intake was from the protein. The relationship of moderate to high protein intake in their diet that corresponds to those having met their more than 20% calorie intake by protein had a significant relation with the level of AMH and had a higher mean AMH (Table 6).
Majority of the patients 69.5% had moderate protein intake that is about 20-35% of their calorie intake was from the protein. The relationship of moderate to high protein intake in their diet that corresponds to those having met their more than 20% calorie intake by protein had a significant relation with the level of AFC and had a higher mean AFC.
DISCUSSION
Our study found a strong association between a high ovarian reserve and AMH and AFC in patients on a moderate protein diet, defined as individuals consuming between 20% and 35% of calories from protein. Patients on this diet had a higher ovarian reserve in both AMH and AFC. The link between carbohydrate and fat consumption and ovarian reserve, on the other hand, was determined to be statistically negligible. There have been few studies examining the link between the calorie percentage from various macronutrients and the degree of ovarian research such as AMH and AFC. Souter I, et al1 according to their findings, total protein intake (as a percentage of total calories) was not associated with AFC in 264 women. The researchers identified a negative connection between protein derived from dairy products consumption and Antral follicular count when they looked at protein from other dietary sources
Vol 120, No 12, December 2022Journal of the Indian Medical Association
3 — Level of AMH AMHFrequency (n)Percent (%) Low3132.6 Normal41 43.2 High23 24.2
17
independently of dairy protein consumption. There were no associations found between protein derived from non-dairy diet or protein derived to vegetable components and AFC in the research.



CONCLUSION
•Based on the results of the current study the effects higher protein intake was found to be significant on the level of ovarian reserve.
• This study suggests that inculcation of Nutrition and lifestyle modification Counseling into fertility treatment is required for better outcome and also help in limiting the financial burden.
Limitations of the study included : Data acquired was self-reported via questionnaires administered to research participants for many lifestyle variables. For example, it is widely established that participants tend to underreport non-socially desirable activities such as alcohol consumption and smoking, which may result in some persons being misclassified.

Additionally, the very small sample size, in particular, may create some statistical power issues. This may be represented in the fact that some of the results are statistically insignificant, while others indicate substantial and steady trends.
Funding : SPARSH IVF.
Contributions : PS contributed to the design and
drafting of the manuscript. PS contributed to the formal analysis, statistical analysis and editing of the manuscript. RA contributed to the methodology and experimental test. The authors have read and approved the final manuscript.
Conflicts of Interest : There is no conflict of interests
Vol 120, No 12, December 2022Journal of the
Medical Association
Indian
Table 5 — Relationship of protein intake and level of AMH
Table 6 — Relationship of dietary intake and level of AFC
Relationship of Protein Intake and Level of AMH
18
Relationship Protein Intake and Level of AMH
REFERENCES
1Souter I, Chiu YH, Batsis M, Afeiche MC, Williams PL, Hauser R, et al — The association of protein intake (amount and type) with ovarian antral follicle counts among infertile women: results from the EARTH prospective study cohort. BJOG: An International Journal of Obstetrics and Gynaecology 2017; 124(10): 1547-55.
2Kupka MS, Ferraretti AP, De Mouzon J, Erb K, D’Hooghe T, Castilla JA, et al — Assisted reproductive technology in Europe, 2010: results generated from European registers by ESHRE. Human reproduction 2014; 29(10): 2099-113.
3Adamson PC, Krupp K, Freeman AH, Klausner JD, Reingold AL, Madhivanan P — Prevalence & correlates of primary infertility among young women in Mysore, India. The Indian Journal of Medical Research 2011; 134(4): 440.
4Luke B, Brown MB, Stern JE, Missmer SA, Fujimoto VY, Leach R — Female obesity adversely affects assisted reproductive technology (ART) pregnancy and live birth rates. Human reproduction (Oxford, England) 2011; 26(1): 245-52.
5Matalliotakis I, Cakmak H, Sakkas D, Mahutte N, Koumantakis G, Arici A — Impact of body mass index on IVF and ICSI outcome: a retrospective study. Reproductive biomedicine online 2008; 16(6): 778-83.
6Bellver J, Ayllon Y, Ferrando M, Melo M, Goyri E, Pellicer A, et al — Female obesity impairs in vitro fertilization outcome without affecting embryo quality. Fertility and Sterility 2010; 93(2): 447-54.
7Missmer SA, Chavarro JE, Malspeis S, Bertone-Johnson ER, Hornstein MD, Spiegelman D, et al — A prospective study of dietary fat consumption and endometriosis risk. Human Reproduction (Oxford, England) 2010; 25(6): 1528.
8Chavarro JE, Rich-Edwards JW, Rosner BA, Willett WC — A prospective study of dietary carbohydrate quantity and quality in relation to risk of ovulatory infertility. European Journal of Clinical Nutrition 2009; 63(1): 78-86.
9Chavarro JE, Rich-Edwards JW, Rosner BA, Willett WC — Protein intake and ovulatory infertility. American Journal of Obstetrics and Gynecology 2008; 198(2).
10Chavarro JE, Rich-Edwards JW, Rosner BA, Willett WC — Dietary fatty acid intakes and the risk of ovulatory infertility. American Journal of Clinical Nutrition 2007; 85(1).
11Chavarro JE, Rich-Edwards JW, Rosner B, Willett WC — A prospective study of dairy foods intake and anovulatory infertility. Humanreproduction(Oxford,England) 2007; 22(5): 1340-7.
12Attaman JA, Toth TL, Furtado J, Campos H, Hauser R, Chavarro JE — Dietary fat and semen quality among men attending a fertility clinic. Human reproduction (Oxford, England) 2012; 27(5): 1466-74.
13Afeiche M, Williams PL, Mendiola J, Gaskins AJ, Jørgensen N, Swan SH, et al — Dairy food intake in relation to semen quality and reproductive hormone levels among physically active young men. Human Reproduction (Oxford, England) 2013; 28(8): 2265.
14Afeiche MC, Bridges ND, Williams PL, Gaskins AJ, Tanrikut C, Petrozza JC, et al — Dairy intake and semen quality among men attending a fertility clinic. Fertility and Sterility 2014; 101(5).
15Dunlop AL, Jack BW, Bottalico JN, Lu MC, James A, Shellhaas CS, et al — The clinical content of preconception care: women with chronic medical conditions. American Journal of Obstetrics and Gynecology 2008; 199(6): S310-27.
16Testing and interpreting measures of ovarian reserve: a committee opinion. Fertility and Sterility 2015; 103(3): e9-17.
17Shaw CM, Stanczyk FZ, Egleston BL, Kahle LL, Spittle CS,
Godwin AK, et al — Serum antimullerian hormone in healthy premenopausal women. Fertility and Sterility 2011; 95(8): 2718.
18Plante BJ, Cooper GS, Baird DD, Steiner AZ — The impact of smoking on antimullerian hormone levels in women aged 38 to 50 years. Menopause (New York, NY) 2010; 17(3): 571-6.
19Schuh-Huerta SM, Johnson NA, Rosen MP, Sternfeld B, Cedars MI, Reijo Pera RA — Genetic markers of ovarian follicle number and menopause in women of multiple ethnicities. Human Genetics 2012; 131(11): 1709.
20la Marca A, Spada E, Grisendi V, Argento C, Papaleo E, Milani S, et al — Normal serum anti-Mullerian hormone levels in the general female population and the relationship with reproductive history. European Journal of Obstetrics, Gynecology and Reproductive Biology 2012; 163(2): 180-4.
21Hansen KR, Hodnett GM, Knowlton N, Craig LB — Correlation of ovarian reserve tests with histologically determined primordial follicle number. Fertility and Sterility 2011; 95(1).
22ESHRE Task Force on Ethics and Law, including, Dondorp W, De Wert G, Pennings G, Shenfield F, Devroey P, Tarlatzis B, Barri P. Lifestyle-related factors and access to medically assisted reproduction. Human Reproduction 2010; 25(3): 578-83.
23Hammarberg K, Setter T, Norman RJ, Holden CA, Michelmore J, Johnson L — Knowledge about factors that influence fertility among Australians of reproductive age: A population-based survey. Fertility and Sterility 2013; 99(2).
24Kloss JD, Perlis ML, Zamzow JA, Culnan EJ, Gracia CR — Sleep, sleep disturbance, and fertility in women. Sleep Medicine Reviews 2015; 22: 78-87.
25Hassan MAM, Killick SR — Negative lifestyle is associated with a significant reduction in fecundity. Fertility and Sterility 2004; 81(2).
26Anderson K, Nisenblat V, Norman R — Lifestyle factors in people seeking infertility treatment–a review. Australian and New Zealand Journal of Obstetrics and Gynaecology 2010; 50(1): 8-20.
27Silvestris E, Lovero D, Palmirotta R — Nutrition and female fertility: An interdependent correlation. Published online 2019 Jun 7. doi: 10.3389/fendo.2019.00346
28Rich-Edwards JW, Goldman MB, Willett WC, Hunter DJ, Stampfer MJ, Colditz GA, et al — Adolescent body mass index and infertility caused by ovulatory disorder. American Journal of Obstetrics and Gynecology 1994; 171(1).
29Chavarro JE, Rich-Edwards JW, Rosner BA, Willett WC — Diet and lifestyle in the prevention of ovulatory disorder infertility. Obstetrics and Gynecology 2007; 110(5).
30Moslehi N, Mirmiran P, Azizi F, Tehrani FR — Do dietary intakes influence the rate of decline in anti-Mullerian hormone among eumenorrheic women? A population-based prospective investigation. Nutrition Journal 2019; 18(1).
31Anderson C, Mark Park YM, Stanczyk FZ, Sandler DP, Nichols HB — Dietary factors and serum antimullerian hormone concentrations in late premenopausal women. Fertility and Sterility 2018; 110(6).
32Hohos NM, Skaznik-Wikiel ME — High-fat diet and female fertility. Endocrinology 2017; 158(8): 2407-19.
33KaboodMehri R, Sorouri ZZ, Sharami SH, Bagheri SE, Yazdipaz S, Doaei S — The association between the levels of antiMüllerian hormone (AMH) and dietary intake in Iranian women. 2021; 304(3): 687-94. doi: 10.1007/s00404-021-060984. Epub 2021 May 22.
34Wang N, Luo LL, Xu JJ, Xu MY, Zhang XM, Zhou XL, et al — Obesity accelerates ovarian follicle development and follicle loss in rats. Metabolism: Clinical and Experimental 2014; 63(1).
Vol 120, No 12, December 2022Journal
of the Indian Medical Association
19
Original Article
A Clinical Correlation of EEG Changes in Relation to Ischaemic Stroke on its Prognosis as per Location
Mukherjee1, Paramita Bhattacharya2, Sujoy Sarkar3, Arkadeb Maity1, Mrinal Kanti Roy4, Salil kumar Pal5
Background : Stroke is a common, potentially devastating disease with potential high morbidity and mortality. EEG (Electro-encephalogram), functional representation of electrical activity of brain, changes are closely tied to CBF (Cerebral Blood Flow). Thus EEG is useful to establish the location of Ischaemic CVA (Cerebro-vascular accident). It can also prognosticate Ischaemic stroke.
Aims & Objectives : (1) To assess the grade and severity of clinical manifestations in acute ischaemic stroke patients by clinical scoring following admission. (2) To obtain EEG findings of ischaemic stroke patients following admission and after 1 month. (3) To assess the morbidity of ischaemic stroke patients by Modified Rankin Scale after 1 month. (4) To correlate EEG changes according to the clinical outcome and according to the site of involvement of ischaemic stroke.
Materials and Methods : 90 Patients were selected during the study period as per the inclusion and exclusion criteria. Clinical scoring was done by NIHSS (National Institute of Health Scoring System). CT (Computed Tomography) scan of brain and MRI (Magnetic Resonance Imaging) Brain with DWI (Diffusion Weighted Image) extension was done. EEG findings on admission of morbidity was done by Modified Rankin Score on follow up after 1 month was noted. EEG findings after 1 month was noted on follow up. Assessment Clinical correlation was compared with EEG changes. All the data were collected and analysed by statistical software SPSS version 20.
Results : The mean MRS (Modified Rankin Score) after 1 month for abnormal EEG on admission was 4.50 in comparison to score of 3.36 in case of normal EEG. The p value of this association was 0.003 and was considered significant.
Conclusions : Normal EEG and focal slowing of EEG was mostly noted in MCA (Middle Cerebral Artery) and PCA (Posterior Cerebral Artery) infarcts involving the cortical region. Those with normal EEG findings had good clinical outcome in comparison to those with abnormal findings in EEG.
[J Indian Med Assoc 2022; 120(12): 20-2]
Key words :Stroke, EEG, NIHSS, MRS.
Stroke is a common disease with potential high morbidity and mortality, requiring accurate diagnosis rapidly. EEG, representation of electrical activity of neuronal network of brain, is closely related to changes in Cerebral Blood Flow. Thus EEG is closely related to changes in Cerebral Blood Flow. Thus EEG is important in establishing the site and prognostication of Ischaemic CVA.
AIMS AND OBJECTIVES
Our aims and objectives were grading the severity of clinical manifestations in acute ischaemic stroke patients by clinical scoring and to obtain EEG findings
Department of General Medicine, Calcutta National Medical College and Hospital, Kolkata 700014
1MBBS, Postgraduate Trainee
2 MBBS, DNB (Medicine), Assistant Professor and Corresponding Author
3MBBS, MD, Associate Professor
4MBBS, MD, DM (Neurology), Professor
5MBBS, MD, DM (Endocrinology), Professor
Received on : 09/03/2022
Accepted on : 08/11/2022
Editor's Comment :
CVA is a major cause of mortality and morbidity. EEG is a simple test that can predict the severity of the disease.
It can help in prognostication of the patient and thus help in proper care and rehabilitation of the patient.
following admission. Then to assess the morbidity by Modified Rankin Scale (MRS) and obtain EEG of them after 1 month. Lastly to correlate EEG changes according to the clinical outcome and according to the site of involvement of ischaemic stroke.
MATERIALS AND METHODS
It was an institution based descriptive study done at Medicine Ward at CNMCH, Kolkata for a period of 18 months. 90 haemodynamically stable patients, without existing neurological diseases and metabolic encephalopathy, from the age group of 18-95 years with signs of ischaemic stroke, NIHSS>4 and supportive neuro-imaging were selected. EEG findings of these patients were noted during admission and during follow up after 1 month. During follow up
Vol 120, No 12, December 2022Journal of the Indian Medical Association
Amit
20
morbidity was assessed by MRS. All the data were collected and tabulated. Categorical variables are expressed as Number of patients and percentage of patients and compared across the groups using Pearson’s Chi Square test for Independence of Attributes/ Fisher’s Exact Test as appropriate. Continuous variables are expressed as Mean, Median and Standard Deviation and compared across the groups using Mann Whitney U test/Kruskal Wallis Test as appropriate. The statistical software SPSS version 20 has been used for the analysis. An alpha level of 5% has been taken, ie, if any p value is less than 0.05 it has been considered as significant.
ANALYSIS AND RESULTS
In our study most of the patients were in the age group of 61-70 years (45.6%), followed by the 51-60 years age group. Range of age was 51-85 years. Females were 44.4% and Males were 55.6% of the study-population. MRI of Brain with DWI extension revealed - 63.3%, 14.4%, 4.4% of the cases had MCA territory infarction, Multi-infarct state, ACA territory involvement respectively. On admission, 58.9%, 18.9%, 14.4%, 7.8% of the cases showed Normal EEG, Focal, Diffuse slowing and Multifocal slowing respectively. During follow up at 1 month, 91.8% of the cases showed Normal EEG, Focal and Diffuse slowing was noted in 4.1% cases each. The mean MRS after 1 month for abnormal and normal EEG on admission was 4.30 and 3.68 respectively, p value being 0.024 (significant). Among the abnormal EEG on admission the mean values of MRS were 3.29±0.59 and 5.77±0.44 in cases with focal slowing and diffuse slowing respectively, with p value of <0.001 (significant). The mean values of MRS were 3.36±0.8, 4.0±0, 5.0±0 in cases with normal EEG, focal slowing and diffuse slowing of EEG on follow up, with the p value of 0.006 (significant). In our study all Normal EEG on admission were focal lesions. Among abnormal EEG findings 64.86% and 35.14% were with focal lesions and Multi-infarct state respectively with p value being <0.001 (significant). During follow up all of the normal EEG was of patients with Focal lesions and abnormal EEG findings were equal among focal lesions and multi-infarct state with p value of <0.001 (significant). Our study shows 73.58% and rest of normal EEG on admission were with Subcortical lesions and Unifocal lesions respectively. Among the abnormal EEG 66.67%, 4.17% and rest were of unifocal, subcortical and multifocal lesions respectively, with p value <0.001 (significant). Our study showed 96.43% of cases with MCA territory infarct had normal EEG after 1 month in comparison to
68.42% on admission, which was statistically significant. Also 3.57% of cases with MCA infarct showed EEG with focal slowing after 1 month against 19.3% on admission, which was also considered significant. Significant improvement was also found in case of multifocal slowing of EEG in MCA territory infarct. 90.0% of PCA territory infarct showed normal EEG after 1 month against 54.55% on admission, with a significant p value. 10% of them had focal slowing after 1 month in comparison to 45.45% on admission, which was statistically significant. 91.67% of cortical lesions showed normal EEG after 1 month in comparison to 37.84% on admission with p value of <0.001 (significant). 8.33% of them showed focal slowing after 1 month in comparison to 43.24% on admission, which was statistically significant. Significant improvement change in multifocal slowing of EEG in them was also found. This study showed good clinical outcome in patients with ACA, MCA and PCA infarct. Whereas, Pontine infarct and those with Multi-infarct state showed very poor clinical outcome with high mortality. The p value of this correlation was found significant. The mean MRS after 1 month for ACA, MCA, PCA, Multi-infarct and pontine infarct respectively were 3±0, 3.44±0.91, 3.73±1.19, 5.77±0.44, 6±0. Multi-infarct state was associated with high mortality rate, whereas, cortical or subcortical lesion showed good clinical outcome according to MRS after 1 month which for cortical, subcortical and multi-infarct state respectively were 3.54±0.77, 3.7±1.34, 5.77±0.44. The p value of this study was also significant (Tables 1 & 2).
DISCUSSION
The patients in our study was between 44 to 85 years of age, with maximum patients in the group of 61-70 years (45.6% of the patients). In our study there were 55.6% males and 44.4% females. A previous study1 showed prevalence of stroke for individuals older than 80 years is more than that of individuals of 60-79 years of age. Other studies(2,3) showed that stroke is commoner in men and most common age group was 61-70 years. In our study MCA territory infarct was commonest followed by Multiinfarct state, PCA infarct and Pontine infarct. Previous studies4,5 revealed MCA territory was most frequently involved. On admission normal EEG was commonest finding followed by focal slowing and diffuse slowing. But in previous studies6,7, the most common EEG finding was focal slowing (43.5%). 91.8% cases showed normal EEG on follow up, similar to a previous study8. In our study Abnormal EEG findings significantly decreased from 41.1% on admission
Vol 120, No 12, December 2022Journal
of the Indian Medical Association
21
Table 1 — Comparison of EEG findings on admission and after 1 month according to site of infarct


Table 2 — Comparison of EEG findings on admission and after 1 month according to site of lesion
to 8.2% after 1 month Among all the cases discharged, 17 patients died before follow-up. The mean MRS after 1 month for abnormal EEG on admission was 4.50 that is significantly more than a score of 3.36 in normal EEG. There was significant improvement in EEG findings on follow up in comparison to that on admission in cases with MCA and PCA territory infarct. Cortical lesions also showed significant improvement in EEG findings after 1 month. Clinical outcome determined by MRS after 1 month also showed significant correlation with territory and site of infarct corroborating EEG findings. Patients with ACA, MCA and PCA infarct showed better prognosis than those with Pontine infarct and with Multi-infarct state. Simple EEG study can give an idea about the site of Simple EEG study can give an idea about the site of infarct as well as the clinical outcome. Though neuroimaging have taken an important place in determination of site of ischaemia, EEG can be used as a contemporary measure to diagnose and prognosticate this. Neuroimaging needs expensive apparatus and infrastructure whereas EEG can be done with portable machines in the remotest corners in our country. With proper training reporting can also be done locally or with the help of Telemedicine. Thus we can prognosticate cerebral infarct in a cost effective way in a resource poor country like ours.
CONCLUSION
Patients with normal EEG had better clinical outcome. Normal EEG and focal slowing of EEG
was mostly noted in MCA and PCA infarcts involving the cortical region. Hence an idea about the site and vascular territory of the lesion can be determined.
Limitations of the study : As the study used small population group, it may not simulate other studies. Simple EEG recordings were done instead of Continuous EEG or Quantitative EEG. As the study was done in a tertiary care centre it may not represent the community, as mainly patients with poorer condition presents here.
REFERENCES
1Soler EP, Ruiz VC — Epidemiology and risk factors of cerebral ischemia and ischemic heart diseases: similarities and differences. Curr Cardiol Rev 6: 2010: 138-49.
2Appelros P, Stegmayr B, Terént A — Sex differences in stroke epidemiology. A systematic review: Stroke 2009; 40: 1082–90.
3Vaidya CV — A retrospective study of clinical profile of stroke patients from GMERS Medical College and Hospital, Gandhinagar, Gujarat: International Journal of Clinical Trials 2014; 1(2): 62-6.
4Paciaroni M, Silvestrelli G, Caso V, Corea F, Venti M, Milia P, et al — Neurovascular territory involved in different etiological subtypes of ischemic stroke in the Perugia Stroke Registry. Eur J Neurol 2003; 10(4): 361-5.
5Chung JW, Park SH, Kim N — Trial of ORG 10172 in AcuteStroke Treatment (TOAST) classification and vascular territory of ischemic stroke lesions diagnosed by diffusion-weighted imaging. J Am Heart Assoc 2014; 3(4).
6Wolf ME — The use of routine EEG in acute ischemic stroke patients without seizures: generalized but not focal EEG pathology is associated with clinical deterioration. Int Journal of Neuroscience 2017; 127(5): 421-6. Epub 2016 Jun 1.
7Jennifer Wu — Utility of EEG measures of brain function in patients with acute stroke. Journal of Neurophysiology, 115(5).
8Giaquinto S, Cobianchi A — EEG recordings in the course of recovery from stroke. Stroke 1994; 25(11): 2204-9.
Vol 120, No 12, December 2022Journal of the Indian Medical Association
22
Original Article
Benign Retrovesical Pelvic Mass in Men : Diagnostic and Management Dilemma
Rama Kishan Saran1, Kiran Mirdha2, Sanya Saran3, Irshad4, Aishwarya4
Aim : To identify the diagnostic difficulties and management issues of benign pelvic masses in males and high light the diagnostic protocol for these rare pelvic masses.
Methods : A prospective single center study over a period of six years and three months. History, physical examination, operative findings and histopathological (HPE) diagnosis were recorded.
Results : A total of 20 male patients presented with retrovesical mass, aged 17 to 65 years old (mean age 36.7 years) were evaluated. masses were found to be of prostatic origin in seven cases (5 prostatic utricle cyst and 2 prostatic abscess), connective tissue in seven, seminal vesicle origin in four, mullerian duct remnant in one case, and embryonic urogenital vestigial remnants in one case. Of these 20 patients, 19 presented with acute or chronic lower urinary tract symptoms and in one case, the mass was asymptomatic and found incidentally. Ultrasound showed cystic lesions in 17 patients and solid masses in three. Nine cases underwent exploratory laparotomy. Further biopsies of specimen demonstrated tissue of origin in all cases (8/9) except one. HPE report confirmed the same clinical and operative diagnosis in six cases.
Conclusion : Benign retrovesical mass presents with lower tract obstructive symptoms, palpable pelvic mass and retention of urine. Needle or open biopsy is required in most cases to establish a histopathological diagnosis. Benign retrovesical mass is rare, we faces difficulty in diagnosis and management. Hence, diagnostic protocols can be helpful to manage retrovesical pelvic masses.
[J Indian Med Assoc 2022; 120(12): 23-9]
Key words :Diagnostic protocol, Seminal vesicle, Prostate, Histopathology.
Retrovesical pelvic mass are often inflammatory, neoplastic or congenital. Benign pelvic masses in males apart from benign prostatic hypertrophy and bladder or prostate cancer may be a rare entity and pose problems in diagnosis and management1. Rare retrovesical masses can be classified as cystic includes mullerian duct cyst, prostatic utricle cysts, congenital or acquired vesicle cysts and dermoid cysts or solid includes teratomas.
These retrovesical masses can be presented with varying clinical features and signs, which may mimic various other common diseases of the lower tract. There are often numerous differential diagnoses for a retrovesical mass which must be narrowed down to a histologically confirmed or biopsy-proven diagnosis. A series of diagnostic tests are available including USG, CECT or MRI and vasography etc. Hence a diagnostic
Department of Surgery, Dr S N Medical College, Jodhpur, Rajasthan 342003
1MBBS, MS, MCh (Urology), Professor and Corresponding Author
2MBBS, MS (Obstet and Gynaecol), Principal, Specialist, Umaid Hospital, Jodhpur 342006, Rajasthan
3MBBS, MD (Paediatrics), Resident, Department of Paediatrics, Government Medical College, Kota, Rajasthan 324010
4MBBS, MS (General Surgery), Resident
Received on : 08/06/2022
Accepted on : 24/08/2022
Editor's Comment :
Diagnosis and management of retrovesical pelvic (RVP) masses pose problems in men.
This study identified the diagnostic difficulties and management issues of RVP masses.
Radiological investigations showed cystic extra prostatic mass with no specific features.
The surgical approach of CSVC can be challenging and associated with many complications.
Therefore, there is a need of accurate treatment whenever symptoms are present.
protocol for suspected pelvic masses needs to be made clear. Inspite of many new diagnostic modalities still present a diagnostic dilemma. We are here with presenting a case series of the following rare benign pelvic masses in male patients, their presenting features, diagnosis, and management aspects. The aimed is to identify the diagnostic difficulties and management issues of benign pelvic masses in males and high light the diagnostic protocol for these rare pelvic masses.
MATERIALS AND METHODS
A prospective study conducted at the Department of Surgery, Dr S N Medical College, Jodhpur, Rajasthan, India between September 2013 and December 2019. This study protocol was reviewed and
Vol 120, No 12, December 2022Journal of the Indian Medical Association
23
approved by Institutional Ethics Committee. All male patients diagnosed with pelvic mass with age between 17 and 65 years were included. A total of 20 male patients presented with retrovesical mass, aged 17 to 65 years old (mean age 36.7 years) were evaluated. We were analyzed our data with regard to history, physical examination obtained with special attention to age, clinical presentation, diagnostic testshaemogram, renal function test, X-KUB and USG, individualized investigations-CT scan, vasography, TRUS, MRI abdomen and pelvis, type of operation, operative findings, and histopathological diagnosis. Exclusion criteria-Common pelvic masses such as bladder diverticula, BPH, or malignant bladder or prostatic masses were excluded.
RESULTS
Table 1 summarizes the clinical findings, details of diagnosis and management of 20 patients with rare benign pelvic masses. These masses were found to be of prostatic origin in seven cases (5 prostatic utricle cyst and 2 prostatic abscess), connective tissue in seven, seminal vesicle origin in four, mullerian duct remnant in one case and embryonic urogenital vestigial remnants in one case.

Clinical presentation : Of these 20 patients, 19 presented with acute or chronic lower urinary tract symptoms and in one case, the mass was asymptomatic and found incidentally. Two patients presented with acute inflammatory symptoms, such as fever with or without flank pain and nine patients had non-inflammatory, such as urinary retention. In contrast, six patients had chronic symptoms, such as perineal pain, frequency, hemi- scrotal pain and urinary incontinence. Two patients had primary infertility and perineal pain.
On Abdominal, Digital Rectal and Bimanual Examination : Large suprapubic cystic mass was palpable in two cases, in the same two patients on Digital Rectal Examination (DRE), huge bimanually palpable cystic mass was found, prostate could not be felt separately and upper limit was not reachable. In addition, DRE revealed a large hard, non-tender, nonpulsatile, smooth surface, felt anterior to rectum just above the anal verge, upper limit not reachable, prostate can felt separately likely connective tissue masses in three patients, while four patients revealed soft, non-tender, non-pulsatile, smooth surface, felt anterior to rectum just above the prostate, upper limit not reachable, likely connective or adipose tissue
Table 1 — Clinical findings, details of diagnosis and management of 20 patients with rare benign pelvic masses
Vol 120, No 12, December 2022Journal
of the Indian Medical Association
(Contd........) 24
masses. Intraprostatic lesions were noted in seven patients with a prostatic mass. Extra-prostatic masses were detected in four patients with a seminal vesicle mass.
Laboratory studies: All patients had haemoglobin, blood counts, urine examinations complete microscopic with culture, renal function tests. Urine examination showed pus cells 4-6 to full field per high power field in seven cases and E. coli was detected in urine culture of two cases. Urinalysis also demonstrated microhaematuria in all cases of prostatic and seminal vesicle masses. white blood count and Urine leukocytes were significantly higher in two

patients (prostatic abscess) than for a simple prostatic utricle but renal function tests was within normal range for all cases.Two patients presented as primary infertility had normal testosterone, FSH, LSH, serum prolactin and azoospermia but one patient had an ejaculation with azoospermia in post-void urinary sample. In the other patient’s laboratory studies revealed no pathological findings.
Ultrasound studies : Ultrasound showed cystic lesions in 17 patients and solid masses in three. Medial locations of a cystic retro-vesical mass were consistent with a prostatic utricle cyst (Fig 1) or abscess (Fig 2). Transrectal ultrasound was performed
Vol 120, No 12, December 2022Journal of the Indian Medical Association
25
additionally in eight patients to confirm the intraprostatic or extra-prostatic location of the cysts. Ultrasound revealed mixed echogenic masses in all the three patients with retro-vesical teratoma (Fig 3) which was difficult to differentiate from haematoma and four patients had cystic lesion contained hyperechoic material consistent with dermoid cyst but one letter on confirm on HPE was mullerian duct cyst with cystadenoma. A cystic extra-prostatic mass lateral to


the bladder neck was demonstrated on ultrasound for all seminal vesicle (Fig 4).

IVU, CYSTOGRAM, AGP and Vasography : One patient reported large mass shadow seen in pelvis left side pushing bladder towards right and anteriorly with raised base of the bladder. Vasography -B/l vas and seminal vesicle normal, bladder base elevated and grade 1 reflex on left side (Fig 5) (mullerian duct cyst with cystadenoma). In Case-4 vasogram confirm the

Vol 120, No 12, December 2022Journal of the Indian Medical Association
Fig 4 — USG images of seminal vesicle cyst
Fig 1 — USG images showed prostatic cyst
Fig 3 — Radiological images of Teratoma (case no 5)
26
Fig 2 — Radiological pictures of Epidermoid cyst (case no 3) and Last MRI picture showed b/l seminal vesicle cyst (case no 4)
diagnosis of ejaculatory duct cyst.
CT scan and/or MRI abdomen pelvis : CT Scan and/ or MRI abdomen pelvis was performed in 16 cases, both were accurately demonstrated the anatomical relationship of associated intra pelvic organs with surrounding fat and pelvic lymph nodes. CT Scan and/ or MRI abdomen pelvis clearly depicted prostatic utricle cysts in 3/3(100%) cases, intraprostatic abscess cavities in 2/2 (100%) cases, seminal vesicle cysts 2/ 2 (100%) and cystic connective tissue masses in 4/4 (100%). CT scan abdomen pelvis accurately demonstrated retro-vesical connective tissue solid masses in three cases. CT scan and/or MRI abdomen pelvis failed to differentiate accurate diagnosis in two cases (ejaculatory duct cyst and mullerian duct cyst with cystadenoma). However, MRI failed to differentiate between teratoma and haematoma. FNAC accurately demonstrates diagnosis in two cases of intraprostatic abscess (Fig 6).
Open Surgical and Endoscopic management : Nine cases underwent exploratory laparotomy ie, three

cases solid masses cut surface finding suggestive mature teratoma, three cases semi solid cyst masses on cut suggestive dermoid cyst and 3 were cystic masses surgical specimen finding inconclusive to clench the diagnosis. All surgical specimen sent for histopathological examination to confirm the diagnosis of the pelvic mass. Prostatic utricle and seminal vesicle cysts and prostatic abscess were treated with transurethral route. Transurethral unroofing was done in prostatic utricle cyst (4 cases) and in seminal vesicle cysts (3 cases). Transurethral resection of the ejaculatory duct was performed in one case of ejaculatory duct cyst and was uneventful. Transurethral unroofing and drainage of the prostatic abscess was done in two cases and were uneventful. One case of bilateral seminal vesical cyst managed conservatively. Follow up period was unremarkable in all cases.
Histopathological examination : Biopsies of specimen demonstrated tissue of origin in all cases (8/9) except one. HPE report confirmed the same clinical and operative diagnosis in six cases (3 were

Vol 120, No 12, December 2022Journal of the Indian Medical Association
Fig 5 — Radiological and operative images of mullarian duct cyst with cystadenoma (case no 1)
27
Fig 6 — Radiological and operative images of embryonic urogenital vestigeal remnant ??/ Presacral meningocele ??(case no 2 )
mature teratoma and 3 were dermoid cysts). We were unable to clench the diagnosis in two cystic mass with our clinical and operative finding but confirm with HPE ie, Mullerian duct cyst with cystadenoma and inclusion cyst. Even after HPE report in one case of cystic mass suggestive diagnosis embryonic urogenital vestigial remnant? presacral meningocele but not confirmed.
DISCUSSION
Retrovesical pelvic masses in males are uncommon and presented with varying features1. They can be congenital or acquired. The mesonephric duct and the ureteral bud join the urogenital sinus during embryogenesis2. The Wolffian duct differentiates into the genital duct system, forming the epididymis, vas deferens, seminal vesicles and ejaculatory ducts in males.
The appearance of Mullerian duct cyst was associated with the remnants of the Mullerian duct3 and usually occur in the 3rd and 4th decades of life, maybe incidental4. If large enough, they can cause obstructive or irritative urinary symptoms, like haematuria, ejaculatory impairment or suprapubic or rectal pain. In this study, a 65 years old male patient presented with LUTS and a cystic supra pubic lump with MRI abdomen showing cystic mass pushing bladder to right side. Final diagnosis of Mullerian duct cystadenoma was made on HPE of the cyst excised. In 1942, Clyde, et al described a Mullerian duct cyst in 34-year-old male with LUTS where final diagnosis was made on histopathological examination5
Pre-sacral meningocele most frequently presenting as a presacral mass. It is an extension of the dura mater and arachnoid out of the sacral spinal canal into the retroperitoneal and intraperitoneal space through a congenital defect in the sacrum. Most of the patients presented with long standing constipation and urinary dysfunction. In case of constipation, the urinary dysfunction may be related to direct pressure on the bladder or may result from spinal cord tethering or sacral nerve root compression. Here we represent a 17-year-old male student with constipation for 5 years, episodes of ROU in the last one year & painless lump in the lower abdomen for 6 months. CECT and MRI abdomen showed a cystic mass in the pelvis, posterior to the bladder and posterolateral to rectum. On exploratory laparotomy confirm CECT finding with a fibrotic attachment to the posterior surface of the prostate. Mass was excised and sent for HPE. Biopsy of the specimen suggestive of embryonic urogenital vestigial remnants? Presacral meningocele? In 1971,
Chovnick, et al reported a case of 50-year-old male patient with retention of urine and cystic mass, diagnosis of anterior sacral meningocele was confirmed by HPE.
Dermoid cysts of the presacral space are relatively common while dermoid cysts presented at the anterior to the rectum are not so common, and those which involve the bladder usually occur in women and are ovarian in origin and rare in men6. In the present study, three male patients diagnosed to have dermoid cyst in pelvis, where all of them presented with pain in the scrotum and burning micturition. Radiological investigations showed cystic extra prostatic mass with no specific features and confirm by FNAC . In one case, dermoid cyst was wrongly diagnosed to be ischiorectal abscess and incision drainage was done, which yielded whitish material. Wilson, et al in 1973, reported a case of dermoid cyst in a 51-year-old male, which was diagnosed to be a gluteal hernia on clinical examination, final diagnosis of dermoid cyst was made on HPE and fluid examination of the cyst after excision.
Prostatic utricle cysts are emerged at the extent of the verumontanum and most of the time found within the midline. Utricle cysts are usually smaller and are less likely to extend above the prostate. There is an association between utricle cysts and variety of genitourinary abnormalities7
Congenital Vesicle Cysts (CSVCs) related to anomalies of the ipsilateral upper urinary tract are uncommon. This condition has been reported as “Zinner syndrome”. In such patients onset was reported during second or third decade of life with high incidence of dysuria (37%), frequency (33%), perineal pain (29%), and epididymitis (27%)8 . The diagnosis is mainly achieved in adult age but demanding in pediatric age . The surgical approach of CSVC can be challenging and associated with many complications. Therefore, there is a need of accurate treatment whenever symptoms are present. Livingston L and Larsen CR reported seminal vesical cyst in all five patients, two patients were examined for primary infertility. Four patients were seen because of a history of dysuria. Other clinical symptoms included hematuria; nocturia; urinary frequency; urgency; lower abdominal, perineal, and ejaculatory pain; and haematospermia. One patient was treated empirically for prostatitis and chronic recurrent epididymitis with antibiotic therapy during a 6-year interval9
Teratomas are congenital tumours that contain derivatives of all three germ layers. Retrovescical teratomas are rare entity of extragonadal tumour commonly observed in adults, especially in males. The
Vol 120, No 12, December 2022Journal
of the Indian Medical Association
28
prevalence of retrovescical teratomas is more in various sites and organs. The majority of patients were asymptomatic with large neoplasm at the time of presentation which can cause urinary disturbance10.
Prostatic abscess is rare in the era of antibiotics. Most of them presented with perineal pain, fever, urinary tract infection. In 1992, 25 patients with prostatic abscess were diagnosed mainly by TRUS and IVP. Treated with parenteral antibiotics and 22 underwent surgical drainage11
The present study proposed a diagnostic algorithm (Fig 7) for suspected pelvic masses, according to proposed diagnostic guideline. Every retro-vesical mass evaluated by history, general physical and local examination with findings on DRE followed by ultrasound allow reliable diagnosis of retro-vesical lesions whether cystic or solid mass but most of the times exact location, tissue origin, involvement of organs and lymph nodes cannot be confirmed. In such situation, most of the cases according to the present study diagnostic approach CT and MRI of abdomen and pelvis are needed. However, rare retro-vesical mass may require biopsy and exploratory laparotomy followed by histopathological examination to confirm the diagnosis.

CONCLUSION
Benign retrovesical mass presents with lower tract obstructive symptoms, palpable pelvic mass and retention of urine. CT or MRI is useful for exact location, tissue of origin, the involvement of organs and lymph nodes. Needle or open biopsy is required in most cases to establish a histopathological diagnosis. Laparotomy and histopathological examination are the procedures of choice when other findings are equivocal. Excision of benign retrovesical mass is difficult because of deeply situated in pelvis. Benign retrovesical mass is rare, we faces difficulty in diagnosis and management. Hence, diagnostic protocols can be helpful to manage retrovesical pelvic masses.
Acknowledgement : None
Conflict of interest : None to be declared
Funding : None
REFERENCES
1Sivashankar M, D Perera N, Nalin Ruvinda PG, Samarasinghe TM, Navarooban N — A giant retrovesical cystic mass: A rarest of rare with a management dilemma. Urol Case Rep
Fig 7 — Proposed diagnostic protocol flow chart
2021; 35: 101548.
2Coplen DE, Duckett JW — The Modern Approach to Ureteroceles. J Urol 1995; 153(1): 166-71.
3Syme G — Müllerian Duct Cyst. AustNZJSurg 1965; 35: 5660.
4Johnson D, Parikh K, Schey W, Mar W — MRI in diagnosis of a giant prostatic utricle. CaseRepRadiol 2014; 2014: 217563.
5Deming CL, Berneike RR — Müllerian Duct Cysts. JUrol 1944; 51(6): 563-8.
6Wilson RG — Dermoid cyst of the rectovesical space: Report of a case. Dis Colon Rectum 1973; 16(6): 530-1.
7Feutry G, De Perrot T, Wirth GJ, Montet X, Martin SP — Prostatic Utricle Cyst as the Most Likely Cause in a Case of Recurrent Episodes of Hematospermia. Case Rep Urol 2017; 2017: 7502878.
8Mehra S, Ranjan R, Garga UC — Zinner syndrome-A rare developmental anomaly of the mesonephric duct diagnosed on magnetic resonance imaging. Radiol Case Rep 2016; 11(4): 313-7.
9Livingston L, Larsen CR — Seminal Vesicle Cyst with Ipsilateral Renal Agenesis. Am J Roentgenol 2000; 175(1): 177-80.
10Vera, Safriadi F — Mature (Benign) Cystic Retrovesical Teratoma in a 49-Year-Old Male: a Case Report and Literature Review. Am J Med Case Rep 2016; 4(5): 153-7.
11Granados EA, Riley G, Salvador J, Vicente J — Prostatic Abscess: Diagnosis and Treatment. J Urol 1992; 148(1): 802.
Vol 120, No 12, December 2022Journal
of the Indian Medical Association
29
Original Article
A Single Centre Experience of Spontaneous Bacterial Peritonitis in Ascites with Cirrhosis : A Record Based Observational Study
Ravikeerthy M1, Shambo S Samajdar2
Spontaneous Bacterial Peritonitis (SBP) is one of the complicated infections in patients with cirrhosis and ascites which can be fatal if not diagnosed and treated. This is a record based observational study using the data of all patients admitted with established cirrhosis of liver with ascites. Aim of the study was to find out the incidence of SBP in cirrhosis patients and also to study the clinical profile of SBP. Thirty nine patients’ data were included in the study. Three patients had classic SBP, one patient had Culture Negative Neutrocytic Ascites (CNNA) and two had bacterascites. Patients were treated with injection cefotaxime (2 gm) 8hourly for 5 days and clinical and laboratory parameters were evaluated.
[J Indian Med Assoc 2022; 120(12): 30-2]
Key words :Ascites, Cirrhosis, Spontaneous Bacterial Peritonitis (SBP), Culture Negative Neutrocytic Ascites (CNNA), Bacterascites.
Ascites or hydroperitoneum is the collection of fluid of more than 25 ml in the abdominal cavity .The word ascites was derived from a Greek word “Askos” meaning a bag or sack. The term was coined by an Irish Physician Triwsa. Cirrhosis of liver is the commonest cause of ascites but many other conditions like cardiac (congestive cardiac failure), infections (tuberculosis, chlamydia), hypoproteinemia, pancreatitis, renal (nephrotic syndrome), hypothyroidism and familial Mediterranean fever can cause Ascites1. Laennec coined the term “Cirrhosis” in 1826 and derived from a Greek word meaning ‘Orange’ or ‘Twany’. Worldwide cirrhosis contributes to 1.1% of all deaths2 Causes of cirrhosis can be alcoholic or post necrotic or NAFLD. Spontaneous Bacterial Peritonitis (SBP) is the bacterial infection of peritoneum in the presence of ascites. SBP rarely occurs without ascites. It is potentially a reversible condition if treated early and can be fatal without diagnosis and treatment. With availability of newer antibiotics the mortality rates has been reduced from 100% to less than 20% with early diagnosis and treatment3 Clinical presentation of SBP may be varying. It could be starting from asymptomatic to minor symptoms to severe symptoms. Clinically SBP
1MBBS, MD (Medicine), FICP, Professor, Department of Medicine, Meenakshi Medical College and Research Institute, Enathur, Tamilnadu 631552 and Corresponding Author
2MBBS, MD, DM (Clinical Pharmacology), Fellowship in Respiratory & Critical Care (WBUHS), PG Dip Endo & Diabetes (RCP); Clinical Pharmacologist, School of Tropical Medicine, Kolkata 700073
Received on : 08/11/2022
Accepted on : 10/11/2022
Editor's Comment :
Spontaneous bacterial peritonitis (SBP) needs early recognition in patients ofcirrhosis with ascites to prevent mortality.
We had conducted a record based observational study including 39 patients.
Of the 39 patients, 3 patients had classic SBP, one case was CNNA and two patients had bacterascites and rest had sterile ascites.
Injection cefotaxime 2 gm 8 hourly for 5 days were used which was associated with zero mortality in our study. Small sample size of the study is an important limitation.
is classified into three variants —
(1) Classic SBP- More than 250/mm3 polymorphonuclear leucocytes in ascitic fluid and culture is positive
(2) Polymorpho-nuclear leucocytes >250/mm3 but culture is negative (3) Bacterascites- Culture is positive but polymorpho-nuclear leucocytes are less than 250/mm3
Common clinical manifestations are fever, pain abdomen, altered GI motility, features of hepatic encephalopathy in severe cases4. Early diagnosis and proper treatment reduces the mortality rates. In this back ground this study was conducted to find out the incidence of SBP in ascitic patients and to study the clinical profile of patients with SBP.
MATERIALS AND METHODS
This is a record based observational study done with patients admitted with history of ascites over a period of one year from May 2021 to April 2022. Ethics committee permission was obtained. Patients with history of abdominal paracentesis in the last three weeks, patients who had received antibiotics four weeks prior and patients with secondary causes of
Vol 120, No 12, December 2022Journal of the Indian Medical Association
30
peritonitis were excluded from the study. Detailed history was taken and clinical examination was done. Patients underwent relevant investigations, were evaluated. Diagnosis of cirrhosis was confirmed by the report of ultrasound abdomen. After admission all patients 30 ml of ascitic fluid wad obtained immediately which was sent for cytological examination and biochemistry and 10 ml of fluid for culture. Ascitic fluid cell count was done under microscope. Ascitic fluid cultures were done as per standard culture methods.According to record based evaluation of all these documented data focusing on the ascitic fluid Polymorpho-Nuclear count (PMN), patients were grouped into(1)Sterile ascites
(2)Classic SBP- Culture positive and PMN count more than 250/mm3
(3)Culture Negative Neutrocytic Ascites (CNNA) (4)Bacterascites- PMN less than 250/mm3 but culture positive
RESULTS
We had included the data of 39 patients who were matching predefined inclusion and exclusion criterion.Among the study population,29 were male and 10 were female patients. The mean age was 49.1±9.6 and 47.3±12.05 in male and female patients respectively. Age range was 20-65 years. 25 patients had alcoholic cirrhosis, 4 had post necrotic (hepatitis B) and rest 10 had non-alcoholic fatty liver disease (NAFLD). Patients with SBP had Child-Turcotte-Pugh class C.
Of the 39 patients, 3 patients had classic SBP, one case was CNNA and two patients had bacterascites and rest had sterile ascites. Average age of the patients with classic SBP and bacterascites was less than 40 years and only case with CNNA age was more than 40 years. Majority patients with SBP had alcoholic cirrhosis and one patient had post necrotic cirrhosis. Jaundice was a common finding in all cases with SBP, two patients had fever as presenting symptom and two had abdominal pain and one patient had GI bleed and no one had encephalopathy. Of the 6 cases of SBP only one was female and had classic SBP.
Table 1 is showing the characteristics of patients SBP in the study.
DISCUSSION
Spontaneous Bacterial Peritonitis (SBP) is almost all in cases with cirrhosis of Liver cases with few exceptions some case reports have shown SBP in cardiac ascites5. Incidence rates of SBP vary from
Table 1 — Characteristics of patients with SBP ParameterValue
No of patients positive in all categories of SBP6 (in number)
Total No of patients in study39(in number)
Incidence of SBP15.38%
Incidence of Classic SBP 7.69%
Age47.12 ±10.6 (SD)
Sex Male/Female 5/1 (in number)
Jaundice6 (in number)
Fever2 (in number)
Pain abdomen2 (in number)
GI bleed1 (in number)
Total counts12670 ± 6732 /uL
Hemoglobin 9.5 ± 2.1 gm/dl
Platelet count124670 ± 51670 /uL
T Bilirubin in Classic SBP6.23 ± 5.4 mg/dl
T Bilirubin in CNNA2.8 mg/dl
Total protein5.6 ± 1.1 gm/dl
Albumin 2.1 ± 0.31 gm/dl
Ascitic Fliud PMN counts1500 ± 2897 /uL
Ascitic Fliud Protein1.38 ± 0.89 gm/dl
Ascitic Fliud Sugars88.65 ± 32 mg/dl
Ascitic Fliud Culture5 positive
Ascitic Fliud Organism grown E coli
Ascitic Fliud Response to treatmentAll Recovered
study to study because of sample size in general in hospitalized patients it is around 10-30%6 . In the present study overall incidence of SBP is 15.38% and classic SBP 7.69%, CNNA 2.56% and bacterascites is 5.12%. A study published by Amarapurkar, et al in 1992 showed the incidence of Classic SBP is 12.9% and CNNA 9.6%7. However a study by Runyon and Hoef JC showed higher incidence of SBP is 64.7% classic SBP and 35.3% CNNA8. Two patients had fever in the present study (3.33%). Incidence of fever in study done by Weinstein, et al in 1978 was 68%9. However some studies had shown that they had fever but had vague abdominal pain. Abdominal pain was seen two patients the present study which almost similar to the other published studies. Heapic encephalopathy was observed in many studies like Weinstein, et al and Amarpurkar, et al but none of our patients had encephalopathy. GI bleed was seen in one patient the present study. Asymptomatic cases are also common as seen in the study by Conn and Fessel, et al10. Abdominal paracentesis was a contraindication earlier because of coagulopathy, now the studies have shown that abdominal paracentesis is safe and doesnot increase the risk of bleeding. There are several independent risk predictors of SBP like CRP>13 mg/dl, Platelet count <82000/uL and advanced age11. The other factors that determine the severity of SBP are severity of liver dysfunction; risk is more with advanced liver disease. Fever, high serum bilirubin, ascitic fluid total protein level of <1 g/dl and deranged renal functions are important predictors for
Vol 120, No 12, December 2022Journal
of the Indian Medical Association
31
development of SBP2. MELD score is another important predictors for development of SBP12. MELD scoring was not done in this study as it is record based study. All patients with positive cultures grew E coli. Several other studies also shows similar results. Other common organisms that cause SBP are klebsiella pneumoniae, salmonella, staphylococcus aureus, klebsiella oxytoca, citrobacter spp, corynebacterium spp, pseudomonas aeruginosa, enterobacter cloacae, serratia marcescens, acinetobacter spp, proteus mirabilis13. Possible mechanisms that involve in the development of SBP are increased colonization of gram negative bacteria in the upper gastrointestinal tract and bacterial overgrowth and failure of the gut to control the bacteria and immune system3. SBP is one of the common causes of infection in the setting of ascites. Early diagnosis and treatment are very important in reducing the mortality. Despite of advances in medication, the one month mortality is around 2648%14. Cefotaxime is the most extensively studied antibiotic and, should be given at a dose of 2 gm 8 hourly for 5 days, it rapidly penetrates the ascitic fluid and exceeds the MIC of 90% of the isolated organisms by 20-fold3. In the present study all patients were treated with cefotaxime 2 gm 8 hourly for 5 days and patient showed significant improvement in terms of clinical features and along with the Lab parameters. Other commonly used other two antibiotics are amoxicillin-clavulanic acid are ofloxacin. Use of intravenous albumin in the dose of 1.5gm /kg on day one and 1 gm on day three also reduces short and intermediate term mortality.
Limitations : Small sample size is an important limitation of our study.Predictive parameters could not be used as it is a record based analysis. Prospective observational study with adequate sample size needs to be done for generalization of the study result which emphasizes the need of preparing registry in this regard.
Conclusion : Spontaneous bacterial peritonitis in one of the common infections in setting of ascites secondary to cirrhosis of liver. Without treatment the mortality rates are very high and hence early diagnosis and treatment are very important. Gram negative bacteria like E coli is the commonest microorganism responsible for SBP. Injection cefotaxime 2 gm 8 hourly for 5 days would reduce the mortality rates.
REFERENCES
1Corey KE, Friedman LS — Abdominal Swelling and Ascites. In: Kasper D, Fauci A, Hauser S, Longo D, Jameson J, Loscalzo J. eds. Harrison’s Principles of Internal Medicine, 19e. McGraw Hill; 2014. Accessed November 08, 2022.
2Paul K, Kaur J, Kazal HL — To Study the Incidence, Predictive Factors and Clinical Outcome of Spontaneous Bacterial Peritonitis in Patients of Cirrhosis with Ascites. J Clin Diagn Res 2015; 9(7): OC09-12. doi: 10.7860/JCDR/2015/ 14855.6191. Epub 2015 Jul 1. PMID: 26393155; PMCID: PMC4572986.
3Todd A Sheer, Bruce A — Runyon Spontaneous Bacterial Peritonitis. Dig Dis 2005; 23: 39-46.
4Syed VA, Ansari JA, Karki P, Regmi M, Khanal B — Spontaneous bacterial peritonitis (SBP) in cirrhotic ascites: a prospective study in a tertiary care hospital, Nepal. Kathmandu University Medical Journal (KUMJ) 2007; 5(1): 48-59. PMID: 18603986.
5Canakis A, Canakis J, Lohani M, Ostrander T — Spontaneous Bacterial Peritonitis in Cardiac Ascites: A Rare but Deadly Occurrence. AmJCaseRep 2019; 20: 1446-8. doi: 10.12659/ AJCR.915944. PMID: 31570687; PMCID: PMC6788488.
6Zacharia GS, Rangan K, Kandiyil S, Thomas V — Spontaneous bacterial peritonitis in extrahepatic portal venous obstruction. Ann Gastroenterol 2013; 26(4): 363-4. PMID: 24714664; PMCID: PMC3959491.
7Amarapurkar DN, Viswanathan N, Parikh SS, Kalro RH, Desai HG — Prevalence of spontaneous bacterial peritonitis. JAssoc Physicians India 1992; 40(4): 236-8. PMID: 1452529.
8Runyon BA, Hoefs JC — Culture-negative neutrocytic ascites: a variant of spontaneous bacterial peritonitis. Hepatology 1984; 4(6): 1209-11. doi: 10.1002/hep.1840040619. PMID: 6500513.
9Weinstein MP, Iannini PB, Stratton CW, Eickhoff TC — Spontaneous bacterial peritonitis. A review of 28 cases with emphasis on improved survival and factorsinfluencing prognosis. Am J Med 1978; 64: 593-8.
10Conn HO, Fessel JM — Spontaneous bacterial peritonitis in cirrhosis: variations on a theme. Medicine (Baltimore) 1971; 50(3): 161-97. doi: 10.1097/00005792-197105000-00002. PMID: 4938274.
11Metwally K, Fouad T, Assem M, Abdelsameea E, Yousery M — Predictors of Spontaneous Bacterial Peritonitis in Patients with Cirrhotic Ascites. J Clin Transl Hepatol 2018; 6(4): 3726. doi: 10.14218/JCTH.2018.00001. Epub 2018 Jul 18. PMID: 30637213; PMCID: PMC6328737.
12Bunchorntavakul C, Chamroonkul N, Chavalitdhamrong D — Bacterial infections in cirrhosis: A critical review and practical guidance. World J Hepatol 2016; 8(6): 307-21. doi: 10.4254/ wjh.v8.i6.307. PMID: 26962397; PMCID: PMC4766259.
13Santoiemma PP, Dakwar O, Angarone MP — A retrospective analysis of cases of Spontaneous Bacterial Peritonitis in cirrhosis patients. PLoS One 2020; 15(9): e0239470. doi: 10.1371/journal.pone.0239470. PMID: 32986728; PMCID: PMC7521743.
14Rostkowska KA, Szymanek-Pasternak A, Simon KA. Spontaneous bacterial peritonitis - therapeutic challenges in the era of increasing drug resistance of bacteria. Clin Exp Hepatol 2018; 4(4): 224-31. doi: 10.5114/ceh.2018.80123. Epub 2018 Dec 3. PMID: 30603669; PMCID: PMC6311748.
Vol 120, No 12, December 2022Journal
of the Indian Medical Association
32
Original Article
Immunity Status of Health Care Workers Post-Recovery from COVID-19: Natural Adaptive Immunity Persists at Nine Months Post-Infection : An Online Longitudinal Panel Survey
Shagun Bhatia Shah1, Rajiv Chawla2, Akhilesh Pahade3, Nitin Bansal4, Anurag Mehta5, Ajay Kumar Dewan6, Anuj Parkash7, Meenu Bhatia8
Background : Various studies have pinned longevity of protective Immunoglobulin-G (IgG) titres at 2-5 months. The robustness and longevity of the IgG antibody response to COVID-19 infection has been gauged in a cohort of 214 single institutional health care workers by serial quantitative immunometric tests. Currently no separate guidelines exist for vaccination of COVID-survivors and this study provides data to fill this lacuna in knowledge.
Methodology : Prospective longitudinal panel survey administered to the same cohort of Health Care Workers (HCW) till such time they got vaccinated under Indian Government’s free vaccination drive for HCW. Depending upon the date of contraction of infection the HCW could be longitudinally monitored for variable periods (2-9 months). The survey questionnaire comprising multiple-choice, dichotomous, matrix and Likert-scale questions was deployed to the respondents online via email/WhatsApp. Data was expressed as box-whisker plots, trendlines and trend areas. A p-value<0.05 was considered statistically significant. The composite index of ‘Effective Immunity’ was calculated.
Results : The mean IgG antibody titre was 11.13±8.6AU at 1-2m, 9.68±8.9AU at 3-4m, 8.35±5.9 AU at 6-7m and 7.87±4.4 AU at 8-9m after first symptom, respectively. The lowest titre at all time points was 0 while the highest titres were 46.8 AU, 56.5 AU, 23.4 AU and 17.4 AU at 1-2m, 3-4m, 6-7m and 8-9m, respectively.
Conclusion : Adaptive active immunity acquired through natural infection may last for at least 9 months post-initial exposure and lies in the moderate protection range in 77% HCW, which can be extrapolated to vaccination and immunity passports. Separate vaccination guidelines are required for COVID-survivors. The first shot of vaccine serves as a booster second exposure/booster dose in all COVID-survivors.HCW with low IgG-titre may suffer from a false sense of security. Periodic quantitative IgG-titre based serological tests can help guide timing of second shot of vaccination and predict likelihood of re-infection.
[J Indian Med Assoc 2022; 120(12): 33-8]
Key words :Antibody, COVID-19, Humoral immunity, Immunoglobulin-G.
The corona virus disease (COVID-19) pandemic with associated lockdowns had mercilessly brought life to a grinding halt. People have now adjusted with remarkable resilience to the new normal of social distancing, repeated hand-washing, personal protective equipment and the concept of work/study from home. The latest official sero-survey (28000 sample size;
Department of Anaesthesiology and Critical Care, Rajiv Gandhi Cancer Institute and Research Centre, Delhi 110085
1MBBS, DNB, DA; Cert TEE; FIMSA, Senior Consultant and Corresponding Author
2MBBS, MD, Director
3MBBS, MD, Attending Consultant
4MBBS, MD, Infectious Disease Officer, Department of Infectious Disease Control
5MBBS, MD, Director and Senior Consultant, Department of Laboratory and Transfusion Services
6MBBS, MD, Director, Department of Surgical Oncology
7MBBS, MD, Senior Biochemist and Quality Manager, Department of Laboratory and Transfusion Services
8PhD, Biochemist, Department of Laboratory and Transfusion Services
Received on : 06/07/2021
Accepted on : 09/02/2022
Editor's Comment :
Immunity acquired through SARS-CoV-2 infection may last at least 9 months.
IgG-titres are inmoderate protection range in 77% convalescent individuals.
First vaccine shot serves as a second exposure/booster dose in all COVID-survivors.
Periodic quantitative IgG-based serological tests can guide spacing of second vaccination-shot and predict susceptibility to re-infection.
Requirement of separate vaccination guidelines for COVIDsurvivors.
Februry, 2021) results have divulged that 56% of Delhi inhabitants are seropositive 1 Herd immunity development is the Holy grail of the COVID-pandemic and duration for which seropositivity lasts is an important determinant. The free, state-sponsored vaccination drive exclusively for HCW has started on a priority basis since 16th January, 2021 after emergency use authorization of two vaccines2. 214 Health Care Workers (HCW) of a premier tertiary-care onco-hospital who are COVID-survivors periodically got their IgG-titres tested. On follow-up of this cohort until
Vol 120, No 12, December 2022Journal of the Indian Medical Association
33
the date they got vaccinated we could collect data for a maximum of 9 months from the date of symptomonset (index/first case at our institution was diagnosed on 1st of May, 2020 and the last HCW in the survey was enrolled in December, 2020). It is important to gauge the existence, extent and duration of immunity in COVID-survivors, as this would be a predictor of the likely duration of protective effect conferred by the available vaccines and this is the research question we seek to answer. Our primary objective is to find out if IgG antibody levels decline with time and by what amount and the time duration for which they last.
MATERIAL AND METHOD
Our prospective longitudinal panel survey was conducted after prior written informed consent from all HCW and approval from the Scientific Committee and Institutional Review Board. The survey was administered to the same cohort of HCW till such time they got vaccinated (15th January to 28th February, 2021) under Indian Government’s free vaccination drive for HCW. Depending upon the date of getting infected the HCW could be longitudinally monitored for variable periods of time ranging from 2-9 months. The survey questionnaire comprising multiple-choice, dichotomous, matrix and Likert-scale questions was deployed to the respondents online via email/WhatsApp.
An online survey software (Google forms), was utilized to create the survey questions and get analyzed data on a dashboard which keeps updating real-time as respondents partake the online survey. Data presentation on this dashboard comprises charts and graphs for the ease of statistical analysis.
Initial three steps of the survey (defining the population and sample,deciding the type of survey, designing the survey-questionnaire) were completed before and the remaining three steps (distribution of survey and response-collection, survey-result analysis, penning the survey results) were conducted after ethics committee approval.
All HCW, employed at Rajiv Gandhi Cancer Institute and Research Centre (RGCIRC) with a history of being a laboratory confirmed COVID-positive patient and who underwent antibody tests were included in the study. Non-HCW and HCW without Reverse Transcription Polymerase Chain Reaction (RT-PCR)/Gene Xpert reports were excluded from the survey.
Antibodies binding to the receptor binding domain (RBD) of the surface glycoprotein/spike (S) protein of SARS-CoV-2 can neutralize the virus3-5 The antibody test kit utilized at RGCIRC (VITROS Immunodiagnostic Products Anti-SARS-CoV-2 IgG) is based on the high throughput automated Chemiluminescence
Immunoassay (CLIA) technology and the antibodies tested are those produced against the S-protein of SARSCoV-2. It is an immunometric test utilizing ECi/ECiQ, 3600, 5600/XT 7600 system with incubation time 37mins, time to first result 48mins and an intravenous serum sample of 20 μL tested at 37°C. Positive Percent Agreement to PCR of 90.0% and 100% clinical specificity (95% CI: 99.1–100.0%) are additional features6
It describes values<1AU as non-reactive, those between 1-1.46AU as providing low/inadequate levels of immunity, those between 1.46-18.45AU as moderate levels of protection and values above 18.45AU as providing high levels of protection.
Data was collected at three time points. T1, T2 and T3 at 1-2 months, 3-4 months and 6-7 months Post-development of first COVID-19 symptom/positive RTPCR test whichever was earlier, from the same cohort of HCW. IgG tests were repeated prior to vaccination at 8-9 months (T4) in the small subset of HCW who had contracted the disease in May/June 2020. The HCW then partook the nationwide free vaccination drive for HCW initiated on 15 January, 2021 (beginning 8.5 months after our index case) and their antibody levels could be tested for variable periods of time depending on the time elapsed from development of first symptom to first dose of vaccination.
Statistical Analysis : All continuous/quantitative variables are expressed as mean ± Standard deviation while categorical/qualitative variables are expressed as numbers and percentage. Microsoft Excel 2010 (Microsoft Corp., Redmond, WA, USA) was utilized for Descriptive statistics and MedCalc software for Boxwhisker plots, trendlines and trend-areas. P<0.05 was considered statistically significant.
OBSERVATIONS
Demographic parameters: Out of the 214 respondents,164 (76.64%) belonged to 20-40 years age group, 45(21.03%) in the 40-60 years age bracket, 3 (1.40%) in more than 60y bracket and 2 (0.94%) in <20 years bracket.129 (60.28%) of the COVID-19 infected HCW are females and 85 (39.72%) are male.
Mean IgG antibody titres with standard deviation at 4 time-points have been tabulated (Table 1).
We collected 304 readings from 214 HCW. 137 HCW had their titres measured at one time point only, 52 HCW had their titres examined at only 2 time points. 21 HCW underwent serological test at only 3 time points (18 HCW got their IgG titres measured at T1, T2 as well as T3 (Fig 1), another 3 HCW at T2, T3 and T4) and only 6 HCW had their IgG-titres tested four times in 9 months. None of the surveyed HCW had any symptoms suggestive of re-infection in the
Vol 120, No 12, December 2022Journal
of the Indian Medical Association
34
Table 1 — Summary statistics for Health Care Workers at 4 time points (CI=Confidence Interval; T1: 1-2 months; T2: 3-4 months; T3:6-7 months; T4:8-9 months)
entire study period.
117/214 HCW got their IgG antibody titre tested at 1-2m. 3 months had already elapsed since the institutional index case when the study commenced in August 2020 and hence, 97 HCW missed the T1 time slot of 1-2m. The mean IgG antibody titre was 11.13±8.6AU
125/214 HCW got their IgG tested at 3-4m.5HCW resigned and 85 HCW got vaccinated before they could complete 3-4 m. The mean IgG-titre was 9.68±8.9AU
41/214 HCW got their IgG antibody levels tested at 6-7m post infection. Another 2 HCW resigned between T2 and T3 (total 7 resignations out of 214 at 6-7m post infection) while 166 HCW got vaccinated before they could complete 6-7 months postinfection. The mean IgG-titre was 8.35±5.9 AU.
Only 22 HCW completed 8-9 months Post-Infection before they got vaccinated. Their antibody levels tested at 8-9m Post-Infection had a mean titre of 7.87±4.4 AU.
The lowest titre at all time points was 0 while the highest titres were 46.8 AU, 56.5 AU, 23.4AUand 17.4AU at 1-2m, 3-4m, 6-7m and 8-9m, respectively.
The box plots depict the median (middle line) and first and third quartiles (boxes), while the whiskers show 1.5 times the Inter Quartile Range above and below the box. There were 3 outside values/inner fences (values smaller than the lower quartile minus 1.5 times the interquartile range or larger than the upper quartile plus 1.5 times the interquartile range) at T1, one at T2 and none at T3 and T4. There was one far out value/ outer fence (value smaller than the lower quartile minus 3 times the interquartile range, or larger than the upper
quartile plus 3 times the interquartile range) at both T1 and T2 but none at T3 and T4 (Fig 2).

The Standard Deviation at 1-2m and 3-4m was much higher (accompanied by skewed distribution and kurtosis)than that at 6-7m and 8-9m (bell-shaped Gaussian data-distribution).
DISCUSSION
When time, resources and patient-compliance are of exponential essence, selecting the right medical diagnostic test is of utmost importance. Out of diverse antibody isotopes with differential neutralization capacity we chose to focus on IgG directed against RBD-spike protein because these are not just binding but also neutralizing in nature depending upon their plasma levels and a simple, reliable, quantitative immunometric test is available to gauge IgG-titres7 Although it is known that time to seroconversion ranges from 11-22 days depending on severity of illness and IgG-titres peak at 21-40 days post appearance of first symptom and thereafter decline8,9, it is unknown for how long protective IgG-titres last. Long, et al have reported that the IgG levels in 93.3% of asymptomatic and 96.8% of symptomatic COVID-survivors declined during the early convalescent phase by 71.1% and 76.2% respectively compared to acute stage levels (3.4 and 20.5 units respectively) and that 40% of asymptomatic and 12.9% of symptomatic individuals became seronegative for IgG in the early convalescent phase10. Their study ends in the early convalescent phase (2months post first symptom) while we followed up our HCW (all of whom were symptomatic) for maximum 9 months into the convalescent phase. The
Vol 120, No 12, December 2022Journal of the Indian Medical Association
Art i c l e no : 370/ 2021 Take hom e me s s ageOva r i an cance r s are rare in paed i a t r i c age g r oups . Mu itl d i s c i p il na r y 35
SIREN study, steered by Public Health England (PHE), reported that corona-survivors develop antibodies that provide 83% protection for at least five months duration11. Another two studies report detectable IgGtitres at 3 and 5 months post-exposure, respectively12,13. We have observed moderate IgG antibody titres in 17/22 (77.3%) HCW even after 9months of developing the first symptom/ positive RTPCR test.
Immunity against SARS-CoV-2 is not binary, albeit it is graded. Although the mean IgG-titres progressively declined over 9 months (from 11.1 to 7.9AU) the values were still in the moderate immunity range (4.62-18AU) in our patients. On the face value,clinical implications of this decline for the concerned HCWs are insignificant as they still enjoy moderate levels of protection at the end of 9months. Of concern is the large Standard Deviation at T1 and T2, indicating that individual HCW have nil to low levels of protection (<4.62AU) making them vulnerable although the subset as a whole has moderate levels of protection. 20.5% HCW at 12months (IgG titre<1=10/171 HCW; IgG-titre 1-4.62 AU= 14/171 HCW), 34.7% of HCW at 3-4 months, 31.7%HCW at 6-7m(4/41 IgG-titre<1; 9/41 with IgGtitre 1-4.62 AU) and 22.73% HCW at 8-9m (IgGtitre<1=1/22; IgG-titre 1-4.62AU=4/22HCW) failed to develop protective levels of IgG.This underscores the importance of serological testing to discover and pinpoint those 1/3rd-1/5th patients with low IgG-titres who may suffer from antibody dependent
enhancement15 and concomitantly may lower their protective measures due to a false sense of security (Peltzman effect)16
The detailed sequential IgGtitres in 18 HCW have been plotted as trendlines (Fig 1).


5 HCW displayed a falling trend over the 3 time points with decay in IgG-titres as expected. But the fall in IgG-titres was too steep (18.2<5.52<4) and cannot be accounted for only by exponential decay and may be attributable to convalescent plasma donation by this HCW
4 HCW showed a rise at T2 followed by a fall at T3 (rhomboid pattern) attributable to a delayed IgG-peak at 3-4m instead of 1-2m.
7 HCW showed a fall at T2 followed by a rise at T3 (bowtie pattern). Fall at T2 is expected as per the exponential decay model. But the rise at T3 maybe explained by subclinical infection/anamnestic response
Vol 120, No 12, December 2022Journal of the Indian Medical Association
Fig 1 — Box-whisker plotsdepicting distribution of IgG-titres at four different time points
36
Fig 2 — Trendlines depicting IgG-titres over time
1 HCW failed to develop any antibodies at all three time points. This maybe due to a humoral immune system deficiency, accompanied by compensatory heightened T-cell immunity which enabled this individual to recover from COVID-1917.
1 HCW showed a rising trend in antibodies at all three time points. Multiple subclinical exposures maybe responsible for this paradoxical rising IgG-titre trendline.
Declining IgG-titres in HCW signify the natural course of this disease. Rising/nearly constant IgGtitres at successive time-points can be explained by re-exposure to SARS-CoV-2 with subclinical infection, akin to a booster dose of vaccination.
An upslope between points T1 andT2 in one HCW may be countered by a downslope between points TI and T2 in another HCW. The vector sum of these individual undulating vectors may hence be a straight line. To demonstrate this we divided the 18 HCW into 3 strata, first strata was rhomboid (low-high-low IgG-titres at T1-T2-T3), the second was bow-shaped (high-lowhigh IgG-titres at T1-T2-T3) and the third was a rightangled triangle; hypotenuse sloping down from left to right; steadily declining IgG-titres). Stacking would give a false impression of antibody levels remaining fairly constant with elapsed time (Fig 3). Hence, the product of “IgG-titre numerical value” and the “time duration in months for which those titres lasted” is a superior measure of antibody levels in a particular HCW since it also takes into consideration the upslopes and downslopes in the IgG-titre curves plotted against time. We shall denote this by the term “Effective Immunity” (EI) which is a composite figure facilitating comparisons between different individuals (Table 2).
The fact that 28/41 respondents still had moderate/high IgG-titres 6-7 months Post-Infection indicates that immunity triggered by natural infection to COVID19 is more robust than imagined earlier. The fact that 22 out of these declined to take the free vaccines being provided to them and had their antibody titres tested at 8-9months indicates that they strongly believe that their IgG-titres would remain maintained at moderate levels in a gently undulating fashion till such time the pandemic lasts/herd immunity is produced. A wait and watch policy has been adopted by many HCW amidst apprehensions of adverse reactions to the vaccine. Some desire to derive full benefit from their preexisting immunity till it lasts, as

Fig 3 — Stacked area chart with IgG-titres clustered into three strata based on similar time-trends

indicated by periodic IgG-titres and receive the vaccine shot once the titres fall below 4.62AU.
No vaccination guidelines exist for COVID-survivors. We recommend that the initial dose/ first shot must be taken by all individuals irrespective of history of previous infection/ antibody status. It is unclear whether the second dose should be administered to HCW who have recovered from COVID-19. Their naturally acquired active immunity is at par or even more robust than the artificially acquired active immunity from the first dose of vaccination. The first dose of vaccination in COVIDsurvivors is akin to the second/booster dose of vaccination prescribed for exposure naïve people. Hence bimonthly serological tests gauging IgG directed at the RBD-antigen are required before the second dose to postpone it till a drop in IgG-titre corresponding to mild levels of protection is observed.
UK-based investigators utilized the Gamma Exponential Decay Model (GEDM) and gamma plateau model (GPM) for predicting longevity of antibody
IgG-titre
3-
Vol 120, No 12, December 2022Journal of the
Association
Indian Medical
Table 2 — Trends in IgG-titres over time and Effective Immunity (EI=Effective immunity; IgG-1=IgG-titre at 1-2months post first symptom; IgG-2=
at
4months post first symptom; IgG-3= IgG-titre at 6-7months post first symptom; IgG4= IgG-titre at 8-9 months post first symptom; Vac=Vaccinated)
37
response to SARS-CoV-2 and reported that the halflives for the nucleoprotein, RBD and spike protein antibodies were 60 days, 102 days and 126 days, respectively under GEDM18 . The half-life of RBD antibodies was 110 days while that of spike protein antibodies was projected as 364 days under the GPM, which assumes long-lived antibodies.This implies that at 126 days post infection the IgG-titres should have reduced to half the original values as per GEDM and halved at 364 days post infection as per the GPM. The results of our study demonstrate that at 274 days post first-symptom/RTPCR positive result, the mean IgG-titre was 7.87AU which falls in the moderate protection range. This is not half of the mean titres recorded at 1-2 months post infection (11.13AU) which implies that the GPM is a better predictor of IgG longevity while the GEDM under estimates the halflife of IgG.
The main strength of our survey is its conduction on HCW in a hospital setting who bear the brunt of SARSCoV-2 exposure as an occupational hazard and would benefit from results and transmit the benefit to the society as a whole in terms of better-organized deployment of healthcare workforce in operation theatres, emergency wards and COVID-intensive care units based on their IgG-titres. Also, the results are reproducible since blood-samples have been preserved in the institutional biorepository for future reference. The main limitation of our study is that all HCW could not be followed for 6-7 months after first symptom as initially planned, owing to the nationwide vaccination drive.
CONCLUSION
Adaptive active immunity acquired through natural infection may last for at least 9 months postinitial exposure and lies in the moderate protection range in 77% HCW. Moderate levels of protection were observed by our immunometric test at 9 months which can be extrapolated to vaccination and immunity passports. Vaccine can be used as a booster dose/second exposure in all COVID-survivors especially those with low IgG-titre. Periodic quantitative IgG-titre based serological tests can help guide timing of second shot of vaccination.
REFERENCES
156% in Delhi have Covid antibodies: Serosurvey of 28,000 people. Available from: https://www.msn.com/en-in/news/ other/56-in-delhi-have-covid-antibodies-serosurvey-of-28000-people/ar-BB1dktnF. Last accessed 2021 Mar 30.
2Vaccination drive: 49% turn up for shots in Delhi, walk-ins. Available from, https://timesofindia.indiatimes.com/city/delhi/ vaccination-drive-49-turn-up-for-shots-in-delhi-walk-ins-fillabsentee-slots/articleshow/80355721.cms. Last accessed 2021 Mar 30
3Stadlbauer D, Amanat F, Chromikova V — SARS-CoV-2 Seroconversion in Humans: A Detailed Protocol for a Serological Assay, Antigen Production, and Test Setup. Curr Protoc Microbiol 2020; 57(1): 100-7.
4Espejo AP, Akgun Y, Al Mana AF, Tjendra Y, Millan NC, GomezFernandez C, et al — Review of Current Advances in Serologic Testing for COVID-19. Am J Clin Pathol 2020; 154(3): 293-304.
5Premkumar L, Segovia-Chumbez B, Jadi R, Martinez DR, Raut R, Markmann A — The receptor binding domain of the viral spike protein is an immunodominant and highly specific target of antibodies in SARS-CoV-2 patients. Sci immunol 2020; 5: 48-59.
6Instructions for use CoV2G. Available from: Instructions for use CoV2G VITROS Immunodiagnostic Products Anti-SARSCoV-2 IgG Reagent Pack 619 9919 - Bing. Last accessed 2021Mar 20.
7Noval MG, Kaczmarek ME, Koide A — Antibody isotype diversity against SARS-CoV-2 is associated with differential serum neutralization capacities. Sci Rep 2021; 11(1): 553843. DOI: 10.1038/s41598-021-84913-3.
8Marklund E, Leach S, Axelsson H, Nyström K, Norder H, Bemark M, et al — Serum-IgG responses to SARS-CoV-2 after mild and severe COVID-19 infection and analysis of IgG non-responders. PloS one 2020; 15(10): e0241104.
9Adams ER, Ainsworth M, Anand R, Andersson MI, Auckland K, Baillie JK— Antibody testing for COVID-19: a report from the National COVID Scientific Advisory Panel. WellcomeOpen Res 2020; 5: 139-56.
10Long QX, Tang XJ, Shi QL, Li Q, Deng HJ, Yuan J. Clinical and immunological assessment of asymptomatic SARS-CoV-2 infections. Nat Med 2020; 26:1200-4.
11Hall V, Foulkes S, Charlett A, Atti A, Monk EJM, Simmons R — Do antibody positive healthcare workers have lower SARSCoV-2 infection rates than antibody negative healthcare workers? Large multi-centre prospective cohort study (the SIREN study), England: June to November 2020. medRxiv 2021.01.13.21249642; doi: https://doi.org/10.1101/ 2021.01.13.21249642
12Wajnberg A, Amanat F, Firpo A, Altman DR, Bailey MJ, Mansour M, et al — Robust neutralizing antibodies to SARSCoV-2 infection persist for months. Sci 2020; 370(6521): 1227-30.
13Seow J, Graham C, Merrick B, Acors S, Steel KJA, Hemmings O — Longitudinal evaluation and decline of antibody responses in SARS-CoV-2 infection. Nat Microbiol 2020. doi: 10.1038/s41564-020-00813-8
14Edridge A — Coronavirus protective immunity is short lasting. medRxiv, doi:10.1101/2020.05.11.20086439 (2020).
15Iwasaki A, Yang Y — The potential danger of suboptimal antibody responses in COVID-19. Nat Rev Immunol 2020; 20: 339-41.
16Trogen B, Caplan A — Risk Compensation and COVID-19 Vaccines. Ann Int Med 2021; https://doi.org/10.7326/M208251
17Sekine T, Perez-Potti A, Rivera-Ballesteros O, Strålin K, Gorin JB, Olsson A, et al — Robust T cell immunity in convalescent individuals with asymptomatic or mild COVID-19. Cell 2020; 183(1): 158-68.
18Grandjean L, Saso A, Torres A, Lam T, Hatcher J, Thistlethwayte R — Long-Term Persistence of Spike Antibody and Predictive Modeling of Antibody Dynamics Following Infection with SARS-CoV-2.(2020). medRxiv. https://doi.org/ 10.1101/2020.11.20.20235697, https://www.medrxiv.org/ content/10.1101/2020.11.20.20235697v1
Vol 120, No 12, December 2022Journal
of the Indian Medical Association
38
Original Article
Clinico-demographic Profile and Outcome of Scrub Typhus in North Eastern State of India
Soma Saha1, Dipankar Prakas Bhaumik2, Susmita Deb3
Scrub typhus is a form of bacterial Zoonosis caused by Orintia tsutsugamushi usually presents as Acute febrile illness with multiorgan involvement as a complication and is associated with significant mortality. This study aims to document the clinico-demographic profile, laboratory parameters and complication of Scrub Typhus in North Eastern Hilly State of Tripura with background of tropical climate.
This retrospective study was conducted at Tripura Medical College, including 42 patients admitted with acute febrile illness between June, 2020 to December, 2021 during the era of COVID-19 Pandemic. The diagnosis was established by Rapid card test, Lateral Flow Metry Assay (LFA) followed by confirmation through IgM, ELISA test and pathognomic Eschar where feasible. The clinlical, demographic and laboratory profile were documented and analysed.
Post rainy season and people from rural area with farming background were mostly affected population. Apart from Fever and Flu like symptom, respiratory and Gastrointestinal (GI) symptoms were more prominent feature. Pathognomic skin lesion eschar was found in maximum cases followed by shortness of breath, GI involvement and Renal failure. Acute Respiratory Distress Syndrome (ARDS), Acute Kidney Injury (AKI), Hepatic encephalopathy and meningitis were the serious complications.
While evaluating cases of acute febrile illness with multiorgan involvement clinician should have high index of suspicion for Scrub typhus specially resource poor areas of North Eastern (NE) state of India so that early detection and time bound intervention may help to reduce the mortality.
[J Indian Med Assoc 2022; 120(12): 39-43]
Key words :Febrile illness, Scrub Typhus, Zoonosis.
Scrub typhus is a public health problem causing severe morbidity and mortality. It is caused by Orientia tsutasugamushi (O tsugtsugamushi) can result in severe multiorgan failure with a case fatality rate up to 70% without appropriate treatment1. It is the oldest vector born Zoonotic disease now re emerging with new trends worldwide specially in the endemic areas2 Antigenie heterogenicity of O tsugtsugamushi may be the reason behind the generic immunity which causes re-infection. Clinical picture consist of high grade fever, severe headache, apathy, myalgia and generalised lymphadenopathy. A maculopapular rash may appear first on the trunk and then on extremities. Eyelid edema and facial edema are also prominent feature. Black Eschar may be seen at the site of inoculation. Patients may develop complication like interstitial pneumonia, ARDS, HE, AKI, meningoencephalitis, and myocarditis 3-5 Diagnostic approaches for Scrub Typhus are based on detection of antibody in the serum
Department of Medicine, Tripura Medical College and DR BRAM
Teaching Hospital, Agartala, Tripura 799014
1MBBB, DNB, Associate Professor and Corresponding Author
2MBBS, MD, Associate Professor
3MBBS, MD, Senior Resident
Received on : 05/03/2022
Accepted on : 02/06/2022
Editor's Comment :
Scrub typhus is a bacterial zoonosis caused by Orintia tsutsugamushi presents as an acute febrile illness with multiorgan involvement and is associated with high mortality. A simple Rapid diagnostic test Lateral flow assay can assist in the early diagnosis of the disease especially in the resource-poor difficult areas of Northeastern states so that early initiation of treatment can prevent life-threatening complications and reduce mortality.
of patient suspected suffering from Scrub typhus. The mainstay in Scrub-Typhus diagnostics remains serology. The gold standard of diagnostic test is Indirect Immunofluorescent Antibody (IFA) test. Indirect immunoperoxidase (IIP) reduces cost of a fluorescent microscope by substituting peroxidase for fluorescein6 Weil- Felix OX-K agglutination reaction are the oldest test which lacks of specificity or sensitivity. Lateral flow assay, SD – Biolin rapid card test and detection of IgM antibody to Scrub Typhus by ELISA are also used in resource poor settings of difficult areas of India with high specificity and low sensitivity 18. Early detection and treatment can reduce the burden of the disease. It is the general conception that in the state of Tripura Scrub Typhus is not seen, though the geotopology, climate, humidity and vegetations are favorable for the growth of tick, the vector of the O
Vol 120, No 12, December 2022Journal of the Indian Medical Association
39
tsugtsugamushi. As in the recent past we are encountering considerable number of patients being diagnosed as Scrub Typhus, we feel, it is relevant to study scientifically the characteristics of the patients. It will help to generate awareness among the health service providers hence forth of interest for the people of the beautiful state of Tripura.
MATERIALS AND METHOD
This is a retrospective observational study carried out in 2021 in the Department of General Medicine Tripura Medical College and Dr BRAM Teaching Hospital , Tripura. The case records of 42 Scrub Typhus antibody positive by rapid diagnostic test Lateral Flow Assay (LFA) subsequently confirmed by detection of IgM by ELISA admitted in the Department of General Medicine of TMC & Dr BRAM Hospital, in one and half year (1st June, 2020 to 31st December, 2021) were collected and analyzed. The demographic profile, Age, Sex. Gender, occupation and clinical features, examination findings, laboratory results, complications and outcome in the form of discharged or death were documented in pre-designed proforma.
Inclusion Criteria :
(1)Fever more than 3 days.
(2)Age more than 18 years.
(3)Positive serology for Scrub Typhus.
(4)With or without complication.
Exclusion criteria :
(1)Patient with other established causes of fever (Infectious or Non infectious)
(2)Negative serology for Scrub Typhus. The study was conducted with due permission from the appropriate authority of Hospital and after Clarence from the Institutional Ethical Committee.
RESULT
Socio-demographic Profile :
The middle aged group of people between 31 to 50 years 60.05% ( n=29) were mostly affected population in our study followed by young people below the age of 30, 21.43% (n=9) and older age group 9.52% (N=4). Male were affected more 61% compared to female population 31% (Table 1). The minimum and maximum age of the patient were 21years and 78 years respectively with a mean age of 43.6±12.2 years. The Male to female ratio was 2.23 : 1. Most of the affected people were from rural and hilly areas of Tripura with farming as occupation in the background. Maximum no cases were reported from South district of Tripura followed by Sepahijala
and Gomti District the main harvesting areas of Tripura. Most of the cases were observed in Rainy season that is July to October (Table 1).
Clinical Profile :
All the study population (n=42) presented with fever with average duration of 5.52±2.07 days (Table 2). Maximum temperature noted was 104 oF 23.08% (n=10)(Table 2). The most common symptom in our study were headache (81%) and respiratory symptom in the form of Cough (73.8%) and Breathlessness 16.7% followed by Body ache ( 64%), Arthralgia (64%) and GI symptom (64%). Only six (14.29%) patient had Central Nervous System (CNS) involvement in the form of altered sensorium of which two (33.33%) of them had seizure during their hospital stay (Fig 1). Among the six (14.3%) patient presented with Icterus two (33.33%) of them developed Hepatic Encephalopathy.
The most common clinical examination findings Eschar was observed in 26 (61.9%) patients in our study followed by Hepatomegaly 42.9% (n=18), Anemia 28.6% ( n=12), Skin rash 19.5% (n=8), Eyelid edema 14.3% (n=6) and Jaundice14.3% (n=6). Four patient (66.67%) developed acute hepatitis, Two (33.33%) of them developed hepatic encephalopathy
Table 1 — Showing Demographic profile (n = 42) Parameters Number Precentage (%) Age group (in Years) : Group I (20-30 years)4 9.52% Group II (31-50 years)29 69.05% Group III (>50 years)9 21.43%
Gender : Male29 69.0% Female13 31.0% Area of Distribution (District wise) : South District13 31.0% West District10 23.8% North District0Gomati6 14.3% Dhalai1 2.4% Sipahijala511.9% Khowai614.3% Unokoti1 2.4%
Table 2 — Showing pattern of fever (n = 42)
Parameters Number Percentage (%) Fever Present42 100% Absent0Temperature Average temperature – 102.57 ± 0.99 oF (in oF)101 oF511.9% 102 oF1842.9% 103 oF921.4% 104 oF1023.8%
Duration of fever Average duration of fever – 5.52±2.07 (in days)3-4 days13 31.0% 5-6 days18 42.9% >7 days11 26.2%
Vol 120, No 12, December 2022Journal of the
Indian Medical Association
40
Fig 1 — Symptomatology of Scrub typhus
(Fig 2). Abdomainal Ultrasonography(USG) showed hepatomegaly in 23.81% (n=10), splenomegaly in 4.8% (n=2).There was no alteration of hepatic echotexture or obstructive features in USG except in two patients who showed periportal cuffing and increased echogenicity of liver. Chest radiography that is chest X-Ray postero anterior view done in all the cases (n=42), showed radio opacities in 64.41% (n=20), peribronchial thickening in 25.81% (n= 8) ARDS in 6.45% (n=2), pleural effusion in 3.22% (n=1) Lumber puncture were done in six patient who presented with altered sensorium. Amongst them only one (42.8%) had shown high protein and lymphocytic predominance in Cerebrospinal Fluid (CSF) examination. Computed Tomography with contrast were performed in six cases of suspected CNS involvement and was essentially normal study. Apart from sinus tachycardia no other significant abnormality
was found in Electrocardiography done in twenty patients. Urine routine and microscopic examination showed increased protein and Red blood cells in one case (2.38%)(Table 3).


Laboratory Parameter :
In laboratory parameter Anaemia was observed with mean of 10.83±1.54 followed by raised hepatic transamineses 99.996±8.96 for AST(Aspertate Aminotransferase) and 82.864±9.69 for ALT (Alanin aminotransferase). Total count ranges from 4100 to 18000 with mean of 8764.29±3095.85, with neutrophil predominance mean of 76.05±11.79. Alteration in kidney function also observed for urea mean 35.76±32.89 and creatinine 1.06±0.30. Electrolytes abnormality in the form of Hypontremia (n=4) 9.52% and hypokalemia also noted in our study (Table 3).
DISCUSSION
Scrub Typhus is a Zoonotic disease caused by Orientia tsutsugamushi, has wide range of serotypal variability due to the antigenic protein -56Da, TSA in the genous Orienta 5. The various type of clinical presentation, multiple organ involvement and case fatality may be duo to antigenic variability. The middle aged male were most affected group in our study like Varghese, et al, may be duo to outdoor activity in day time with an occupation of farming from the hilly areas of Tripura6. Maximum no of cases were observed in Rainy or extended Rainy season in the month of July to October due to the tropical climate of Tripura where rains continues even up to November7. This is the main
Table 3 — showing Laboratory findings (n = 42) Parameters Minimum Maximum Mean ± SD Hemoglobin 5.8013.00 10.83 ± 1.54 Total count 410018000 8764.29 ± 3095.85 Neutrofil4590 76.05 ± 11.79 Lymphocytes1050 19.79 ± 8.464 Eosinophil05 1.07 ± 1.50 ESR226844.62 ± 10.92 CRP0.05821.68 ± 15.27 Billirubin 0.062.10 1.09 ± 0.43 SGPT26246 99.98 ± 68.69 SGOT28235 82.86 ± 49.69 ALP130242175.26 ± 35.4 TP5.67.76.86 ± 0.45 Albumin2.16.8 3.54 ± 0.68 Urea21232 35.76 ± 32.89 Creatinine 0.702.00 1.06 ± 0.30 Urinary protein010.31 ± 0.47 Urinary RBC010.12 ± 0.32 Na+ 129149134.60 ± 4.41 K+ 2.94.83.6 ± 0.38 Mg+ 1.52.11.84 ± 0.15 [SD = Standard Deviation]
Vol 120, No 12, December 2022Journal of the Indian Medical Association
Fig 2 — Clinical signs of Scrub typhus 41
cultivating time for JOOM cultivations in the hills of Tripura. There are very few cases from the North Tripura probably due to lack of communication and difficult transport duo to the period of Lock down and Government regulation.
Eschar which is the pathognomic lesion for Scrub Typhus were found in 26 cases in our study corresponds with other Asian and Indian study8. The most commonest site of Eschar in the Inguinal, peri inguinal area followed by axilla and below the breast. It is very difficult to demonstrate Eschar in highly pigmented people because of its non itchy nature, so thorough clinical examination is required in suspected individuals in the endemic areas9
Almost all the cases presented with fever followed by headache, arthralgia, and myelgia which mimicked with other viral illness specially when the study was conducted during COVID-19 Pandemic period. Most prominent symptom was breathlessness in our study though less documented in other Asian study except in few North Indian study5,11. In the background of Pandemic it was difficult to differentiate the pulmonary involvement of Scrub Typhus from COVID 19. All the patient were admitted after screening through RT PCR and those developed respiratory complications were retested through RT PCR for COVID-19 on fifth day according to ICMR protocol. Interstitial pneumonia, bronchopneumonia and pleural effusion were the prominent respiratory findings which are similar to the other studies done in the sub Himalayan region14 Initial low oxygen saturation (SpO2) may be due to mild pleural effusion and Pneumonia which resolved with treatment. Severe form of respiratory complication ARDS also found in our study which correlates with other North Indian studies11
Second commonest involvement is GI system in our observation in the form of elevated Liver enzymes and anicteric hepatitis, though jaundice was not a prominent feature but different study described Scrub typhus as a commonest cause for acute febrile jaundice in the sub Himalayan region13.
Facial oedema and periorbital oedema were observed in few cases in our study is not very uncommon rather sizeable number of cases reported in other studies 10 . This oedema may be due to accumulation of fluid in the interstitial space after breeching of endothelial lining with perivasculitis10 Very few cases of Central Nervous System (CNS) involvement in the form of altered sensorium and seizure were noted, with a complication of meningitis in our study which is similar to other studies as well15
The important complications noted in our study were
AKI (Acute Kidney Injury), ARDS, hepatic encephalopathy and Meningitis. Most of the complications were due to delayed presentation or treatment initiation. one patient developed AKI which resolved with treatment in the second week though some studies in adult showed AKI in 12% to 22%16 Two of our patient who developed hepatic encephalopathy during hospital stay had a history of chronic alcohol intake so may be preexisting liver disease worsen with acute injury, though hepatic complication mentioned in studies by Vikrant, et al16
Leucocytosis with neutrophilic preponderance observed in our study though different Indian studies showed lymphocytic preponderance with thrombocyopenia17. Some studies from China showed lower rates of Thrombocytopenia 4.6% to 48.9%17 Elevated CRP in our study may be attributed to systemic inflammation. Low albumin in few patient may be duo to acute on chronic Liver failure.
Dyselctrolytemia may be duo to Fever and Dehydration which is mentioned in other studies also.
The limitation of our study is that the study was based on first detection of Scrub Typhus by Lateral flow assay which has got high specificity and low sensitivity in the absence of Standard diagnostic test like Indirect immunofluroscence assay. All the cases subsequently confirmed by IgM positivity by ELISA. However, a positive correlation of 97% between IgM ELISA and SD BIOLINE rapid test was reported in India18
In conclusion Scrub Typhus should be one of the important differential diagnosis while evaluating a patient with Acute Febrile Illness and multiorgan involvement specially in the North Eastern Region of India where Malaria is endemic. Tropical rain forest is one of the main source of vector larval mite for Rickettsial disease. Varied clinical presentation and low case fatality of Scrub Typhus in NE Region may be due to antigenic variability of O tsutsugamushi and recurrent exposure to the organism. Primary care physician should have a high index of suspicion for Scrub Typhus especially in resource poor setting of difficult areas of NE States so that early diagnosis and treatment can prevent severe complications and also will help in reduction of mortality due to Scrub Typhus.
REFERENCES
1A review of Scrub typhus (Orienta Tusugamushi and related organism): then, now and tomorrow. Tropical medicine and infectious disease 2018; 3-8.
2Indian journal of basic and applied medical research; Sept 2015; 4(4): 394-400.
Vol 120, No 12, December 2022Journal
of the Indian Medical Association
42
Vol 120, No 12, December 2022Journal of the Indian Medical Association
3Kim IS, Walker DH — Scrub Typhus. In: Guerrant RL, Walker DH, Weller PF, editors. Tropical infectious diseases: principles, pathogens and practice. Third ed: Elsevier Health Sciences 2011: 332-6.
4Paris DH, Shelite TR, Day NP, Walker DH — Unresolved problems related to scrub typhus: A seriously neglected lifethreatening disease. American Journal of Tropical Medicine and Hygiene 2013; 89: 301-7. https://doi.org/10.4269/ ajtmh.13-0064 PMID: 23926142
5Pal S, Sharma M, Kotian S, Juyal D, Singh A, Sharma N — Post disaster outbreak of scrub typhus in sub Himalayan region of Uttarakhand. J Acad Clin Microbiol 2016; 18: 95-9.
6Varghese GM, Raj D, Muliyil J — Epidemiology and risk factors of scrub typhus in South India. Indian J Med Res 2016l;144(1).
7Takhar RP, Bunkar ML, Arya S, Mirdha N, Mohd A — Scrub typhus; a prospective, observational study during an outbreak in Rajasthan, India. The National Medical Journal of India 2017; 30(2).
8Zhang M, Zhao ZT, Wang XJ, Li Z, Ding L, Ding SJ — Scrub typhus: Surveillance, clinical profile and diagnostic issues in Shangdong, China. Am J Trop Med Hyg 2012; 87: 1099-104. doi: 10.4269/ajtmh. 2012.12 0306.
9Kim DM,Won kJ,Park CY, Yu KD, Kim HS, Yang Ty, et al — Distribution of eschars on the body of scrub typhus patients: a prospective study. AM J Trop Med Hyg 2007; 76: 806-9
10Scheie HG. Ocular changes in scrub typhus. A study of 451 patients. Trans Am Opthamol Soc 1947; 45: 637-77.
11Wang CC, Liu SF, Liu JW, Chung YH, Su MC, Lin MC — Acute respiratory distress syndrome in scrub typhus. Am J Trop Med Hyg 2007; 76: 1148-52.
12Elsom KA, Beebe GW, Sayen JJ, Scheie HG, Gammon GD, Wood FC — Scrub typhus: A follow up study. Ann Intern Med 1961; 55: 785-95.
13Mokta J, Yadav R, Mokta K, Panda P, Ranjan A — Scrub typhus – The most common cause of Febrile Jaundice in a tertiary care hospital of Himalayan State. J Assoc Physicians India 2017; 65: 47-50.
14Abhilash K, Mannam PR, Rajendran K, John RA, Ramasami P — Chest radiographic manifestations of scrub typhus. J Postgrad Med 2016; 62: 235-8.
15Rana A, Mahajan SK, Sharma A, Sharma S, Verma BS, Sharma A — Neurological manifestations of scrub typhus in adults. Trop Doct 2017; 47: 22-5.
16Vikrant S, Dheer SK, Parashar A, Gupta D, Thakur S, Sharma A, et al — Scrub typhus associated acute kidney injury – A study from a tertiary care hospital from western Himalayan state of India. Ren Fail 2013; 35: 1338 43. doi: 10.3109/ 0886022X.2013.828257.
17Varghese G, Abraham O, Mathai D, Thomas K, Aaron R, Kanitha M, et al — Scrub typhus among hospitalised patients with febrile illness in South India: Magnitude and clinical predictors. J Infect 2006; 52: 56-60. doi: 10.1016/j.jinf. 2005.02.001.
18Kalawat U, Rani ND, Chaudhary A — Seroprevalence of scrub typhus at a tertiary care hospital in Andhra Pradesh. Indian J Med Microbiol 2015; 33: 68-72. doi: 10.4103/0255 0857.14831.
43 Ifyouwanttosendyourqueriesandreceivethe responseonanysubjectfromJIMA,pleaseuse the E-mail or Mobile facility. Know Your JIMA Website:https://onlinejima.com For Reception: Mobile : +919477493033 For Editorial:jima1930@rediffmail.com Mobile : +919477493027 For Circulation: jimacir@gmail.com Mobile : +919477493037 For Marketing:jimamkt@gmail.com Mobile : +919477493036 For Accounts: journalaccts@gmail.com Mobile : +919432211112 For Guideline:https://onlinejima.com
Original Article
Preparedness of Phase 1 MBBS Students for Self-directed Learning Process
Soma Gupta1, Alka Rawekar2, Md Quazi Tajuddin3
Self-directed learning is important for MBBS students to prepare themselves as lifelong learner. But a “spoonfed” school student needs to be sufficiently prepared to learn by SDL. In this study, the ability of the students to learn by SDL is measured along with evaluation of the reliability of as “Self-Directed Learning Instrument” (SDLI) as measuring tool. All willing students of the 1st phase MBBS curriculum (Batch 2020-21) were given a 20-item questionnaire known as “Self-directed Learning Instrument” (SDLI) to evaluate their learning abilities by SDL. A higher level of SDL is indicated by a higher score. A total of 247 students were included in the study. The result shows that students have poorest ability in Planning and Implementation domain (Mean: 3.9, variance: 0.26) whereas they are strongly motivated (Mean:4.3, variance: 0.37). SDLI score revealed that only 6 students need special care from faculties. Some (n = 81) needed observation and monitoring whereas majority of students (160, 64.8%) were supposed to be able to learn of their own. The method was found to be reliable as Cronbach’s alpha for all domains were over 0.70. The students with poor ability to learn by themselves can be identified in the very beginning of the session who can be given special attention and facilitated to grow as lifelong learner.
[J Indian Med Assoc 2022; 120(12): 44-7]
Key words :Self-directed Learning (SDL), Self-directed Learning Instrument (SDLI), Domain wise assessment.
The introduction of Competency-based Medical Education (CBME) Curriculum in India has endorsed many new concepts, one of which is SelfDirected Learning (SDL). In SDL the students are expected to take the initiative to diagnose their learning needs, formulate their learning goals, identify resources for learning and evaluate their learning outcomes1. Thus, SDL is primarily a higher order active learning technique where onus of learning lies with the students. Dedicated time has been allotted to SDL in CBME curriculum in each specialty. As SDL is a newly introduced method of learning, the implementation of SDL is facing some challenges. One of such problem is that medical students in Phase 1 of their MBBS curriculum are in the transition phase from their school life. They depend too much on teachers and expect some sort of “spoon feeding.” A study by Sari D, et al2 had reported that students are very much dependant on teachers. So, without active involvement of faculties, students can rarely develop the skills of becoming selfdirected learner. Hence it is very much important to understand their preparedness to study by SDL.
Department of Biochemistry, NRS Medical College and Hospital, Kolkata 700014
1MD, Professor and Head and Corresponding Author
2MD, Professor and Head, Department of Physiology, Jawaharlal Nehru Medical College, Datta Meghe Institute of Medical Sciences, Sawangi, Maharashtra 442004
3MD, Demonstrator
Received on : 29/09/2022
Accepted on : 30/10/2022
Editor's Comment :
To implement self-directed learning successfully, the preparedness of MBBS students should be initially assessed by SDLI. The limitation of individual students, if identified and taken care of, then only they will be able to carry out their role as “Life long learner,” as mentioned in CBME.
Garrison developed a model3, where self- motivation, self - monitoring and self-management were demonstrated as components of SDL. In addition to these components, communication is an important learning process for the medical profession, which is also related to Self-directed learning process. The inner drive and external stimuli motivating a learner to learn and to take responsibility for own learning is known as learning motivation. The ability of setting learning objectives independently is called planning, Achievement of learning goals using appropriate learning strategies and resources is called implementation. The ability to evaluate one’s learning process and outcome is self-monitoring. When learners interact with each other to promote their own learning, that is known as Interpersonal communication.
The measurement of ability of the students to learn by SDL is a challenge. Cadorin, et al compared several tools for the same and recommended superiority of “Self-Directed Learning Instrument” (SDLI) to evaluate SDL abilities4. SDLI was developed by Shen, et al5 for mainland Chinese Nursing students. No such tool for
Vol 120, No 12, December 2022Journal of the Indian Medical Association
44
medical students is still available. So, the reliability of this tool in a Medical College set up needed to be established.
In this background, this study is conducted to assess the ability of the students to learn by SDL in a Government Medical College of West Bengal. The specific objective of the study is to find out whether the Phase 1 MBBS students are prepared to learn Biochemistry by self-directed learning activity. The reliability of measuring tool (SDLI) was also evaluated in the current study setting.
MATERIALS AND METHODS
This cross-sectional study was conducted in a Government Medical College of West Bengal in December, 2021. All students of the 1st phase MBBS curriculum were asked to bring their own smartphone/ laptop with internet connection during one fixed date of Biochemistry class of one hour. They were introduced briefly to the objectives and the methodological workflow of the study by an interactive lecture. All willing students were included in the study. Those students, who were absent on that day were excluded for the study.
Then they were given a questionnaire prepared in google form. The first part consisted of questionnaire on personal data. In the next part, they were given 20 items of SDLI. The participants were asked to select their response from a Likert scale of 5-point rating: “strongly disagree,” “disagree,” “neutral,” “agree,” and “strongly agree.” Estimated time to respond to the entire questionnaire was approximately 30 minutes. Research has been proved that Computer based methods are better than paper-based questions. It solves the problem of incomplete data or missing data by making the answer field mandatory. Retrieval of data in excel form is automatic and thus statistical analysis becomes easy. Electronic versions of questionnaires have shown consistent test-retest reliability of data. Due to all these reasons, though students were present physically, electronic version was used to gather survey data.
“Self-directed Learning Instrument (SDLI) is a validated tool composed of 20 items questionnaire, containing four domains. First domain is “learning motivation.” which is defined as the inner drive of the learner as well as external stimuli motivating one to learn and to take responsibility for one’s learning (first 6 questions state, I know what I need to learn; Regardless of the results or effectiveness of my learning, I still like learning; I strongly hope to constantly improve and excel in my learning; My successes and failures inspire me to continue learning;
I enjoy finding answers to questions; I will not give up learning because I face some difficulties).
The next domain is “Planning and implementing” (Question No. 7 -12 stating I can proactively establish my learning goals; I know what learning strategies are appropriate for me in reaching my learning goals; I set the priorities of my learning; Whether in the clinical practicum, classroom or on my own, I am able to follow my own plan of learning; I am good at arranging and controlling my learning time; I know how to find resources for my learning). “Planning and implementing” is defined as the ability to independently set learning objectives, using appropriate learning strategies and resources in order to effectively achieve learning goals.
Third domain “self-monitoring,” is defined as the ability to evaluate one’s learning process and outcomes. It consists of Question No. 13 -16, stating I can connect new knowledge with my own personal experiences; I understand the strengths and weakness of my learning; I can monitor my learning progress; I can evaluate on my own my learning outcomes.
The fourth domain, “interpersonal communication” is defined as the ability of learners to interact with others to promote their own learning (Question No. 17-20 stating My interaction with others helps me plan for further learning; I would like to learn the language and culture of those whom I frequently interact with; I am able to express messages effectively in oral presentations; I am able to communicate messages effectively in writing).
All items of SDLI are positively stated. The respondent is asked to rate each item on a 5-point Likert scale ranging from 1 for “strongly disagree” to 5 for “strongly agree”. Thus, the total possible score on the SDLI ranges from 20 to 100. A higher level of SDL is indicated by a higher score.
The summary statistics were presented using frequencies with percentage for all response. SDLI score was calculated. No cut off value of the score is available in existing literature. It is mentioned that higher the score, better is the ability to learn. We supposed if students have low score like 2 in all responses the score becomes 40. If all students give 3 in all responses the score becomes 60. This is considered as the cut off as students have no positive response. If students give 4 in all responses, the score is 80. Students scoring 80 or above are considered as good learner and the score within 60 to 79 is considered as borderline score.
The reliability of the score in the present setting was determined by calculating Cronbach’s alpha coefficient.
Vol 120, No 12, December 2022Journal
of the Indian Medical Association
45
All data were analysed using SPSS software version 22.
The study was approved by Institutional Ethics Committee.
RESULTS
Out of a total 252 students (Current academic year: 250 & Old academic year: 2), 247 students (156 male, 91 female) took part voluntarily in the study.
In SDLI, the participants were asked to select their response from a Likert scale of 5-point rating: “strongly disagree,” “disagree,” “neutral,” “agree,” and “strongly agree.” The percentage of frequencies for all such responses are presented in Fig 1.
Mean score of each item of SDLI is presented in Table 1. Only 2% students had strongly disagreed (Response 1) with the statements and 3% only disagreed (Response 2). 14% of the students remained neutral (Response 3). Majority agreed with the statement (Response 4, 46%) and rest strongly agreed (Response 5, 35%). From item mean, it seemed that students have poorest ability in Planning and Implementation domain (Mean: 3.9, variance: 0.26) whereas they are strongly motivated (Mean:4.3, variance: 0.37).

Distribution of study population according to SDLI score is presented in Table 2. Though the cut off value was considered as 40, only 1 student was found below that score. 5 students were between 40 and 59. These 6 students need special care from faculties. A total of 81 students with score 60 to 79 need observation and monitoring. However, majority of students (160, 64.8%) scored above 80 and they are supposed to learn of their own. Table 3 shows Reliability statistics according to different domain expressed by Cronbach’s alpha. Highest Cronbach’s alpha was obtained for Planning and Implementation domain (0.852), followed by selfmonitoring (0.807), self-motivation (0.786) and interpersonal communication (0.708).
Table 1 — Mean score of each item of SDLI ItemStatementMean Noscore
Learning Motivation (LM)
4.4
1I know what I need to learn.4.1
2Regardless of the results or effectiveness of my learning, I still like learning.4.2
3I strongly hope to constantly improve and excel in my learning.4.6
4My successes and failures inspire me to continue learning. 4.44
5I enjoy finding answers to questions4.3
6I will not give up learning because I face some difficulties 4.42 Planning and Implementing (PI) 3.9
7I can pro-actively establish my learning goals.4.0
8I know what learning strategies are appropriate for me in reaching my learning goals.3.8
9I set the priorities of my learning.4.1
10Whether in the clinical practicum, classroom or on my own, I am able to follow my own plan of learning.3.9
11I am good at arranging and controlling my learning time.3.6
12I know how to find resources for my learning.3.8
Self-Monitoring (SM) 4.06
13I can connect new knowledge with my own personal experiences.4.1
14I understand the strengths and weakness of my learning.4.2
15I can monitor my learning progress.4
16I can evaluate on my own my learning outcomes.3.9 Interpersonal Communication (IC) 4.07
17My interaction with others helps me plan for further learning.4.3
18I would like to learn the language and culture of those whom I frequently interact with.4.3
19I am able to express messages effectively in oral presentations.3.6
20I am able to communicate messages effectively in writing4.1
DISCUSSION
CBME has emphasized that from teacher Centric Learning Process must be replaced by Student Centric Learning process. One of such approaches is Selfdirected learning, which is supposed to help the medical students to become lifelong learner and fulfil one of the goals of an Indian Medical Graduate3. But there are certain pre-requisites to learn successfully by Self-directed learning process. Students need to be focused and self-motivated. They should be able to assess themselves and thus monitor own learning process. They should plan according to their need and implement various methods of learning to achieve their goal. They need to communicate facilitators and other resource persons or their peers or seniors for necessary help. Medical students in first year are too young to have all these qualities.
Vol 120, No 12, December 2022Journal of the
Medical Association
Indian
Fig 1 — Frequency distribution of response in percentage
46
Table 2 — Distribution of study population according to SDLI score
Total score Male FemaleNo of Percen- Remarks of SDLI studentstage
Below 40101 0.4% Needs special care 40 - 594152% 60 -7944378132.8% Needs to observe and monitor 80 and1075316064.8% Can learn of above their own Total15691247100%
In this study, the maximum score in SDLI was for item 3 (Mean score: 4.6), that states, “I strongly hope to constantly improve and excel in my learning, which is similar to the study by Bhandari, et al (Score:4.7)6. The minimum score of 3.6 was given to item 11 and 19. Item 11 states that “I am good at arranging and controlling my learning time and Item 19 states that “I am able to express messages effectively in oral presentations.” Bhandari, et al also reported that students are poor in time management6. Moreover, they need to develop their interpersonal communication skills and express themselves orally. High score was also found in Item 4, stating, “My successes and failures inspire me to continue learning’ (Score: 4.44), and Item 6, stating “I will not give up learning because I face some difficulties.” (Score: 4.42). Bhandari, et al also got high score in Item 4. In fact, domain wise highest mean score was observed in learning motivation domain (Table 1). Mean scores of all individual items were above 4.1. Domain wise, lowest mean score was observed in Planning and implementation domain. Except Item 7 and 9, mean score of all individual items were below 4.
Self-monitoring domain shows that, they are aware of their strengths and weaknesses for learning (mean 4.2), can connect new knowledge with their personal experiences (4.1), can monitor own learning progress (Mean score:4). Unlike Bhandari, et al, mean scores of the interpersonal communication domain is better in our study. The only difficult part for them was expressing themselves orally (Mean score:3.6).
From Table 2; it is obvious that 2.4% students with SDLI score definitely need special guidance to learn by SDL. Another 32.8% students, with SDLI score between 60 to 79 needs to be observed and monitored. Rest 64.8% students can study of their own.
In the current situation SDLI was found to be reliable as Cronbach’s alpha for internal consistency of 4 domains were between .708 to .852, which is similar to Shen, et al (0.755 - 0.825)5.
Table 3 — Reliability statistics according to different domain
Name of DomainNo of itemCronbach alpha Learning motivation60.786 Planning and implementing60.852 Self-monitoring40.807 Interpersonal communication40.708
CONCLUSION
This study shows that SDLI is a reliable tool to assess the ability of phase 1 MBBS student to learn by Self-directed learning process. In the study majority of the students (64.8%) were found to learn of their own. Rest of the students need either some special guidance (2.4%) or monitoring by faculties (32.8%). Domain wise assessment shows students are motivated but they lack in planning and implementation of their abilities. Self-monitoring domain and interpersonal communication domains are more or less acceptable. Limitation of this study is that the result solely depends on self-assessment of the students. We have no scope to verify whether it is correct or not. The outcome of the study is we can identify the students with poor ability to learn by themselves in the very beginning of the session. Special attention can be given to them to overcome their difficulties and facilitate them to grow as lifelong learner.
ACKNOWLEDGEMENT
This study is done as a part of the project of 12th ACME conducted by Jawaharlal Nehru Medical College, Datta Meghe Institute of Medical Sciences (DU), Sawangi, Wardha, Maharashtra. Financial Support and sponsorship : Nil Conflicts of interest : There are no conflicts of interest.
REFERENCES
1Knowles M S — Self-directed learning: A guide for learners and teachers Englewood Cliffs, NJ: 1975; Prentice Hall.
2Sari D, Ashadi I — Graduate students’ attitudes & self-directed for lifelong learning in foreign language environment. Ling Tera 2020; 7(1): 38-50.
3Abd-El-Fattah SM: Garrison’s model of self-directed learning: preliminary validation and relationship to academic achievement. Span J Psychol 2010; 13(2): 586-96.
4Cadorin L, Bressan V, Palese A — Instruments evaluating the self-directed learning abilities among nursing students and nurses: a systematic review of psychometric properties. BMC medical education (2017); 17(1): 229.
5Shen WQ, Chen HL, Hu Y — The validity and reliability of the self-directed learning instrument (SDLI) in mainland Chinese nursing students. BMC Medical Education; 14(1): 108.
6Bhandari B, Chopra D, Singh K — Self-directed learning: assessment of student’s abilities and their perspective. Adv Physiol Educ 2020; 44: 383-6.
Vol 120, No 12, December 2022Journal of the
Indian Medical Association
47
Original Article
Online Classes Design and Delivery Based on Student Responses
Surya Prakasa Rao1, Sivakumar Vijayaraghavalu2
Background : COVID-19 has made a series changes in all system of life especially in education. As a result, education has changed dramatically with the distinctive rise of e-learning. The present study was aim to examine the preference and perception of MBBS student on newly introduced online live video classes.
Methods: An online questionnaire survey consisting of closed and open-ended questions on nine different categories such as accessing online video content, previous experience with online learning, interaction with video lectures addressing the content, duration, visualize, timings and screen size, perceived learning experience, the online content learning assessment methods and the experience with the online learning management system.Two hundred and thirteen undergraduate medical students were participating in this study. And it was conducted by the large medical institution in Andhra Pradesh.
Results: The e-learning methods were encouraged and its gaining popularity among the medical students and faculty. Our analysis shown 97.7% students were highly satisfied and 2.3% were not satisfied with online classes on comparison to the traditional methods of learning.
Conclusions: The teaching method and teachers support are the pivotal elements which enable online learning experience with a mutual relationship. Furthermore, the usefulness and acceptability of e-learning among medical students as a part of their curriculum is still not fathomed in medical education.
[J Indian Med Assoc 2022; 120(12): 48-56]
Key words :Medical Education, Assessment, Video lectures, E-learning, Feedback, Questionnaire.
The e-learning courses and lectures provide medical students with learning opportunities 9 . While devising the e-learning classrooms, one should consider the various situational, institutional and dispositional reasons for which students do not perform well in online classes1. The reasons can range from such as administrative problems, degree of interactivity, prior academic preparedness, technical skills, motivation level, time and support for learning, and availability of technical assistance designed to troubleshoot1,13. Assessment is a fundamental and essential issue in non-traditional learning environments. Clear understanding and the strategies for assessment are critical for both teachers and students in creating online environments for more effective teaching and learning22. Teachers need to identify and implement assessment strategies and methods appropriate for online learning. Teachers also need to be familiar with the potential of a variety of technology tools for monitoring student learning and improving their teaching effectiveness 4 . From the students’ perspective, good assessment practices can show
1MD, Dean & Professor, Department of Community Medicine, Narayana Medical College, Nellore, Andhra Pradesh 524002
2PhD, Professor and Head, Narayana Translational Research and Incubation Center, Narayana Medical College, Nellore, Andhra Pradesh 524003 and Corresponding Author
Received on : 15/12/2021
Accepted on : 06/09/2022
Editor's Comment :
Given the dynamics of online learning, it is common for students to feel distant and isolated during the course. One of the best ways to prevent medical students from feeling this way is by delivering personalized feedback. The teaching method and teachers support are the pivotal elements which enable online learning experience with a mutual relationship.
them what is essential to learn and how they should encourage learning; hence, engaging them in goaloriented and self-regulatory cognitions and behaviors.
There seems to be an urgent need to devise a dynamic design expected to lead to higher learning outcomes and more positive approaches toward learning4. The faculty engaged in online teaching should understand the concept of flexible pedagogy that takes into account the audience members, the set of appropriate instructional and technological tools and strategies, course cadence or pace, and creating and maintaining an online learning community, as well as valid and reliable assessment measures20.This type of online learning can be designated as negotiated learning, relying on using gradual community-building strategies, prior personal knowledge, and effective communication. This also creates a flexible pedagogy that takes into account the audience members, the set of appropriate instructional and technological tools and strategies, course cadence or pace and creating and maintaining an online learning student community,
Vol 120, No 12, December 2022Journal of the Indian Medical Association
48
of the Indian Medical Association
as well as valid and reliable assessment measures20.
The objective of this paper is to describe the methodology and measures undertaken to devise an effective, influential dynamic implementation of the online teaching and learning for medical students. The student involvement in this endeavour is engagement which is both structured/formal and unstructured/ informal following every week in the online environment.
The Learning Management System (LMS), Moodle, along with ZOOM video conferencing tools are used in this online teaching2. Students feedback is gathered through google docs/ questionnaire. Both sets of evidence of student engagement during the online lectures and feedback are used to help the researcher devise and adapt the course content and delivery methods to suit the varied needs and interests of students, as they emerge from the wide range of online communicative exchanges.
Online classes are assessed through a questionnaire designed under the following criteria
(A)Accessing the Online Content : i)Instrument : Mobile/ Tablet/ PC/ Laptop ii)Network : Poor/ Satisfactory/ Good/ Excellent iii) Audio-Visual Clarity : Poor/ Fair/ Good/ Excellent
(B)Online Experience :
i)Whether underwent any online courses: Yes/ No. If Yes whether it is assessment or learning or both ii)How long he/ she underwent the course:
(C)Lectures :
i) Content : Whether the content of the lecture is interesting to the participant? The content mainly consists of textual material in routine physical lectures; do the participants prefer the same format of Power Point slides? If yes, why? If no suggest
ii) Duration : What should be the duration of the lecture? Whether they prefer short lectures of 5-10minute duration followed by immediate assessment or a lengthy say 45 minutes of single lecture? What should be the optimal duration of an online lecture? Do you prefer varying duration of lectures for different subjects?
iii)Visuality: Whether the same teachers should teach or do they prefer other college teachers/ guests to teach them? Whether they prefer a complete view of the teacher or only the portrait view? Whether classroom background is acceptable or any other background? Whether they prefer the participant video at the administrator screen? Does the participant feel isolated in listening to the class?
iv)Assessment : Whether before beginning and after completion of the lecture, some form of assessment is preferred? Whether they would accept
immediate online question & answer session after the lecture? Do they mind asking questions specific to one or more participants (students)?
v)Timings : Whether participants are satisfied with the timings of the online (10.00 am to 12.30 noon)?Do you suggest any suitable timing? If yes suggest, if No
vi)Screen Size : Which screen size do you normally watch for lectures?
vii) Experience with Online Lectures: a)Acceptability: Cultural/ parental/ Peer/ b)Adaptability: Personal/ c)Learning experience: Enjoyable/ Lost personal touch
d)Preferability: Personal/ Priority e)Difficulty level: Personal/ Peer f)Suggestions if any:
(D)Learning Platform: a)Have you heard about this videoconferencing platform before: Yes/ No? b)Are you conversant with the facilities available in this platform?
i)Asking questions/ Raising hand : Yes/ No ii)Mute/ unmute : Yes/ No iii)Video sharing/ file sharing : Yes/ No Constructive feedback can transform a student’s learning experience. It encourages them to reflect, deal with criticism, learn better and stay motivated.
However, providing feedback in an online course is not as straightforward. In fact, the lack of meaningful feedback happens to be one of the biggest challenges online learners face. In a traditional classroom setting, instructors get more facetime with students, and this allows them to gauge students and offer frequent feedback accordingly. The same cannot be said about online classes because the interaction is limited.
Students learning through online teaching require continuous assessment by the teachers. Unlike the physical classes, during online teaching, teacher is devoid of assessment of the students understanding of the VL. Hence, students are enquired about the preferred method of learning assessment.
Research Questions :
(1)How are students accessing the online video lecture content at their homes?
(2)To what extent are students’ perceptions of online video lectures related to the content, duration, visuality, timings and screen size?
(3)What is their overall experience with the online video lectures specifically concerning the adaptability, acceptability, learning experience, preference and difficulty level?
Vol 120, No 12, December 2022Journal
49
(4)What would be their preference for learning assessment of online lecture?
(5)What is their experience with the online learning management platform?
Methods :
This mixed-method study employed an online questionnaire survey consisting of closed and openended questions on six categories. The methodology was chosen because the integration of qualitative and quantitative data would lead to having a better understanding of the research problem than either of each alone. Moreover, this mixed-method would allow better corroboration via triangulation and in-depth visualization of the research problem.
Participants :
The participant sample for this study was a purposeful selection of the I MBBS students who underwent the ten-day-long online video lectures during the COVID-19 lockdown period in Andhra Pradesh, India. The selection criteria included : (1) undergraduate students participated in the online video lectures on Anatomy, Physiology and Biochemistry during I MBBS. and (2) Medical teachers’ approval to explore the design of the online courses. All participant students were instructed to answer the online questionnaire and submit it in the stipulated period. Their participation was mandatory. However, those who are unable to access online video lectures are excluded from this questionnaire survey. A total of 213 out of 227 undergraduate students responded to the survey questionnaire.
Data Collection :
Data was collected using an online questionnaire survey. The online consisted of 33 questions that focused on six main categories: accessing online video content, previous experience with online learning, interaction with Video lectures addressing the content, duration, visuality, timings and screen size, perceived learning experience, the online content learning assessment methods and the experience with the online Learning Management System (LMS). Data from the focus group was collected by researchers in the form of digital notes.
Data Analysis :
The data collected from an online survey had both quantitative and qualitative responses. Basic descriptive statistics and graphical analysis were performed with quantitative data using percentages. Frequency and percentage were calculated for most of the questions to summarize the data. Furthermore, some basic cross tabulations were performed in order
to better understand the student’s response and the relationship between the variables. Data analysis of the qualitative portion followed the three concurrent flows of activity suggested by Miles and Huberman (1994): data reduction, data display and drawing conclusions. The three components were constantly interacting among themselves and with other stages in the process. Conclusions were drawn, reviewed and discussed as the data analysis process was ongoing. There was a constant interaction between the processes of data reduction, displays and verification of conclusions until final results were achieved (Fig 1).
Selection of the participants
I MBBS Student (Total 227)
Accessibility of online course
Include the student 213 out of 227
Exclude those unable to access online classes
Selection of subject (Human Anatomy, Human Physiology, Biochemistry)
Explore design online course
Preparation of Questionnaries on 12 categories
Data collection Data analysis
Research Write up
Fig 1 — Overview of Methodology
Results : QuantitativeAnalysis—
The present data relate to I MBBS students’ online lectures enrolling 250 students, offered during the compulsory home quarantine break as a part of COVID-19 control measures in a teaching and learning program at a large medical institution in Andhra Pradesh. Due to the suspension of physical attendance classes at medical colleges and to avoid large gathering of students, the institution offered online lectures. The teachers working at the institution developed their own teaching material for their online version of the lecture class while adapting the pedagogy to the specifics of Web-based teaching and learning. However, these teachers are a novice to online teaching. Hence, the author’s research interest in the dynamics of online teaching, learning, and assessment
Vol 120, No 12, December 2022Journal of the Indian Medical Association
50
of the Indian Medical Association
spurred the emphasis of this particular research area. Teachers are expected to teach a series of at least ten days entire lecture lessons to a whole class of students online. Students are prompted to attend the series of lectures between 10.00 am to 11.00 am and again 11.30 am to 12.30 noon everyday continuously for ten days. The students’ attendance ranged from190 to 220 participants at the online conference lectures.
Students are requested to answer the questionnaire dealing with self-reporting on a variety of factors that could impact teaching effectiveness, such as planning for instruction; support and respect from peers, students, and parents; a student needs based on which to design effective learning opportunities; assessment of student learning; being supervised; and overall satisfaction, both for students and teachers. Teachers were questioned about the preparedness and the design of the online lectures and their preferences over the traditional, face-to-face version of the class lectures. The five-point Likert scale ranges from 1 being equated with “not being concerned at all” to 5 representing a serious preoccupation with the given factor is utilized.
There is a distinction between student feedback that emphasizes satisfaction with the quality of online class interactions and student responses that depend on engagement with peers during asynchronous and synchronous conversations (Table 1).
The background characteristics of the 213 participants who provided the feedback are described in Table 1a. Mobile is found to be commonest (86.4%) instrument used to access the video lecture content. Twenty-two students accessed through a laptop. The cellular network of the mobile is the preferred network utilised by the participants. Around half of the
Table 1 — Background characteristics of the online lecture users and their methods of accessibility of the online lectures
CriteriaNo (n=213)
Instrument/machine used to access the online content :
participants felt that the speed of the internet was felt to be good and excellent. When enquired, 46 students (22.0%) revealed to have had previous experience with online teaching and learning.
Table 2 depicts the distribution of students’ perceptions concerning the characteristics of online video lectures. These characteristics are classified according to the content, duration of the session, visual preferences, the suitability of the timings and the picture size. Seventy-one (33.4%) clearly expressed that VL content is interesting. Rest 142 (68.6%) reserved their opinion. Among these, 113 (53.1%) said that the interest of the content depends on the subject/ topic and the teacher. Rest of the students, 29 (13.5%) indicated that the VL is not interesting. When enquired about the duration of the lecture and the method of assessment of their concentration/ attention/ learning, 89 (41.7%)
Table 2 —Distribution of Characteristics of Online lectures and the Students opinion NoLecture CriteriaStudent Response
1Content: a)Interesting71 (33.4) Not interesting/ No opinion29 (13.5) Depends on the Teacher/ topic/ subjectb)113 (53.1) Should be same as traditional physical classroom lecture Yes154 (72.3) No59 (27.7)
2Duration of Lecture (minutes): a)5-10 followed by an immediate assessment7 (3.2) b)20-30 followed by an immediate assessment89 (41.7) c)45 NOT followed by an immediate assessment93 (43.6) d)My personal preference 24 (11.2)
3Preferred duration of lecture (minutes): (Median) Anatomy45 Physiology45 Biochemistry45
4aVisuality Preferences: Speaker Lecture by same Institute faculty 156(73.5) Reputed Guest Faculty/ Other institute faculty 24(11.2) Sharing other suggested video links of that topic 32(15.1)
4bVisuality Preferences: Screen appearance Only portrait/ Full view of the speaker 45(21.2) Toggle view/ Picture in Picture (PPT & Speaker)167 (78.7)
4cVisuality Preferences: Background of speaker Classroom160 (75.5) Customized 55(24.5)
4dVisuality Preferences: Social Isolation Social isolation unlike traditional classroom (Yes)113 (53.3) Social isolation (No) 99(46.7)
5Suitability of the lecture timings 10.00 am to 12.30 (Present timings) 193(91.0) Not suitable19 (9.0)
6Screen size preferred for watching Smartphone (<10 inch)148 (69.8) Tablet/ Ipad (>10 - <13 inch)13 (6.1) Laptop/ Desktop (>13 – <15 inch)41 (19.3) >15 inch screen size10 (4.7)
Vol 120, No 12, December 2022Journal
Mobile 184 (86.4) Ipad/ Tablet5 (2.3) Laptop22 (10.3) Desktop2 (0.90) Network used : Broadband/ Fiber network37 (17.4) Cellular 176 (82.6) Satisfaction level with internet speed : Not at all satisfied28 (13.1) Average79 (37.1) Good89 (41.8) Excellent17 (8.0) Previous experience with online learning : Yes46 (22.0) No167 (78.0)
51
of the Indian Medical Association
preferred 20-30 minutes of presentation, followed by an assessment of the content. However, 117(44.8%) preferred no such assessment of their learning following the VL. Only seven students opined that after every 510 minutes, there should be an assessment of the content. The preferred median duration of the lecture is 45 minutes for all the three subjects.
When enquired about the social isolation, 113 (53.3%) students replied affirmatively to social isolation during the VL. Unlike many reports where social isolation is being identified as a major hurdle for the online VL, 99 (46.7%) of students felt no social isolation while listening to online VL. The suitability of the online video lectures was approved by 193(91.0%) of the respondents. The timings of the VLs and that of the routine traditional lectures coincide.
The preferred instrument by the students to access the video lectures when enquired was found to be the smartphone (69.8%). The smartphone screen dimension was small (<10 inch) and is the most favoured screen size (Table 2).
The important aspect of the online VL is the assessment. It is necessary to monitor the student listening and assess the learning through vigilant assessment. The assessment frequency preferences by the students are depicted in Table 3. The speaker recapitulating the content delivered during the VL at frequent intervals during the lecture was preferred by 65 students (30.7%). Forty-eight students (22.6%) opined that questions based on the content delivered during the VL could be directed at the audience at the end to assess the learning of the students. Conducting once a week online tests on the respective subject content delivered during that week is the chosen assessment frequency by 84 (39.6%) of students. Routinely, weekly tests are organized during the traditional normal teaching course. Students are habituated to this method of weekly assessment (Table 3).
The distribution of perceived acceptability and the adaptability of the video online lectures by the students is shown in Table 4. When enquired about the cultural suitability of the VL in improving the learning process, 151 (71.2%) responded in agreement. The remaining 61 students (28.7%) responded negative and or unable to decide. When enquired about the adaptability of the students to the online video lectures as a teaching
Table 3
— Online Assessment for the video lectures Preferred by the Students
Assessment schedule
Response
Questions at the end of each video lecture48 (22.6)
Recapitulation at the end of every 5-10 minutes65 (30.7)
At the beginning of each lecture on a topic covered before15 (7.0)
Weekly online tests on topics covered in week84 (39.6)
and learning medium, 81 (38.2%) expressed complete satisfaction and said that they are able to adapt to this online medium of instruction. Nearly 62.0% of students (172 out of 213) are unable to adapt to the online video lectures for their learning. Among these, 117 (54.9%) agreed that these they are able to adapt to these online VL somewhat partially.
The cognitive experience through online video watching and listening should be an enjoyable learning activity. Out of 213 students, 72 (34.0%) expressed this activity as an enjoyable learning experience. Out of the remaining students, 33 (15.6%) opined that there is no personal touch in the online VL. It is pertinent to note that 107 (50.4%) expressed that this online VL are either not interesting or boring. The difficulty level of this VL when questioned, only 31 students (14.6%) said that this online VL are easy to understand. Remaining 84.4% of students expressed reservations regarding the difficulty level in understanding. One hundred and eighteen Students (55.3%) suggested that online VL should be continued for further learning (Table 4).
Students’ familiarity with the online platform (ZOOM) for video lectures was enquired, and the results are shown in Table 5. The advantages and the inbuilt facilities like raising the hand to ask a question, communicating through a chat room, video sharing and recording of the VL are known to 139 (65.2%) of students. Rest of the students (73 out of 213) are either not confident and/ unaware of these facilities. The
Table 4 — Experience perception & acceptability of online Video Lectures Criteria Response
VL is a culturally suitable way to improve your learning process :
Yes151 (71.2) No30 (14.1)
Don’t Know31 (14.6)
Perception of adaptability from classroom to online lectures : Yes Complete81 (38.0) Partially117 (54.9) No11 (5.2) Don’t Know4 (1.9)
The learning experience of listening and watching online lectures is
Boring10 (4.7)
Enjoyable & Good72 (34.0)
Not so interesting97 (45.7) No personal touch 33(15.6)
The difficulty level of understanding VL :
Easy to understand31 (14.6) Not so difficult140 (66.0) Difficult to comprehend41 (19.3)
Do you suggest a continuation of the VL in future : Yes118 (55.3) No71 (33.5)
Don’t know24 (11.3)
Vol 120, No 12, December 2022Journal
52
comfortability of sharing the video (switching on the self-video button) when inquired, 130 students (61.0%) declined to switch it on during the VL. Fifty-three students (25.0%) agreed to share their video and the remaining are unable to decide. The adaptation to Online VL is graded on a visual analogue scale of 1 to 5, in an ascending acceptability order. It is worthy to note that 172 (80.8%) accorded better adaptation of watching the VL and graded their adaptation between 3 and 5. The adaptation to online VL was perceived by the 41 students (19.2%) as poor denoted as less than two on a scale of 0 to 5 (Table 5).
Students were enquired about their preference of screen size for watching. Students who are regularly watching VL on their mobiles preferred the same mobile screen to watch (147 out of 184). In comparison,95.5% of students who watch VL on laptop preferred to continue watching them on a laptop screen. Though 86.4% of students are watching these VL online on mobile, only 80.0% preferred mobile screen to watch. In general, students prefer mobile to watch VL (Table 6).
The difficulty level of the online VL and its relationship with the instrument used for accessing these lectures is shown in Table 7. Thirty-one (14.6%) of students felt that these VL are easy to understand. Rest of the students 182 out of 213 felt that these lectures are not so difficult to understand and / difficult to understand. Among students who are connecting through a laptop, 31.8% felt that these lectures are easy to understand compared to 14.6% of those using mobile. Forty-one (19.2%) expressed that these VL
Table 5 — Familiarity with the Online Learning Video Conference Management Platform (ZOOM) Parameter Response
Advantages & Facilities (lifting a hand to ask questions, Video sharing of you, recording)
Yes139 (65.2) No38 (17.8) Not Sure36 (17.0) Comfortability of sharing the self-video during VL Yes53 (24.9) No130 (61.0) Undecided30 (14.1) Grading your adaptation to the VL 1-241 (19.2) 3-4162 (76.1) 510 (4.7) Table 6
9(4.9)20(10.9)147(79.9)8(4.3)184(86.4) Total10(4.7)41(19.2)149(70.0)13(6.1)213(100.0)
Table 7—The difficulty level of VL perceived by the student and its relationship with the instrument used for accessing these lectures
Instrument Difficult toEasy toNot soTotal understandunderstand difficult to understand
Desktop0 1(50.0)1(50.0)2 (1.0) Ipad/tablet0 2(40.0)3(60.0)5 (2.3)
Laptop 3(13.6)7(31.8)12(54.6)22 (10.3)
Mobile 38(20.7)21(11.4)125(67.9) 184 (86.4)
Total41(19.2)31(14.6)141(66.2)213 (100.0)
are difficult to comprehend (Table 7).
It is proposed that the difficult level opined by the student might have had the influence of previous experience with online teaching and learning. Among those students who had previous experience of online learning, 17.4% felt video lectures are easy to understand. The difficulty levels felt are almost same among those who had experience and those who are a novice (17.4% and 19.8% respectively) (Table 8).
The various causes for the high difficulty level in understanding as perceived by the students suggest that the VL should be interesting and the concerned teacher/ topic also is responsible. Seventy (32.8%) students felt that the topics covered in VL are interesting. Majority of the students (53.5%) felt that the difficulty level of the VL depends on the topic covered and the teacher delivering the VL (Table 9).
Qualitative Analysis : (1)Online Video Lecture — a)Content : Students opined that these online
Table 8 — The relationship of perceived difficulty levels of VL and the previous experience of online teaching and learning
Attended Difficult toEasy toNot soTotal Online understandunderstand difficult to Coaching before understand No33(19.8)23(13.8) 111(66.4)167(78.4) Yes8(17.4)8(17.4)30(65.2)46(21.6) Total41(19.2)31(14.6)141(66.2)213(100.0)
Table 9 — The distribution of reasons for the perceived difficulty levels of VL among students
Instrument Difficult to Easy Not soTotal understandto difficult to understand understand
Depends on teacher/ topic/ subject 22(19.3)13(11.4) 79(69.3)114(53.5) interesting 10(14.3)16(22.9)44(62.8)70(32.8) No opinion 6(25.0)2(8.3) 16(66.7) 24(11.3) not interesting at all 3(60.0)02(40.0)5(2.3)
Total41(19.2) 31(14.6)141(66.2)213(100.0)
Vol 120, No 12, December 2022Journal
of the Indian Medical Association
users
their
to
— Present
and
preferences of Screen size
access VL TheNo students who reported their preferred instrumentinstrument to watch VL (%) to Access >15" LaptopSmart-Tablet/Total VLincluding(13-15")phone Ipad TV screen Desktop0 1(50.0)1(50.0)02(1.0) Ipad/Tablet000 5(100.0)5(2.3) Laptop 1(4.5)21(95.5)0022(10.3) Mobile
53
classes are helpful only for the subject revision but not for explaining new topics. Many students felt that these classes should incorporate more animations/ 3D pictures rather than simple text in the power points shown. They are also of the firm opinion that explanation of the topic on a blackboard is beneficial for clarity. Students also requested that the faculty should summarize the main points at the end of each online session. They also preferred more interactions with their fellow participants.
b)Assessment : Students requested that the faculty member should pose frequent questions in between to the participants by unmuting a specific participant.
c)Accessibility : The main hurdle expressed is the network connectivity at their respective home. The online lecture is a continuous one for nearly 45 minutes, and the students experienced automatic network disconnection after every 20 minutes. They also complained that the faculty voice not clear and even the video breaks in-between the session. These difficulties are mainly due to poor connectivity.
d)Others : Students who are regular in VL attendance, expressed that they could recall the subject taught in the previous class. However, they felt that the home environment is causing disturbances in concentration and experienced household interruptions at their home.
(2)VL Timings — Students felt that timings are acceptable and are suitable for them. Some students even suggested starting the VL sessions late in the morning and continuing beyond 1.00 pm. They also indicated an eagerness to attend the sessions even in the evening.
DISCUSSION
The primary objective of this exploratory study was to examine the preference and perception of students regarding the newly introduced online live video lecture classes. Two hundred and thirteen undergraduate students’ feedback was sought regarding the newly introduced online teaching sessions. These Online Video lectures replaced the traditional physical classroom teaching due to the COVID-19 pandemic. Students were instructed to leave the college campus and advised to stay at their respective homes. The online VL are accessed by these students through their mobile phone/ tablet/ desktop computer/ laptop. The present study revealed that 86.4% of students are routinely using their mobile phones to access the VL. Similar studies19 also revealed that the majority of students (58.0%) are using a smartphone to access the online teaching. The internet is slow, and fifty
percent of students expressed their dissatisfaction with the internet speed. As students are utilizing the mobile data, the speed is far below the required19. The habit of learning through online video lectures is a novice to the present student population, and 78.0% of them had no previous experience. Lack of familiarity and exposure to a different method of teaching, are causing conflicts in the habituated methods of learning among students. Hence 72.3% of students preferred online VL format and content to be similar to that of a traditional physical classroom lecture. Non-familiarity of this method of teaching might be influencing the students’ perception of dissatisfaction with the current content delivery. On inquiry, students preferred this VL method should be complimentary and a blended system would be more interesting and effective7,11,13,16. Students reported that online lectures provide an additional educational value compared with “live” traditional lectures. In other words, blended learning would be more effective and should be continued further11,16,21. This method of online VL is also precipitating the feeling of social isolation among 53.3% of students. The habitual physical presence of their colleagues and appreciation of their friends’ verbal and nonverbal reactionduring the traditional classroom atmosphere is conspicuously absent in the online method1,2. This is resulting in the perception of social isolation among them. It is known that students who receive personalized feedback have higher levels of course satisfaction and perform academically better than those students who receive only collective feedback16,17,22. Hence personalized feedback needs to be incorporated into the VL program. A simple act, like using the student’s name while writing feedback, also helps in developing teacher’s rapport with the student17
Seventy percent of the students preferred watching the VL on smartphone screen measuring less than 10 inches. The habitual use of the smartphone by students and non-availability of bigger screens are the underlying factors influencing the screen size preferences19.
During the traditional classroom teaching, formative assessment is undertaken through weekly physical tests. Students, when inquired about preferred assessment method during online VL, only Forty percent opted weekly tests. 31.0% preferred recapitalization of the subject and assessment after every 5-10 minutes. Around 23.0% of students preferred assessment at the end of each VL. These findings affirm students’ preference for the spot assessment to assess their understanding and learning. Due to this reason, the majority of the online course videos are of short duration, and at the end of 5-10-minute
Vol 120, No 12, December 2022Journal
of the Indian Medical Association
54
VL, assessment is introduced.
Creating a conducive environment during online lectures is difficult but is necessary for online learning1,2,20. This would prevent the students from feeling isolated and also enhance the classroom ambience for better learning1
Seventy-one percent of students agreed that VL is a culturally suitable way to learn the subject. As the students are traditionally habituated to learn from the physical classroom teaching, nearly 58.0% of them expressed dis-comfort and inability to adjust with the online teaching. The same percentage of students expressed that online listening and watching is not such an interesting experience. The study finding that 66% of the students do not enjoy the online teaching requires introspection of the teaching methodology adopted for the online lectures. It is well known that the attention span decreases after 20 minutes in case of a physical lecture. This period might be much shorter for an online lecture24. Around 20.0% of students felt that it is difficult to comprehend the contents of the VL. All these factors emphasize that the faculty need to modify the way of teaching, assessment of learning and convert their teaching sessions into more interesting learning experiences20. Students would fully accept and appreciate online VL if they perceive that VLs would offer an advantage over traditional alternatives16. As the faculty is habituated to traditional teaching sessions, they require to modify their teaching and learning assessment methodology20
Interestingly, even after two sessions of training, 35.0% of students are not fully familiar with the facilities available in the online platform. Surprisingly, 75.0% of students refused to share their video online during the lecture. The use of the smart mobile phone has become universal and students are keen to access online content through their mobile phone devices only. The easy availability, portability and multiple uses are the reasons for their mobile phone preferences. When cross-tabulated, people who are accessing the VL through bigger screen devices (Ipad/ tablet/ laptop) find these lectures to be easy to understand. Bigger the screen, easy for them to visualise for a longer time and causes less eyestrain.
CONCLUSIONS
Based on the findings of the study, the following conclusions can be drawn:
The purpose of effective online lectures and learning is to provide learners with opportunities to engage in enhanced teacher supportive educational experiences. Such experiences are pillared by a triad of factors— student involvement, teachers support and teaching
presence—that work in tandem. There are several areas of convergence that connect these components of educational experience, as follows: Not only the mere presence but listening and comprehending the audiovisual content, immediate clarification of concepts, visualizing whenever necessary at their own pace and convenience etc. would constitute the student involvement. The teaching presence and teachers support are pivotal in enabling this online learning experience into a mutual relationship. Teachers need to be aware that the controls are with the student. When the student is not interested, they can remotely switch off/ leave the VL without the knowledge of the teacher. Teachers involved in VL should change their style of teaching, encourage student involvement more frequently and deliberately to keep the interest. Unlike traditional physical class which is controlled by the teacher, VL is controlled by the student. The VL should appeal to the students. In order to design a better learning experience, continuous students’ feedback is pivotal. Given the degree of interactivity in online classes, the need for the use of a constructive approach to teaching, learning, and assessment is crucial in helping students to co-construct knowledge by making meaning of their interactions with content, instructors, and peers, as well as the interface provided by the learning management system. Student responses and formative feedback connect supporting discourse, learning environment setting, and content selection in particular ways that are grounded in the context of the class where the research was conducted. In other words, formative assessment through feedback was an integral part of structuring student responses, thus creating a positive learning environment where communicative exchanges were student-centred. Formative course content assessment is as important as a dynamic VL course design to suit the student community requirements for meaningful enhanced educational experiences. The study findings support recommendations for future iterations of the flexible online lectures/ teaching & learning design procedures used, with a particular focus on the interplay among various considerations to be made when developing online teaching & learning effectively.
(1)SetClearExpectations—
When you are designing an online discussion, take a moment to think about what you want the students to achieve. By setting clear expectations and giving specific instructions and training at the beginning, students will be familiarised with all the options available at the online learning platform and get a better idea of what is expected of them, and it saves both stakeholders time.
Vol 120, No 12, December 2022Journal
of the Indian Medical Association
55
(2)PersonaliseIt—
Given the dynamics of online learning, it is common for students to feel distant and isolated during the course. One of the best ways to prevent your students from feeling this way is by delivering personalised feedback. Knowing the social isolation, the assessments are devised in such a way that feedback is obtained from each and every student personally. What is already known :
1)E-learning is gaining popularity among the medical faculty and students. The affordable video conferencing technology enabled some of the organisations to adopt and offer online e-learning to their students.
2)Many researchers documented the advantages of e-learning and its positive effect on learning among students.
3)Many students adopt e-learning for acquiring additional knowledge/ skills or as a means of intensified training method for competitive examinations.
4)However, the usefulness and acceptability of elearning among medical students as a part of their curriculum is still not fathomed in medical education. What this paper adds :
1)Information about the role of video lecture in students’ overall online experience
2)Students’ perception of VL based upon their accessibility, previous experience and their preferences.
3)Students perceptions and their acceptance of the video lectures and online assessment methods. Conflict of interest : The authors have no conflicts of interest to report.
REFERENCES
1Richardson J, Swan K — Examining Social Presence in Online Courses in Relation to Students’ Perceived Learning and Satisfaction. Online Learning 2019; 7(1).
2Scagnoli N, Choo J, Tian J — Students’ insights on the use of video lectures in online classes. British Journal of Educational Technology 2017; 50(1): 399-414.
3Wieling M, Hofman W — The impact of online video lecture recordings and automated feedback on student performance. Computers & Education 2010; 54(4): 992-8.
4Chowdhury T, Khan H, Druce M, Drake W, Rajakariar R, Thuraisingham R, et al — Flipped learning: Turning medical education upside down. Future Healthcare Journal 2019; 6(3): 192-5.
5Kyaw B, Posadzki P, Paddock S, Car J, Campbell J, Tudor Car L — Effectiveness of Digital Education on Communication Skills Among Medical Students: Systematic Review and MetaAnalysis by the Digital Health Education Collaboration. Journal of Medical Internet Research 2019; 21(8): e12967.
6Alexander A, Deas D, Lyons P — An Internet-Based Radiology Course in Medical School: Comparison of Academic
Performance of Students on Campus Versus Those With Absenteeism Due to Residency Interviews. JMIR Medical Education 2018; 4(1): e14.
7Herbert C, Velan G, Pryor W, Kumar R — A model for the use of blended learning in large group teaching sessions. BMC Medical Education 2017; 17(1).
8Samulski T, Taylor L, La T, Mehr C, McGrath C, Wu R — The utility of adaptive eLearning in cervical cytopathology education. Cancer Cytopathology 2017; 126(2): 129-35.
9Fontaine G, Cossette S, Maheu-Cadotte M, Mailhot T, Deschênes M, Mathieu-Dupuis G, et al — Efficacy of adaptive e-learning for health professionals and students: a systematic review and meta-analysis. BMJ Open 2019; 9(8): e025252.
10Sajid M, Laheji A, Abothenain F, Salam Y, AlJayar D, Obeidat A. Can blended learning and the flipped classroom improve student learning and satisfaction in Saudi Arabia?. International Journal of Medical Education 2016; 7: 281-5.
11Kalludi S — Is Video Podcast Supplementation as a Learning Aid Beneficial to Dental Students?. Journal of Clinical and Diagnostic Research 2015;
12Suda K, Bell G, Franks A — Faculty and Student Perceptions of Effective Study Strategies and Materials. American Journal of Pharmaceutical Education 2011; 75(10): 201.
13Benino D, Girardi A, Czarniak P — Incorporating online teaching in an introductory pharmaceutical practice course: a study of student perceptions within an Australian University. Pharmacy Practice (Internet) 2011; 9(4): 252-9.
14Levine A — Evaluation of World Wide Web-based Lessons for a First Year Dental Biochemistry Course. Medical Education Online 2002; 7(1): 45-7.
15Suda K, Sterling J, Guirguis A, Mathur S — Student perception and academic performance after implementation of a blended learning approach to a drug information and literature evaluation course. Currents in Pharmacy Teaching and Learning 2014; 6(3): 367-372.
16Phillips J. Replacing traditional live lectures with online learning modules: Effects on learning and student perceptions. Currents in Pharmacy Teaching and Learning 2015; 7(6): 738-44.
17McKinnie R — White paper on Best Practices for Delivering Virtual Classroom Training. Available from:https:// www.eastfalls.jefferson.edu/oir/inc/docs/ Best Practices for Virtual Classrooms.pdf on 10.05.2020.
18Sahi P, Mishra D, Singh T. Medical Education Amid the COVID19 Pandemic. Indian Pediatrics 2020; 57(7): 652-7.
19T M, S A, Aditya K, Jha G — Students’ Perception and Preference for Online Education in India During COVID -19 Pandemic. SSRN Electronic Journal. 2020.
20Sahi P, Mishra D, Singh T — Medical Education Amid the COVID-19 Pandemic. Indian Pediatrics 2020; 57(7): 652-7.
21Suda K, Sterling J, Guirguis A, Mathur S — Student perception and academic performance after implementation of a blended learning approach to a drug information and literature evaluation course. Currents in Pharmacy Teaching and Learning 2014; 6(3): 367-72.
22Burnett K, Bonnici LJ, Miksa SD, Kim J — Frequency, Intensity and Topicality in Online Learning: An Exploration of the Interaction Dimensions that Contribute to Student Satisfaction in Online Learning. Journal of Education for Library and Information Science 2007; 48(1): 21-35.
23Balan, Anna & Montemayor, Thomas & Dalisay, Jill — The Influence of Online Learning towards the Attention Span and Motivation of College Students. An Undergraduate Research submitted to the School of Social Sciences and Education, Mapúa University, 2021.
Vol 120, No 12, December 2022Journal of the
Medical Association
Indian
56
Review Article
Executive Summary of the Recommendations on the Management of Asthma In Primary Care (2022) – New Updates
S K Jindal1, J Lele2, A G Ghoshal3, S Nair4, S Kant5, A Parakh6, Meena7, Rekha8, V D Nagda9, T Masurkar10, SK Joshi11
Background : Asthma is a heterogenous disease defined by the history of respiratory symptoms (shortness of breath, wheezing, cough, and chest tightness) that vary over time and in intensity, along with variable expiratory airflow limitation Despite an ever-increasing prevalence of asthma across all age groups, this condition remains poorly managed in India. Majority of the Indian patients remain undiagnosed or wrongly diagnosed in general clinical practice and even those who get diagnosed, remain poorly or inadequately treated1,2. Since the last published 2020 Indian Medical Association (IMA) recommendations on the management of asthma in primary care, noteworthy critical changes have been recommended in relation to the diagnosis/management of asthma in international guidelines. Hence, there was a need to update the existing IMA recommendations. For the same, an expert group meeting was organized with family physicians having clinical experience in managing patients with asthma along with chest physicians and pediatricians. Important updates related to asthma diagnosis and its management were discussed and the final recommendation decisions were derived from the joint group discussion. Some of the key points derived from the discussion are mentioned below in the executive summary.
For a detailed version of the new recommendations please click on the url.
[J Indian Med Assoc 2022; 120(12): 57-60]
Key words :Asthma, Stable Asthma, Exacerbations, Spirometry, Peak Expiratory Flow, Bronchodilator, Medication.
New Updates in the IMA Recommendations 2022?
Diagnosing asthma in adults, adolescents, and children aged >5 Years :
The diagnosis of asthma is based on the history of characteristic symptom patterns and evidence of
1MD, FCCP, FAMS, FNCCP, Emeritus Professor of Pulmonary Medicine, Postgraduate Institute of Medical Education and Research, Chandigarh 160012
2MBBS, Hony. Secretary General, IMA HBI, IMA Building, J R Mhatre Marg, Juhu, Mumbai 400049 and Corresponding Author
3MD, DNB, FCCP, Ex-WHO Fellow ICS, FICP, Medical Director National Allergy Asthma Bronchitis Institutes, Kolkata 700017
4MD, DNB, DTCD, Associate Professor Department of Pulmonary Medicine Medical College, Trivandrum 695011
5MBBS, MD (Gold Medalist), MNAMS, FCCP (USA), FIAMS, FNCCP, FCAI, FIMSA, FIAB, FUPDA, FIACM, FICP, Professor and Head of The Department Respiratory Medicine, KGMU, Lucknow 226003
6MBBS, MD (Pediatric), DNB (Pediatric), Senior Consultant Pediatric Pulmonology, Allergy and Sleep Medicine, BLK Super Speciality Hospital, Delhi and Children’s Chest Clinic, Delhi 110005
7MBBS, Family Physician, National Chairperson, IMA – Women Doctors Wing, Past President IMA Dhule Branch 424001
8MBBS, Director at RR Medicare Centre & E J Immunisation Centre, Chennai, Tamil Nadu 600102
9MBBS, Senior General Practitioner at Dr Nagda’s Multispeciality Clinic, Mumbai 400055
10MBBS, Past secretary, IMA Virar Branch 401203
11MBBS, Ex-President, IMA Mumbai West Branch, Juhu 400049
Received on : 25/11/2022
Accepted on : 27/11/2022
Executive Summary :
Asthma is a clinical diagnosis; however, in cases where dilemma exists, refer to an expert. In clinical practice for general physicians, peak expiratory flow can be a good indicator for asthma diagnosis if it shows reversibility after bronchodilator therapy. In young children, asthma diagnosis is mainly based on recurrent symptom patterns, assessment of family history, physical findings (if the child is symptomatic), short-term corticosteroid trial therapy, and differential diagnosis. The optimal management of asthma includes the use of controller medications, which reduce the underlying inflammation and prevent the occurrence of symptoms, and reliever medications, which are used as required for quick symptom relief. Increased use of short-acting beta2-agonists is associated with adverse clinical outcomes. Low-dose inhaled corticosteroid plus fast-acting beta2-agonist, ie, budesonide-formoterol, is the preferred reliever in adults and adolescents, as it reduces the risk of severe exacerbations compared with regimens with short-acting beta 2-agonist alone as a reliever.
variable expiratory airflow limitation3.
For general physicians (GPs), the peak expiratory flow (PEF) value (tested via a peak flow meter) can be a good diagnostic indicator for asthma if it shows
Vol 120, No 12, December 2022Journal of the Indian Medical Association
57
reversibility after bronchodilator medication3. Spirometry (forced expiratory volume in 1 second) should be considered more reliable than PEF. However, if spirometry is unavailable, bronchodilator reversibility may be assessed with a peak flow meter3
Diagnosing Asthma in Children Aged <5 Years : Based on the pattern of symptoms during and between viral respiratory infections, a probabilitybased approach may be useful for discussion with parents/carers3
In children aged 5 years and younger, no specific tests can confirm the diagnosis of asthma, but there are a few useful adjuncts3.
Updates about the Treatment of Asthma in Adults and Adolescents :
The stepwise approach to the management of stable asthma in adults and adolescents has been updated with Inhaled Corticosteroid (ICS)-formoterol as the preferred reliever and short-acting beta2agonist (SABA) as an alternative option.
In Step 1 and Step 2 (Track 1), the recommendation for treatment is as-needed low-dose ICSFormoterol.
For the alternate (Track 2), the following recommendations are made:
Step 1: Low-dose ICS should be taken whenever SABA is taken.
Step 2: Low-dose daily ICS should be taken for maintenance and as-needed SABA should be taken for relief.
In Steps 3–5, maintenance and reliever therapy with budesonide-formoterol (preferred approach) or ICSLABA as maintenance therapy plus SABA as reliever (alternate approach) is recommended.
Newer recommendations for add-on long-acting muscarinic antagonist (LAMA) and introduction of anti-thymic stromal lymphopoietin (ATSL) as a new biologic agent have been included for severe asthma.
Other controller options have been clarified and included in the treatment.
Updates about the Treatment of Asthma in Children 6-11 years :
Step 1 includes low-dose ICS to be taken whenever SABA is taken.
Steps 3 and 4 include maintenance and reliever therapy (MART) with very low-dose ICSformoterol and low-dose ICS-formoterol, respectively, to reduce exacerbations.
Preferred route for administering asthma medications :
Inhalation therapy is the preferred route for the administration of medications in asthma management4. The inhalation route ensures the deposition of the optimum concentration of medication in the airways and rapid onset of action and causes fewer systemic adverse effects than oral delivery3
The most commonly used inhalation devices include Pressurized Metered-dose Inhalers (pMDIs), Dry Powder Inhalers (DPIs), Breathactuated Inhalers (BAIs) and Nebulizers5
Concerns with Prescribing SABAs alone for Asthma Management, including Mild Asthma : Large multicenter studies have demonstrated that increased use of SABA is associated with increased risks of exacerbation and mortality in asthmatics6
Regular use of SABA, even for 1-2 weeks, is associated with adverse effects7,8 : •Beta-receptor downregulation, decreased broncho protection, rebound hyperresponsiveness, and decreased bronchodilator response
• Increased allergic response and increased eosinophilic airway inflammation
Hence, SABA should always be administered along with ICS3because ICS reduce the risk of asthma deaths, hospitalization, and exacerbations requiring oral corticosteroids9,10
The Emerging Concept of using an Antiinflammatory Reliever in Asthmatics :
Asthma is a chronic inflammatory disease. During an exacerbation, along with spasms of the smooth muscles, inflammation in the airways increases, which causes an increase in airway obstruction. Traditionally, SABA alone was recommended for quick symptom relief, which does not address the underlying inflammation and may eventually lead to a decline in lung function3
The ideal constituents of reliever medication, thus, should be a fast-acting bronchodilator used in combination with ICS (popularly known as an anti-inflammatory reliever), thereby addressing both bronchoconstriction and inflammation3.
As per the new guideline, low-dose ICS-formoterol is the preferred anti-inflammatory reliever in adults and adolescents, as it significantly reduces the risk of severe exacerbations compared with SABA alone as a reliever3
Vol 120, No 12, December 2022Journal
of the Indian Medical Association
58
Using SABA as a Reliever :
SABA can be used as reliever therapy in adults and adolescents in the following cases3 :
As an alternative to an ICS-formoterol reliever, in Step 1, SABA and low-dose ICS can be administered together for symptom relief, either with an ICS plus SABA combination inhaler or with ICS taken right after SABA3.
As an alternative to an ICS-formoterol reliever, in Steps 2–5, SABA can be administered as a reliever medication, in addition to a controller, to patients who are on controller therapy other than formoterolbudesonide3
Importance of correct inhalation technique :
Though inhalation therapy is the cornerstone of asthma treatment, up to 94% of patients with asthma and chronic obstructive pulmonary disease do not use their inhalers correctly. It is important to reinforce the correct inhaler technique at every patient visit11
Many people have difficulty using a pMDI, wherein the most common mistake is not being able to actuate and inhale the medication at the same time12
Spacers are used as an add-on with pMDIs. They offer the advantages of easier use and improved deposition pattern of the inhaled drug, reduced side effects, and improved drug efficacy13.
DPIs have the advantages of being portable and compact and overcoming issues of coordination. In addition, they do not contain propellants. However, they require a minimum inspiratory flow for optimum delivery of the dose5
BAIs have the advantage of overcoming the drawbacks of both DPIs and pMDIs. BAIs sense an inhalation effort through the actuator and mechanically actuate the dose in synchrony, resolving the issue of hand-breath coordination that is commonly seen with pMDIs14
Correct inhalation devices based on the age for the successful management of asthma
Selection of the correct inhalation device is crucial for successful asthma management (Table 1)3
Table 1 — Selection of inhalation device based on age Age group Preferred choice Alternative
0–3 yearspMDI + spacer Nebulizer with with face mask face mask
4–5 years pMDI + spacerpMDI + spacer with face mask
5 years andpMDI+ spacer/Nebulizer above DPI/BAI
Role of the GP in Educating and Counseling Patients with Asthma :
Some pointers for GPs with respect to educating and counseling patients with asthma15,16 : Adequate time should be invested in educating and counseling patients with asthma.
It is also important to keep oneself updated about different inhalation devices so that the most appropriate inhalation device for patients can be prescribed.
Train patients on correct inhalation technique and ensure technique at follow-up visits.
Discuss the patient’s treatment goals and guide the patient on an asthma self-management plan. Clarify queries during patient visits on a continual basis to improve compliance.
Check for drug compliance and adherence to asthma treatment at every visit for ensuring optimal asthma control.
Guidance about Asthma and COVID-19 :
It is advisable for patients with asthma having coronavirus disease (COVID-19) to continue taking their prescribed asthma medications, particularly ICS.
COVID-19 vaccine is safe for people with asthma (follow the Government of India guidelines for more information).
Article Support and Acknowledgement: This support was provided by Insignia Learning Private Limited, which received an unconditional and unrestricted educational grant from Cipla Ltd. The authors wish to thank Dr Swati Singh* for offering all her support in the author meeting and manuscript/article preparation.
(*EmployeeofInsigniaLearningPrivateLimited)
REFERENCES
1Salvi S, Apte K, Madas S, Barne M, Chhowala S, Sethi T, et al Symptoms and medical conditions in 204 912 patients visiting primary health-care practitioners in India: a 1-day point prevalence study (the POSEIDON study). Lancet Glob Health 2015; 3(12): e776-84.
2Salvi SS, Apte K, Dhar R, Shetty P, Faruqi RA, Thompson PJ, et al — Asthma Insights and Management in India: Lessons Learnt from the Asia Pacific – Asthma Insights and Management (AP-AIM) Study. J Assoc Physicians India 2015; 63(9): 3643.
3Global Initiative for Asthma. Global Strategy for Asthma Management and Prevention 2022 [Internet] [Updated 2022]. Available at: https://ginasthma.org/wp-content/uploads/2022/ 05/GINA-Main-Report-2022-FINAL-22-05-03-WMS.pdf. Accessed on Aug 1, 2022.
4Virchow JC. What plays a role in the choice of inhaler device
Vol
No 12, December
120,
2022Journal of the Indian Medical Association
59
Vol 120, No 12, December 2022Journal of the Indian Medical Association
for asthma therapy? Curr Med Res Opin 2005; 21 Suppl 4: S19–S25.
5Usmani OS — Choosing the right inhaler for your asthma or COPD patient. Ther Clin Risk Manag 2019; 15: 461-72.
6Nwaru BI, Ekström M, Hasvold P, Wiklund F, Telg G, Janson C — Overuse of short-acting ²2-agonists in asthma is associated with increased risk of exacerbation and mortality: A nationwide cohort study of the global SABINA programme. Eur Respir J 2020; 55(4): 1901872.
7Aldridge RE, Hancox RJ, Taylor DR, Robin Taylor D, Cowan JO, Winn MC, et al — Effects of terbutaline and budesonide on sputum cells and bronchial hyperresponsiveness in asthma. Am J Respir Crit Care Med 2000; 161(5): 1459-64.
8Suissa S, Ernst P, Benayoun S, Baltzan M, Cai B — Lowdose inhaled corticosteroids and the prevention of death from asthma. N Engl J Med 2000; 343(5): 332-6.
9Pauwels RA, Pedersen S, Busse WW, Tan WC, Chen YZ, Ohlsson SV, et al — START Investigators Group Early intervention with budesonide in mild persistent asthma: A randomised, double-blind trial. Lancet 2003; 361(9363): 10716.
10Beasley R, Holliday M, Reddel HK, Braithwaite I, Ebmeier S, Hancox RJ, et al — Novel START Study Team. Controlled trial of budesonide-formoterol as needed for mild asthma. N Engl J Med 2019; 380(21): 2020-30.
11Jahedi L, Downie SR, Saini B, Chan HK, Bosnic-Anticevich S — Inhaler technique in asthma: How does it relate to patient’s preferences and attitudes toward their inhalers? J Aerosol Med Pulm Drug Deliv 2017; 30(1): 42-52.
12American Thoracic Society — Using your metered dose inhaler (MDI). Am J Respir Crit Care Med 2014; 190: P5–P6.
13Anderson G, Johnson N, Mulgirigama A, Aggarwal B — Use of spacers for patients treated with pressurized metered dose inhalers: Focus on the VENTOLIN™ mini spacer. Expert Opin Drug Deliv 2018; 15(4): 419-30.
14Data on file
15Jindal SK, Gupta D, Aggarwal AN, et al — Guidelines for management of asthma at primary and secondary levels of health care in India (2005). Indian J Chest Dis Allied Sci 2005; 47(4): 309-43.
16Global Initiative for Asthma. Pocket guide for asthma management and prevention, 2019. https://ginasthma.org/ wpcontent/ uploads/2019/04/GINA-2019-main-Pocket-Guidewms.pdf (accessed Aug 29, 2022): 1-39.
60 Submit Article in JIMA - Online See website : https: // onlinejima.com Any queries : (033) 2237-8092, +919477493027; +919477493033
Review Article
Prevention Strategies to De-escalate Workplace Violence against Doctors…
Puja Bansal1, Anirban Das2
Workplace violence is something we can discuss it, tolerating it but we can’t prevent it even we can’t accept it that it belongs to us, we are initiating it against people like us only. Nothing can solve violence, neither two wrong can make anything right. Though every sector is afflicted by it but healthcare sector is majorly affected by it because patients family is in great trauma of facing their people’s death and no one have been able to do anything to stop it. Accepting loved ones especially death has always been painful to everyone. But blaming some sector and taking revenge is big NO NO. As we all know prevention is better than cure so via this paper I am trying to address some prevention Strategies that may be helpful to de-escalate this issue on ground level.
[J Indian Med Assoc 2022; 120(12): 61-3]
Key words :Workplace violence, Government laws, Standalone training, Prevention Strategies.
Workplace violence has always been serious problem for doctors and healthcare workers as they have always been dealing with emotional breakdowns and loss of life on patients’ family. However violence at workplace exists almost in everywhere and in every sector. This even exists in both developed and developing countries (Liu J, et al, 2019) and can be declared as top most occupational hazards.. there can’t be universal formally accepted definition of workplace violence as this is subjective concept and everyone carries different opinions and beliefs (N Imran, et al, 2013).
The Occupation Health and Safety Act, 2019 defines workplace violence as “the exercise of physical force by a person against a worker, in a workplace, that causes or could cause physical injury to the worker; a statement or behaviour that it is reasonable for a worker to interpret as a threat to exercise physical force against the worker, in a workplace, that could cause physical injury to the worker (OSHA, 2019)”.
This has always been serious issue to a sector who is engaging themselves in keeping nation healthy but failed to same themselves. According to report of IMA 75% of Doctors faced workplace violence atleast once in their career. Thousands of cases had been reported but no serious action has been taken till now. From Worldwide protest to hunger strike everything went in vein.
Now with this paper we as a author tried to point
1Research
2MBBS,
Received on : 17/08/2022
Accepted on : 15/09/2022
Editor's Comment :
To de-escalate workplace violence, different strategies need to be taken such as standalone coaching, structured programme, multicomponent interventions, recordkeeping and program analysis. Apart from these, government should also take necessary steps like non-bailable offense with strict penalty.
some basic strategies that can be adopted to prevent workplace violence before it goes extremely dangerous for doctors.
These strategies are based on multiple studies includes Government role to de-escalate it.
Standalone Coaching :
The studies deals with the aggressive work place voilence that tend to done by nurse and hospital workers. Two studies were included in the research which assess the effectiveness of three to four hours of coaching on violence. Study also added the financial impact of workplace violence on the hospital. Other studies based on imapct of shorter coaching session that targeted violence managemnt and team work were also included. These studies concluded that intraction of nurses with their colleagues improved by the coaching and their level of comfort also increased during handling important conversations. Also, nurse replacement rate were also reduced due to standalone coaching. Study by Al Alietal, reported nurses were confidence enough to handle workplace violence once they have successful completed eight-hours of coaching session. There is no alteration of the basic safety issues in the coaching. It can be concluded the standalone coaching is definitely helpful however, it is effective at distinct parts of workplace violence. It fails
Vol 120, No 12, December 2022Journal of the Indian Medical Association
Scholar, Guru Jambheshwar University, Hisar 125001 and Corresponding Author
Final Year Student, IQ City Medical College, Durgapur 713206
61
of the Indian Medical Association
to provide substantive impact on the violence faced by the nurses1
Structured Programme :
Structured teaching programs take issue from standalone coaching primarily in duration. These structured programs typically span weeks, permitting participants to absorb information info. The commonly seen perpetrators of this particular type of workplace violence are often seen as coworkers of victim, nurse managers or supervisors, and sometimes physicians. In two of the considered studies, how to deal with verbal aggression and psychological/emotional abuse were the primarily focus of the structured education program. In this, the common perpetrators were observed as patients and their relatives. Apart from having different prime focus points, the eleven studies adopt additionally used dissimiliar sorts of structured teaching programs in their interventions. for example, five of the included studies used or adopted a Cognitive Rehearsal Program (CRP).
CRP could be a technique whereby specific situations are role-played in an exceedingly structured method, expedited by trained professionals. Using CRP, nurses got the chance to firstly analyse and then apply what could be the most effective response to common violent behaviors. In keeping view the findings of the four major studies that had applied CRP as their intervention to workplace violence, it was shown as CRP enables nurses to build up their cope ability and hindrance skills against workplace adverse situations. It will facilitate improve participants’ social bondings with each other and boost awareness regarding violence between nurses. So it can be concluded as CRP might play a handsome role in reducing nurse turnover1
Train-the-trainer programs are designed to coach bound ‘champions’ on the workplace supervisor, who learn and later on go onto their colleagues and train them. In simple words this system is meant to facilitate the unfold of specialist data in an economical, efficient manner. No of studies it was commonly observed trainthe-trainer workshops pointed on controlling or solving lateral violence by giving strength to nurses’ communication skills. Over the years of three, 203 workshops were conducted with 4,000 participants. The study showed that verbal abuse towards nurses attenuated from nineteenth to seventy six, and nurses’ awareness of verbal abuse influencing their patient care accumulated from forty second to sixty three, following the implementation of workshops by trained facilitators1
Chipps and McRury two authors have evaluated
the effectiveness of a three to four months of education program where they majorly focus on communication and conflict management skills to handle workplace bullying. This study discovered accumulated job satisfaction in participants.
Multicomponent Interventions :
This involves an action set up wherever multiple ways were enforced across 3 categories:
(1) Environmental that includes panic buttons, security locks.
(2) Administrative policies to deal with workplace violence hindrance, safety procedures.
(3) behavioural (staff coaching for workplace violence management).
Study by Arnetz, et al If this successfuly implemented in a unit that will surely results in reduction in workplace violence rates. Another study by Arnetz, et al. Where he used a three-staged intervention model, additionally that includes the involvement of relevant stakeholders too. It includes :
(1) Development of a formal and standardized reporting system for workplace violence
(2) application of a hazard risk matrix to spot most accumulated risk spots work units of workplace violence.
(3) Worksite walkthrough strategy.
This study shown a significant reduction in the rate of workplace violence within the intervention units as compared to manage units (IRR: 0.48, 95% CI 0.29e0.80) at six months and at twenty four months (IRR 0.37, 95% CI 0.17e0.83).
Similarly, in a new study a 3 pronged intervention model featuring:
(1) conferences with all shareholders and directors to revise and formulated workplace violence policies time to time.
(2) Walkthrough conferences with health care professionals for environmental changes if required.
(3) Education and coaching sessions for employees.
On the application of these steps, there might be a big cut in the rate of assaults and violent threats fully fledged by nurses collaborating within the study.
Two alternative studies additionally took a multicomponent approach, though they didn’t feature the broad involvement of relevant stakeholders. Of these, study used a two-phase intervention:
(1) Implementation of alert system to spot risky patients upon admission
(2) Nursing employees coaching for hindrance of geographic point violence6
Vol 120, No 12, December 2022Journal
62
Record Keeping and Program Analysis :
Recordkeeping and analysis of the violence hindrance program must be done properly to see its overall effectiveness and to check any deficiencies or changes that ought to be created2
Proper recording system should be implemented of patients history where everything should be clearly written what kind of injury or illness patient was suffering from, what line of treatment was given, how about the progress, severity of problem and etc. that will surely help employers about the severity of problem and establish any developing trends or patterns above all locations, jobs or departments; measure ways of hazard control; establish coaching needs and develops solutions for an efficient program. And Records will be helpful to organizations and for members of a trade association that “pools” information2
As a part of their overall program, owners/ shareholders ought to measure their safety and security measures. prime management ought to analyse the program often and, with each and every situation so arise to evaluate its success and whom to accountable (including managers, supervisors and employees) ought to revise and reformulate policies and how to solve on a continuous basis to point problems and then how can it be corrected.
Management should share workplace violence prevention analysis reports regularly with whole of staff. Any changes within the program ought to be mentioned at regular conferences of the protection committee, union representatives or alternative worker teams. What Government can Do :
The Government officials and the political leaders are the general public appearance up to for steering and solutions. they must set the example and shouldn’t intend to do by force. they must condemn such acts instead of carry on them. there’s a high time to implement formalized law to safeguard rights of doctors throughout the country. It needs to be included in Indian penal code with declaration of non bailable offense with strict penalization. An appeal against doctors by patients’ family has to be deemed infructous if proof of violence is provided by hospital and even penalize for false complaint filling. The Government should pay attention towards filling of vacant post, additional security system to safeguard as well as Doctors. Some mishappening occurs due to shortage of sufficient infrastructure, medicines at Government hospitals that need to be solve by Government at their own level. thereby departure the doctors within the tertiary care centers to give more
time and attention to cases that need masterful intervention from them. a significant drawback is delay in reaching the hospital is too a major cause of death that can be solved by Government by opening primary and seconday hospitals, with better connectivity of roads, with transportation and ambulance facility. Paramedical coaching ought to run a lot of importance so cases of trauma may be may be and through transportation3.
Conclusion :
From as a society to Government everyone needs to be involved in this process of saving Doctors. But what major role is to play by Government by implementing strict actions and laws against culprit. Passing law on central level, declaring it non bailable offense to include in rare of rarest case, everything has to be done immediately. Apart from it we as a human being has to accept this fact they can treat us neither of them can assure life. Life and death is in jands of destiny, no one has incharge of it so it is useless to harm some sector which is atleast trying to make people healthy always. Without them no one would ever be able to calculate death rate. So it’s better to accept out responsibility towards them.
REFERENCES
1Int J Environ Res Public Health 2015, 12, 14429-14444; doi:10.3390/ijerph121114429
2activity Safety and Health Act of 1970 (OSH Act or Act)
3Sen M, Honavar SG — It’s a doc’s life – geographic point violence against doctors. Indian J Ophthalmol 2019; 67: 9814.
4Liu J, Gan Y, Jiang H, Li L, Dwyer R, Lu K, et al — Prevalence of workplace violence against healthcare workers: a systematic review and meta-analysis. Occup Environ Med 2019; 76(12): 927e37. https://doi.org/10.1136/oemed-2019105849.
5Imran N, Pervez MH, Farooq R, Asghar AR — Aggression and violence towards medical doctors and nurses in a public health care facility in Lahore, Pakistan: a preliminary investigation. KHYBER Med Univ J 2013; 5(4): 179e84.
6Somani R, Muntaner C, Hillan E, Velonis AJ, Smith P. A systematic review: effectiveness of interventions to deescalate workplace violence against nurses in healthcare settings. Safety and health at work 2021; 12(3): 289-95.
Workplace violence in school boards: a guide to the law: workplace violence under the Occupational Health and Safety Act | Ontario.ca [Internet]. [cited 2020 Jul 15]. Available from: http s://www.ont ario.ca/document/workplaceviolence-school-boards-guide-law/workplace-violenceunder-occupational- health-and-safety-act.
Vol 120, No 12, December 2022Journal of the
Indian Medical Association
63
Case Report
An Uncommon Presentation of a Common Etiology : Tubercular Cerebral Abscess in Pulmonary TB
Upoma Saha1, Sriradha Chatterjee2, Srijib Pal3, Navoneel Debnath4, Salil Kumar Pal5
A patient, recently diagnosed with Pulmonary Tuberculosis and on ATT for the last 1 month, was initially admitted in a primary care setup with severe headache and altered consciousness for 5 days and then referred to our institute for further management. Extensive investigations and imaging led to the conclusion that the patient had a massive Tubercular Brain Abscess (TBA) in the background of Pulmonary TB. [J Indian Med Assoc 2022; 120(12): 64-6]
Key words :Fever, Headache, Tubercular, Cerebral abscess, NCCT Brain, MRI Brain.
Tuberculous Brain Abscess (TBA) is a rare presentation of Central Nervous System (CNS) tuberculosis. They often present with focal neurological signs, and are associated with a past history of tuberculosis. The following is a case report on one such patient encountered in our hospital setup.
CASE REPORT
A 60-year-old male from Kultali, South 24 Parganas, West Bengal, presented with the chief complaint of fever, headache and altered sensorium for last 5 days and was admitted to a primary care setup from where he was referred to our hospital for further management. On admission, he was unconscious with a GCS of 8. There was history of high-grade fever for last 2 days, recorded as 102oF on a single occasion, not associated with chill and rigor and subsided temporarily with medication. There was no history of trauma, vomiting or any episode of seizures on presentation.
One month back, patient had presented with a history of low grade temperature for 2-3 weeks, night sweats along with loss of weight (undocumented), and right sided chest pain. Initial investigations including Chest X-ray and HRCT thorax were done which was reported as- pleural effusion and right lower lobe consolidation with subcentimetric mediastinal

Department of General Medicine, Calcutta National Medical College and Hospital, Kolkata 700014
1MD, Postgraduate Trainee and Corresponding Author
2MD, Senior Resident
3MD, 3rd year Postgraduate Trainee
4MD, 1st year Postgraduate Trainee
5MD, Professor
Received on : 17/08/2022
Accepted on : 18/10/2022
Editor's Comment
:
Tubercular Brain Abscess is a rare manifestation of CNS tuberculosis in adults, whose clinical presentation mimics that of pyogenic meningitis and poses a diagnostic challenge. It is rare even in a country like India where tuberculosis has a high prevalence and requires a high degree of clinical suspicion.
Histological evidence may not always be available.
ATT should be started as early as possible in all cases to limit the extent of complications before contemplating surgical intervention if TBA is considered as the diagnosis.
lymph nodes? Koch’s etiology (Figs 1 & 2). Pleural fluid analysis was done and a diagnosis of ‘microbiologically confirmed TB’ was made based on which patient was started on ATD as per regimen (3 tabs 4 FDC) on
05.04.2022
He had been on regular medication till his condition started deteriorating 1 week back and he was unable to take oral feed properly.
There was a history of CVA with left sided hemiparesis 2 years back, with no residual paralysis. Patient was hypertensive, but on irregular medication for the same.
Vol 120, No 12, December 2022Journal of the Indian Medical Association
64
Figs 1 & 2 — (1) Dig CXR showing Right lower lobe consolidation and (2) HRCT thorax report
He had no known addictions, there was no history of high-risk behaviour. His family history was non-contributory as well.
Patient was unconscious at the time of admission and regained consciousness within a few hours after conservative management. Pulse rate was 100/min, respiratory rate 22/min, and BP recorded on admission was 120/80 mm Hg. Sp0 2 was 96% in room air. Temperature was 101 deg F.
His higher mental function could not be assessed at the time of admission. Tone was reduced in all four limbs and plantar reflex was found to be extensor bilaterally. Signs of meningeal irritation were absent. Pupils were normal in size bilaterally and reacting sluggishly to light. When he regained consciousness, he was disoriented and restless.
An urgent NCCT Brain was done at admission which showed the following (Figs 3 & 4) : -
Immediate measures were taken to reduce the patient’s intracerebral edema, ATT was continued and the patient slowly regained orientation over the next 24 hours. A Neuromedicine and Neurosurgical consult was sought and patient was advised MRI Brain (contrast) with a MR Spectroscopy.

Initial laboratory investigations showed low Haemoglobin (7 gm/dl), Total Leucocyte Count of 3800, Differential Leucocyte count – lymphocyte count of 400, neutrophil : 3200, Urea, Creatinine, Sodium, Potassium, Liver Function Tests within normal range. His ICTC report was non-reactive.
MRI Brain with contrast and MR Spectroscopy (Figs 4 & 5) was done, which revealed the following : -

“Large peripherally rim-enhancing irregular shaped cystic lesion about [(AP) 40.4 mm * (TR) 58.4 mm * (CC) 36.8 mm] showing incomplete internal septae, significant perilesional edema and mass effect at left fronto-parietal region showing MRS featureslikely Tubercular Cerebral Abscess.
Microangiopathic chronic ischaemic changes in bilateral periventricular deep white matter, centrum semiovale, bilateral cerebral subcortical white matters.
Cerebrospinal Fluid (CSF) intensity chronic lacunar infarcts at bilateral basal ganglia and right paraventricular deep white matter regions.”
Patient improved gradually
over the next 48 hours with medical management. Spontaneous eye opening was present, he was responsive to verbal commands and oriented to time, place and person. Given the infrastructural constraints, we were not able to microbiologically prove the presence of AFB or M tuberculosis from a cerebral pus aspirate. However, taking into consideration the patient’s background of pulmonary TB and the MRI Brain with MRS analysis, it was considered prudent to maintain him on ATT and steroids after due consultation with the Neurology department. The trajectory of the patient’s hospital stay was satisfactory.
DISCUSSION
Tuberculous Brain abscess (TBA) is a rarely reported form of CNS tuberculosis, occurring in 4-8% of non HIV patients. Despite the low frequency ( only around 1% of extra-pulmonary tuberculosis cases)2, it is given special importance because of the very high mortality associated with it. It is a focal collection of pus containing abundant Acid-fast Bacilli (AFB) surrounded by a dense capsule comprising vascular granulation tissue. The abscess is often single, sometimes multilocular and accompanied by greater perilesional oedema3. TBA is an uncommon clinical entity even in countries where TB is endemic4.
TBA always poses a diagnostic dilemma as they are difficult to differentiate from pyogenic brain abscesses,
Vol 120, No 12, December 2022Journal of the
Medical Association
Indian
Figs 3 & 4 — NCCT Brain – a large area of ? cavitation in the left fronto-parietal area with surrounding perilesional edema and midline shift
65
Fig 4 (B) — Choline Creatinine peak >2 , prominent lipid lactate peak
Tuberculous Meningitis and Tuberculoma on the basis of clinical, laboratory and roentgenographic information. They are more frequently encountered in patients who are immunocompromised. Patients with tuberculous abscess present nonspecifically, with focal neurological deficits, seizures or signs and symptoms of raised intracranial pressure. These brain abscesses, like tuberculomas, are probably secondary to haematogenous dissemination from a primitive site, most often pulmonary5

Mycobacterium Tuberculosis can be isolated from the pus (ZN stain, AFB demonstration or PCR) which is sometimes unable to be isolated from Tuberculomas.
Approach to management is medico-surgical. ATT along with corticosteroid therapy have been shown to improve mortality in multiple studies. Studies show that it reduces mortality and neurological sequelae in patients with a medium severity picture (confusion, focal signs) and also in comatose patients6
Surgical drainage is often curative and the mainstay of treatment for large abscesses, though associated with its own risks and sequelae. Progression under antituberculosis treatment is not discriminatory diagnostic evidence. Several observations have reported the development of Tuberculous Abscesses under wellconducted specific treatment as was also seen in our patient7,8
CONCLUSION
TBA still remains a topic of concern and intrigue due to poor prognosis despite medical and surgical intervention. Despite best efforts and management under specialist care, outcomes in majority of patients have not thus far been as promising as hoped and expected. Given the rarity of the condition, even among the CNS TB manifestations, it remains an area of research and development. One of the reasons for the morbidity and mortality could be due to the late presentation seen in majority of patients and concomitant presence of an immunocompromised state.
Patient would need integrated approach with neurosurgical intervention and Neuromedicine consultation. The following was done from our end after management with ATT and steroids. Patient was ultimately lost to follow-up.
REFERENCES
1Boukobza M, Tamer I, Guichard JP, Brunereau L, Polivka M, Leibinger F, et al — Tuberculose du système nerveux central. Aspects IRM et évolution à propos de 12 cas. J Neuroradiol 1999; 26: 172-8.
2Gavazzi G, Bouchard O, Queyrel V, Bosseray A, Leclercq A, Micoud M — Vascularite et miliaire cérébrale d’origine tuberculeuse: aggravation sous traitement adapté. Rév Med Interne 1998; 19: 1.
3Kilani B, Ammari L, Tiouiri H, Goubontini A, Kanoun F, Zouiten F — Manifestations neuroradiologiques initiales de la tuberculose du système nerveux central de l’adulte. À propos de 122 cas. La Revue de Médecine Interne 2003; 24: 86-96.
4Bottieau E, Noe A, Florence E, Colebunders R — Multiple tuberculous brain abscesses in an HIV-infected patient successfully treated with HAART and antituberculous treatment. Infection 2003; 31: 118-20. [PubMed] [Google Scholar]
5Felten-Papaiconomou A, Ruf C, George B — Les abcès du cerveau tuberculeux. A propos de deux cas. Médecine et Maladies Infectieuse 1981; 1: 33-6
6Cerebral abscesses of tuberculosis origin: study of 8 cases at the University Hospital of Conakry :Barry HYPERLINK “https:/ /ejns.springeropen.com/articles/10.1186/s41984-020-00090x”LouncényHYPERLINK “https://ejns.springeropen.com/ articles/10.1186/s41984-020-00090-x” HYPERLINK “https:// ejns.springeropen.com/articles/10.1186/s41984-020-00090x”Fatoumata, Souare Ibrahima Sory, Cissé Fodé Abass. Egyptian Journal of Neurosurgery volume 35, Article number: 20 (2020)
7David M, Benda R, Benda P — foyer confluent encéphalique de nécrose suppurée tuberculeuse : vérification bactériologique per-opératoire. Rev Neurol 1954; 90: 854-6.
8Decuns P, Garre H, Pascalis G —. Abcès froids miliaires du cerveau, du cervelet et du tronc cérébral chez un tuberculeux traité par antibiotiques. Rev Otoneuroophtalmol 1956; 28: 250-5.
Vol 120, No 12, December 2022Journal of the Indian Medical Association
Fig 4 & 5 — Large peripherally rim-enhancing irregular shaped cystic lesion about [(AP) 40.4 mm * (TR) 58.4 mm * (CC) 36.8 mm] showing incomplete internal septae, significant perilesional edema and mass effect at left fronto-parietal region
66
Case Report
Mixed Germ Cell Ovarian Tumour in an 8-year-old Child — A Case Report
Bijan Kumar Saha1, Richa Sharma2
In paediatric population occurrence of ovarian cancer is rare. In this study, an 8-year-old girl was diagnosed mixed malignant ovarian Germ Cell Tumuor (GCT), with predominantly Embryonal Carcinoma component (95%) and focal dysgerminoma component (5%). The patient presented with dull aching pain abdomen and mass in abdomen. On examination mass occupied whole of abdomen, hard in consistency, mobile and lower border per vaginally occupying right fornix. CECT abdomen was done which showed a well-defined solid cystic mass measuring 24.1x 18.7x 14.9 cm mass arising from the right adnexa causing suggestive of malignancy. Uterus, right ovary and rest of the peritoneal cavity was normal. CECT chest was normal. Tumour markers S. Beta-hCG was 27,601.44 mIU/mL, S. LDH was 1735 IU/mL, S. AFP was >400 ng/ mL and S.CA-125 was 114.5IU/mL. After multidisciplinary tumuor board discussion patient was planned for staging ovarian laparotomy (fertility preserving surgery). Intraoperatively ascites was present, right ovary was enlarged measuring about 25x15 cm occupying whole of abdomen, adherent to small bowel, fundus of uterus and right fallopian tube. Left ovary, Fallopian tube and Uterus was normal. Right pelvic and paraaortic lymph nodes was enlarged. Liver, bilateral diaphragm and rest of the peritoneal cavity normal. Procedure done was excision of right ovarian mass with right salpingectomy, bilateral pelvic lymph node dissection, retroperitoneal lymph node dissection, greater omentectomy and peritoneal biopsies. On histopathology right ovary was reported as poorly differentiated neoplasm. In retroperitoneal lymph nodes 1 out 15 lymph nodes showed tumour deposits measuring 0.2cm. Right fallopian tube, bilateral pelvic lymph nodes, greater omentum, peritoneal biopsies and ascitic fluid were free of tumour. On immunohistochemistry (IHC), right ovary tissue was positive for SALL4 and PLAP (germ cell tumour marker). CD30 (Embryonal carcinoma marker) was diffusely positive and CD117 (dysgerminoma marker) was focally positive. It was negative for Beta-hCG (choriocarcinoma marker), AFP (yolk sac tumour marker), EMA (epithelial marker), Calretinin (sex cord stromal tumour marker) and Inhibin (sex cord stromal tumuor marker). From above findings, diagnosis of FIGO stage III A1 (ii) (T1cN1aM0) mixed malignant GCT was made. Patient was advised adjuvant chemotherapy with Bleomycin, Etoposide and Cisplatin (BEP).
[J Indian Med Assoc 2022; 120(12): 67-9]
Key words :Mixed Germ Cell Tumuor, Ovary, Child.
In paediatric population ovarian neoplasms are rarely seen. Annual incidence of ovarian cancer in paediatric population is about 2.2 cases per 1 lakh girls. 27% of all ovarian tumours in females less than 16 years are malignant 1 . Ovarian cancer represents 1.1% of all childhood malignancies2. In contrast to adults in whom epithelial carcinoma of ovary are common, whereas in paediatric population malignant Germ Tumours (GCTs)of ovary are more common 3 . The overall prognosis for patients with malignant Germ Cell Tumour is excellent3 Though understanding about etiology and pathogenesis of epithelial ovarian cancer has improved recently but understanding of etiopathogenesis of malignant ovarian GCTs has not improved 4 . Reporting a case of mixed malignant GCT diagnosed in an 8-year-old girl.
1MBBS, MS (General Surgery), DNB (Surgical Oncology), Assistant Professor, Department of Surgical Oncology National Institute of Medical Sciences And Hospital, Jaipur 303104 and Corresponding Author
2MBBS, MD (Pathology), Consultant Pathologist, Department of Pathology, Unipath Laboratory, Jaipur 302004
Received on : 30/11/2021
Accepted on : 18/10/2022
Editor's Comment :
Ovarian cancers are rare in paediatric age groups. Multidisciplinary team is required to treat the patients. Staging ovarian surgery is the standard of care. Fertility preservation surgery should be done whenever possible.
Neoadjuvant chemotherapy should be used to decrease the tumour burden to increase the chance of fertility preservation.
CASE REPORT
8-year-old girl with no significant family history presented with dull aching pain abdomen and mass in abdomen. On examination mass occupied whole of abdomen, hard in consistency, mobile and lower border per vaginally occupying right fornix. CECT abdomen was done which showed a well-defined solid cystic mass measuring 24.1x 18.7x 14.9 cm mass arising from the right adnexa causing right reflex hydrouteronephrosis suggestive of malignancy. Uterus, right ovary and rest of the peritoneal cavity was normal. CECT chest was normal. Tumour markers S. Beta-hCG was 27,601.44 mIU/mL, S. LDH was 1735 IU/mL, S. AFP was >400 ng/
Vol 120, No 12, December 2022Journal of the Indian Medical Association
67
mL and S.CA-125 was 114.5IU/mL. After multidisciplinary tumuor board discussion patient was planned for staging ovarian laparotomy (fertility preserving surgery). Intraoperatively ascites was present, right ovary was enlarged measuring about 25x15 cm occupying whole of abdomen, adherent to small bowel, fundus of uterus and right fallopian tube. Left ovary, Fallopian tube and Uterus was normal. Right pelvic and paraaortic lymph nodes was enlarged. Liver, bilateral diaphragm and rest of the peritoneal cavity normal. Procedure done was excision of right ovarian mass with right salpingectomy, bilateral pelvic lymph node dissection, retroperitoneal lymph node dissection, greater omentectomy and peritoneal biopsies. On histopathology right ovary was reported as poorly differentiated neoplasm with capsular breach. In retroperitoneal lymph nodes one out 15 lymph nodes showed tumour deposits measuring 0.2 cm. Right Fallopian tube, Bilateral pelvic lymph nodes, Greater omentum, Peritoneal biopsies and Ascitic fluid were free of tumour. OnIHC, right ovary tissue was positive for SALL4 and PLAP (germ cell tumour marker). CD30 (Embryonal carcinoma marker) was diffusely positive and CD117 (dysgerminoma marker) was focally positive. It was negative for Beta-hCG (choriocarcinoma marker), AFP (yolk sac tumour marker), EMA (epithelial marker), Calretinin (sex cord stromal tumour marker) and Inhibin (sex cord stromal tumuor marker). From above findings, diagnosis of FIGO stage III A1(ii) (T1cN1aM0) mixed malignant GCT was made5. Patient was advised adjuvant chemotherapy with Bleomycin, Etoposide and Cisplatin (BEP regimen)for 4 cycles which patient refused. Patient had no recurrence on 1 year follow up (Figs 1-4)..
DISCUSSION
In children and adolescents, GCTs are the most common variety of ovarian tumours histologically and they are mostly benign6,7. In India most common type of GCT is dysgerminoma followed by teratoma 8. Incidence of mixed malignant Germ Cell Tumour is extremely rare. In one study done by Khanna, et al most common combination of subtypes were Yolk Sac tumour and immature teratoma. Mature and immature teratoma combination was second most common followed by combination of Yolk Sac tumuor and embryonal
Fig 2 — Showing postoperative excised specimen of right ovary.

Fig 3 — Showing IHC on right ovary tumour was positive for SALL-4 (germ cell tumour marker).


Fig 1 — CECT
Fig 4 — Showing IHC on right ovary tumour was diffusely positive for CD 30 (Embryonal carcinoma marker).
carcinoma being third most common9 World Health Organisation (WHO) classifies ovarian GCTs into many histological subtypes. Subtypes are : (1) Dysgerminoma, (2) Yolk Sac tumours, (3) Embryonal carcinoma, (4) Polyembryoma, (5) Choriocarcinoma, (7) Teratomas and (8) Mixed GCTs10. Dysgerminoma is most common followed by Yolk Sac tumuor also known endodermal sinus tumour 10 . In our patient, on histopathological examination and IHC revealed a combination two types tumours hence term as mixed GCT. 95% of tumour stained with IHC marker CD30 (Embryonal carcinoma marker) and 5% of tumour stained with CD117 (dysgerminoma marker). Most paediatric

Vol 120, No 12, December 2022Journal of the
Association
Indian Medical
of abdomen and pelvis tumour arising from right ovary occupying whole of abdomen with ascites.
68
of the Indian Medical Association
patients with ovarian GCTs present between age 20-30 years11. Patients generally remain asymptomatic till ovarian mass grows to a large size causing abdomen pain adjacent organ compression. Less common presentations are vaginal bleeding, constipation and amenorrhoea. Sometimes they present as complication secondary to ovarian mass such as rupture of themass, infraction or torsion1. One-third of GCTs have extra-gonadal origin such as vagina, mediastinum, pineal gland, cervix, endometrium and sacrococcygeal area12-14
Surgery is main treatment of ovarian GCT. Fertility preservation surgery should be done whenever possible ie, preservation of uterus and opposite side ovary. When in doubt, opposite ovary biopsy should be taken before excision. Staging ovarian laparotomy is should be done to stage the disease15. Principles of staging surgery is defined by Children Oncology Group (1) Intact ovarian removal without rupture of the tumuor capsule. A salpingectomy must be performed if the fallopian tube is adherent. (2) Examination of the contralateral ovary with biopsy if a suspicious aspect is seen. (3) Inspection of the peritoneum, the liver and the omentum and resection of any abnormal tissue. (4) Inspection of aorto-caval and iliac lymph nodes and biopsy of suspicious ones. 5. Sampling of ascitic fluid for cytological examination. If ascites is absent, a washing is required 16,17. Adjuvant chemotherapy should be used for tumours of FIGO any stage embryonal carcinoma and yolk sac tumour, stage II-IV dysgerminoma, Stage I with grade 2 or 3 and above immature teratoma18. BEP regimen is treatment of choice for treating ovarian GCTs 19 . Whenever extensive is disease is noted, neoadjuvant chemotherapy followed by surgery can be considered.In a study done by Rudaitis, et al showed that use neoadjuvant chemotherapy can significantly decrease the tumour size which minimizes the extent of surgery and thus helps in preserving fertility20. Overall prognosis of patients with ovarian GCT is excellent3
CONCLUSION
Ovarian tumours are rare in paediatric age group specially mixed ovarian Germ Cell Tumours. Multidisciplinary team is required to treat the patients. Coordination between paediatricians, surgical oncologist, medical oncologists, radiologists and pathologists is important for diagnosis and treatment. Surgery (staging ovarian laparotomy) is the standard of care. Fertility preservation surgery should be done whenever possible. Neoadjuvant chemotherapy should be used to decrease the tumour burden to enhance fertility preservation. Adjuvant chemotherapy should be used for tumours of FIGO any stage embryonal carcinoma and Yolk Sac tumour, stage II-IV dysgerminoma, Stage I with grade 2 or 3 and above immature teratoma.
REFERENCES
1Taskinen S, Fagerholm R, Lohi J, Taskinen M — Pediatric ovarian neoplastic tumors: incidence, age at presentation,
tumor markers and outcome. Acta Obstet Gynecol Scand 2015; 94(4): 425-9.
2Young JL Jr, Miller RW — Incidence of malignant tumors in U. S. children. J Pediatr 1975; 86(2): 254-8.
3Baert T, Storme N, Van Nieuwenhuysen E, Uyttebroeck A, Van Damme N, Vergote I, et al — Ovarian cancer in children and adolescents: A rare disease that needs more attention. Maturitas 2016; 88: 3-8.
4Chen Z, Robison L, Giller R, Krailo M, Davis M, Gardner K, et al — Risk of childhood germ cell tumors in association with parental smoking and drinking. Cancer 2005; 103(5): 106471.
5James D. Brierley, Mary K — Gospodarowicz, Christian Wittekind. UICC TNM Classification of Malignant Tumours.8th edition. West Sussex: Wiley Blackwell 2017.179p.
6Young JL Jr, Cheng Wu X, Roffers SD, Howe HL, Correa C, Weinstein R — Ovarian cancer in children and young adults in the United States, 1992-1997. Cancer 2003; 97(1): 2694700.
7Koonings PP, Campbell K, Mishell DR Jr, Grimes DA — Relative frequency of primary ovarian neoplasms: a 10-year review. Obstet Gynecol 1989; 74(6): 921-6.
8Maheshwari A, Gupta S, Parikh PM, Tongaonkar HB — Malignant germ cell tumor ovary—experience at Tata Memorial Hospital. Indian J Med Paediatr Oncol 2004; 25(1): 43.
9Khanna S, Arya NC, Gupta IM, Gupta S, Singhal GD — Germ cell tumors in Indian children. J Surg Oncol 1988; 37(4): 2358. doi: 10.1002/jso.2930370405. PMID: 2834607.
10Chen VW, Ruiz B, Killeen JL, Coté TR, Wu XC, Correa CN — Pathology and classification of ovarian tumors. Cancer 2003; 97(10): 2631-42.
11Cecchetto G — Gonadal germ cell tumour in chidren and adolescents. J Indian Assoc Pediatr Surg 2014; 19(4): 18994.
12Meriem Elbaz, Rabiy El Qadiry, Karima Fouraiji, Hicham Jalal, Jamila Elhoudzi. Yolk sac tumor of vagina: a rare cause of vaginal bleeding in adolescents - a case report. Pan African Medical Journal 2020; 37(169). 10.11604/ pamj.2020.37.169.20949.
13Sudour-Bonnange H, Orbach D, Kalfa N, Fasola S, Patte C — Germ cell tumors in atypical locations: experience of the TGM 95 SFCE trial. J Pediatr Hematol Oncol 2014; 36: 646-8.
14Lightfoot MA, Bilgutay AN, Kirsch AJ — A rare case of pediatric vaginal yolk sac tumor. Urology 2018; 119: 137-9.
15DeVita, Vincent T, Jr, Theodore S — Lawrence, and Steven A. Rosenberg. Devita, Hellman, and Rosenberg’s Cancer: Principles & Practice of Oncology. 10thedition. Philadelphia: Wolters Kluwer 2015. 1628p.
16Billmire DF — Malignant germ cell tumors in childhood. Semin Pediatr Surg 2006; 15(1): 30-6.
17Göbel U, Calaminus G, Engert J, Kaatsch P, Gadner H, Bökkerink JP, et al — Teratomas in infancy and childhood. Med Pediatr Oncol 1998; 31(1): 8-15.
18National Comprehensive Cancer Network. (2017). Malignant germ cell tumour (version 4.2017). Retrieved from https:// www.nccn.org/professionals/physician_gls/pdf/ovary.pdf
19Williams S, Blessing JA, Liao SY, Ball H, Hanjani P— Adjuvant therapy of ovarian germ cell tumors with cisplatin, etoposide, and bleomycin: a trial of the Gynecologic Oncology Group. J Clin Oncol 1994; 12: 701-6.
20Rudaitis V, Mickys U, Katinaite J, Dulko J — Successful treatment of advanced stage yolk sac tumour of extragonadal origin: a case report and review of literature. Acta Med Litu 2016; 23: 110-6.
Vol 120, No 12, December 2022Journal
69
Case Report
The Rare Imitator : Pulmonary Nocardiosis Mimics Tuberculosis Reactivation
Ruchi Arora Sachdeva1, Juhi Taneja2, Litika Verma3, Manas Kamal Sen4, Kamran Chaudhary5, Amrita Swati6, Avinash Kumar6
Pulmonary Nocardiosis is a rare bacterial infection of lungs, caused by a filamentous bacterium. Immunocompromised people are known to be at danger, but there are other new emerging risk factors to consider. The presentation and clinical course in such patients differ from the previous. Here the present case is aimed to underline the presentation and diagnosis in non-risk individual.
[J Indian Med Assoc 2022; 120(12): 70-3]
Key words :Nocardiosis, Filamentous Fungus, Immunocompromised, TMP-SMX.
When Global economic expansion began in the 18th century, the Western World was still in its infancy and contagious diseases were rife among the populace. Koch and Pastuer, two of the greatest figures and Fathers of Microbiology, devised the germ theory of diseases, which paved the path for the discovery of disease-causing microbes. Edmond Nocard, a French Veterinarian and Microbiologist, was an assistant to Koch’s adversary and Father of Bacteriology Louis Pasteur at the time when Koch discovered Tubercle Bacilli. He was fascinated by diseases that were passed from people to animals. His most significant contribution to medicine was isolating a filamentous fungus, that caused bovine farcy in economically important animals. The novel microbe was named Nocardia after him. He discovered that Nocardia can cause Nocardiosis in humans, which primarily affects the Central Nervous System (CNS) or immunocompromised individuals. Nocard was also interested in the relation of tuberculosis in animals with that of humans, he published literature on bovine tuberculosis, tuberculin test in cattles, bovine pleuro pneumonia agent14
The finding of this bacteria by Edmond, who was working so closely with tuberculosis, couldn’t have
Department of Respiratory Medicine, ESIC Medical College and Hospital, Faridabad, Haryana 121012
1MBBS, DTCD, DNB, MNAMS, Associate Professor and Corresponding Author
2MD (Microbiology), Assistant Professor, Department of Microbiology
3MBBS, Junior Resident
4MD (Respiratory Medicine), Professor
5MD (Respiratory Medicine), Assistant Professor
6MD (Respiratory Medicine), Senior Resident
Received on : 03/02/2022
Accepted on : 15/02/2022
Editor's Comment :
Nocardia can cause infection in both immunocompetent and immunocompromised hosts.
Pulmonary Nocardiosis may mimic relapse of tuberculosis. Nocardiosis should always be thought as differential organism in patients with old treated Tuberculosis lung.
happened by mere chance.It has structural similarities to tubercule bacilli, is acid-fast, is a persistent illness comparable to tuberculosis, thus can occasionally be mistaken for tuberculosis. Nocardia genus is now classified under bacteria Actinomycetes and belong specifically to the family Mycobacteriaceae15. This account of Nocardia’s discovery reveals a lot about the clinical acuity required for diagnosing Nocardia.
Nocardia species are gram-positive, filamentous bacilli belonging to the actinomycetes genus that are non-motile, catalase-positive, weakly acid-fast, aerobic and do not form spores1,2,4. These organisms are frequently found in the soil and also as saprophytes in fresh and salt water8
Tlymphocyte mediated immune response is significant in preventing Nocardia infection. Therefore, clinically, it manifests as a cutaneous, systemic, or disseminated infection mostly inimmuno-compromised hosts with autoimmune diseases, human immunodeficiency virus, organ transplant recipients or patients on long-term steroid therapy3,4,6-8
The most common manifestation is pulmonary nocardiosis3,5,8. It may occur in patients suffering from chronic obstructive airway disease, asthma, bronchiectasis or chronic sarcoidosis 6,8 . Extrapulmonary disease may involve the Skin, Brain, Kidneys and other Organs1,3,5.
Because of being ubiquitous organisms, laboratory contamination or colonization without infection must
Vol 120, No 12, December 2022Journal of the Indian Medical Association
70
be ruled out8. Clinical presentation is also important along with the laboratory diagnosis. The patient may present with cough, thick purulent sputum, fever, weight loss or malaise and with a sign for pre-existing medical condition6,8.
We present a case of pulmonary nocardiosis in a patient who is a known case of old pulmonary tuberculosis, chronic obstructive airway disease and bronchiectasis.
CASE REPORT
A 66-year-old male presented to the Emergency Department of our Hospital with difficulty in breathing for three weeks, cough with sputum for one week, localized left-sided chest pain three weeks back that lasted for three days and on and off fever for one week.
The patient was a known case of old Pulmonary Tuberculosis with Chronic Obstructive airway disease (COPD) with bronchiectasis with recent onset of bilateral pneumonia. The patient was not diabetic and had not received systemic steroid therapy.
He experienced weight loss in the past three months and also complained of loss of appetite.
He has a history of Pulmonary Tuberculosis 45 years back for which he took an extended course antitubercular treatment for three years.
He was on an anticholinergic inhaler and long-acting bronchodilator and corticosteroid inhaler medication for COPD for eight years.
Patient had a history of smoking 1 pack bidi per day for 11 years but left in the past 40 years. In the past, he worked in a factory that exposed him to cotton fibers for 24 years.
He was diagnosed with bilateral pneumonia elsewhere and was on treatment for the same. He was managed by Sulbactam-Cefoperazone and Clarithromycin for pneumonia.
On examination, his axillary temperature was 97.2 Fahrenheit, Blood Pressure 134/84mmHg, Pulse rate 100/min, oxygen saturation 92% on room air. The
patient was dyspneic and general physical examination was within normal limits. Left eye aphakia and right eye pseudophakia present.
On Auscultation S1S2 heard. Bilateral air entry equal with bilateral crepitations and coarse crepitations in left infrascapular and scapular area.
Vital parameters, blood sugar and electrolytes were monitored and required corrections given. Patient was started on antibiotics, bronchodilators, and oxygen therapy.
HRCT chest was suggestive of multifocal patchy are as of consolidation in bilateral lungs.


Partial collapse with cystic bronchiectatic change and fibrotic parenchymal calcification was seen in the right upper lobe -sequel to old etiology (Figs 1&2).
RTPCR for COVID was negative.
Bronchoscopy showed bilateral infective secretions. Bilateral Bronchoalveolar Lavage (BAL) sample was collected and sent for investigations.
No fungal elements were seen on 10% KOH mount. Gram’s stain and Ziehl–Neelsen modified stain of the BAL showed Gram positive bacilli and acid fast branching filaments, respectively (Fig 1). No atypical cells were seen on cytological evaluation.
Acid-fast filamentous branching bacilli resembling Nocardia were seen in bronchoalveolar lavage specimen on Modified Ziehl-Neelson stain (1000 x Magnification).
Culture grew colonies with a chalky white appearance after 48 hours of incubation on Blood agar. The isolate was identified as N Otitidiscaviarum by MALDIT-OF.
After microbiological confirmation, the patient was started on empirical triple therapy with Injectable Imipenem, Amikacin and Cotrimoxazole for suspected disseminated Nocardiosis. After CEMRI of brain showed normal study, the treatment was de-escalated to oral cotrimoxazole therapy and patient was discharged on the same. The patient showed significant symptomatic improvement in 1 week. A
Vol 120, No 12, December 2022Journal of the
Medical Association
Indian
71
Fig 1 — CT chestFig 2 — CT chest
regular follow up and repeat chest X-ray after 2 months showed partial regression of pulmonary lesions.
Cardiac evaluation suggestive of trivial tricuspid regurgitation. The pulmonary function test revealed moderate obstructive with restrictive pattern (Figs 3&4).
DISCUSSION
Nocardiosis, a tropical disease; primarily affects immuno-compromised people, but its diagnosis in an immunocompetent host is not an inconceivable entity. Despite the fact that it is a disseminated disease, it is shown to be confined in immunocompetent hosts9, with pulmonary involvement being the most common.
As seen in the current report, such cases have been more frequently reported in patients with bronchiectasis or old tuberculosis, emphasising the need of considering this differential when traditional treatment options fail to relieve symptoms.Inhaled corticosteroid medication induced changes in local microbial flora and damage to airway and fibrosis-induced alteration in airway architecture may all be variables that pre-dispose to localised opportunistic infection and explain its incidence in these patients10-12
Treatment usually involves trimethoprimsulfamethoxazole therapy, expect in instances of sulfadrug allergy where minocycline has proven to be an effective alternative, while other would-be inhaled aminoglycosides, cephalosporins, carbapenems. Pulmonary Nocardiosis responds well on monotherapy
of 3 to 12 months13. Disseminated disease is treated with multi-drug therapy and partial treatment is associated with high mortality. Hence it is important to rule out brain or meningeal involvement by imaging or CSF studies in all cases and search for symptoms of dissemination other organs.
This report highlights the importance of differentiating such instances which are usually misdiagnosed as tuberculosis in an endemic zone like India. Doing a fungal culture more routinely in these newly defined high risk cases can help finding more such cases. Despite the relative rarity of these conditions, an awareness of the disease manifestations caused by these organisms is important because of their debilitating nature. In addition, outcomes are more favourable if they are diagnosed early and effective treatment is initiated in good time.

Nocardia, although rare in Indian scenario can present with unusual pulmonary lesion mimicking lung malignancy. Pulmonary infections due to N Otitidiscaviarum have been reported previously16. Species identification is important in deciding the clinical management and management of patients with nocardial disease. According to literature, isolates of N Otitidiscaviarum complex are usually resistant to betalactams, including most broad spectrum cephalosporins, ampicillin, amoxicillin clavulanic acid and imipenem but are usually susceptible to amikacin, the fluoroquinolones and sulphonamides17. However, sensitive isolates have also been reported18
Nocardiosis can present as acute or chronic disease. In acute presentation, it can lead to fatal disease when undiagnosed and untreated, especially

Vol 120, No 12, December 2022Journal of the Indian Medical Association
Fig 3 — Acid Fast filamentous bacteria in BAL specimen on Modified ZN Stain (1000x magnification)
72
Fig 4 — Chalky white colonies of Nocardia on Blood agar
in TMP-SMX resistant cases. In chronic form it can get disseminate to other areas like Brain, Pleural, Abdomen19
CONCLUSION
Pulmonary Nocardiosis should always be kept in mind while treating old tuberculosis patients or COPD patients for exacerbation or recurrent infection. It responds well to treatment and significantly improves the outcome. Thorough microbiological investigations help in establishing the diagnosis and significantly improve the outcome.
ACKNOWLEDGEMENT
Authors thank Dr Harsimran Kaur, Associate Professor, Centre of Advance Research in Medical Mycology, WHO collaborating Centre for Reference and Research of Fungi of Medical Importance, Postgraduate Institute of Medical Education and Research, Chandigarh, for the kind help in the final identification of the organism.
REFERENCES
1Kato K, Noguchi S, Naito K, Ikushima I, Hanaka T, Yamasaki K et al — Pulmonary Nocardiosis Causedby Nocardiaexalbida in a Patient with Lung Cancer and Radiation Pneumonitis: A Case Report and Literature Review. Intern Med 2019; 58(11): 1605-11.
2Wu J, Wu Y, Zhu Z — Pulmonary infection caused by Nocardiacyriacigeorgica in a patient withallergic bronchopulmonaryaspergillosis: A case report. Medicine (Baltimore) 2018; 97(43): e13023
3Shen T, Wu L, Geng L, Wei Z, Zheng S — Successful treatment of pulmonary Nocardiafarcinicainfection with linezolid: case report and literature review. Braz J Infect Dis 2011; 15(5): 486-9.
4Nakamura I, Nagakura T, Fujita H, Fukusima S, Gonoi T— Nocardiaelegans infection: a case report and literature review. Int J Infect Dis 2017; 54: 15-7.
5Abe S, Tanabe Y, Ota T, et al — Case report: pulmonary no cardiosiscaused by No cardia exalbida inanimmuno competent patient. BMC Infect Dis 2021; 21: 776.
6Castellana G, Grimaldi A, Castellana M, Farina C, Castellana G — Pulmonary nocardiosis in Chronic Obstructive Pulmonary Disease: A new clinical challenge. Respir Med Case Rep 2016; 18: 14-21.
7Woodworth MH, Saullo JL, Lantos PM, Cox GM, Stout JE — Increasing Nocardia Incidence Associated with Bronchiectasisata Tertiary Care Center. Ann Am Thorac Soc 2017; 14(3): 347-54.
8Takiguchi Y, Ishizaki S, Kobayashi T, Sato S, Hashimoto Y, Suruga Y, Akiba Y — Pulmonary Nocardiosis: A Clinical Analysis of 30 Cases. Intern Med 2017; 56(12): 1485-90.
9Ashmita Banik & Tapan Majumdar — Pulmonary Nocardiosis in an Immunocompetent Patient : - A Rare Case Report from A Tertiary Care Hospital in Tripura. Sch J Med Case Rep 2021; 9(8): 813-6.
10Peter E, Bakri F, Donna M — Ball, Richard T. Cheney, Brahm H. Segal, Invasive Pulmonary Filamentous Fungal Infection in a Patient Receiving Inhaled Corticosteroid Therapy, Clinical Infectious Diseases 2002; 35(5): e54-e56, https://doi.org/ 10.1086/341971
11Husta BC, Raoof S, Erzurum S, Mehta AC— Tracheo bronchopathy from inhaled corticosteroids. Chest 2017; 152(6): 1296-305.
12Lederman ER, Crum NF — A case series and focused review of nocardiosis: clinical and microbiologic aspects. Medicine 2004; 83: 300-13.
13Anderson M, KuŸniar TJ — Pulmonary nocardiosis in a patient with chronic obstructive pulmonary disease—case report and literature review. Advances in Respiratory Medicine 2012; 80(6): 565-9.
14HAAS L Edmond Isidore Etienne Nocard (1850-1903) Journal of Neurology, Neurosurgery & Psychiatry 2000; 69: 130.
15Saubolle MA, Sussland D — Nocardiosis: review of clinical and laboratory experience. Journal of Clinical Microbiology 2003; 41(10): 4497-501.
16Taneja J, Sen B, Dang N — Pulmonary nocardiosis mimicking malignancy. Indian J Med Microbiol 2016; 34(1): 117-8. doi: 10.4103/0255-0857.167680. PMID: 26776140.
17BrownElliott BA, Brown JM, Conville PS, Wallace RJ Jr — Clinical and laboratory features of the Nocardia spp. based on current molecular taxonomy. Clin Microbiol Rev 2006; 19: 25982.
18Sah R, Khadka S, Neupane S, Nepal G, Singla S, Kumari P, et al — Disseminated infection with Nocardiaotitidiscaviarum in a patient under steroid therapy. Clin Case Rep 2020; 8(2): 369-73. doi: 10.1002/ccr3.2640. PMID: 32128191; PMCID: PMC7044388.
19Fatal pulmonary nocardiosis in tmp-smx resistant cases.
Vol
No
December
120,
12,
2022Journal of the Indian Medical Association
73
Drug Corner
Assessment of Prescribing Practices in Overactive Bladder Pharmacotherapy across Different
Specialties of India : A Prescription Trend Analysis
Purpose : To assess the temporal prescription patterns of overactive bladder (OAB) pharmacotherapy based on the prescription trend analysis amongst Indian clinicians.
Methods : IQVIA (Quintiles and IMS Health) secondary sales audit (SSA) and prescription audit for antimuscarinics and beta-3 adrenoceptor agonist (mirabegron) from 2014 to 2022, were analyzed. Prescribers overlap analysis for solifenacin and mirabegron among Indian urologists was also analyzed.
Results : Urologists’ prescription rates of OAB drugs were 65% in 2016 and 52% in 2022. The rate of OAB medication prescription by non-urologists was highest among surgeons (17%), followed by consultant physicians (9%) and gynecologists (8%) in 2022. In addition, among OAB medication prescription rates for antimuscarinics were 100% in 2016 and 56% in 2022 whereas for mirabegron, it was 0% in 2016 and 44% in 2022. The proportion of prescribers of OAB medication among urologists was 38% in 2016 and 33% in 2022. Exclusive prescribers of solifenacin were 748 in 2018 and 715 in 2022 at the urologist, whereas for mirabegron, it was 961 in 2018 and 1475 in 2022.
Conclusions : Urologists remained a top prescribing specialty for OAB drugs, although prescription share increased among surgeons and consultant physicians. OAB medicines prescriptions by urologists are shifting from solifenacin to mirabegron. The results of this study could further help clinicians, to design the optimum treatment approach in OAB patients according to their need, which can help to lower antimuscarinic side effects, improves treatment adherence, and improves patient’s QoL.
[J Indian Med Assoc 2022; 120(12): 74-9]
Key words :Overactive bladder; Prescription analysis; IQVIA database; Antimuscarinics, Mirabegron.
There are a variety of symptoms associated with an Overactive Bladder (OAB), which include urgency, frequency, and nocturia, with or without Urge Urinary Incontinence (UUI)1. OAB is also associated with decreased quality of life and a high economic cost to society2
International Continence Society (ICS) estimates that 12.8% of women and 10.8% of men suffer from OAB; the prevalence of frequency, urgency, and Urge Incontinence (UI) rises with age3,4. In Men, UUI was significantly lower than in women. The reported prevalence of OAB in India is 10-42%, with a
1PhD, Gujarat Technological University, Ahmedabad, Gujarat 382424, India and Corresponding Author
2PhD, Associate Professor, SIIB, Pune, Maharashtra 411057, India
3MD, Department of Pharmacology, Maharashtra University of Health Sciences, Nashik, Maharashtra 422004, India
4MD, Editorial Board Member, IJDE, Ahmedabad, Gujarat 382470, India
5MD, Department of Anaesthesiology, Sardar Vallabhbhai Patel Institute of Medical Science and Research, Ellisbridge, Ahmedabad, Gujarat 380006, India
Received on : 24/11/2022
Accepted on : 30/11/2022
progressive increase in prevalence from the third to seventh decade of life5
Behavioural and self-control training methods are regarded as first-line options for reducing urine incontinence in patients. Antimuscarinics or â3 adrenoceptor agonists are popular treatments for OAB if behavioural changes fail to alleviate symptoms6. In India,the most commonly prescribed OAB medications are solifenacin, oxybutynin, tolterodine, darifenacin, trospium, and mirabegron7 (Table 1).
Antimuscarinics prevent the contraction of the smooth muscle wall around the bladder. Stimulation of the acetylcholine muscarinic M3 receptors in the detrusor muscle wall usually results in micturition. Solifenacin and darifenacin are muscarinic receptor antagonists that only affect the M3 receptor. Oxybutynin and tolterodine are non-selective antimuscarinics that affect all muscarinic receptors, which causes dry mouth 9 . As a beta-3 agonist, mirabegron relaxes the detrusor muscles and enhances bladder storage capacity without affecting voiding contractions. As a result, mirabegron can assist in alleviating the symptoms of OAB10. According
Vol 120, No 12, December 2022Journal of the Indian Medical Association
Vishavadia Krunal1, Sandip Solanki2, Sandesh Warudkar3, Hiren Prajapati4, Madhu Sharma5
74
Table 1 — Treatment of Non-Neurogenic Overactive Bladder (OAB) in adults1,8
First-LineBehavioral Bladder training Treatments Therapies Bladder control strategies
Pelvic floor muscle training Fluid management
Second-Line Pharmacologic Antimuscarinic Treatments Management Solifenacin
Oxybutynin Tolterodine Darifenacin Trospium Propiverine
Fesoterodine
Beta-3 adrenoceptor agonists Mirabegron Vibegron
Serotonin noradrenaline reuptake inhibitor Duloxetine
Third-Line PTNS and Intradetrus oronabotulinumtoxinA (100U) TreatmentsNeuro-Peripheral tibial nerve stimulation (PTNS) modulation Sacral neuromodulation (SNS)
Fourth-LineAugmentationAugmentation cystoplasty or TreatmentsCystoplasty and urinary diversion for severe, Urinary Diversion refractory, complicated OAB
to a report by the Urological Society of India, OAB is most commonly treated with antimuscarinic or beta-3 adrenoceptor agonists5
The objective of the present study is to assess the prescription patternof OAB pharmacotherapy especially antimuscarinic and beta-3 adrenoceptor agonists, based on the prescription trend analysis among Indian clinicians.
MATERIALS AND METHODS
Data Source and Setting :
From August 2016 to August 2022, we have been using IQVIA Medical Audit Data (formerly IMS Health) to track the urological preparation prescription rates for primary care physicians in India who work in the private sector11. In more than 100 countries, IQVIA collects market intelligence and disseminates it. Medical audit data monitor prescriptions written by allopathic doctors in private practices. Data were gathered from a random sample of 4600 healthcare practitioners from 23 metropolitan areas of India (over 1 million population), 128 Class 1 cities (population over 100,000), and 1A cities (population fewer than 100,000). A national sample of prescriptions written by doctors in cities with populations greater than one million was drawn from the original data12
The data use the European Pharmaceutical Market Research Association’s (EphMRA) Anatomical Therapeutic Classification (ATC).The data does not include prescriptions written in the public sector,
thereby analysis only includes outpatient prescriptions from the private sector. Last but not least, IQVIA makes the data available to us in aggregate form, processed, and extrapolated to reflect national prescription practices.
Outcome Measure :
The study focused on the antimuscarinics (solifenacin, oxybutynin, tolterodine, darifenacin, and trospium) and mirabegron prescribed each year as a primary outcome measure. In addition, a study estimated and reported prescriptions by specialty and molecule.
Statistical Analysis :
The study used the International Statistical Classification of Diseases and Related Health Problems, 10th Revision, to code prescription diagnosis data from an IQVIA medical audit (ICD-10 classification; version: 2016)12. Anatomic Therapeutic Chemical (ATC) classification of antimuscarinics and beta-3 adrenoceptor agonists recommended for the related diagnosis have been coded to the 3rd level of WHOCC’s proposed drug statistics methodology (ATC index-2016)13. Based on the diagnostic information provided, medical audit data was used to code the ICD 10 at the smallest level possible.
The annual prescription data of IQVIA medical audit for urological preparations, including antimuscarinics and beta-3 adrenoceptor agonists, were analyzed. The medicines prescribed were categorized into these subgroups: solifenacin, darifenacin, tolterodine, oxybutynin, trospium & mirabegron. We used software Microsoft Excel 2013 to perform statistical analysis.
Ethics Considerations :
The data used had no identifiers for the patients. So current study does not require Ethical Committee approval.
RESULTS
Prescription and prescriber data of various antimuscarinics and beta-3 adrenoceptor agonists were analyzed for 7 Moving Annual Total (MAT) periods starting from MAT Aug’16 to MAT Aug ’22.
In 2016, for OAB treatment, 84% of prescriptions were generated by the top 4 specialties, ie, urologist, consultant physician, gynecologist& general surgeon, which further increased to 86% in 2022. In MAT 2022, the urologist is the leading specialty prescribing OAB
Vol 120, No 12, December 2022Journal of the Indian Medical Association
75
of the Indian Medical Association
drugs, with a 52% prescription share. General surgeon contributes 17%, while consultant physician and gynecologisthave a 9% & 8% prescription share, respectively (Fig 1A).
In 2016, 38% of urologists contributed 65% of prescriptions in the OAB drug market, which reduces to 33% and 52% in 2022, prescriber contribution and prescription contribution, respectively. At consultant physicians, prescriber contribution increases from 11% to 17%. Still, at the same time, prescription contribution did not grow at the same pace (6% to 9%), mainly because of low prescription per doctor per month (PDM). 8% of surgeons contributed around 5% of prescriptions in 2016, which increased to 17% in 2022 due to a positive change in the number of prescriptions per doctor (Fig 1B).


Antimuscarinics and beta-3 adrenoceptor agonist, mirabegron are the preferred drugs for the medical management of overactive bladder in India. Prescription share for antimuscarinics were 100% in 2017 & 56% in 2022 whereas for mirabegron, it was 0% in 2017 & 44% in 2022. Prescriber share data also reflect a similar trend, antimuscarinics were 100% in 2017 & 64% in 2022 whereas, for mirabegron, it was 0% in 2017 & 36% in 2022 (Fig 2).
Before the launch of Mirabegron in the Indian market, solifenacin was the most preferred drug for the treatment of OAB, with a prescription share of 37% in 2017. Mirabegron was approved in India by Central Drugs Standard Control Organisation (CDSCO) in June 2017 & marketed by Nov 201714. The majority of Antimuscarinics lost their prescription share to mirabegron, as in 2022, mirabegron gained 44% prescription share in the OAB market (Table 2).
Solifenacin prescription share reduced from 36% to 30%, during 2016-2022. Major loss in prescription share for antimuscarinics was, oxybutynin (19% - 8%), tolterodine (18% - 9%), and darifenacin (25% - 9%). MAT 2020 period experienced COVID-19 impact in terms of loss in prescription, applicable to all the molecules. Greater relative prescription loss at antimuscarinics indicates the change in molecular preference in OAB management.
Among different specialties, urologists were the major specialty prescribing overactive bladder drugs & solifenacin was the most preferred molecule (38% prescriber share) in India before the launch of mirabegron. Tolterodine was the second preferred drug (29% prescriber share) for OAB by urologists in 2016, but in 2022, the prescriber share was reduced to 12%. Darifenacin also lost the prescriber share from 18% to 4% (Fig 3).
OAB medication preferences by urologists are shifting from antimuscarinics to mirabegron. Other specialties continue to prescribe antimuscarinics as a preferred drug for OAB (Fig 4).
Solifenacin and mirabegron are the most prescribed molecules across specialties and also by urologists. An exclusive prescriber (urologist) based analysis was done to understand the molecular shift at the prescriber level.
In India, before the launch of mirabegron, solifenacin dominated the OAB market. But after the launch of mirabegron, a considerable decline was observed in solifenacin prescribers and a significant gain in mirabegron prescribers. The decline in solifenacin exclusive prescribers and gain in mirabegron exclusive prescribers show the molecular shift at the urologist level from solifenacin to mirabegron.
Vol 120, No 12, December 2022Journal
[A] [B] Fig 1 — Speciality-wise contribution for OAB drugs in India (2016-2022) : [A] Prescription share; [B] Prescriber contribution 76
DISCUSSION
The urology drug market contributes almost 1.6% to the Indian pharmaceutical market. Drugs for OAB contribute 7.3% of the total urology market. Although the prevalence of OAB in India ranges from 10 - 42%15, the market size is minuscule, just 0.1% in the Indian pharmaceutical market15
Among Indian urologists, solifenacin (46.7%) is the most commonly prescribed drug for UUI, according to a survey conducted by the Urological Society of India (November 2017). In the two months following the launch of mirabegron in India, a 4.5% preference for mirabegron was recorded16
The efficacy and tolerability data unveil the reason behind shifting the molecular preference of Indian clinicians within the antimuscarinics or antimuscarinics to mirabegron. Many studies have compared the efficacy and tolerability of antimuscarinics/solifenacin vs. mirabegron. The majority of studies concluded antimuscarinics/solifenacin are comparable with mirabegron in efficacy, but mirabegron scores more on tolerability and thereby therapy adherence17-19.



Solifenacin 5 mg/day was found to be as effective as other common antimuscarinics across the spectrum of OAB symptoms and more effective than tolterodine 4 mg/day in reducing incontinence and UUI episodes, according to a systematic review and meta-
analysis. When compared to other solifenacin doses, such as 10 mg/day, darifenacin 15 mg/day, tolterodine IR 4 mg/day, fesoterodine 8 mg/day, propiverine 20 mg/day, and oxybutynin (IR 9-15 mg/day or ER 10mg-daily), solifenacin 5 mg/day had a lower incidence of dry mouth20
Mirabegron is an oral adrenoceptor agonist that provides an alternative to antimuscarinics for patients with OAB, as phase III trials of mirabegron versus placebo found significant improvements in key efficacy measures (eg, urinary incontinence and frequency of urination)17. Researchers compared antimuscarinics and mirabegron 50mg in patients with OAB by conducting a systematic literature review and network meta-analysis based on peer-reviewed articles published between 2000 and 2013. Mirabegron 50 mg was as effective as antimuscarinics (excluding solifenacin 10 mg) for urinary frequency, incontinence, and UUI episodes, according to 44 RCTs involving 27,309 patients21. Also, mirabegron was found to be better tolerated in terms of dry mouth, constipation, and urinary retention than antimuscarinics. Better symptomatic relief with patient satisfaction is the primary objective behind any medical treatment.
Vol 120, No 12, December 2022Journal of the Indian Medical Association
— % Prescription and Prescriber share of
3 — Prescriber share of OAB drugs at Urologist
Table 2 — Molecule-wise % prescription share of OAB drugs in India (2016-2022) Drugs for OAB2016201720182019202020212022 Mirabegron002235384244 Solifenacin36372831333330 Oxybutynin192017121078 Tolterodine18191591099 Darifenacin25211713999 Trospium2211000 77
[A] Prescription share [B] Prescriber share Fig 2
beta-3 adrenoceptor agonist and antimuscarinics (2017-2022) Fig
specialty (2016-2022)
[A] %Prescription Share (Urologist)
[B] %Prescription Share (Other specialities)
Fig 4 — % Prescription share of antimuscarinics and mirabegron at urologists and other specialties (2016-2022)


stones, falling/fractures in the elderly, sleep disturbances, adverse effects on quality of life, and depression27. OAB is often accompanied by chronic diseases such as hypertension and diabetes. It is common for elderly incontinence patients to be managed by a non-urologist, especially in rural areas28 . Urologists were most likely to prescribe mirabegron whereas non-urologists were found to prescribe older-generation antimuscarinics like oxybutynin and darifenacin; rather than a newer class of OAB drug, mirabegron29
Fig 5 — Exclusive prescriber (urologist) analysis for Solifenacin and Mirabegron
Antimuscarinicfulfil the first requirement and provide better symptom relief, but patient satisfaction is less due to undesirable side effects. Patients switching from antimuscarinics to mirabegron for OAB have better outcomes if their baseline OAB symptom scores are higher, such as the OAB-SS and IPSS-S22. According to a retrospective cohort study, Mirabegron may reduce the antimuscarinic drug’s dosage and thus improve NDO treatment’s long-term efficacy23. High therapy adherence, comparable efficacy, and lower side effects could be why clinicians shift their preference from solifenacin to mirabegron.
Recently CDSCO has approved a fixed-dose combination of solifenacin and mirabegron24. The randomized, multicentre SYNERGY trial studied the long-term safety and efficacy of the combination of mirabegron and solifenacin in patients with overactive bladder compared to monotherapy. The study concluded that the treatment with a combination of solifenacin and mirabegron was better tolerated and found to be effective than solifenacin monotherapy25 In the Indian market, the mirabegron/solifenacin combi pack was introduced in late 2019, whereas the fixeddose combination was approved in 202126
OAB is a common disease that causes serious problems such as UTIs, skin infections, bladder
Limitation :
Our study is not deprived of limitations. The IQVIA database did not offer detailed, patient-level data on OAB management; only limited OAB data could be included in this study, representing a source of bias. Moreover, IQVIA data were extrapolated to a population of Indian physicians using inverse proportional weight. In doing this, it is assumed that the stable panel generally represents other practices, pharmacies, and hospitals for which IQVIA did not have reliable data. Minor difference in the stable panel creates significant differences in the final data output. Also, the current study only evaluates prescriptions and prescriber trends of two major classes of drugs, ie, antimuscarinics and beta-3 adrenoceptor agonists used for the treatments of OAB. No other pharmacotherapy has been evaluated. Despite limitations, our study comprehensively evaluated the change in practicing trends of OAB management.
Conclusion :
Urologists remained a top prescribing specialty for OAB drugs, although prescription share increased among surgeons and consultant physicians. OAB medication preferences by urologists are shifting from solifenacin to mirabegron. Other non-urologist specialties continue to prescribe antimuscarinics as a preferred drug for OAB. Antimuscarinics’ prescription

Vol 120, No 12, December 2022Journal of the Indian Medical Association
78
of the Indian Medical Association
share shows a downtrend due to the risk of side effects and lowers therapy adherence compared with mirabegron, which is comparatively better tolerated & equally effective in OAB management. Across Indian specialties, mirabegron emerges as a promising treatment option for overactive bladder. Recently approved fixed-dose combination of antimuscarinic, solifenacin, and beta-3 adrenoceptor agonist mirabegron is the newer approach for refractory OAB management in India. Results of this study could further help clinicians, to design the optimum treatment approach in OAB patients according to their need, which can help to lower antimuscarinic side effects, improves treatment adherence, and improves patient’s quality of life.
Ethics approval and consent to participate : The data we used had no identifiers for the patients. We, therefore, did not require ethical approval for our study.
Funding : The authors received no specific funding for this work.
Competing interests : The authors have declared that no competing interests exist.
REFERENCES
1Wróbel A — Overactive bladder syndrome pharmacotherapy: future treatment options, Menopausal Rev 2015; 4(4): 211-7.
2Lee UJ — Defining and Managing Overactive Bladder: Disagreement Among the Experts. Urology 2013; 81(2): 25762.
3Irwin DE — Population-Based Survey of Urinary Incontinence, Overactive Bladder, and Other Lower Urinary Tract Symptoms in Five Countries: Results of the EPIC Study. Eur Urol 2006; 6: 1306-5.
4Moorthy P, Lapitan MC, Quek PLC, Lim PHC — Prevalence of overactive bladder in Asian men: an epidemiological survey. BJU Int 2004; 93(4): 528-31.
5Sinha S — The urological society of India guidelines for the evaluation and management of nonneurogenic urinary incontinence in adults (executive summary). Indian J Urol 2019; 35(3): 185-8.
6Gulur DM, Drake MJ — Management of overactive bladder. Nat Rev Urol 2010; 7(10): 572-82.
7Central Drugs Standard Control Organization, “CDSCO List of Approved New Drugs,” 2021. [Online]. Available: https:// cdsco.gov.in/opencms/opencms/en/Approval_new/ Approved-New-Drugs/. [Accessed: 03-Jun-2021].
8Gormley EA — Diagnosis and treatment of overactive bladder (non-neurogenic) in adults: AUA/SUFU guideline. J Urol 2012; 188(6): SUPPL 2455-63.
9Chilman Blair K, Bosch JL — Solifenacin: Treatment of overactive bladder. Drugs of Today 2004; 40(4): 343.
10Mandpe P, Prabhakar B, Shende P — Potential of Mirabegron and its Extended-release Formulations for the Treatment of Overactive Bladder Syndrome. CurrDrugMetab 2020; 21(2): 79-88.
11Candore G, Hedenmalm K, Slattery J, Cave A, Kurz X, Arlett P — Can We Rely on Results From IQVIA Medical Research Data UK Converted to the Observational Medical Outcome Partnership Common Data Model? ClinPharmacolTher2020; 107(4): 915-25.
12Farooqui HH, Mehta A, Selvaraj S — Outpatient antibiotic prescription rate and pattern in the private sector in India: Evidence from medical audit data,” PLoS One 2019; 14(11): 1-11.
13WHO, “International Statistical Classification of Diseases and Related Health Problems (ICD),” 2016. [Online]. Available: https://icd.who.int/browse10/2016/en. [Accessed: 09-Jun2021].
14CDSCO — Recommendations of the SEC (Reproductive & Urology) made in its 25. 2017; 6–8.
15IQVIA India — IQVIA Industry Highlights AUG-20. IQVIA Inst Hum Data Sci 2020; 5.
16Sinha S — The Urological Society of India survey on urinary incontinence practice patterns among urologists. Indian J Urol 2018; 34(3): 202-10.
17Kelleher C — Efficacy and Tolerability of Mirabegron Compared with Antimuscarinic Monotherapy or Combination Therapies for Overactive Bladder: A Systematic Review and Network Meta-analysis. Eur Urol 2018; 74(3): 324-33.
18Yeowell G, Smith P, Nazir J, Hakimi Z, Siddiqui E, Fatoye F — Real-world persistence and adherence to oral antimuscarinics and mirabegron in patients with overactive bladder (OAB): a systematic literature review. BMJ Open 2018; 8(11): e021889.
19Chapple CR — Persistence and Adherence with Mirabegron versus Antimuscarinic Agents in Patients with Overactive Bladder: A Retrospective Observational Study in UK Clinical Practice. Eur Urol 2017; 72(3): 389-99.
20Nazir J — Comparative efficacy and tolerability of solifenacin 5 mg/day versus other oral antimuscarinic agents in overactive bladder: A systematic literature review and network metaanalysis. Neurourol. Urodyn 2018; 37(3): 986-96.
21Maman K — Comparative efficacy and safety of medical treatments for the management of overactive bladder: A systematic literature review and mixed treatment comparison. Eur Urol 2014; 65(4): 755-65.
22Liao C-H, Kuo H-C — High satisfaction with direct switching from antimuscarinics to mirabegron in patients receiving stable antimuscarinic treatment. Medicine (Baltimore) 2016; 95(45): e4962.
23Krebs J, Pannek J, Rademacher F, Wöllner J — Real-World Effects of Mirabegron in Patients with Chronic Neurogenic Detrusor Overactivity – A Retrospective Cohort Study,” Res. Reports Urol 2020; 12: 187-92.
24CDSCO — Recommendations of the SEC (Reproductive & Urology) made in its 59th meeting. Cent Drugs Stand Control Organ 2021; 6-8.
25Gratzke C — Long-term Safety and Efficacy of Mirabegron and Solifenacin in Combination Compared with Monotherapy in Patients with Overactive Bladder: A Randomised, Multicentre Phase 3 Study (SYNERGY II). Eur Urol 2018; 74(4): 501-9.
26Medical Dialogues Team, “MSN laboratories gets CDSCO panel nod for FDCs Solifenacin, Mirabegron capsules,” www.medicaldialogues.in, 2022. [Online]. Available: https:// medicaldialogues.in/news/industry/pharma/msn-laboratoriesgets-cdsco-panel-nod-for-fdcs-solifenacin-mirabegroncapsules-90712?infinitescroll=1.
27Alana Biggers MD — Overactive Bladder (OAB) Complications,” Healthline, 2017. [Online]. Available: https:// www.healthline.com/health/overactive-bladdercomplications.
28Liu R-T — Prevalence of Overactive Bladder and Associated Risk Factors in 1359 Patients With Type 2 Diabetes. Urology 2011; 78(5): 1040-5.
29Sripad AA, Raker CA, Sung VW — Overactive bladder medication: Anticholinergics versus mirabegron by specialty. Urol J 2022; 039156032210769.
Vol 120, No 12, December 2022Journal
79
Drug Corner
Expert Opinion on Novel Fixed Drug Combination of Metformin Sustained Release and Vildagliptin Immediate Release for Type 2 Diabetes Mellitus Management in India
Rajeev Chawla1, Vageesh Ayyar2, Manoj Chawla3, Usha Ayyagari4, Vidhya Natarajan5, Shweta Sharma5, Kumar Gaurav6
Type 2 Diabetes Mellitus (T2DM) is a highly prevalent cardiometabolic disorder in India and is further projected to rise (10.4% by 2030). In newly diagnosed patients, maintaining HbA1c 6.5-7.0% and minimizing glycaemic exposure, particularly during the first year following diagnosis, may be crucial for preventing complications. Early treatment initiation with a synergistic combination of vildagliptin and metformin is one of the many possible combinations to manage type 2 diabetes mellitus. In view of emerging clinical evidence on early initiation of combination therapy than monotherapy with metformin, there is a need for expert consensus on the use of the current approved Fixed Dose Combination (FDC) of Metformin SR + Vildagliptin IR in newly diagnosed diabetic patients. Experts framed final consensus statements based on available scientiûc evidence, experience and collective clinical judgment from practical experience this FDC.
[J Indian Med Assoc 2022; 120(12): 80-4]
Key words :Type 2 diabetes mellitus, Fixed-dose combination, Metformin, Vildagliptin
Introduction
Current Indian Scenario :
The age-adjusted prevalence of diabetes in India as per the Diabetes Atlas 2021 released by the International Diabetes Federation (IDF) is 9.6% (projected to increase by 10.4 by 2030)1. In a recent 2020 Indian study, the average HbA1C in a newly diagnosed diabetic patient was reported to be 9.1 ± 2.3%, whereas the average HbA1C was 8.3 ± 2.4% in a diabetic patient diagnosed during screening2. This suboptimal disease awareness and high average HbA1C at diagnosis, in addition to the fact that the onset of diabetes among Indians is about a decade earlier than the Western counterparts, highlights that diagnosis is delayed or missed in Indians.Indians have a higher overall disease burden with a longer duration
1Senior Consultant Diabetologist, Director, North Delhi Diabetes Centre
2Professor & Former Head, Dept Of Endocrinology, St.John’s Medical college & Hospital, Bengaluru
3Director and Senior Consultant Diabetologist, Lina Diabetes Care Center, Mumbai
4Senior Consultant Endocrinologist and Diabetologist, Apollo Sugar Clinics, Chennai
5MBBS, MD, Medical Affairs, Dr. Reddy’s Laboratories Pvt. Ltd., Hyderabad and Corresponding Author
6Medical Affairs, Dr. Reddy’s Laboratories Pvt. Ltd., Hyderabad
Received on : 21/11/2022
Accepted on : 26/11/2022
spent in pre-detection, hence a longer untreated period than the Western population3
Early versus Late Intensification of Diabetic Therapy :
A 1% increase in HbA 1c concentration was associated with about a 30% increase in all-cause mortality and a 40% increase in cardiovascular mortality 4. Risk of hospitalization for heart failure increases 8-32% per 1% unit increase in HbA1c5 Hence, optimal glycemic control is one of the most important treatment goals.
For most patients with HbA1c 8.0-8.5% at diagnosis, metformin monotherapy does not lower HbA1c sufficiently to achieve target levels6,7. Delayed
Early combination therapy could potentially alter the course T2DM, thereby providing longer periods with stable HbA1c levels, delaying the need for therapy intensification, and reducing the risk of chronic complications.Initial combination therapy with Metformin Sustained Release (SR) and Vildagliptin Immediate Release (IR) Fixed Drug Combination (FDC) should be considered in:
•Patients presenting with A1C levels 1.5-2.0% above target,
•Patients with any one of the below comorbidities: #Patients with diabetic end-organ damage manifestations
#Patients with Cardiac or renal risk factors.
#Elderly patient
#Obese patients and patients in whom weight gain is undesirable.
Vol 120, No 12, December 2022Journal of the Indian Medical Association
80
treatment intensification after monotherapy failure, seen in real-world settings, results in more time spent in avoidable hyperglycemia, raising a crucial barrier to optimized care8
The INITIAL study demonstrated that vildagliptin and metformin combination therapy was associated with significant and clinically relevant HbA1c reduction in relatively young drug-naïve Asian patients with T2DM9 In newly diagnosed patients, maintaining HbA1c 6.57.0% and minimizing glycaemic exposure, particularly during the first year following diagnosis, may be crucial for preventing complications10,11
The VERIFY (Vildagliptin Efficacy in combination with Metformin for Early Treatment of Type 2 Diabetes) Trial :
The five year long VERIFY trial demonstrated that initial combination therapy is superior to sequential addition of medications for extending primary and secondary treatment failure. Newly diagnosed T2DM patients that received early combination therapy had a significant reduction in the relative risk for time to initial treatment failure compared to initial metformin monotherapy (HR 0.51, p<0.0001). Compared to initial metformin monotherapy, at 5 years, more than twice as many patients had an extended time with good glycaemic control after early combination therapy. The median time to loss of glycaemic control was almost doubled in patients that received early combination therapy compared to patients that received initial metformin monotherapy (61.9 months versus 36.1 months). Thus, extending the need to intensify treatment by more than 2 years. Furthermore, patients receiving early combination therapy had consistently lower glycaemic exposure for the entire study duration, compared with those on initial metformin monotherapy, with a greater proportion of patients attaining HbA1c target levels of <7%, <6.5%, or <6.0%12. Both groups showed similar safety and tolerability profiles, with no new safety findings, low rates of hypoglycaemic events, and comparable changes in body weight, despite the concurrent use of two OHAs in the combination treatment arm.
Besides delaying the time to primary treatment failure, early combination therapy also reduced the risk of time to secondary treatment failure by 26% (HR 0.74, p<0.0001). This suggests a ‘legacy effect’ in which only the early normalization of blood glucose can help to reduce diabetes progression11,13
Early treatment initiation with a synergistic combination of vildagliptin and metformin is one of the many possible combinations to manage T2DM. Results from the ongoing GRADE study comparing
the durability of different agents in combination with metformin will add evidence to the proposed early combination treatment strategy14
Current Treatment Guidelines on Combination Therapy for Diabetes :
(1) Global Guidelines :
The American Diabetes Association (ADA) 2021 states that more intensive early treatment has some clinical benefits, and it should be evaluated as part of a collaborative decision-making process with patients. Furthermore, since the absolute effectiveness of most oral hypoglycemic agents (OHAs) rarely exceeds 1%, initial combination therapy should be considered in patients with HbA1C levels 1.5- 2.0% above the target. Treatment intensification recommendations for patients not meeting treatment goals should not be delayed. The choice of OHA added to metformin is based on the patient‘s clinical condition3.
The American Association of Clinical Endocrinology (AACE) 2020 guidelines recommend dual combination therapy when HbA1c is >7.5% at diagnosis15.
(2) Indian Guidelines :
The latest Research Society for the Study of Diabetes in India (RSSDI) guidelines 2020 recommends initiating combination therapy early if the HbA1c >1.5% above the target16.
Rationality of Metformin SR + Vildagliptin IR Fixed Drug Combination (FDC) :
The Metformin SR + Vildagliptin IR FDC consists of antidiabetic with complementary modes of action. Metformin helps with insulin sensitization and Vildagliptin with glucose-dependent beta-cell stimulation. Furthermore, both drugs reduce hepatic glucose production17
A survey showed that patients and providers both cited gastrointestinal side effects as the primary barrier to metformin use18. The once-daily metformin (MetXR) formulation allows a more gradual release of metformin in the upper gastrointestinal tract compared to the immediate release of metformin (Met-IR)19. An open-label, prospective 24-week study showed that patients who switched to metformin XR observed the same clinical and metabolic benefits as for standard metformin but with fewer gastrointestinal side effects, reduced dosage, and a greater sense of well-being and satisfaction on medication20
Benefits of metformin hydrochloride sustained release (SR) and vildagliptin immediate release (IR) combination therapy have been summarised in Fig 119,20
Need for Expert Opinion
In view of emerging clinical evidence on early
Vol 120, No 12, December 2022Journal
of the Indian Medical Association
81
Fig 1 — Assessment of Treatment Satisfaction Criterion
CV: Cardiovascular; HbA1c: Glycated haemoglobin; IR: Immediate release; XR: Extended release; T2D: Type 2 diabetes.
initiation of combination therapy than monotherapy with metformin, we need expert opinion on the use of the current approved FDC of Metformin SR + Vildagliptin IR in newly diagnosed diabetic patients.
Methodology
110 diabetologists from India convened for 10 advisory board meetings between June 2021 to August 2021 to discuss the use of Metformin SR + Vildagliptin IR in current practice. All meetings were conducted on a virtual platform. The experienced endocrinologists were selected based on their seniority (over at least 10 years of experience in field of diabetes management).Experts framed statements based on available scientific evidence, experience and collective clinical judgment from practical experience with this combination. Objectives and specific topics relating to metformin and vildagliptin combination were discussed, and each expert shared their views, which led to group discussions. The consensus was formed if the agreement to the statement was more than 80% within the group.
Consensus statements introduced for panel discussion :
•In India, diagnosis of type 2 diabetes is delayed.
•In India, the average HbA1C at the time of diagnosis is higher than the west.
•In practice, treatment should be individualised for patients including shared decision making for early initiation of combination therapy early in newly diagnosed diabetics.
•In practice, Metformin sustained release (SR) has better tolerance than Metformin immediate release (IR).

•·It is important to identify patient profiles who could benefit from Metformin SR + Vildagliptin IR combination therapy.
Expert Opinion
In the light of the above information, a panel of experts discussed the following topics to help arrive at final expert consensus statements.
Diagnosis of Type 2 Diabetes is Delayed in India
All experts agreed that only 50% of the patients with diabetes are diagnosed and only 50% of the diagnosed patients are on treatment. There is suboptimal disease awareness and limited accessibility to regular health care. The average HbA1C at the time of diagnosis is higher in India compared to the West
Most of the experts reported that the average HbA1C at the time of diagnosis in their practice ranges between 8-10%.
Monotherapy has Limitations when used for the Treatment of T2DM Patients
Metformin monotherapy, which primarily controls fasting plasma glucose, is preferred, especially when the HbA1C is 7.5-8% at the time of diagnosis. Treatment failure to Metformin monotherapy is usually noticed at an average of 3 months. A trial with monotherapy is done for a maximum of 8-12 weeks before switching to combination therapy based on Hb1AC values at follow-up. Usually, a maximum dose of Metformin Monotherapy is needed to achieve an average of 1% drop in HbA1C. Monotherapy does not provide long-term stable glycaemic control, requiring up-titration of dose or initiation of combination therapy. In Clinical Practice, Shared Decision-making should be for Early Initiation of Combination Therapy in Newly Diagnosed Diabetics
Experts believe that considering the unique challenges faced by Indian patients, the “Hit it hard” strategy is necessary. Early combination therapy using OHAs with complementary mechanisms of action can alter the course of the disease, allowing for more extended periods of stable HbA1c levels, delaying the need for treatment intensification, and lowering the risk of chronic complications.
Patients with high HbA1c (9-10%) at diagnosis need dual therapy or a Fixed-dose Combination (FDC). Experts also report that it is better to switch to combination therapy rather than increasing the drug dose used in the initial monotherapy. Dual therapy with two different classes of medication provides the benefit
Vol 120, No 12, December 2022Journal of the Indian Medical Association
82
Indian Medical Association
of complementary action. FDCs are known to increase adherence to therapy and reduce pill burden. Patients also achieve glycemic control at lower doses of individual components of the combination. One of the drawbacks of combination therapy is the higher cost to the patient, therefore shared decision-making is critical. To facilitate shared decision-making in India, where the time spent with each patient is limited.It is helpful to have an algorithm (Fig 2) to help facilitate discussion.
Identify Patient Profiles who could benefit from Metformin SR + Vildagliptin IR Combination Therapy
Most experts agreed that Metformin SR + Vildagliptin FDC therapy benefits patients with
baseline HbA1c 1.5-2.0% above target with any of the following comorbidities: (a) diabetic end-organ manifestations, (b) cardiac or renal risk factors, (c) elderly patients d) obesity or undesirable weight gain. The experts also agreed that patients with T2DM who practice fasting during Ramadan or Navratra would benefit from this combination therapy. Patients with T2DM at high risk of hypoglycemia or intolerant to Metformin IR formulations can be given this combination therapy, according to experts. Finally, the experts agreed that patients with T2DM on Metformin and Vildagliptin combination therapy can also be switched to Metformin SR + Vildagliptin IR FDC therapy.
Fig 2 — Algorithm to enable shared decision-making in diabetes management
Adapted from Matthews D, et al Diabetes Therapy 2020; 11(11): 2465-7634

Vol
120, No 12, December 2022Journal of the
83
Final Expert Opinion
Combination therapy is required for sustained glycemic control in patients with type 2 diabetes mellitus.
Early combination therapy could potentially alter the course T2DM, thereby providing longer periods with stable HbA 1c levels, delaying the need for therapy intensification, and reducing the risk of chronic complications.
Initial combination therapy with Metformin Sustained Release (SR) and Vildagliptin Immediate Release (IR) Fixed Drug Combination (FDC) should be considered in:
•Patients presenting with A1C levels 1.5– 2.0% above target,
•Patients with any one of the below comorbidities:
#Patients with diabetic end-organ damage manifestations
#Patients with Cardiac or renal risk factors.
#Elderly patient
#Obese patients and patients in whom weight gain is undesirable.
Diabetic patients who can be started or switched to Metformin SR + Vildagliptin IR Fixed Drug Combination (FDC):
•Practice fasting during Ramadan or Navratra
•Are at high risk for hypoglycemia
•Are intolerant to Metformin IR formulations
•Patients on Metformin and Vildagliptin combination therapy can also be switched to FDC.
REFERENCES
1IDF_Atlas_10th_Edition_2021.pdf [Internet]. [cited 2022 Mar 22]. Available from: https://diabetesatlas.org/idfawp/resourcefiles/2021/07/IDF_Atlas_10th_Edition_2021.pdf
2Raghavan A, Nanditha A, Satheesh K, Susairaj P, Vinitha R, et al — The Profile of Clinically Diagnosed New Type 2 Diabetes among Asian Indians. Endocrinol Diabetes Metab J 2020; 4(3): 1-4. DOI: 10.31038/EDMJ.2020434
3Ramaiya KL, Kodali VR, Alberti KG — Epidemiology of diabetes in Asians of the Indian subcontinent. Diabetes Metab Rev 1990; 6(3): 125-46.
4Sherwani SI, Khan HA, Ekhzaimy A, Masood A, Sakharkar MK— Significance of HbA1c Test in Diagnosis and Prognosis of Diabetic Patients. Biomark Insights 2016; 11(3): 95-104.
5Matsushita K, Blecker S, Pazin-Filho A, Bertoni A, Chang PP, Coresh J, et al — The Association of Hemoglobin A1c With Incident Heart Failure Among People Without Diabetes: The Atherosclerosis Risk in Communities Study. Diabetes 2010; 59(8): 2020-6.
6Brown JB, Conner C, Nichols GA — Secondary failure of metformin monotherapy in clinical practice. Diabetes Care. 2010; 33(3): 501-6.
7DeFronzo RA, Eldor R, Abdul-Ghani M — Pathophysiologic approach to therapy in patients with newly diagnosed type 2 diabetes. Diabetes Care 2013; 36 Suppl 2: S127-138.
8Khunti K, Wolden ML, Thorsted BL, Andersen M, Davies MJ — Clinical inertia in people with type 2 diabetes: a retrospective cohort study of more than 80,000 people. Diabetes Care 2013; 36(11): 3411-7.
9Chawla M, Kim TH, Mirasol RC, Faruque P, Cooke K, HoursZesiger P, et al — Initial combination therapy with vildagliptin plus metformin in drug-naïve patients with T2DM: a 24-week real-life study from Asia. Curr Med Res Opin 2018; 34(9): 1605-11.
10Laiteerapong N, Ham SA, Gao Y, Moffet HH, Liu JY, Huang ES, et al — The Legacy Effect in Type 2 Diabetes: Impact of Early Glycemic Control on Future Complications (The Diabetes & Aging Study). Diabetes Care 2019; 42(3): 416-26.
11Holman RR, Paul SK, Bethel MA, Matthews DR, Neil HAW — 10-year follow-up of intensive glucose control in type 2 diabetes. N Engl J Med 2008; 359(15): 1577-89.
12Matthews DR, Paldánius PM, Proot P, Chiang Y, Stumvoll M, Del Prato S, et al — Glycaemic durability of an early combination therapy with vildagliptin and metformin versus sequential metformin monotherapy in newly diagnosed type 2 diabetes (VERIFY): a 5-year, multicentre, randomised, double-blind trial. Lancet Lond Engl 2019; 394(10208): 151929.
13Mosenzon O, Leibowitz G — VERIFY the role of initial combination therapy in patients with type 2 diabetes. Lancet Lond Engl 2019; 394(10208): 1483-5.
14Nathan DM, Buse JB, Kahn SE, Krause-Steinrauf H, Larkin ME, Staten M, et al — Rationale and design of the glycemia reduction approaches in diabetes: a comparative effectiveness study (GRADE). Diabetes Care 2013; 36(8): 2254-61.
15Garber AJ, Handelsman Y, Grunberger G, Einhorn D, Abrahamson MJ, Barzilay JI, et al — Consensus Statement By The American Association Of Clinical Endocrinologists And American College Of Endocrinology On The Comprehensive Type 2 Diabetes Management Algorithm - 2020 Executive Summary. Endocr Pract Off J Am Coll Endocrinol Am Assoc Clin Endocrinol 2020; 26(1): 107-39.
16Chawla R, Madhu S, Makkar B, Ghosh S, Saboo B, Kalra S — RSSDI-ESI clinical practice recommendations for the management of type 2 diabetes mellitus 2020. Indian J Endocrinol Metab 2020; 24(1): 1.
17Halimi S, Schweizer A, Minic B, Foley J, Dejager S — Combination treatment in the management of type 2 diabetes: focus on vildagliptin and metformin as a single tablet. Vasc Health Risk Manag 2008; 4(3): 481-92.
18Flory JH, Keating S, Guelce D, Mushlin AI — Overcoming barriers to the use of metformin: patient and provider perspectives. Patient Preference and Adherence 2019; 13: 1433.
19Derosa G, D’Angelo A, Romano D, Maffioli P — Effects of metformin extended release compared to immediate release formula on glycemic control and glycemic variability in patients with type 2 diabetes. Drug Des Devel Ther 2017; 11: 14818.
20Levy J, Cobas RA, Gomes MB. Assessment of efficacy and tolerability of once-daily extended release metformin in patients with type 2 diabetes mellitus. Diabetol Metab Syndr 2010; 2: 16.
21Matthews D, Del Prato S, Mohan V, Mathieu C, Vencio S, Chan JCN, et al — Insights from VERIFY: Early Combination Therapy Provides Better Glycaemic Durability Than a Stepwise Approach in Newly Diagnosed Type 2 Diabetes. Diabetes Ther 2020; 11(11): 2465-76.
Vol
120, No 12, December 2022Journal of the Indian Medical Association
84
Drug Corner
Consensus Statement : The Need for Tobacco Harm Reduction
in India
Cigarette smoking is a major public health issue in India and leads to significant morbidity and mortality. Addressing the issue of smoking is a major challenge to public health, as the addiction is hard to break. Counseling smokers regarding smoking cessation is the first step to achieving cessation, but the quit rates remain low. Several pharmacological interventions have been developed over the years. Nicotine replacement therapy is available in a variety of formulations, each with different advantages, drawbacks, acceptability among smokers and quit rates. In addition, a range of novel nicotine and tobacco products, including Heated Tobacco Products (HTPs), have been developed which leverage nicotine to aid in smoking cessation. A group of medical experts convened to review the evidence on the burden of smoking, the concept of Tobacco Harm Reduction (THR), novel nicotine and tobacco products for THR, and the potential of HTPs to aid in smoking cessation. This paper outlines the findings and recommendations regarding THR in the Indian context. The panel opined that tobacco cessation centers and counseling remain the foundation of tobacco cessation in India. At the same time, there appears to be potential for the application of THR products in India. The relevant authorities must review the potential of THR products, and make these available, to provide the best possible cessation strategy for the Indian population that is currently at risk of mortality and severe morbidity.
[J Indian Med Assoc 2022; 120(12): 85-90]
Key words :Cigarette smoking, Nicotine, Tobacco, Tobacco harm reduction, Heated tobacco products, Novel nicotine, Tobacco products.
The epidemic of smoking looms large over the Indian population, with millions of adult smokers at risk of developing life-threatening diseases. Overcoming the nicotine addiction is the key to preventing morbidity and mortality associated with smoking 1 Several modalities are available to aid in smoking cessation, including non-pharmacological and pharmacological therapies. These have varied acceptability among smokers, and varied efficacy of cessation and impact on risk of disease2,3 Over the years, a number of Nicotine Replacement Therapies (NRTs) have been introduced as smoking cessation aids4. In addition, a class of Noncombustible Nicotine and Tobacco Products (NNTPs) has been developed, which present lower health risks than conventional cigarettes5. A process of regulatory approval is required before
1MBBS, M Phil, General Manager, Hiranandani Hospital, Mumbai 400 076
2MBBS, MD (Pharmacology), Clinical Director, Peerless Hospital & B K Roy Research Center, Kolkata 700094
3MD, FPRD, DAA, Department of Paediatrics, Associate Professor, Believers Church Medical College Hospital, Kerala 689103
4MBBS, Director, AHPI, New Delhi 110001
5MBBS, MS, ENT Surgeon, Chairman & Director, Dr Hans Centre for ENT & Cochlear Implant, New Delhi 110049
6MBBS, MD, FCGP, Public Health Specialist, Assistant Finance Secretary, Indian Medical Association (IMA) Bengal
7MBBS, MD, Associate Professor, Department of Pulmonologist, SMS Hospital, Jaipur, Rajasthan 302016
Received on : 25/11/2022
Accepted on : 06/12/2022
introduction of any smoking cessation interventions, which follows a thorough review of the science of a given intervention. Products such as electronic cigarettes (ecigarettes) and heated tobacco products (HTPs) are not approved for use in India, thus depriving the at-risk groups from potentially life-saving therapies. The consensus statement presented in this paper describes the opinion of Tobacco Harm Reduction (THR) products of a panel of experts, in the Indian context.
Methodology :
A group of medical experts convened to review the evidence on the burden of smoking, the concept of Tobacco Harm Reduction (THR), novel nicotine and tobacco products for THR, and the potential of Heated Tobacco Products (HTP) to aid in smoking cessation. The HTPs are currently not approved for use in India. The group of experts reviewed the available evidence and presented their conclusions on the same. The objective was to discuss the current scientific evidence on novel nicotine and tobacco products to develop a consensus on potential of THR to alleviate the health burden faced by smokers.
Panelists :
The group included Dr Subhrojyoti Bhowmick (Clinical Director at Peerless Hospital & B K Roy Research Center), Dr Sunil K Khetarpal (Director, Association of Healthcare Providers), Dr Jijo Joseph John (Professor and Head of Department, Pediatrics,
Vol 120, No 12, December 2022Journal of the Indian Medical Association
Shashikant Pawar1, Subhrojyoti Bhowmick2, Jijo Joseph John3, Sunil Khetarpal4, Jitendra Mohan Hans5, Anirban Dalui6, Shubhra Jain7
85
Dean of Research, Believers Church Medical College), Dr Shubhra Jain (Assistant Professor, Chest and TB Hospital, Jaipur), Dr Jitendra Mohan Hans (Chairman & Director Dr Hans Centre for ENT and Cochlear Implant), and Dr Anirban Dalui (Public Health Specialist, Assistant Finance Secretary, Indian Medical Association, Bengal). The discussion was moderated by Dr Shashikant Pawar (General Manager, Dr L H Hiranandani Hospital).
FINDINGS AND RECOMMENDATIONS
Establishing a tobacco cessation center at every medical college including the district medical collegeisausefulapproachtoaddresstheissue ofcounselingandshouldbemademandatory. Counselingofyouthisacrucialaspectinreducing the dependence on tobacco. Towards this, counseling centers should be established which focus on preventing initiation of smoking among youth.Furthermore,theuseofsocialmediacould alsoproveuseful.
Patients at high risk must be made aware of the need for smoking cessation and the risks of continuing to smoke. Regular follow-up of these patientsisrequiredtoensurecontinuedabstinence from smoking.
Stringent implementation of laws prohibiting smoking in public places should be taken up with the relevant authorities.
Relevant authorities must review the potential of THR products, and make these available, to provide the best possible cessation strategy for theIndianpopulation.
Regulatory aspects regarding sale of tobacco products,suchashighcost,shouldbeaddressed
THE SMOKING EPIDEMIC : INDIAN SCENARIO AND IMPACT OF SMOKING
India has the second highest burden of tobacco consumption in the world, second only to China. Tobacco smoking remains a significant concern, with nearly 100 million adults smoking tobacco, and over one million adult deaths attributed to tobacco consumption each year. The maximum prevalence among men is estimated to be 17.5% while that among women is estimated to be 1.2%1,6.
Smoking is known to significantly impact health, causing more deaths from vascular, respiratory, and other causes than from cancer. Worldwide, the annual deaths attributed to tobacco smoking are 4-5 million, with over 1 million deaths attributed to tobacco smoking in India6,7 It is concerning that a majority of the projected tobacco-related deaths are from middle- and
low-income countries such as India, and these countries are expected to carry the majority of the burden of tobacco-related deaths until 20357
Tobacco is a potent carcinogen and is associated with cancers at various sites. Over 90% of lung cancers are due to tobacco smoking, with a risk ratio of 15-30. Similarly, the risk ratio for cancer of the urinary tract is 3, that of the pancreas, nasal cavity and liver is 1.52.5, and that of the kidney is 1.5-2.0. Alarmingly, about one-third of deaths from cancer are due to tobacco smoking. The risk of death from lung cancer is highest among current smokers compared with never smokers, and smoking cessation reduces the risk of death from lung cancer in an age-dependent manner7
A comprehensive analysis on the burden of tobacco use in India revealed a higher risk of all cause-mortality from smoked tobacco rather than smokeless tobacco (relative risk [RR] 1.67 versus 1.16 among men; RR 1.53 versus 1.30 among women).When analyzed by cause of death, the trend remained constant for deaths from Respiratory Diseases, Tuberculosis, Cardiovascular Disease (CVD), and cancer. Economic analysis indicated that smoked tobacco accounted for 78% of the total cost attributed to tobacco use, with higher costs reported among men than women. For all diseases attributed to smoking, the share of the cost was higher among men than women8
Conclusion :
Even after varied awareness campaigns and traditional nicotine replacement methods, the number of smokers is >100 million. What measures can be taken to improve individual and public health?
As compared to the burden of tobacco smoking, there are very few tobacco cessation centers and counseling centers in India.The knowledge deficit regarding the harms of smoking, and addiction itself also play a role in the low rates of quitting. Establishing a tobacco cessation center at every medical college including the district medical college is a useful approach to address the issue ofcounselingandshouldbemademandatory.
There is a need to address smoking among the younger population, and target prevention of initiation of smoking among the youth. The harms are noted in the long-term, and therefore, preventing the initiation of smoking is important. Counseling of youth is a crucial aspect in reducing the dependenceontobacco.Towardsthis,counseling centers should be established which focus on preventing initiation of smoking among youth. Furthermore, the use of social media could also proveuseful.
Vol 120, No 12, December 2022Journal
of the Indian Medical Association
86
Counseling of patients at higher risk, such as those with Chronic Obstructive Pulmonary Disease (COPD) should be mandatory. Patientsathighrisk must be made aware of the need for smoking cessation and the risks of continuing to smoke. Regular follow-up of these patients is required to ensure continued abstinence from smoking. The Cigarettes and Other Tobacco Products Act (COTPA) is existent but is not implemented in mass gathering places. The issue of stringent implementation of laws should be taken up with the relevant authorities.
There are several THR products available across the globe. These products are proven to be successful in achieving smoking cessation. Relevant authorities must review the potential of THRproducts,andmaketheseavailable,toprovide thebestpossiblecessationstrategyfortheIndian population.
Lastly, regulatoryaspectsregardingsaleoftobacco products,suchashighcost,shouldbeaddressed.
THR can be an alternative to reduce the harm caused by smoking tobacco. The options available in India are limited at the current time. There is therefore scope for expanding the portfolio of available options to lower the risk of disease among the population of smokers in India.
Althoughtheuseofe-cigarettesisbannedinIndia, itmaybenecessarytore-considerthisdecision.The availability of a THR product on prescription as a smokingcessationaidhasthepotentialofachieving the target of reduction of the risk of disease. TheevidenceinfavorofHTPscouldbepresented toregulatoryauthoritiesinIndia,forconsideration as use as a smoking cessation therapy. There is a need to test HTPs in India to understand theefficacy,safety,andviabilityofuseintheIndian population. To successfully carry out a study, the product must be in sustained use for a prolonged period,inordertoevaluatetheeffectsontheusers andthecommunity.
TOBACCO HARM REDUCTION
Cigarette smoke is generated when tobacco is burned at high temperatures (600-900°C). This complex mixture consisting of solid particles and liquid droplets has over 6,000 known chemicals. There are several Harmful and Potentially Harmful Constituents (HPHCs) in cigarette smoke and are responsible for the development of chronic smoking-related diseases9
Tobacco Harm Reduction (THR) is considered to minimize the harm of exposure to tobacco. National Institute for Health and Care Excellence (NICE) defines
Tobacco Harm Reduction (THR) as “reducing the illnesses and deaths caused by smoking tobacco— among people who smoke and those around them”3. The WHO Framework Convention on Tobacco Control defines “tobacco control” as a range of supply, demand and harm reduction strategies that aim to improve the health of a population by eliminating or reducing their consumption of tobacco products and exposure to tobacco smoke10
The concept of harm reduction is not new, and has been used in medicine and social policy in cases where hazardous behaviors cannot be completely avoided. This concept aims to minimize the harm to individuals and society when certain harmful behaviors cannot be prevented. In the context of tobacco, it is hoped that THR would allow smokers to gain some control of their addiction to nicotine3,11
This approach has gained traction in several countries, including USA, UK, Japan, and Sweden (among many other countries), where less toxic nicotine-containing products are available as alternatives to smoking. The purpose is to reduce death and disease caused by cigarette smoking. In fact, the use of snus in Sweden is a prime example of the potential of THR. The availability of snus has reduced the prevalence of smoking among males in Sweden, resulting in one of the lowest rates of smoking-related deaths across Europe3
Addiction to nicotine stems from nicotine content rather than tobacco. Regular cigarette smoking creates a pleasurable sensation mediated by the Central Nervous System (CNS), leading to nicotine addiction. When a person abstains from nicotine exposure for a few hours, withdrawal symptoms arise which sustain the nicotine addiction. To overcome this addiction, Nicotine Replacement Therapies (NRTs) have been developed which deliver steady but lower concentrations of nicotine. This allows for blunting of the pleasurable effect of nicotine and reduction of the intensity of withdrawal symptoms. Cigarettes rapidly deliver nicotine to the brain, thus creating an immediate pleasurable sensation. In contrast, NRTs deliver low levels of nicotine with a blunted pleasurable sensation12
While there are a number of approved NRTs, a major drawback across all the products is that nicotine is not delivered in the same way, nor at the same rate and dose as cigarettes. Additionally, the sensory cues and rituals associated with cigarette smoking are not replicated by NRTs, thus impacting user acceptance. There are also concerns among users that NRTs may become addicting, and doubts about the effectiveness and safety of these products. As with several medical treatments, premature withdrawal has been reported with NRTs as well, which affects the efficacy of these products3,4,11.
Vol 120, No 12, December 2022Journal
of the Indian Medical Association
87
Discussion :
Do novel nicotine and tobacco products have potential to improve individual and public health and manage the overall harm caused by consumption of conventional cigarettes? What are the potential options for adopting THR in India?
Studies have indicated the introduction of noncombustible tobacco products has reduced the consumption of combustible tobacco products, and thus it can be inferred that these products are acceptable to the users. It is necessary to separately consider nicotine (which causes addiction) and harmful byproducts (which cause diseases). Therefore, THR products should play a role as cessation therapy. While no product would be completely safe, the focus should be on the outcome (reduction of harm, and lower risk of disease). The panelists unanimously agreed that THR products will be useful. Although medical treatment has been available in India, these treatments are expensive and require a long duration. Furthermore, varenicline which is commonly prescribed has adverse effects and is expensive. Therefore, there is a need for less harmful products, as medication is not the solution. THR can be an alternative to reduce the harm causedbysmokingtobacco.Theoptionsavailablein India are limited at the current time. There is therefore scopeforexpandingtheportfolioofavailableoptions to lower the risk of disease among the population of smokers in India.
NOVEL NICOTINE AND TOBACCO PRODUCTS
THR products which are associated with low risk of disease include electronic cigarettes (e-cigarettes) and other vapor products, snus and low-risk non-combustible nicotine or Heated Tobacco Products (HTPs)11
Snus is an example of a successful THR product, as the use of snus has progressively replaced cigarette smoking in Sweden (58% of daily tobacco users use snus), with consequent low mortality rates (reduction in mortality from 26% in 1990-95 to 10% in 2002-07 among men). Snus has the advantage of not producing toxic combustion products and Tobacco-Specific Nitrosamines (TSNAs), as well as having lower risks of cancer, CVD and all-cause mortality compared with cigarette smoking11
E-cigarettes or electronic nicotine delivery systems are a safer alternative to conventional smoking. These products are battery-powered and resemble a cigarette in appearance and in the need for repetitive hand-to-mouth movement, as well as the visual cue of smoke-like vapor. Unlike conventional cigarettes, combustion of tobacco does not occur.
Furthermore, e-cigarette vapor has substantially lower levels of potentially toxic compounds compared with conventional cigarettes. Maximum TSNA levels are 500-fold to 1,400-fold lower in ecigarettes than conventional cigarettes. Formaldehyde, acetaldehyde, and acrolein (potentially toxic carbonyl compounds) have been detected in e-cigarette vapor in 12 brands of ecigarettes but at levels substantially lower than in cigarette smoke11
•Comprehensive toxicological analysis of ecigarette vapor indicates that the use of ecigarettes may lead to lower exposure to harmful constituents, as well as lower cytotoxic and mutagenic effects13 In fact, the health risks are similar to those of smokeless tobacco, which has 1% of the mortality risk of smoking. Data indicates that current e-cigarette use does not increase the risk of Myocardial Infarction (MI). Rather, the association between e-cigarette use and MI depends on the history of conventional cigarette use14. Modeling studies have estimated that switching from conventional cigarettes to ecigarettes for 10 years could lead to 6.6 million fewer premature deaths and 86.7 million fewer life-years lost due to cigarette use15. With respect to smoking cessation, the use of e-cigarettes is twice as effective as NRT in helping smokers quit16 Harnessing the potential of alternative products may be effective in achieving THR15. E-cigarettes are not associated with increase in serious health concerns and can be considered a much safer alternative to conventional smoking11. Conventional cigarettes involve the combustion of tobacco, wherein the temperature at the tip is 700950°C during puffs. The generation of toxic components occurs at 200-600°C. This gives rise to the concept that heating tobacco to lower temperatures could prevent the generation of toxic chemicals. Heated Tobacco Products (HTPs) utilize this concept and apply controlled heating to uniquely processed tobacco. HTPs heat tobacco to a maximum of 350°C9. Studies have reported that exposure to HTPs as opposed to conventional cigarettes leads to lower risk of lung cancer and CVD, and lower exposure to HPHCs. Beneficial changes have also been noted in lipid metabolism, endothelial dysfunction and cardiovascular risk factors among individuals who switch from conventional cigarettes to HTPs17. Furthermore, after the introduction of HTPs in Japan, there has been a significant reduction in hospitalizations due to COPD and ischemic heart disease (IHD)18.
Vol 120, No 12, December 2022Journal of the Indian Medical Association
88
Discussion :
Given the potential benefits of THR strategies, what measures can be taken to increase the awareness and understanding of harm reduction principles? Are any specific measures required to regulate the use of THR products among adolescents/youth, so as not to promote cigarette smoking, or use THR products as a stepping stone to cigarette smoking?
All forms of smoking cessation should be available in India as smoking is a lifelong disease that requires multiple treatment approaches. Smoking cessation strategies that are effective in other countries must be considered in India as well, so as not to deprive individuals of an effective solution.It is important to acknowledge the fact that cigarettes are the cause addiction and life-threatening disease, while THR products reduce the risk of disease.
Althoughtheuseofe-cigarettesisbannedinIndia, it may be necessary to re-consider this decision. The availability of a THR product on prescription as a smoking cessation aid has the potential of achieving thetargetofreductionoftheriskofdisease.As per the regulatory requirements in India, the e-cigarette is a “device” and thus it cannot be bought directly by customers. Appropriate regulatory procedures could be applied to ensure that the products meet the desired quality standards, and the availability and sale of these products occur only based on a prescription. The aim of introduction of THR products is to aid in smoking cessation and reduce the risk of disease in individuals exposed to tobacco. Simultaneously, awareness campaigns among youth to highlight that tobacco consumptioninanyformisharmfulcouldbeundertaken.
INDEPENDENT RISK ASSESSMENT OF HTPS
Several countries (USA, UK, Netherlands, Japan, Germany) have assessed the evidence and generally conclude that HTPs may be less harmful than cigarettes. In a ruling by the United States Food and Drug Administration (USFDA), they state “the proposed products, as actually used, reduces a user’s exposure to Harmful and Potentially Harmful Constituents (HPHCs) if they switch completely from combusted cigarettes to the HTPs. A measurable and substantial reduction in morbidity or mortality among individual tobacco users is reasonably likely in subsequent studies”20. Authorities in the United Kingdom concluded that “The available evidence suggests that heated tobacco products may be considerably less harmful than tobacco cigarettes and more harmful than ecigarettes”21. The National Institute for Public Health and the Environment, Ministry of Health, Welfare and Sport, The Netherlands in an evaluation of e-cigarettes
stated that “It may be concluded that the health risks associated with smoking conventional cigarettes are considerably higher than those associated with using e-cigarettes”22. There appears to be a general consensus that e-cigarettes and HTPs are less harmful than conventional cigarettes.
Discussion :
How can the evidence of evaluations from Government Agencies of other countries for HTPs be taken forward for developing regulatory strategies for THR in India? Based on the current ban on NNTPs in India, what are the important considerations for developing a policymaking document of THR? What measures can be taken to uplift the ban on NNTPs for THR?
It may be useful to conduct a detailed analysis of the conclusions of the agencies. Based on the findings, thescienceofHTPscouldbepresentedtoregulatory authorities in India, for consideration as use as a smokingcessationtherapy.Inviewofthelackofdata from India, data from studies conducted in other countries could be presented.
Is there a need for further studies demonstrating the reduced harm of HTPs or is the real problem a lack of awareness of the data? How can gaps in awareness be addressed?
There is information on the potential of HTPs from other countries, but studies from India are lacking, as these products are not available in the country. There is a need to test HTPs in India to understand the efficacy, safety, and viability of use in the Indian population.To successfully carry out a study, the product must be in sustained use for a prolonged period, to evaluate the effects on the users and the community. Furthermore, it is not ethically correct to carry out a randomized controlled trial. Nonetheless, if the manufacturer aims to conduct a trial in India, the relevant authorities must consider the dual outcome of aiding smoking cessation and reducing the risk of disease in individuals using tobacco. To achieve this dual outcome, the availability of effective, safe, and cost-effective products (whether pharmacological products or “devices” such as HTPs) that meet stringent quality standards and are available strictly under prescription for the purpose of smoking cessation, could benefit the community as a whole.
IMPACT OF NNTPs ON CIGARETTE SMOKING: EXPERIENCE FROM OTHER COUNTRIES
Japan is the largest consumer of HTPs, accounting for nearly 85% of the global market. The increasing market share of HTPs in Japan has led to a concomitant decline in annual cigarette sales, and a decline in aggregate consumption of tobacco products.
Vol 120, No 12, December 2022Journal of the Indian Medical Association
89
Nearly 70% of those who use HTPs in Japan have switched completely to HTPs, with dual use noted only in 9% of tobacco users. The introduction of HTPs led to a decline in cigarette smoking. Furthermore, usage among the youth remains low (0.1%). HTPs have a low impact on the use of tobacco by never-smokers (0.5%) and re-initiation by former smokers (<0.1%) in Japan. Similar data has emerged from UK as well19
Discussion :
How can a balance be formed between heavily regulated nicotine pharmaceuticals and THR products, and unregulated tobacco products?
Cost is expected to be a major factor impacting the use of such alternative products. While the cost may initially be high, it is expected that a competitive market of HTPs may lead to reduction in costs. The HTPs would be available only on the prescription of a registered medical practitioner for the purpose of smoking cessation in an individual who aims to quit smoking. The products would be classified as “devices”, and hence would not be available for purchase without a prescription. It follows that the quality and composition of the product would be strictly regulated, unlike the tobacco products available in the open market.
SUMMARY
The road to smoking cessation is marred in controversy on the potential for misuse of smoking cessation therapies. While the panel acknowledges that the THR products in question carry the potential for misuse, the benefits of introduction of these products in India cannot be denied. In the context of cigarette smoking, the ideal is complete cessation, and the objective of harm reduction can be achieved with the use of multiple approaches. Towards this, several NRTs and other products have been developed over the years, with varying efficacy in achieving sustained cessation. The products must not only be effective, but also acceptable to the users, to ensure appropriate use for the desired duration, to achieve the required outcome. Novel nicotine and tobacco products such as electronic cigarettes have demonstrated considerable efficacy over NRTs and have a lower risk of disease. Several countries have adopted these products for the purpose of smoking cessation. In light of the evidence of reduction in disease and the toxicological studies, it would be useful to consider THR products for use in India. Given the burden of tobacco smoking and the consequent health effects, it is necessary to make available the most effective products as smoking cessation therapies. There is hope that the evidence on THR products can be reviewed objectively by the relevant
authorities, so that the individuals currently at increased risk of potentially life-threatening disease could benefit from a policy change that grants them an alternative smoking cessation aid that could improve the health of the individuals using it and the community.
REFERENCES
1Mishra S, Joseph RA, Gupta PC, et al. Trends in bidi and cigarette smoking in India from 1998 to 2015, by age, gender and education. BMJ Global Health 2016; 1: e000005.
2Cornuz J, Willi C — Nonpharmacological smoking cessation interventions in clinical practice. Eur Respir Rev 2008; 17(110): 187-191.
3Fagerstrom KO, Bridgman K — Tobacco harm reduction: The need for new products that can compete with cigarettes. Addictive Behav 2014; 39: 507-11.
4Wadgave U, Nagesh L — Nicotine replacement therapy: An overview. Int J Health Sci 2016; 10(3): 426-35.
5Choi S, Lee K, Park SM — Combined Associations of changes in noncombustible nicotine or tobacco product and combustible cigarette use habits with subsequent short-term cardiovascular disease risk among South Korean men: A nationwide cohort study. Circulation 2021; 144: 1528-38.
6Shaikh R, Janssen F, Vogt T — The progression of the tobacco epidemic in India on the national and regional level, 1998 2016. BMC Public Health 2022; 22: 317.
7Vineis P — Smoking and impact on health. Eur Respir Rev 2008; 17(110): 182-6.
8Ministry of health and family Welfare. Government of India. Economic burden of tobacco related diseases in India.
9Mallock N, Pieper E, Hutzler C — Heated tobacco products: A review of current knowledge and initial assessments. Front Public Health 2019; 7: 287.
10World Health Organization — WHO Framework Convention on Tobacco Control.
11Polosa R. A fresh look at tobacco harm reduction: The case for the electronic cigarette. Harm Reduction J 2013; 10: 19.
12McNeill A — ABC of smoking cessation. Harm reduction.Br Med J.2004;528:885-887.
13Xu T, Niu ZY, Xu J — Chemical analysis of selected harmful and potentially harmful constituents and in vitro toxicological evaluation of leading flavoured e-cigarette aerosols in the Chinese market. Drug Testing Analysis 2022. Epub before print.
14Critcher CR, Siegel M — Re-examining the association between e-cigarette use and myocardial infarction: A cautionary tale. Am J Prev Med 2021; 61(4): 474-82.
15Levy DT, Borland R, Lindblom EN — Potential deaths averted in USA by replacing cigarettes with e-cigarettes. Tob Control 2017.
16Hajek P, Phillips-Waller A, Przulj D — A randomized trial of ecigarettes versus nicotine-replacement therapy. N Engl J Med 2019;
17Zynk M, Jurewicz J, Kaleta D — Exposure to heated tobacco products and adverse health effects, a systematic review. Int J Environ Res Public Health 2021; 18: 6651.
18van der Plas A, Antunes M, Romero-Kauss A, et al.Ischemic heart disease and chronic obstructive pulmonary disease hospitalizations in Japan before and after the introduction of a heated tobacco product. Front Public Health 2022; 10: 909459.
19Tobacco harm reduction and novel nicotine and tobacco products. Evidence from the Japanese market. 2020.
20United States Food and Drug Administration. Technical Project Lead Review of MRTPA.
21National Institute for Public Health and the Environment. Ministry of Health Welfare and Sport. The Netherlands. The health risks of using e-cigarettes. 2015.
22Public Health England. Evidence review of e-cigarettes and heated tobacco products 2018: Executive Summary.
Vol 120, No 12, December 2022Journal of
the Indian Medical Association
90
Pictorial CME
A Man with Rash
Rudrajit Paul1
A 30-year-old man came to the OPD with a sudden onset rash (Fig 1) on his hands (arrowhead), feet and neck (arrow). The rash was tender. Panel C shows closeup of the rash. He also complained of severe sore throat with mild fever. His son had recently been afflicted with similar symptoms.
(1)What is the most likely diagnosis?
(2)What is the causative agent?
(3)What are the other types of rash in this disease?
(4)What is a close mimicker of the oral lesion?
Answers : -
(1)The typical morphology and distribution of the rash, along with history of contact is suggestive of hand-foot-and-mouth disease, a contagious viral illness. There has been recent resurgence of this infection in Eastern India.
(2)This viral exanthem is most commonly caused by Coxsackie virus A16 and Enterovirus A71.
(3)As panel C shows, the commonest type of rash in this case is a macule or papule surrounded by a zone of erythema. In children, the rash is typically not painful. But in adults, as in our case, the rash may be tender. The other type of rash isvesicular, which may rupture to form superficial ulcers, which heal without scarring. Oral lesions, located on lips, tongue or buccal mucosa, are usually painful, as in our

1Consultant Physician, Kolkata
case. Also, although the disease is named “hand-footmouth”, in adults, the distribution of the rash may be more extensive.
(4)One closely related disease, caused by the same family of enterovirus, is Herpangina. The differentiating point is, in herpangina, the exquisitely tender oral lesions are located in posterior soft palate and pharynx.
Disclaimer
The information and opinions presented in the Journal reflect the views of the authors and not of the Journal or its Editorial Board or the Publisher. Publication does not constitute endorsement by the journal.
JIMA assumes no responsibility for the authenticity or reliability of any product, equipment, gadget or any claim by medical establishments/institutions/manufacturers or any training programme in the form of advertisements appearing in JIMA and also does not endorse or give any guarantee to such products or training programme or promote any such thing or claims made so after.
Vol 120, No 12, December 2022Journal of the Indian Medical Association
91
— HonyEditor
Image in Medicine
Bhoomi Angirish1, Bhavin Jankharia2 Quiz 1
CT Brain Angiogram images of a 42-year-old Female Patient who presented with Headache.

Questions :
(1)What is the diagnosis?
(2)What are the common locations?
Answers :
(1)Well defined round outpouching is seen from the junction of M1-M2 segment of right middle cerebral artery suggestive of saccular cerebral aneurysm.

(2)The common locations of cerebral aneurysm are:
Anterior circulation : more common a)Anterior cerebral artery /Anterior Communicating artery
b)Supraclinoid Internal carotid artery and ICA/Posterior Communicating artery junction c)Middle cerebral artery (M1/M2 junction) bi/trifurcation
Posterior circulation : d)Basilar tipe) Superior cerebellar arteryf) Posterior inferior cerebellar artery
Quiz 2
CT Scan Images of a 28-year-old Male who presented with Abdominal Pain since 5 months.

Questions :
(1)What is the diagnosis?
(2)Name the signs of ruptured endocyst.
Answers :
(1)Well defined partially calcified cystic lesion with internal hyperdense contents and multiple curvilinear serpentine membranes is seen in right lobe of liver , these imaging findings are suggestive of hepatic hydatid cyst.

(2)A) Serpent (snake) sign: Wavy membranes within the cyst.
B) Spin (whirl) sign: Twisting membranes within the cyst.
C) Congealed water lily or ball of wool sign: Solid conglomeration of membranes settled in the dependent portion of the cyst.
Department of Radiology, Picture This by Jankharia, Mumbai, Maharashtra 400004
1MD, DNB (Radiology)
2MD, DMRD (Radiology)
Vol 120, No 12, December 2022Journal of the Indian Medical Association
92
Student's Corner
Become a Sherlock Holmes in ECG
M Chenniappan1
Series 11 : “Massage to Unmask”
This is the ECG of 80 years old female with intermittent palpitation (ECG-1)
Questions :
(1) Describe the ECG Finding?
(2)Why is this Clue?
(3)What is Practical Implication?
Answers :
(1) The ECG Findings :
This ECG shows narrow QRS regular tachycardia. Each QRS is preceded by p wave which mimics sinus tachycardia. There seems to be another P wave at the end of QRS which means that atrial rate is almost 286/mt. So this is atrial tachycardia with 2:1 AV block. But it is difficult to differentiate between sinus tachycardia and atrial tachycardia with 2:1 AV conduction. That’s why some other maneuver is necessary to confirm the diagnosis of atrial tachycardia with 2:1 AV block.
(2) The Clue :
Whenever there is confusion about sinus tachycardia vs atrial tachycardia it is preferable to employ a vagal maneuver to delay the AV conduction. The simple bedside vagal maneuver is carotid sinus massage (CSM). If it is sinus tachycardia there will be gradual slowing of sinus tachycardia as long as the massage is applied; once the massage is stopped, the original rate is restored. If it is atrial tachycardia, due to increase in A.V. nodal refractory period, more p waves are blocked resulting in long R-R interval within which we can see rapid, blocked p waves, confirming the diagnosis of atrial tachycardia. Hence the clue “massage to unmask” is given. The ECG of this
ECG 1
ECG 2 — The last portion of this strip shows rapid blocked P waves confirming atrial tachycardia

patient after CSM is given (ECG-2) which shows rapid blocked P waves due to long R-R interval produced by CSM.

(3) Practical Implication :
1Adjunct Professor, Dr MGR Medical University, Tamilnadu; Senior consultant cardiologist, Tamilnadu; Ramakrishna Medical Centre, Apollo Speciality Hospital, Trichy
If this ECG is diagnosed as sinus tachycardia, active intervention may not be necessary other than treating underlying cause. If atrial tachycardia is diagnosed by CSM active intervention like cardio version or pharmacological intervention is needed to covert the rhythm to normal sinus rhythm or controlling ventricular response.
Vol 120, No 12, December 2022Journal of the Indian Medical Association
93
Letter to the Editor
What they didn’t teach us in Medical College — An Indian Perspective
SIR, — In the last four decades the world has changed beyond recognition and so has the world of doctors, but the question is ‘ has the medical education changed too’? With an exploding population and enhanced awareness because of the internet,a doctor today is expected to know many new things and develop many new skills which the past medical students perhaps never required to master. There isa huge set of skills that they still don’t teach students in medical school, and they are expected to pick them up by osmosis from unsubstantiated sources. Needless to say, these medical students miss these skills dearly all their lives. The science of medicine is important, but the art of medicine can no longer be ignored. A renewed emphasis is today needed on the professional aspect of medicine, rather than catering only to the knowledge basefor a doctor to be maximally useful to the society. We have tried to enumerate all these skills, which a doctor should have but the busy medical curriculum leaves no time for them.
Biostatistics & Data Science :
Today’s doctors are jotting notes on an iPad and navigating various electronic medical record systems. Medical practices and hospitals are generating and dealing with a deluge of data. Smarter and smarter software’s are being to record this data. But none of the medical students knows why they are generating this data or equipped enough to use them or understand the data fully. The aim is to connect the collected data to patient outcome to understand the disease and improve treatment. This is the road to ‘Evidence based medicine’ form the less accurate ‘Eminence based medicine’.
From good data, protocols are developed and if the designed are implemented properly, it saves patients’ lives and good data generate good protocols1. Standardization of the steps in routine patient care that do not utilize physician intellect frees up time to focus on actually practicing medicine. If everyone has a different way to treat a disease, say Hypospadias, for which there are over 300 surgeries, and each surgeon can’t all be doing it the best way! By following protocols two things happen - quality of health care goes up and costs go down giving rise predominantly to evidence based medicine.
Information technology 101 :
Doctors are increasingly using technology in their practices, whether it’s to record notes or store patient data in an electronic medical record2. Some doctors are using the newest telemedicine tools to consult with patients online. Almost all medical journals are today available online and conferences held continents apart can be attended and webinars conducted on handheld electronic devices. So why are medical graduates not being taught to use information technology both for their own education as well as for patient care?
Communication skills :
Doctorsneed to be nice people and doctors need to be nice to people too and for that good communication skills is mandatory3 What to say, whom to say, when to say and how to say cannot be
left for chance. The most effective doctors understand how to communicate with patients. That doesn’t mean rattling off a diagnosis and sending them home. It requires picking up on the subtle indications that a patient has not understood something or is too upset to take in information.
Only 35% of communication is verbal and the remaining 65% involves facial expression, tone of voice, movement, appearance, eye contact, gesture, and posture! A consultation involves listening, writing, presenting, negotiating, influencing, and finally establishing a professional relationship. The crux is who should be teaching the medical students all this, and the reply is obviously a communication expert who need not be a doctor.
Personal Finance :
The medical profession may be a gold mine for some, but majority of the doctors are poor in managing personal finance. Outlandish lifestyle and block-buster success stories, owning palatial mansions, fancy speed boats, helicopters and airplanes are usually anecdotaland not the rule. The reality is that too many of the doctors are in debt, paying too many EMIs and as a result, cannot afford to retire when they should. It’s now imperative that doctors learn to manage their money, or they risk drowning in debt. Recent medical school graduates could benefit from some formal education about how to use the latest web and mobile tools to manage their finances. The present generation feels that investment managers and property dealers usually take them for a ride because of their ignorance of the subject. From personal finances, to dealing with loans, to contract negotiation to basic skills involved in setting up a practice, there is no formal education in medical schools.
Teaching skills :
A doctor will remain an educator all his life. Whether he is a resident or a medical educator or a consultant or a family physician he has to impart the knowledge of good health. Teaching is such an invaluable skill for the doctors. Butare oblivious about the difference between adult or child learning and what is worse, we don’t even know how to keep on learning ourselves! As a teacher one wears many hats - a communicator, a disciplinarian, a conveyor of information, an evaluator,a classroom manager, a counselor, a member of many teams and groups, a decision-maker, a role-model, and even a surrogate parent. Unfortunately, the doctors are not trained for any one of these!
The four core qualities are essential for teaching are knowledge, the skills to convey that knowledge, the ability to make the teaching material interesting and relevant, and a deep-seated respect for the student.Except the first none of the other three are taught in medical colleges. And all this is an established science today supported by information technology.
Management and Entrepreneurship :
Doctors need to be taught how to run a business, the basics of money, the basics of running a hospital or clinic, the realities of the world of taxes and how to be competitive and yet commercially viable. A very unfortunate reality is that when it comes to financial stability, it takes a long time for the Doctor of Medicine who has been in school for at least 8 years! The business of medicine is not
Vol 120, No 12, December 2022Journal of the Indian Medical Association
94
[The Editor is not responsible for the views expressed by the correspondents]
taught in medical school, and sadly, that is where the money is. Some courses in business management and entrepreneurship specially tailored for medical students need to be a part of their curriculum.It is estimated that India needs about 6,00,000-7,00,000 additional beds over the next five to six years - indicative of an investment opportunity of $25-30 billion4
Leadership and Man Management :
Doctors are often placed in leadership roles even in their residency years. Doctors have torun teams of interns, coordinate with other physicians and nurses, conduct multi-disciplinary planning sessions and align families around shared treatment goals. And yet there is almost no training on how to succeed in the working world! Man management involves managing oneself, managing communication, managing relationships and managing teams. It is a complex interplay and very difficult to pick up if not properly taught. Doctors can be benefited from basic management skills - delegating work, providing feedback, motivating others, and collaborating with other teams. They could use training on how to lead a room full of people with different roles, experiences, and emotions, especially in the trauma emergency. A medical graduate needs to know how to interact with juniors, seniors, teachers, nurses, ministerial staff, patients, relatives, administrators, Class IV employees.
Time management :
Time is our most precious asset and yet right from the medical college days , majority of the doctors fail to respect it. It is known that 20 percent of patients consume 80 percent of healthcare resources and our energy. In medical colleges, the medical professionals spend 80 percent of their time on 20 percent of diseases, including a litany of esoteric rare disorders that are academically illuminating but most clinicians will never see in their entire careers. The medical professional does not need to know about rare, complex and difficult to pronounce syndromes and fancy investigations being done in laboratories nowhere near their practice, but they need to know how to manage dementia, manage pain thoughtfully and assess patient safety. The biggest gap in 21st century medical training is a lack of old-school skills, and not high-tech coding. Thankfully we, the past generation were taught clinical signs5 which have been replaced today by a battery of investigations. Picking uppapilledemais far quicker way of diagnosing raised intracranial tension than a CT scan. In a study from India, more than two-third of the students were found to have poor to average time management skills6
Research skills :
If India still remains a developing country despite being the fastest growing economy in the world, then it is because we lack research skills. A medical graduate is expected to understand:
•how to critically read a research article?
•how to cite sources and find good articles?
•how to understand basic statistics?
•how to get a research grant?
•how to get ethical clearance for clinical trials ?
•how to train in GLP – good laboratory practices?
•how does one start a lab and get funding?
The medical graduates,in most Indian colleges, don’t even know what a career in research looks like and how does it even start!
Nutrition, Fitness and Disease prevention :
Though the doctor spends a lot of time studying Social &
Preventive Medicine but how much of that is brought to clinical use? What proportion of the consultation time is spent on conveying the message of nutrition, fitness and disease prevention? Lifestyle diseases drive some of the biggest costs in healthcare and have some of arguably the biggest impacts on patients’ lives but how many of us find ourselves adequate enough to discuss about lifestyle changes, nutrition, and exercises to our patients?7 Keeping people healthy is far easier and cheaper than treating them when they are sick. In a study from University of Florida, it was highlighting the need for significant improvement in education of physicians about nutrition and physical activity and need for physicians to focus on good personal health behaviors, which may potentially improve with better education8
Biotechnology :
The medical community need not know the entire subject, but they at least need to know how the instrument in their hand works and what can be done to prolong its life? Whether it is X- Ray, CT Scan, MRI, Lasers, or Endoscopes, Medicine is surrounded by technology and ever changing ones. How long can one keep on wearing blinkers and relying on company engineers? They think the doctor are too demanding, don’t understand machines and the doctor think they don’t understand our demands and make machines first and then start searching for their use. This dichotomy can only be solved if the medical professionals become more tech savvy and make way to the boardrooms of these medical technology companies. Interestingly enough Texas A&M University has plans to create such a program in creating “Physician Engineers”9
Ethics
:
Is it not an irony that the first time a medical student hear about it is when the thesis proposal goes to the Institutional Ethics Committee? Though the introduction to bio-ethics should start in 1st. Semester and go right up to the end of stay in the medical college with booster doses at every stage of MBBS or postgraduate education, it is hardly ever discussed as a subject. The topic can be taught as didactic lectures, group discussions- knowing another student’s thought process, case presentations – review different ethical cases and seminars –with different sections of the society – judiciary, teacher, journalist, home maker, hospital owner and so on. The purpose is to make the budding medical doctors passionate about ethical medicine10
Health policies and Health Insurance :
This freaks out most doctors. They feel they should have a say in the formulation of health policies of the government, but they know nothing about it. Doctors are not taught how health policies are formulated and how they are brought into action. They are unaware of how they are lobbied for and how to make changes in them. The doctors think black ribbons, candlelight marches and strikes are the only weapon .
Very few of the medical professionals understand how different health insurance schemes work and end up burning their fingers by treating diseases and patients not covered by insurance and not getting remunerated at the end of the day! Doctors are never taught how expensive different medications are, how patients get billed, how can they lower costs for patients in general. Doctors don’t even know the different policies, restrictions, and costs it takes to run a clinic or hospital. They are not market ready! Every doctor should be aware of 4 insurances - Professional
Vol 120, No 12, December 2022Journal of the Indian Medical Association 95
Indemnity Insurance,Personal Accident Insurance, Property Liability Insurance and Public Liability Insurance11
Humanities:
The “humanistic” side of medicine is routinely ignored in the Indian medical institutions as they are 100 % geared towards the “scientific” side of medicine. Bedside manners are neither taught nor tested. Manners are easy to teach to a kid and very difficult to a 20+ year old. The purpose is to change in a manner that is amenable to what patients want in their doctors and change according to the patient’s beliefs and religious and social compulsions. When a procedure goes fine, a good bedside manner can be a luxury. When serious complications arise, empathy and communication can be the difference between acceptance and a dangerous false hope12
Patient’s place a lot of importance on the way a doctor interacts with them. If they can travel miles and wait for hours, they have every right to expect quality time during consultations, uninterrupted by ringing phones and barging in nurses and technicians.
Sustaining empathy for the patients and providing encouragement to them at all times while not keeping them in the dark about the prognosis is absolutely non-negotiable. No problem, however trivial it may sound, can be dismissed without giving due attention. The doctors are overburdened but it’s not the patient’s fault! Spoken words should be carefully chosen and the medical community should be taught this art. Patients being berated for being overweight or noncompliant or smelly or difficult areabsolutely unacceptable. They may repeat, recall and really take to heart….so they need patience and encouragement!There is again a lot of patience and hand holding involved in this art of communicating a poor prognosis, a complication, news of an impending amputation of limb or worst of all, death. Even telling a new mother that her newborn has to stay an extra day because of jaundice can be difficult. 90% of the time, even this little disappointment results in tears. Are the doctors trained to handle this?If not then they will have to face emotional outbursts.
Taking care of ourselves :
The doctors are expected to give – time, effort and energy and keep on giving…….But they should not give so much of themselves away that patients, whom they once enjoyed treating, become burdens and the doctors become empty shells. The doctors need hobbies and interests and days off and vacations and permission to breathe sometimes. Doctors need family time and crazy friends and people around us who let us just be a mom/dad or a wife/ husband or a referee in a football game. They need people who don’t keep putting us on an impossible pedestal and who allow us to be humans. In a study from India, the pooled prevalence of burnout was 24% in the emotional exhaustion domain, 27% in the depersonalization domain, and 23% in the personal accomplishment domain. Younger age, female gender, unmarried status, and difficult working conditions were associated with increased risk of burnout13
Conclusion :
Good communication, patience and encouragement prepare our patients for our imperfections. While the science of medicine is invaluable and is being both taught and updated with time, the art of medicine is lagging behind as our medical education it too science heavy. Thanks to the internet, the savvy patient often knows what his/her disease is and smart medical apps will soon offer treatment too, but it will not be able to offer empathy, comfort and understanding. Are the doctors of today offering the same? Or are they in a mad rush jotting online forms, getting irritated by huge patient load and suffering early burnouts? With time our medical education must change and our doctors, the product of that education, must be market ready for all eventualities.
REFERENCES
1https://www.forbes.com/sites/shourjyasanyal/2019/05/01/5reasons-why-doctors-should-learn-data-science/ ?sh=16d26ed42b85
2https://www .national.edu/2021/11/03/informationtechnology-important-healthcare/ 3Biglu M, Nateq F, Ghojazadeh M, Asgharzadeh A — Communication Skills of Physicians and Patients’ Satisfaction. Mater Sociomed 2017; 29(3): 192-5. doi: 10.5455/ msm.2017.29.192-195
4https://www.entrepreneur.com/article/307400
5Verghese A, Charlton B, Cotter B, Kugler J — A History of Physical Examination Texts and the Conception of Bedside Diagnosis. Trans Am Clin Climatol Assoc 2011; 122: 290311.
6Naik BN, Rangasamy S, Vrushabhendra HN — Time management among undergraduate medical students: A study from a tertiary health-care teaching institution in Puducherry. J Integr Health Sci 2019; 7: 39-43.
7http s://www.chicagotribune.com/lifestyles/health/scdoctors-diet-nutrition-health-0803-20160801-story.html
8Aggarwal M, Singh Ospina N, Kazory A, Joseph I, Zaidi Z, Ataya A, et al — The Mismatch of Nutrition and Lifestyle Beliefs and Actions Among Physicians: A Wake-Up Call. Am J Lifestyle Med 2019; 14(3): 304-15. doi: 10.1177/ 1559827619883603.
9https://www.bizjournals.com/houston/morning_call/2016/06/ texas-a-m-plans-to-create-innovative-engineering.html
10Glick SM — The teaching of Medical Ethics to Medical Students. J Med Ethics 1994; 20(4): 239-43. doi: 10.1136/jme.20.4.239
11https://www.insurancedekho.com/health-insurance/articles/ doctors-here-are-4-key-insurance-policies-for-you-330
12Panda SC — Medicine: Science or Art? Mens Sana Monogr 2006; 4(1): 127-38.doi: 10.4103/0973-1229.27610
13Kesarwani V, Husaain ZG, George J — Prevalence and Factors Associated with Burnout among Healthcare Professionals in India: A Systematic Review and MetaAnalysis. Indian J Psychol Med 2020; 42(2): 108-15. doi: 10.4103/IJPSYM.IJPSYM_387_19.
1MS, DNB, MNAMS, FRCS Edin, Kaushik Bhattacharya1
FRCS Glasg, Specialist, Surajit Bhattacharya2 Department of Surgery, CAPFs Composite Hospital, Siliguri and Corresponding Author
2MS, MCh Plastic Surgery, Consultant, Department of Plastic Surgery, Sahara Hospital, Lucknow
Vol 120, No 12, December 2022Journal of the Indian Medical Association 96
JOURNAL OF THE INDIAN MEDICAL ASSOCIATION INDEX TO VOLUME 120
January – December, 2022
ABBREVIATIONS USED
(C) Correspondence, (CR) Case Report, (DC) Drug Corner, (Ed) Editorial, (IM) Imaging in Medicine, (MH) Medical History, (OA) Original Article, (PCME) Pictorial CME, (RA) Review Article, (SC) Student’s Corner, (SA) Special Article, (Spl C) Special Correspondence, (VE) Voice of the Expert
SUBJECT INDEX
A
A Comparative Study of the biochemical components of Human Umbilical Cord Blood and Adult Peripheral Blood, Bhattacharya A, Ghosh A, (C),120(7):83.
Acute Fever in Primary Care A Stepwise Guide for Differential Diagnosis and Management of: An Indian Perspective, Mehta KK, Jayalal JA, Lele J, Joshi P, Rekha S, Vora A, John B, (Fever Guidelines), 120(4):91-6.
Acute Myocardial Infarction in a Tertiary Care Centre of Rural Bengal In Hospital Mortality in Patients with Impaired Fasting Glucose and, (OA), Pramanik S, Mandal PK, Bandyopadhyay A, Das SK, Dey AK, 120(3):16-8.


Acute Undifferentiated Fever in Northern India Seasonal, Regional and Demographic Trends in Patients with, Sharma S, Gupta M, Singla N, Singh Lehl S, Gaba S, (OA), 120(5):33-8.
Ageing Bhattacharya A, (C), 120(4):90.
Alcoholics & Non-Alcoholics Comparative Study of Serum LDL and HDL In, Borah A, Nath BK, Bhattacharjee P, (OA), 120(5):168.
Amiodarone and Surgical Closure of OS ASD in Adults with Surgical Closure alone on Sinus Conversion of Concomitant Atrial Fibrillation Comparison of Effect of Combined Intravenous — A Retrospective Case Series Analysis, Das S, Basu Roy S, Basu Roy S, (OA), 120(6):40-3.
Amitraz Poisoning : A Case Report of an Unusual Pesticide Poisoning. Puri S, Grover A, Choudhary PN, Gupta AP, (C), 120(5):82.
Amoebic Liver Abscess versus Pyogenic Liver Abscess on Clinical and Investigative Consequences Comparative Analysis of, Ghosh S, Bera PK, Saha A, Sur TK, (OA), 120(3):36-40.
An Unusual Untoward Reaction to COVID-19 Vaccine-AZD 1222 (ChaAdOx1), Hai AA, (C), 120(9):66.
Ancient Indian Medical Teaching, Paul R, (MH), 120(4):89.
Aneurysm Iatrogenic Isolated Ruptured Dorsalis Pedis Artery Pseudo: A Rare Case Report, Yeola (Pate) M, Nayak SR, Singh N, Singh AK, (CR), 120(5):56-7.
Antenatal Care : Quality, Utilization and Influencing Factors, DK Mukhopadhyay, K Bandyopadhyay, (Ed), 120(3):09-11.
Antenatal Care Services from Government Sector among Rural Pregnant Women Factors Influencing Non-utilization of — A Hospital-based, Cross-sectional study in Vijayapura District of North Karnataka, Ganganahalli PS, Singh CB , (OA), 120(3):12-5.
Antepartum Eclampsia Retinal Detachment in Primigravida with : A Case Report, Dutta SK, Paul G, Chakraborty A , (CR), 120(5):51-2.
Anti Mullerian Hormone (AMH) and Antral Follicle Count (AFC) in Patients of Infertility Association Dietary Protein on Level of, Singh P, Anand R, (OA), 120(12): 15-9.
anti-reflux agents in the treatment of NERD Role of PPI and importance of, Biswas KD, Purohit D (DC), 120(11): 69-71.
Aortoarteritis PET-CT Scan Appearance in, Paul R, (PCME) 120(3):77.
Are the COVID Warriors Confident about COVID Vaccine? COVID19 Vaccine and causes of Vaccine Hesitancy A Survey among the Healthcare Workers of West Bengal to Explore their Perception about, Chaudhuri A, Chakraborty D, Chakraborty S, Mitra PK, (OA), 120(2):23-6.
Argatroban for the Management of Heparin induced thrombocytopenia in COVID-19 Cases, Agrawal BK, Abraham JJ, (C),120(7):83.
Artificial Intelligence in Medicine Avatar — A Promise for Healthcare, Rajasekar R, Sankar MG, (SA), 120(5):63-6.
Ascites with Cirrhosis A Single Centre Experience of Spontaneous Bacterial Peritonitis in : A Record Based Observational Study, Ravikeerthy M, Samajdar SS, (OA), 120(12): 30-2.
Asphyxiating Thoracic Dystrophy (Juene Syndrome) : p.ARG142Ter Variant Causing Ift52 Gene Mutation Resulting in — A Rare Case Report, Mammen AC, Binukuttan PV, Varghese RG, Sasidharan S, (CR),120(9): 51-2.
Atrial Septal Defect Using Pedicled Right Atrial Wall Flap Repair of— A Retrospective Observational Study of a Novel Surgical Technique in a Tertiary Care Hospital in Eastern India, Sanki PK, Basu Roy S, Basu Roy S, (OA), 120(1):14-6.
B
back pain A man with, Paul R, (PCME), 120(11): 77.
Beard Folliculitis due to Klebsiella pneumonia, Das K, Gorai S, Banerjee P, (C), 120(11):81-2.
Become a Sherlock Holmes in ECG, Chenniappan M , (SC), 120(11):79.
Become a Sherlock Holmes in ECG, Chenniappan M, (SC), 120(12): 93.
Become a Sherlock Holmes in ECG, Chenniappan M , (SC), 120( 4): 88.
Become a Sherlock Holmes in ECG, Chenniappan M , (SC), 120(5):81.
Vol 120, No 12, December 2022Journal of the Indian Medical Association
97
Vol 120, No 12, December 2022Journal of the Indian Medical Association
Become a Sherlock Holmes in ECG, Chenniappan M , (SC), 120(6):67
Become a Sherlock Holmes in ECG, Chenniappan M , (SC), 120(7) :81.
Become a Sherlock Holmes in ECG, Chenniappan M , (SC), 120(8) :76.
Become a Sherlock Holmes in ECG, Chenniappan M , (SC), 120(9) :63.
Become a Sherlock Holmes in ECG, Chenniappan M ,:(SC), 120(2) :65.
Become a Sherlock Holmes in ECG, M Chenniappan , (SC), 120(3):79.
Become a Sherlock Holmes in ECG, M Chenniappan, , (SC), 120(1):53
Behcet’s Disease : Intestinal Behcet’s : A Rare Presentation of, Chowdhury A, Bhakat B, (CR), 120(10):68-70.
Biochemistry in Phase 1 MBBS Students : Effectiveness of Selfdirected Learning to Teach, Gupta S, Rawekar A, Bhakta A, Bandyopadhyyay M, (OA), 120(7):33-5.
Biomarkers for Frailty over the last Decade : A Literature Review, Galhotra A, Gupta M, Singh Lehl S, Galhotra A, Sood D, Gauba A, (RA), 120(8): 59-64.
Brain Those white Spots in the, Paul R, (PCME), 120(5):62.
Breast Cancer Patients The Effect of Diabetes Mellitus on the Postoperative Period in — A Three Years Retrospective Study, Byadigere M, Harindranath HR, Iyer NS, (OA),120(9):17-9.
Brivaracetam in Various Patient Profiles Placement of Oral Formulations of: An Indian Perspective, Srinivasan AV, Kannan L, Gowda VRK, Lingappa L, Utage P, Shah S, Madhusudhan BK, Lalla R, Kumar G, Bandagi RV, Brahma S (DC), 120(4):82-6.
C
Cancer of the Oral Tongue from a Single Institute in Eastern India from 1998-2017 Analysis of Disease-free Survival of 2332 Cases of, Vidyarthi A, Venkataramu V, Ranjan K, Khemka S, Dandekar M , (OA), 120(3):19-23.
Cancer Pain Relief in Elderly Patients Efficacy and Safety of Transdermal Buprenorphine Patch for : A Retrospective Study from a Tertiary Care Centre of Eastern India, Chakrabarti A, Ali Sk H, Ghosh S, (OA), 120(10):58-61.
Carcinoma in Routine Histopathology of Gall Bladder after Cholecystectomy for Gall Stones in the Age Group 30-60 Years Prevalence of Malignancy and Incidental, Saikia M. Devi J, (OA), 120(7):16-20.
Cardio Respiratory faliure cited as — The cause of death, is it a misnomer? Chowdhury SK, (C), 120(11):81
Cardiovascular Diseases Positioning of the fixed dose combination of Rosuvastatin + Clopidogrel + Aspirin in the Treatment of, Magarkar V, Bafna A , Gupta A, Motiramani N, Sharma S, Kumar G, (DC), 120(11): 63-8.
Cascade Prescribing — What, When, How and the Ways to Mitigate, Bagchi C, Majumder B, Pal J, (RA),120(9):39-43.
Cerebellar Ataxia Associated with Covid-19 Generalised Myoclonus and : A Case Report, Tanu, Pillai SM, Jayakrishnan MP, Sowmini PR, Kumar MS, Jayaraj KM, Sakthivelayutham S, Saravanan RV, Mugundhan K : (CR), 120(1):48-9.
Cerebral Abscess in Pulmonary TB An Uncommon Presentation of a Common Etiology : Tubercular Saha U , Chatterjee S, Pal S, Debnath N, Pal SK, (CR), 120(12): 64-6.
Child Health Care Practices in Nanded District of Maharashtra, Central India — A Single Centre Hospital-based Cross-sectional Study Sociology of, Rathod KG, Azam MUurRM, Suroshe BB, Hatkar NK, (OA), 120(10):44-7.
Choledochoduodenostomy in Cases of Common Bile Duct Stones A Comparative Study of Common Bile Duct Drainage by T-tube and, Kunal P, Kumar K, Gupta N, (OA), 120(7):36-40.
Chondroitin Sulfate in Patients with Knee Osteoarthritis A Pilot Observational Study of Topical Glucosamine and, Jah M, Desai A, (DC), 120(11): 72-6.
Chronic Kidney Disease among MD Medicine Postgraduates and Residents : Knowledge of, Sai SN, Sangeetha LB, Aishwarya LP, Ram R, Siva KV, (OA), 120(11):24-8.
Chronic Renal Disease Oral Manifestations of, Dwivedi A, Sinha R, Ghosh S, Maity S, Jha H, (RA), 120(7):41-4.
Colchicine In COVID-19. Bansal P, Bansal R, (C),120(7):83-4.
Common Cold and Flu Syndrome in Children Safety & Efficacy of a Fixed Dose Combination of Paracetamol (125 mg), Phenylephrine (2.5 mg) and Chlorpheniramine Maleate (1mg) [Flucold Drops] in the Treatment of : Postmarketing Surveillance Study, Kumar P, Menezes R, Pinto V , Arora D , Jayseela K, Kumar S , Rajdeo D, Harish S , Vinda Z , Tapas D, (DC), 120(5):75-9.
Consensus Statement : The Need for Tobacco Harm Reduction in India, Pawar S, Bhowmick S , John JJ , Khetarpal S , Hans JM , Dalui A, Jain S, (DC), 120(12): 85-90.
Contraceptive Use among Women in Gujarat, India Evaluating, Parekh D, Shah TG, Dave VK, (C), 120(8):77.
Corrigendum: 120(7):55
COVID and Women’s Health in India, Malhotra N, Malhotra N, Garg R, Malhotra J, (OA), 120(3):48-52.
COVID Associated Mucormycosis (CAM) : ALearning Experience from a Tertiary Care Centre Interpreting Mortality in, Bharathi G, Bhavana K, Vishnudas TV, Kumar V, Bharti B, Srinivaasan A, Ouseph S, Pillai S, Sadhukhan K, Kumar , Kant S, Mandal A, (OA), 120(11):29-36
COVID Pandemic The Transition towards Virtual Teaching Learning Environment during : Medical Educator’s Perspective, Begum J, Ali SI, Lalitha DL, Panda M, Thalanjeri P, (OA), 120(6):349.
COVID Second Wave — The Guiding Principles, Singh S,, MK Srivastava,(C) 120(2):68-9.
COVID-19 Perspectives of — Epidemiology, Prevention, Surgery and Medical Education, Ray Y, (Ed), 120(5):09-10.
COVID-19 : a Narrative Review An update on Oral Manifestations of, Nindra J, Prabhakar M, Singh Sidhu M, Dogra N, (RA), 120(2) :47-51.
COVID-19 Disease The Use of Aspirin in Patients Suffering from, Nath A, (SCom), 120(5):58.
COVID-19 from an Urban Healthcare Centre in Kerala A study on Breakthrough Infections of, Krishnamoorthy S, Pisharody KK, Menon G, Haroon NN, Venkatesan K, (OA), 120(6):2933.
COVID-19 Infection and Myocardial Infarction: Report of Two Cases from Eastern India, Paul R, (C), 120(8):70 &78.
COVID-19 on Postgraduate Residency Curriculum of Internal Medicine and Allied Specialities Impact of : Outcomes from A Web-based Cross-sectional Study from India, Sil A, Biswas P, Chandra A, Chakraborty U, Hati A:(OA), 120(1):26-31.
COVID-19 Pandemic Ethical Issues in Surgery during, Bhattacharya K, Bhattacharya N, (RA), 120(5):48-50.
COVID-19 Patients Electrocardiographic Manifestations in - An Observational Study from a Tertiary Care Centre in North Eastern India, Kapoor M, Kumar A, Ete T, Pala S, Vanlalmalsawmdangliana, Megeji RD, Beyong T , (OA), 120(8):12-6.
COVID-19 Patients in the Tertiary Care Centre Correlation between Laboratory Findings and Clinical Severity among the, Ramesh T, Ramanathan T, Hemalatha G, Appendraj S, Prasath C, Sakthidasan S (OA), 120(10):24-30.
98
Vol 120, No 12, December 2022Journal of the Indian Medical Association
Covid-19 Patients with Secondary Infection Study on Bacteriological Profile and Antibiotic Susceptibility Pattern of Clinical Isolates Obtained from, Panigrahy S, Behera AR, Reddy Basava SP, Samatha P, Begum J, Chandra Sekhar PB, Tripathy S, (OA), 120(3):29-32.
COVID-19 Thrombocytopenia in: A Diagnostic and Therapeutic Challenge, Chandra A, Pal J, Das S, Das S,(CR), 120(3): 713.
COVID-19 Typhoid Outbreak during the Pandemic of : A Report, Khan V, Zala DB, Sanghai AA, Das VK, (OA), 120(6):19-22.
COVID-19 Vaccination among Healthcare Professionals at a Tertiary Care Public hospital in City of Mumbai COVID-19 Infection Rate following, Pandya J , Munshi R, Ambre SR, Kumbhar D , (RA), 120(9):34-8.
COVID-19: Natural Adaptive Immunity Persists at Nine Months Postinfection : An Online Longitudinal Panel Survey Immunity Status of Health Care Workers Post-recovery from, Bhatia Shah S, Chawla R, Pahade A, Bansal N , Mehta A , Dewan AK , Parkash A , Bhatia M, (OA), 120(12): 33-8.
Cranial Nerve Palsy : A Rare Presentation of Dengue Fever Isolated Unilateral, Bhakat B, Karmakar A, (CR), 120(2):52-3.
C-reactive Protein (CRP) Level and Clinico-radiological Profile in COVID-19 Patients Admitted in a Tertiary Care Hospital in Eastern India, (OA), 120(10):31-3.
Current Status of Postgraduate Medical Education in India : SomeThoughts, Lal P, (VE), 120(2):60-3.
D
De-escalate Workplace Violence Prevention Strategies to against Doctors…, Bansal P, Das A, (RA), 120(12): 61-3.
Delivery Based on Student Responses Online Classes Design, Rao SP, Vijayaraghavalu S, (OA), 120(12): 48-56.
Dengue — What is Essential to Know, Singh S, Srivastava MK, (C), 120(6):68-9,
Dengue : How do we manage, Saha B, (Ed),120(10):13-4.
Diabetes in India at 75 : Crossroads with History and Future, Sanyal D,(Ed), 120(8):9-11.
Diabetes Mellitus (Type II) in a Tertiary Care Hospital of Eastern India, An Observational Study on Pharmacoeconomics and Prescription Pattern of Drugs Used in, Sinha S, Mukhopadhyay K, Som Sengupta R, Mukherjee S, Chatterjee C, Borkondaj B, (OA), 120(3):41-7.
Diabetes Type 2 : One Disease or of Many Subtypes? Viswanathan M, (Ed),120(9):09-11.
Diabetology in Daily Practice Digital, Unnikrishnan AG, Kumaran S, (Ed), 120(6):09-12.
Different Administrative Divisions of West Bengal NCD Risk Factors in: An Insight Analysis from National Family Health Survey-5 Report, Acharyya A, Ghosh K, (OA), 120(5):26-32.
Disulfiram Induced Mania — A Case Report, Spoorthy MS, Gupta (Spl C), 120(5):59-61.
Dry Eye Disease among Adolescent Population using Visual Display Terminals in Lockdown Period A Study to Estimate the Magnitude of — A Crosssectional Observational Hospital Based Study, Mitra K, Bandyopadhyay S, Mukhopadhyay S, Karmakar S, (OA), 120(2):32-6.
E
Epilepsy can be Treated by Surgery — Needs Awareness, Ghosh AK, (C), 120(10):78-80.
Epilepsy Management in India Brivaracetam Intravenous Formulation: A Position Statement, Mathur VN, Momin M, Iyer RB, Kumar G, Brahma S,(DC), 120(4):79-81.
Ethics in Publication, Yasmin M, Ghosh S, (Ed), 120(11):13-5.
Executive Summary of the Recommendations on the Management of Asthma in Primary Care (2022) – New Updates, Jindal SK,
Lele J, Ghoshal AG, Nair S, Kant S, Parakh A, Meena, Rekha, Nagda VD, Masurkar T, Joshi SK , (RA), 120(12): 57-60.
Expert opinion on novel fixed drug combination of metformin sustained release and vildagliptin immediate release for type 2 diabetes mellitus management in India, Chawla R, Ayyar V, Chawla M, Ayyagari U, Natarajan V, Sharma S, ar Gaurav K, (DC), 120(12): 80-4.
Extrapulmonary Tuberculosis Challenges in Diagnosis of, Pal J, Bhattacharjee MS, (RA), 120(4):56-60.
Extravasation of Computed Tomography Contrast Material Acute Compartment Syndrome of the Forearm and Hand due to, Safwan M, Haridas M, Ali Khan SLS, (CR), 120(11): 59-62.
F
Factors Affecting Pregnancy Outcome Proportion of Consanguineous Marriages in Community and : A Hospital based Study in Ahmedabad City, Gujarat, Saini VK, Panchal D, Kagathara JD, Prajapati AC, (OA), 120(3):33-5.
Fatty Liver Disease Non-alcoholic (NAFLD) in India : Challenges and the Ways Forward, Singh Bhadoria A, Pathak VK, Lahariya C, (RA), 120( 4):52-5.
Femur Fractures Treated by Ender’s Nail Paediatric Femur — A Prospective Study of 15 Cases, Nayak AJ, Damor HN, Dave DS, Tank PM, Patel DV, (OA),120(9):23-6.
Forensic Medicine and Toxicology in Indian Medical Education : Implementation of Competency-based Medical Education in — A Viewpoint on Challenges and Way Forward, Mada P, Shyamala R, Parmar P, Yadukul S, Reddy Pannala D, (RA), 120(11): 46-9.
Fracture Shaft of Femur by Open Intramedullary Kuntscher’s Nail and Closed Intramedullary Interlocking Nail Comparative Study of Outcome of Treatment of, Roy S, Sekhar S, Pal J , (RA),120(9): 44-8.
G
Geriatric Patients Attending Clinical Pharmacology Clinic — A Descriptive Cross-sectional Study in Eastern India Anticholinergic Burden in, Saha D, Samajdar SS, Begum SA, Mukherjee S, Tripathi SK, Pal J, Joshi SR , (OA), 120(10):39-43.
Geriatric Patients PAID-IVF — A Quick Reminder for Care Givers of Geriatric Patients, Bhattacharyya A, (RA), 120(11): 50-3.
Getting Published : The Inside Story, Ghosh S, Mukhopadhyay P, (Ed), 119(12):12-4.
Giant Mandibular Ameloblastoma Management of — A Case Report, Prabhu SR, Bavishi MP, Masariya BKD, Steward EN, (CR), 120(6):53-5.
Glycemic Status of a Large Cohort in Patients with Diabetes Impact of COVID-19 Pandemic on the, Baruah MP, Bhuyan S, Borah AR, Saikia SK, (OA), 120(10):54-7.
Growing Homophobia due to Monkeypox Outbreak in 2022, Ansar M, Chatterjee A, Roy Chowdhury S, (C), 120(9):65.
H
Haematological and Biochemical Parameters for Diagnosis and Management of Covid-19 Patients The Role of, (OA), Banga V, Jain S, 120(4):23-7.
Haemoglobin Glycated : It’s Diagnostic and Prognostic Efficacy in Various Clinical Scenarios, Kant R, Roy S, Bairwa M, (RA), 120(4):47-51.
Hair Loss with Nutraceuticals Exploring Multi-dimensional Approach for Treating and Preventing. Porwal K, Desai A, (DC),120(9): 56-61.
Harmony in Doctor Patient Relationship through Transactional Analysis Insights into Conflicts and, Bhatt AN, Joseph MR,
99
Vol 120, No 12, December 2022Journal of the Indian Medical Association
(RA), 120(8): 55-8.
Hashimoto’s Thyroiditis A Prospective Study to Evaluate the Possible Role of Cholecalciferol Supplementation on Autoimmunity in, Bhakat B, Chakraborty SK, Das S, Mallick SI , (OA), 120(7):21-4.
Hemoglobinopathies Pulmonary Hypertension in : A Neglected Entity, Mukherjee S, Ray S, Moulick A, Sherpa PL , (OA), 120(3):24-8.
Hepatitis B Virus X Gene Mutations in Patients with and without Cirrhosis/Hepatocellular Carcinoma Investigation of, Hashemi SMA, Sanaei N, Fattahi MR, Hosseini SAM, Hosseini SY, Sarvari J, (OA), 120(9):12-6.
Hernia Amyand — An Uncommon Coexistence of Two Common Disease Entities, Datta R, Chatterjee S, CR), 120(8): 73-4.
HIV/AIDS among High School Students of West Bengal, India Efficacy of Interventional Awareness Program on, Chatterjee R, Samajdar SS, Mukherjee S, Pal J, (RA), 120(2):42-6.
How was the MBBS Examination during British Times? Paul R, (MH), 120(10):77.
Hydatid Disease — An Overview, A Bagchi, Bagchi AS, (RA), 120(8): 65-70.
Hydrochlorthiazide and Chlorthalidone, used either lone or in Combination Therapy in Patients with Essential Hypertension in Tertiary Care Hospital of Uttrakhand Comparative Efficacy of, Dhasmana M, Varma A, (OA), 120(2) :27-31.
Hypertension with Rare Aetiology Two Cases of Secondary, Bhattacharyya A, Haldar T, Pal J, (CR), 120(7):51-3.
Hypothyroidism: Need for national health policy, Ghosh S, (Ed), 120(12): 12-4.
I
Indian Doctors Stress Levels among – An Online Survey, Virmani AK, Pal J, Samajdar SS, Mukherjee S, (OA), 120(4):38-9.
Inflammatory Syndrome in Adults Multisystem : The New Mask on an Old Evil, Chatterjee A, Ansar M, Chandra A, Sil A, Chakraborty U, Dasgupta S, (RA), 120(10):64-7.
Intracranial Haemorrhage in India Recent Cyclones Causing an Increased Incidence of — A Cross-sectional Study, Sharma V, Sharma R, Tiwari T, Goyal S, Sharma K,Chugh S, Mathur G, (OA), 120(10):15-8.
Intussusception Double Compound —A Clinico-radiological Correlation, Chatterjee S, (CR), 120(4):61.
Ischaemic Stroke on its Prognosis as per Location A Clinical Correlation of EEG Changes in Relation to, Mukherjee A, Bhattacharya P, Sarkar S, Maity A, Roy MK Pal SK, (OA), 120(12): 20-2.
J
Jejunal GIST — An Obscure Cause of Melaena, Sangha R, Mukherjee R: (CR), 120(1):43-5.
JIMA — December, 2021, Basu M, (C), 120(4):90.
JIMA September 2021, Udgiri R, (C), 120(11):81
JIMA, Vol 119, December, 2021, Basu M (C), 120(8):77.-8
Jivaka : The Legendary Physician of Ancient India, Paul R, (MH), 120(2) :66.
John Keats : The Doctor and the Poet, Paul R, (MH), 120(9):64.
K
Kala azar — Aneglected Notifiable Disease, Roy D (Spl C), 120( 4):78
L
Laboratory Work and Analysis of the Biochemical components of Human Umbilical Cord Blood and Adult peripheral blood, Bhattacharya A, Ghosh A, (C), 120(10):80-1.
Laparoscopic repair of a symptomatic direct inguinal hernia in an apparently healthy boy, Patel RV, Correia RC, (C), 120(11):801
Last Menstrual Period and Ultrasonographic Evaluation in Pregnancy Comparative Study of Expected Date of Delivery on the basis of, Kumari S, Gunjan, Singh S, Karim R, (OA), 120(7):30-2.
Lean Six Sigma DMAIC Strategy Quantification of Pre-analytical Quality Indicators in a Clinical Laboratory and Formulating the, Jain P, Chauhan P, Uppal V, Debnath E, Gogoi S, Chatterjee P, (OA), 120(2):17-22.
Leiomyosarcoma of Liver Primary — Case Report of a Rare Cancer, Saha BK, Vijayvargiya M, (CR), 120(4):64-6.
Leukotriene A4 Hydroxylase (LTA4H ) Gene in Extra Pulmonary tuberculosis Patients and Healthy Control in North Indian Population All Gene Expression of, Gaur PS, Kant S,Tripathi A, Srivastava K, Chaturvedi R, (OA), 120(8): 34-9.
Levobupivacaine (0.25%) versus Bupivacaine (0.25%) using Ultrasound Guided Transversus Abdominis Plane Block in Total Abdominal Hysterectomy under General Anesthesia Comparison of Analgesic Effects of — An Interventional Study, De S, Sur D, Roy S, Bhattacharya D, (OA), 120(2):37-41.
M
Malaria in Odisha State A Study of, Nath A, (RA), 120(10):62-3.
Maltophila Stenotrophomonas : A Rare cause of Bacteremia in a Patient of Viral Encephalitis, Nanda M , Tiwari S , (CR), 120(2):54-6.
Maternal Cardiac Arrest Perimortem Caesarean Section : A Guideline-based Management of, Kushwah B, Patel S, Singh M, (CR), 120(6):56-7.
Maternal Mortality in a Tertiary Care Hospital in Ahmedabad City, Gujarat A Retrospective Study to find out Factors Affecting, Saini VK, DN Panchal, Prajapati AC, Chaudhary KD. (OA), 120(8): 23-7.
Measuring Blood Pressur A More Hygienic Method for, Raut A, Raut R, (Spl C), 120(2):57-8.
Mechanical Ventilation at a General Critical Care Unit in a Tertiary Care Centre Mortality of Elderly Patients Supported by, Mandal A, Chakraborty S, Ghosh B, Chatterjee N, (OA), 120(11): 42-5.
Medical Certificate of the Cause of Death : Some tips for the Clinician, Das S, (VE) 120(3):74-6.
Medicine in Art, Paul R, (MH),120(7):82.
Mesenchymal Stem Cells Vast Potential for Clinical Trial Opportunities; Adipose Tissue Derived, Vyas B, Marathe A, Vyas R, Bhonde R, (OA), 120(4):32-7.
Methotrexate Gastrointestinal Adverse Events of : A Descriptive Study, Ahmed NJ, (OA), 120(11):20-3.
Microalbuminuria and Glycemic Control in Type 2 Diabetes Mellitus Evaluation of Plasma Fibrinogen Levels and Its Association with, Borawake AG, Dasgupta SS, Barsode SS, Shah N, Maindarkar A, Vangala UK, Girwalkar YA, (OA),120(9):2731.
Monkeypox as a global health emergency — A threat after COVID19 pandemic, Murugesan M, Ramamurthy S (C), 120(11):80.
Mucormycosis during the COVID Pandemic A Hospital based Observational Study of Clinical spectrum and Outcome of, Chatterjee N, Pal J, Khatua I, Pal P, Saha B, Bhattacharya D, Chakraborty A, (OA), 120(5):11-5.
Mucormycosis Study of Admitted Patients of : Experience of A Tertiary Care Centre, Goyal N, Poswal L, Gupta D, Samar N, Parakh P, Raut M, (OA), 120(7):25-9.
Myositis Elderly Lupus Patient Presenting with — An Uncommon Presentation of a Common Disease, Ghosh S, Mony SP, Sen SS, Mahapatra U,(CR),120(9): 49-50.
100
N
National Doctors’ Day-2022 Theme : Is It Appreciating for Past or Preparing for the Future? Mukhida S, Vyawahare C, Das N, Jadav V, (C), 120(10):78.
Neonatal Septicemia and its Antibiogram Prevalent in a Tertiary Care Hospital of Western Odisha, Ghosh T, Jena S, Behera AR, Panigrahy S, Sethi RK, (OA), 120(8):17-22
Neonatal Sepsis Corynebacterium falsenii Bacteremia Occurring in a Term Neonate Causing Late Onset, Bandyopadhyay M, Roy T: (CR), 120(1):46-7.
Neonate Shiver Can a? — A perioperative.Diagnostic Dilemma and a Short literature Review, Parida R, Roy Chowdhury S, Goswami D, Subramaniam R, (CR), 120(3):68-70.
Neonates Admitted in A Tertiary Care Hospital A Study Comparing the Efficacy of Different Non-pharmacological Methods to Reduce Pain in, Deka A, Das G, Debnath SK (OA),120(9):202.
Nephrocutaneous Fistula in Xanthogranulomatous Pyelonephritis Spontaneous — A Rare Complication, Dhok AP, Mitra KR, Nimje VV, Bodhankar S, Yadav TS, (CR), 120(8): 71-2.
Neuro-developmental Outcome of Preterm Babies Using Risk Stratification Score at a Tertiary Care Hospital Study of, Patel S, Mehta V, Parmar H, Shah A, (OA), 120(5):39-42.
Neurogenic Bladder Bladder Innervation and Types of, Sivaroja Y, Sowmini PR, Sathish KM, Mugundhan K, (RA), 120(3):535.
New Symptoms of COVID in the 3rd wave : Some Observations from Eastern India, Paul R, Som K, (C), 120(6):68..
Non-alcoholic Fatty liver Disease Study to Find Out the Correlation Between Cognitive Defect and, Chatterjee S, Datta S, Sarkar S, Ray MK, (OA), 120(4):28-31.
Non-communicable Diseases among Youth Prevention and Care of: Call for Action, Paul B,Yasmin M, (Ed), 120(4):11-3.
Non-communicable Diseases and Health Education for Lifestyle Modification in Wellness Clinic at a Tertiary Care Hospital Screening for, Udgiri RS, Patil A, Sorganvi V, (OA), 120(4):148.
Nutraceuticals Long COVID : New Treatment Perspective Using, Thacker HP, Desai A, (DC), 120(5):67-74.
OOmicron Variant in India/Covid Management Strategy for Third Wave, Kant S, Royson A:(RA), 120(3):56-61.
Ovarian Tumour in an 8-year-old Child Mixed Germ Cell — A Case Report, Saha BK, Sharma R, (CR), 120(12): 67-9.
Overactive Bladder Pharmacotherapy across Different Specialties of India : A Prescription Trend Analysis Assessment of Prescribing Practices in, Krunal V, Solanki S , Warudkar S, Prajapati H, Sharma M, (DC), 120(12): 74-9.
PPacemaker Lead, One Year after Implantation — An Unusual Occurrence and Its Management Cardiac Perforation by Permanent, Basu Roy S, Sarkar P, Basu Roy S, Dutta S, (CR), 120(3):66-7.
Paediatric Subspecialty Telemedicine in: A Low Cost Model for Developing Countries during the COVID-19 Pandemic, MazumderMA, Gulati S, Sengar A, (OA), 120(7):11-5.
Pancreatin Minimicrospheres Supplementation in Patients with Exocrine Pancreatic Insufficiency (EPI) Clinical Efficacy of : Real-world Evidence, Desai A, Anand S, (DC), 120(6):60-5.
Pandemic and Healthcare service Delivery for the Senior Citizens Lessons from the, Wason R, Arora SK, Goel A : (RA), 120(1):32-8
Pandemics — The Current and the Future, Tripathi SK , (VE), 120(6):58-9.
Patient Centered Health Care, Arulrhaj S, (VE), 120(7):61-6.
Pelvic Mass in Men Benign Retrovesical : Diagnostic and Management Dilemma, Saran RK. Mirdha K, Saran S, Irshad, Aishwary, (OA), 120(12):23-9.
Peripheral Artery Disease Screening for: Putting Prevention into Practice, Majumder A, Roy Chaudhuri S, (Ed), 120(2):11-2.
Peripheral Blood Smear Findings in Anemia Correlation of Red Blood Cell Indices and RBC Histogram with, Patni BB, Purohit AP, Modi MY, Prajapati VB: (OA), 120(1):17-21.
Peripheral Cysticercosis in a Young Female from South India A Rare Case of, Philip AJ, Chand A, Ramdas A, Punnooran JJ, (CR), 120(4):62-3.
Physical Activity — Addressing Effectively a Neglected Issue, Virmani AK, (RA),120(9):32-3.
Pledging Service to Humanity........, Wankhedar R , (Spl C), 120(2):59.
Pneumothorax and Subcutaneous Emphysema Rare Possible Complications : In Covid-19 Patients, Verma A, Mahanta P, Khari S, Singh J, Chaudhary H, Sirohi TR, (CR), 120(5):535.
Polyps Gall Bladder : A Paradigm Shift – Need for Reappraisal of Guidelines, Chrungoo I, Abrol S, Mahajan A, Bhardwaj R, Singh Bali H, Chrungoo RK (OA), 120(6):13-8.
Premenstrual Syndrome Pharmacological basis of Evening Primrose Oil in — An evidenced based approach, Gandhi AB, Desai A, (DC), 120(7):75-9.
Proton Pump Inhibitor (PPI) Drugs for Acid Peptic Disease A Prospective, Cross-sectional, Multicenter, Observational, Questionnaire-based Survey to assess the Knowledge, Awareness, Attitude and Practice of Physicians while Prescribing, Pebbili KK, Pendurthi B, Bhagat S, (DC), 120(7) :67-74.
Psychiatric Disorders Serum Ferritin as a Marker of, Saha Roy S, Pal S, Saha S, Gayen R, Ghosh M, Sengupta S, Das HN, (OA), 120(8): 45-9.
Pulmonary Embolism Multi Slice Spiral CT Pulmonary Angiography in Dynamic Pitch Mode using Volume Helical Shuttle Technology for the Diagnosis of, Joseph J, Anand R, Francis R, (OA), 120(5):19-25.
Q
Quiz, Angirish B, Jankharia B, (IM), 120(10):76.
Quiz, Angirish B, Jankharia B, (IM), 120(11):78.
Quiz, Angirish B, Jankharia B, (IM), 120(12): 92.
Quiz, Angirish B, Jankharia B, (IM), 120(8):75.
Quiz, Angirish B, Jankharia B, (IM), 120(9):62.
Quiz, Angirish B, Jankharia B, (IM), 120(4):87.
Quiz, Angirish B, Jankharia B, (IM), 120(5):80.
Quiz, Angirish B, Jankharia B, (IM), 120(6):66
Quiz, Angirish B, Jankharia B, (IM), 120(2):64.
Quiz, Angirish B, Jankharia B, (IM), 120(1):52
Quiz, Angirish B, Jankharia B, (IM), 120(3):78.
Quiz, Angirish B, Jankharia B, (IM), 120(7):80.
R
Rash A Man with, Paul R, (PCNE), 120(12): 91.
Refinement The Standard of Hand Written Operative Notes; A Long Campaign towards— A Complete Audit Loop Study in a Teaching Hospital, Hassan Y, Rather AA, (OA), 120(11):16-9.
Refractive Status Pre and Post Pterygium Surgery among Patients of Tertiary Care Hospital of Ahmedabad City A Study of Changes in, Thakkar S, Desai H, Raol K, Kabra R, Sharma K, Bhanat R, (OA), 120(6):44-6.
Vol 120, No 12, December 2022Journal
Association
of the Indian Medical
101
Vol 120, No 12, December 2022Journal of the Indian Medical Association
REVIEW :
Princples of Assessment in Medical, Singh T, Anshu , 120(2) :67.
Rhabdomyolysis Hypokalemic — A Rare Presentation, Yadav PK, Ghosh S, (CR), 120(7):54-5.
Russian invasion of Ukraine and it’s effect on Public Health, Mandal T, (C), 120(3):81
S
Sarcopenia : Screening Made Simple, Kalra S, Dhar M , (Ed), 120(7):9-10.
Scrub Typhus in North Eastern State of India Clinico-demographic Profile and Outcome of, Saha S, Bhaumik DP , Deb S, (OA), 120(12): 39-43.
Scrub Typhus Patients between Pre and Post Monsoon Clusters in a Tertiary Care Hospital in Kolkata A Comparative Study of Clinical Presentation of, Som Sengupta R, Mondal S, Mukhopadhyay K, Sengupta U, (OA), 120( 4):40-6.
Second Wave and Doctors Death COVID-19, Bhattacharya K, Bhattacharya N: (RA), 120(1):39-40.
Seizure Disorder Intracranial Calcification in a Case of, Chatterjee S, Saha U, Pal S, Samanta S, Bhattacharya P, Pal S, Roy MK, (CR), 120(1):50-1.
Self-Directed Learning Process Preparedness of Phase 1 MBBS Students for, Gupta S, Rawekar A, Tajuddin MdQ, (OA), 120(12): 44-7.
Serum 8-isoprostaglandin F2á Levels with Glycemic Control in Type 2 Diabetes Patients with Senile Cataract : Association of, Kaliaperumal R, Krishnagopal S, Vinod Babu S, Raghavan SA, Vengatapathy K, Anitha TS, (OA), 120(10):34-8.
Sheep’s Clothing Childhood Histiocytic Disorders — A wolf in : Experience from a Cancer Institute in South India, Devi CA, Nargund A, Patil Okaly GV, Amirtham U, Patil AS, Champaka G, Suma MN, Kumar ARA, (OA), 120(11):37-41.
SLE Cardiac Tamponade an Unusual Presentation of — A Case Report, Borse AG, Roy S, Mitra A, Roy T, Mitra KK: (CR), 120(1):41 -2.
SLE Patients Attending Two tertiary Care Hospitals in Kolkata Prevalence of Common Infections and Flare-ups in on-treatment, Sur S, Mallik S, Misra AK, Rahman M, Ghosh P, Goswam RP: (OA), 120(1):22-5.
Sodium Citrate (60 mg/5 mL) for the Treatment of Common Cold and Flu Syndrome in Children Prospective, Interventional, Multicentre, Post-marketing Clinical Study of a fixed-dose combination of Paracetamol (125 mg), Phenylephrine HCL (5 mg), Chlorpheniramine Maleate (1 mg) and, Prospective, Interventional, Multicentre, Post-marketing Clinical Study of a fixed-dose combination of Paracetamol (125 mg), Phenylephrine HCL (5 mg), Chlorpheniramine Maleate (1 mg) and, Kumar P, Menezes R, Pinto V, Arora D, Jayseela K, Kumar S, Rajdeo D, Harish S, Vinda Z, Tapas D: A, (DC), 120(10): 71-5.
Sputnik V and Covaxin COVID-19 Vaccines in Adult General Population of Eastern India An Observational Study Comparing the Adverse Effect Profiles of, Bhowmick S, Maitra S, Paul S, Ahmed A, Das A, Kundu T, Das N, Ray K, Purkayastha SK, (OA), 120(8): 40-4.
Stress Depression Anxiety and Coping Styles among Indian University Students during COVID-19 Outbreak Association between, Das P, Kumar S, Chidambaram R, (OA), 120(8): 50-4.
Strike Omicron before you Captures It ! (Spl C), Rao MVR, Mathai D, Chennamchetty VK, Reddy VR, Dass M , (Spl C), 120(7) :56-60.
Substance Abuse Why MBBS Students are Taking to? — A Retrospective Study on the Pattern and Causes of Substance
Abuse among the MBBS Students of West Bengal, Chaudhuri A, Siddalingaiah HS, Santra R, Bhattacharyya D, (OA), 120(8): 28-33.
Systemic Lupus Erythematosus (SLE) with Special Reference to Metabolic Profile A Study on Prevalence, Clinical Features and Organ Damage in, Mandal UK, Biswas PK, Mandal S, Kole AK, (OA), 120(4):19-22.
T
TB Programme Overview of END, Sarkar S, (RA),120(3):62-5.
Tearful Homage : Late Justice Lahoti A Messiah for Medical Professionals in India, Lahoti RC, (Obituary), 120(4):97.
Telemedicine, Harihar MT, (VE), 120(4):70-7.
The Road not taken : A Perspective of a Medical Professional’s Inability to Choose between Clinical Practice or Postgradu, Chakrabarti A, Roy Chowdhury S, (C), 120(1):54
Transeosophageal Echocardiography Guidance under Total Intravenous Anaesthesia Percutaneous Ostium Secondum Atrial Septal Defect Device Closure in a Pregnant Patient with, Kurien JG, (CR),120(9): 53-5.
Tuberculosis Clinical Spectrum of, Vora A (RA), 120(5):43-7.
Tuberculosis CNS, (RA), Muralidharan K, Mugundhan K, Pal J, 120(6):47-52.
Tuberculosis Imaging in, Angirish B, Jankharia B, (RA), 120(7):4550.
Tuberculosis Reactivation The Rare Imitator : Pulmonary Nocardiosis Mimics, Arora Sachdeva R, Taneja J, Verma L, Sen MK, Chaudhary K, Swati A, Kumar A, (CR), 120(12): 70-3.
Type 2 Diabetes Mellitus with Relation to Ankle Brachial Pressure Index A Study of Peripheral Arterial Disease in, Bhowmick R, Nath BK, Bhattacharjee P, (OA), 120(2):13-6.
UUrinary Tract Infection in a Tertiary Care Hospital Antimicrobial Sensitivity Pattern of Bacterial Isolates Associated with, Das AK, Patra A, Nandy M, Barik G, Ghosh J, (OA),120(10):1923.
Uropathogenic E coli Clinico-microbiological Profile of Urinary Tract Infection with Special Reference to : Antibiotic susceptibility Pattern, Phylogenetic Background and Virulent Factor Distribution from West Bengal, India, Koley S, Mukherjee M, Halder P, Bose A, Lahre D, Mukhopadhyay S, Mallik S, (OA), 120(10):48-53.
Urothelial Carcinoma of Urinary Bladder in terms of Locoregional Response and Toxicities : Outcome of Concurrent Chemoradiation in Inoperable Muscle Invasive — A Longitudinal Study in a Tertiary Care Hospital, Das S, Chakrabarti A, Ghosh SK, (OA), 120(6):23-8. V
Varicose Vein Modified Trendelenburg Procedure for, Mohapatra SK, Dha SP (RA), 120(11): 54-6. W
What they didn’t teach us in Medical College — An Indian Perspective, Bhattacharya K, Bhattacharya S, (C), 120(12): 94-6.
Workplace Violence against Doctors : A Controversial and Contradictory Situation for India, (Commentary), Bansal P, Das A, 120(4): 67-9. Y
Yolk Sac Tumour in Postmenopausal Lady A Rare Case of, Maji S, Saha D (CR), 120(11): 57-8.
102
AUTHOR INDEX
A
A Bagchi, Bagchi AS: Hydatid Disease — An Overview, (RA), 120(8): 65-70.
Abraham JJ:See Agrawal BK
Abrol S: See Chrungoo I
Acharyya A, Ghosh K: NCD Risk Factors in Different Administrative Divisions of West Bengal: An Insight Analysis from National Family Health Survey-5 Report, (OA), 120(5):26-32.
Agrawal BK, Abraham JJ: Argatroban for the Management of Heparin induced thrombocytopenia in COVID-19 Cases, (C), 120(7):83.
Ahmed A: See Bhowmick S
Ahmed NJ: Gastrointestinal Adverse Events of Methotrexate : A Descriptive Study, (OA), 120(11):20-3.
Aishwary: See Saran RK
Aishwarya LP: See Sai SN
Ali Khan SLS: See Safwan M
Ali SI: See Begum J
Ali Sk H: See Chakrabarti A
Ambre SR: See Pandya J
Amirtham U: See Devi CA
Anand R: See Joseph J
Anand R: See Singh P
Anand S: See Desai A
Angirish B, Jankharia B: Quiz, (IM), 120(7):80.
Angirish B, Jankharia B: Quiz, (IM), 120(1:78.
Angirish B, Jankharia B: Quiz, (IM), 120(9):62.
Angirish B, Jankharia B: Imaging in Tuberculosis, (RA), 120(7):4550.
Angirish B, Jankharia B: Quiz, (IM), 120(10):76.
Angirish B, Jankharia B: Quiz, (IM), 120(12): 92.
Angirish B, Jankharia B: Quiz, (IM), 120(2):64.
Angirish B, Jankharia B: Quiz, (IM), 120(4):87.
Angirish B, Jankharia B: Quiz, (IM), 120(5):80.
Angirish B, Jankharia B: Quiz, (IM), 120(6):66
Angirish B, Jankharia B: Quiz, (IM), 120(8):75.
Angirish B, Jankharia B:Quiz, (IM), 120(1):52
Angirish B, Jankharia B:Quiz, (IM), 120(3):78.
Anitha TS: See Kaliaperumal R
Ansar M, Chatterjee A, Roy Chowdhury S : Growing Homophobia due to Monkeypox Outbreak in 2022, (C), 120(9):65.
Ansar M: See Chatterjee A
Anshu: See Singh T
Appendraj S: See Ramesh T.
Arora : See Kumar P.,
Arora D: See Kumar P
Arora Sachdeva R, Taneja J, Verma L, Sen MK, Chaudhary K, Swati A, Kumar A : The Rare Imitator : Pulmonary Nocardiosis Mimics Tuberculosis Reactivation, (CR), 120(12): 70-3.
Arora SK: See Wason R
Arulrhaj S: Patient Centered Health Care, (VE), 120(7):61-6.
Ayyar V: See Chawla R
Azam MUurRM: See Rathod KG
B
Bafna A: See Magarkar V
Bagchi AS: See Bagchi AS
Bagchi C, Majumder B, Pal J: Prescribing Cascade — What, When, How and the Ways to Mitigate, (RA),120(9):39-43.
Bairwa M: See Kant R
Bandagi RV: See Srinivasan AV
Bandyopadhyay A: see Pramanik S
Bandyopadhyay K: see DK Mukhopadhyay.
Bandyopadhyay M, Roy T: Corynebacterium falsenii Bacteremia Occurring in a Term Neonate Causing Late Onset Neonatal Sepsis, (CR), 120(1):46-7.
Bandyopadhyay S:See Mitra K
Bandyopadhyyay M: :See Gupta S
Banerjee P Das K
Banga V, Jain S: The Role of Haematological and Biochemical Parameters for Diagnosis and Management of Covid-19 Patients, (OA), 120( 4):23-7.
Bansal N: See Bhatia Shah S
Bansal P, Bansal R: Colchicine In COVID-19. (C),120(7):83-4.
Bansal P, Das A: Prevention Strategies to De-escalate Workplace Violence against Doctors…, (RA), 120(12): 61-3.
Bansal P, Das A : Workplace Violence against Doctors : A Controversial and Contradictory Situation for India, (Commentary), 120(4):67-9.
Bansal R:See Bansal P
Barik G: See Das AK
Barsode SS: See Borawake AG
Baruah MP, Bhuyan S, Borah AR, Saikia SK: Impact of COVID19 Pandemic on the Glycemic Status of a Large Cohort in Patients with Diabetes, (OA), 120(10):54-7.
Barui H: See Das A
Basu M: JIMA — December, 2021, (C), 120(4):90.
Basu M: JIMA, Vol 119, December, 2021,(C), 120(8):77.-8
Basu Roy S, Sarkar P, Basu Roy S, Dutta S: Cardiac Perforation by Permanent Pacemaker Lead, One Year after Implantation — An Unusual Occurrence and Its Management,(CR) 120(3):667.
Basu Roy S: See Das S
Basu Roy S: See Das S
Basu Roy S: See Sanki PK.
Basu Roy S: See Sanki PK.
Basu Roy S:see Basu Roy S
Bavishi MP: See Prabhu SR
Begum J, Ali SI, Lalitha DL, Panda M, Thalanjeri P: The Transition towards Virtual Teaching Learning Environment during COVID Pandemic : Medical Educator’s Perspective, (OA), 120(6):349.
Begum J: See Panigrahy S
Begum SA: See Saha D
Behera AR See Ghosh T.
Behera AR:see Panigrahy S
Bera PK: see Ghosh S.
Beyong T: See Kapoor M
Bhagat S:See Pebbili KK
Bhakat B, Chakraborty SK, Das S, Mallick SI: A Prospective Study to Evaluate the Possible Role of Cholecalciferol Supplementation on Autoimmunity in Hashimoto’s Thyroiditis, (OA), 120(7):21 -4.
Bhakat B, Karmakar A: Isolated Unilateral Third Cranial Nerve Palsy : A Rare Presentation of Dengue Fever, (CR), 120(2):523.
Bhakat B: See Chowdhury A
Bhakta A:See Gupta S
Bhanat R: See Thakkar S
Vol 120, No 12, December 2022Journal of the
Medical Association
Indian
103
Bharathi G, Bhavana K, Vishnudas TV, Kumar V, Bharti B, Srinivaasan A, Ouseph S, Pillai S, Sadhukhan K, Kumar , Kant S, Mandal A: Interpreting Mortality in COVID Associated Mucormycosis (CAM) : ALearning Experience from a Tertiary Care Centre, (OA), 120(11):29-36.
Bhardwaj R: See Chrungoo I
Bharti B: See Bharathi G
Bhatia M: See Bhatia Shah S
Bhatia Shah S, Chawla R, Pahade A, Bansal N , Mehta A , Dewan AK , Parkash A , Bhatia M: Immunity Status of Health Care Workers Post-recovery from COVID-19: Natural Adaptive Immunity Persists at Nine Months Post-infection : An Online Longitudinal Panel Survey, (OA), 120(12): 33-8.
Bhatt AN, Joseph MR: Insights into Conflicts and Harmony in Doctor Patient Relationship through Transactional Analysis, (RA), 120(8): 55-8.
Bhattacharjee MS: See Pal J
Bhattacharjee P: See Borah A
Bhattacharjee P:See Bhowmick R.
Bhattacharya A, Ghosh A: A Comparative Study of the biochemical components of Human Umbilical Cord Blood and Adult Peripheral Blood, (C),120(7):83.
Bhattacharya A, Ghosh A: Laboratory Work and Analysis of the Biochemical components of Human Umbilical Cord Blood and Adult peripheral blood. (C), 120(10):80-1.
Bhattacharya A: Ageing (C), 120(4):90.
Bhattacharya D: See Chatterjee N
Bhattacharya D:See De S
Bhattacharya K, Bhattacharya N: Ethical Issues in Surgery during COVID-19 Pandemic, (RA), 120(5):48-50.
Bhattacharya K, Bhattacharya N: COVID-19 Second Wave and Doctors Death, (RA), 120(1):39-40.
Bhattacharya K, Bhattacharya S: What they didn’t teach us in Medical College — An Indian Perspective, (C), 120(12): 94-6.
Bhattacharya N: s See Bhattacharya K, Bhattacharya N: See Bhattacharya K
Bhattacharya P: See Chatterjee S.
Bhattacharya P: See Mukherjee A
Bhattacharya S: See Bhattacharya K
Bhattacharyya A, Haldar T, Pal J : Two Cases of Secondary Hypertension with Rare Aetiology, (CR), 120(7):51-3.
Bhattacharyya A: PAID-IVF — A Quick Reminder for Care Givers of Geriatric Patients, (RA), 120(11): 50-3.
Bhattacharyya D: Chaudhuri A
Bhaumik DP: See Saha S
Bhavana K: See Bharathi G
Bhonde R: See Marathe A
Bhowmick R, Nath BK, Bhattacharjee P: A Study of Peripheral Arterial Disease in Type 2 Diabetes Mellitus with Relation to Ankle Brachial Pressure Index, (OA), 120(2):13-6.
Bhowmick S, Maitra S, Paul S, Ahmed A, Das A, Kundu T, Das N, Ray K, Purkayastha SK: An Observational Study Comparing the Adverse Effect Profiles of Sputnik V and Covaxin COVID-19 Vaccines in Adult General Population of Eastern India, (OA), 120(8): 40-4.
Bhowmick S:See Pawar S
Bhuyan S: See Baruah MP
Binukuttan PV: See Mammen AC
Biswas KD, Purohit D: Role of PPI and importance of anti-reflux agents in the treatment of NERD, (DC), 120(11): 69-71.
Biswas P: See Sil A
Biswas PK: See Mandal UK
Bodhankar S:See Dhok AP
Borah A, Nath BK, Bhattacharjee P: Comparative Study of Serum LDL And HDL In Alcoholics & Non-Alcoholics, (OA), 120(5):168.
Borah AR: See Baruah MP
Borawake AG, Dasgupta SS, Barsode SS, Shah N, Maindarkar A, Vangala UK, Girwalkar YA: Evaluation of Plasma Fibrinogen Levels and Its Association with Microalbuminuria and Glycemic Control in Type 2 Diabetes Mellitus, (OA),120(9):27-31.
Borkondaj B: See Sinha S.
Borse AG, Roy S, Mitra A, Roy T, Mitra KK: Cardiac Tamponade an Unusual Presentation of SLE — A Case Report, (CR), 120(1):41-2.
Bose A: See Koley S
Brahma S: See Mathur VN
Brahma S: See Srinivasan AV
Byadigere M, Harindranath HR, Iyer NS: The Effect of Diabetes Mellitus on the Postoperative Period in Breast Cancer Patients — A Three Years Retrospective Study, (OA),120(9):17-9.
C
Chakrabarti A, Roy Chowdhury S: The Road not taken : A Perspective of a Medical Professional’s Inability to Choose between Clinical Practice or Postgradu, (C), 120(1):54
Chakrabarti A, Ali Sk H, Ghosh S : Efficacy and Safety of Transdermal Buprenorphine Patch for Cancer Pain Relief in Elderly Patients : A Retrospective Study from a Tertiary Care Centre of Eastern India, (OA), 120(10):58-61.
Chakrabarti A: See Das S
Chakraborty A: See Chatterjee N
Chakraborty A: See Dutta SK
Chakraborty D: See Chaudhuri A
Chakraborty S: See Mandal A
Chakraborty S : See Chaudhuri A
Chakraborty SK: See Bhakat B
Chakraborty U: See Chatterjee A
Chakraborty U: See Sil A
Champaka G: See Devi CA
Chand A: See Philip AJ
Chandra A, Pal J, Das S, Das S: Thrombocytopenia in COVID-19: A Diagnostic and Therapeutic Challenge, (CR), 120(3):71-3.
Chandra A: See Chatterjee A Chandra A: See Sil A
Chandra Sekhar PB:see Panigrahy S
Chatterjee A, Ansar M, Chandra A, Sil A, Chakraborty U, Dasgupta S: Multisystem Inflammatory Syndrome in Adults : The New Mask on an Old Evil, (RA), 120(10):64-7.
Chatterjee A: See Ansar M Chatterjee C: See Sinha S.
Chatterjee N, Pal J, Khatua I, Pal P, Saha B, Bhattacharya D, Chakraborty A: A Hospital based Observational Study of Clinical spectrum and Outcome of Mucormycosis during the COVID Pandemic, (OA), 120(5):11-5.
Chatterjee N: See Mandal A Chatterjee P: See Jain P.
Chatterjee R, Samajdar SS, Mukherjee S, Pal J: Efficacy of Interventional Awareness Program on HIV/AIDS among High School Students of West Bengal, India, (RA), 120(2):42-6.
Chatterjee S, Datta S, Sarkar S, Ray MK: Study to Find Out the Correlation Between Cognitive Defect and Non-alcoholic Fatty liver Disease, (OA), 120(4):28-31.
Chatterjee S, Saha U, Pal S, Samanta S, Bhattacharya P, Pal S, Roy MK: Intracranial Calcification in a Case of Seizure Disorder, (CR), 120(1):50-1.
Chatterjee S : Double Compound Intussusception—A Clinicoradiological Correlation, (CR), 120(4):61.
Chatterjee S: See Datta R
Chatterjee S: See Saha U
Chaturvedi R: See Gaur PS
Vol 120, No 12, December 2022Journal of the Indian Medical Association
104
Chaudhary H: See Verma A
Chaudhary K: See Arora Sachdeva R
Chaudhary KD: See Saini VK
Chaudhuri A, Chakraborty D, Chakraborty S, Mitra PK: Are the COVID Warriors Confident about COVID Vaccine? A Survey among the Healthcare Workers of West Bengal to Explore their Perception about COVID19 Vaccine and causes of Vaccine Hesitancy, (OA), 120(2):23-6.
Chaudhuri A, Siddalingaiah HS, Santra R, Bhattacharyya D: Why MBBS Students are Taking to Substance Abuse ? — A Retrospective Study on the Pattern and Causes of Substance Abuse among the MBBS Students of West Bengal, (OA), 120(8): 28-33.
Chauhan P: See Jain P.
Chawla M: : See Chawla R
Chawla R, Ayyar V, Chawla M, Ayyagari U, Natarajan V, Sharma S, Gaurav K Expert opinion on novel fixed drug combination of metformin sustained release and vildagliptin immediate release for type 2 diabetes mellitus management in India, (DC), 120(12): 80-4.
Chawla R: See Bhatia Shah S
Chennamchetty VK:See Rao MVR
Chenniappan M: Become a Sherlock Holmes in ECG, (SC), 120(1):53
Chenniappan M: Become a Sherlock Holmes in ECG, (SC), 120(11):79.
Chenniappan M: Become a Sherlock Holmes in ECG, (SC), 120(12): 93.
Chenniappan M: Become a Sherlock Holmes in ECG, (SC), 120(2) :65.
Chenniappan M: Become a Sherlock Holmes in ECG, (SC), 120(3):79.
Chenniappan M: Become a Sherlock Holmes in ECG, (SC), 120( 4):88.
Chenniappan M: Become a Sherlock Holmes in ECG, (SC), 120(5):67
Chenniappan M: Become a Sherlock Holmes in ECG, (SC), 120(5):81.
Chenniappan M: Become a Sherlock Holmes in ECG, (SC), 120(7) :81.
Chenniappan M: Become a Sherlock Holmes in ECG, (SC), 120(8) :76.
Chenniappan M: Become a Sherlock Holmes in ECG, (SC), 120(9) :63.
Chidambaram R: See Das P
Choudhary PN: See Puri S
Chowdhury A, Bhakat B: Intestinal Behcet’s : A Rare Presentation of Behcet’s Disease, (CR), 120(10):68-70.
Chowdhury SK: Cardio Respiratory faliure cited as — The cause of death, is it a misnomer? (C), 120(11):81
Chrungoo I, Abrol S, Mahajan A, Bhardwaj R, Singh Bali H, Chrungoo RK: Gall Bladder Polyps : A Paradigm Shift – Need for Reappraisal of Guidelines, (OA), 120(6):13-8.
Chrungoo RK: See Chrungoo I
Chugh S: See Sharma V
Correia RC: See Patel RV
Dalui A: See Pawar S
Damor HN: See Nayak AJ
Dandekar M: See Vidyarthi A
D
Das A, Ghosh S, Roy Chowdhuri A, Sen P, Barui H, Goswami P: Correlation between C-reactive Protein (CRP) Level and Clinico-radiological Profile in COVID-19 Patients Admitted in a Tertiary Care Hospital in Eastern India, (OA), 120(10):31-3.
Das A: See Bansal P
Das A: See Bansal P
Das A: See Bhowmick S
Das AK, Patra A, Nandy M, Barik G, Ghosh J: Antimicrobial Sensitivity Pattern of Bacterial Isolates Associated with Urinary Tract Infection in a Tertiary Care Hospital, (OA),120(10):19-23.
Das BB: See Roy H
Das G:See Deka A
Das HN: See Saha Roy S
Das K, Gorai S, Banerjee P, Beard Folliculitis due to Klebsiella pneumonia, (C), 120(11):81-2.
Das N: See Bhowmick S
Das N: See Mukhida S
Das P, Kumar S, Chidambaram R: Association between Stress Depression Anxiety and Coping Styles among Indian University Students during COVID-19 Outbreak, (OA), 120(8): 50-4.
Das S, Basu Roy S, Basu Roy S : Comparison of Effect of Combined Intravenous Amiodarone and Surgical Closure of OS ASD in Adults with Surgical Closure alone on Sinus Conversion of Concomitant Atrial Fibrillation — A Retrospective Case Series Analysis, (OA), 120(6):40-3.
Das S, Chakrabarti A, Ghosh SK : Outcome of Concurrent Chemoradiation in Inoperable Muscle Invasive Urothelial Carcinoma of Urinary Bladder in terms of Locoregional Response and Toxicities — A Longitudinal Study in a Tertiary Care Hospital, (OA), 120(6):23-8.
Das S: Medical Certificate of the Cause of Death : Some tips for the Clinician, (VE) 120(3):74-6.
Das S: See Bhakat B
Das S: See Chandra A
Das S: See Chandra A
Das SK: see Pramanik S
Das VK: See Khan V
Dasgupta S: See Chatterjee A
Dasgupta SS: See Borawake AG
Dass M: See Rao MVR
Datta R, Chatterjee S : Amyand Hernia — An Uncommon Coexistence of Two Common Disease Entities, CR), 120(8): 73-4.
Datta S: See Chatterjee S
Dave D: See Nayak AJ
Dave VK: See Parekh D
De S, Sur D, Roy S, Bhattacharya D: Comparison of Analgesic Effects of Levobupivacaine (0.25%) versus Bupivacaine (0.25%) using Ultrasound Guided Transversus Abdominis Plane Block in Total Abdominal Hysterectomy under General Anesthesia — An Interventional Study, (OA), 120(2):37-41.
Deb S: See Saha S
Debnath E: See Jain P.
Debnath N: See Saha U
Debnath SK:See Deka A
Deka A, Das G, Debnath SK: A Study Comparing the Efficacy of Different Non-pharmacological Methods to Reduce Pain in Neonates Admitted in A Tertiary Care Hospital (OA),120(9):202.
Desai A, Anand S: Clinical Efficacy of Pancreatin Minimicrospheres Supplementation in Patients with Exocrine Pancreatic Insufficiency (EPI) : Real-world Evidence, (DC), 120(6):60-5.
Desai A: See Porwal K
Desai A: See Thacker HP
Desai A: See Gandhi AB.
Desai A: See Jah M
Desai H: See Thakkar S
Devi CA, Nargund A, Patil Okaly GV, Amirtham U, Patil AS, Champaka G, Suma MN, Kumar ARA: Childhood Histiocytic
Vol
No
December 2022Journal
120,
12,
of the Indian Medical Association
105
Vol 120, No 12, December 2022Journal of the Indian Medical Association
Disorders — A wolf in Sheep’s Clothing : Experience from a Cancer Institute in South India, (OA), 120(11):37-41
Devi J: See Saikia M
Dewan AK: See Bhatia Shah S
Dey AK: See Pramanik S
Dhar M: See Kalra S
Dhasmana M, Varma A : Comparative Efficacy of Hydrochlorthiazide and Chlorthalidone, used either lone or in Combination Therapy in Patients with Essential Hypertension in Tertiary Care Hospital of Uttrakhand, (OA), 120(2):27-31.
Dhok AP, Mitra KR, Nimje VV, Bodhankar S, Yadav TS : Spontaneous Nephrocutaneous Fistula in Xanthogranulomatous Pyelonephritis — A Rare Complication, (CR), 120(8): 71-2.
DK Mukhopadhyay, K Bandyopadhyay: Antenatal Care : Quality, Utilization and Influencing Factors, (Ed), 120(3):09-11.
DN Panchal: See Saini VK
Dogra N: See Nindra J
Dutta S: See Basu Roy S
Dutta SK, Paul G, Chakraborty A : Retinal Detachment in Primigravida with Antepartum Eclampsia : A Case Report, (CR), 120(5):51-2.
Dwivedi A, Sinha R, Ghosh S, Maity S, Jha H: Oral Manifestations of Chronic Renal Disease, (RA), 120(7):41-4.
E
Ete T: See Kapoor M
F
Fattahi MR: See Hashemi SMA
Francis R: See Joseph J G
Gaba S: See Sharma S
Galhotra A, Gupta M, Singh Lehl S, Galhotra A, Sood D, Gauba A: Evolution of Biomarkers for Frailty over the last Decade : A Literature Review, (RA), 120(8): 59-64.
Galhotra A: See Galhotra A
Gandhi AB, Desai A: Pharmacological basis of Evening Primrose Oil in Premenstrual Syndrome — An evidenced based approach, (DC), 120(7):75-9.
Ganganahalli PS, Singh CB: Factors Influencing Non-utilization of Antenatal Care Services from Government Sector among Rural Pregnant Women — A Hospital-based, Cross-sectional study in Vijayapura District of North Karnataka,(OA), 120(3):125.
Garg R :see Malhotra N
Gauba A: See Galhotra A
Gaur PS, Kant S,Tripathi A, Srivastava K, Chaturvedi R: All Gene Expression of Leukotriene A4 Hydroxylase (LTA4H ) Gene in Extra Pulmonary tuberculosis Patients and Healthy Control in North Indian Population, (OA), 120(8): 34-9.
Gaurav K: See Chawla R
Gayen R: See Saha Roy S
Geriatric Patients PAID-IVF — A Quick Reminder for Care Givers of Geriatric Patients, Bhattacharyya A, (RA), 120(11): 50-3.
Ghosh A: See Bhattacharya A
Ghosh A: See Bhattacharya A
Ghosh AK : Epilepsy can be Treated by Surgery — Needs Awareness, (C), 120(10):78-80.
Ghosh B: See Mandal A
Ghosh J: See Das AK
Ghosh K:See Acharyya A
Ghosh M: See Saha Roy S
Ghosh P: See Sur S
Ghosh S, Mony SP, Sen SS, Mahapatra U: Elderly Lupus Patient Presenting with Myositis — An Uncommon Presentation of a Common Disease, (CR),120(9): 49-50.
Ghosh S, Bera PK, Saha A, Sur TK: Comparative Analysis of Amoebic Liver Abscess versus Pyogenic Liver Abscess on Clinical and Investigative Consequences, (OA), 120(3):36-40.
Ghosh S, Mukhopadhyay P: Getting Published : The Inside Story, (Ed), 120(1):11-3.
Ghosh S: Congenital Hypothyroidism: Need for national health policy, (Ed), 120(12): 12-4.
Ghosh S: See Yadav PK
Ghosh S : See Chakrabarti A
Ghosh S: See Das A
Ghosh S: See Yasmin M
Ghosh S:See Dwivedi A
Ghosh SK: See Das S
Ghosh T, Jena S, Behera AR, Panigrahy S, Sethi RK: Microbial Profile of Neonatal Septicemia and its Antibiogram Prevalent in a Tertiary Care Hospital of Western Odisha, (OA), 120(8):1722.
Ghoshal AG: See Jindal SK
Girwalkar YA: See Borawake AG
Goel A: See Wason R
Gogoi S: See Jain P.
Gorai S: See Das K
Goswam RP: See Sur S
Goswami D:see Parida R
Goswami P: See Das A
Gowda VRK: See Srinivasan AV
Goyal N, Poswal L, Gupta D, Samar N, Parakh P, Raut M: Study of Admitted Patients of Mucormycosis : Experience of A Tertiary Care Centre, (OA), 120(7):25-9.
Goyal S: See Sharma V
Grover A: See Puri S
Gulati S: See MazumderMA
Gunjan:See Kumari S
Gupta A: See Magarkar V
Gupta AP: See Puri S
Gupta D:See Goyal N
Gupta M: See Galhotra A
Gupta M: See Sharma S
Gupta N:See Kunal P
Gupta P:See Spoorthy MS
Gupta S, Rawekar A, Bhakta A, Bandyopadhyyay M : Effectiveness of Self-directed Learning to Teach Biochemistry in Phase 1 MBBS Students, (OA), 120(7):33-5.
Gupta S, Rawekar A, Tajuddin MdQ: Preparedness of Phase 1 MBBS Students for Self-Directed Learning Process, (OA), 120(12): 44-7.
H
Hai AA: An Unusual Untoward Reaction to COVID-19 VaccineAZD 1222 (ChaAdOx1), (C), 120(9):66.
Haldar T: See Bhattacharyya A
Halder P: See Koley S
Hans JM: See Pawar S
Haridas M: See Safwan M
Harihar MT: Telemedicine, (VE), 120(4):70-7.
Harindranath HR: See Byadigere M
Harish S: See Kumar P
Harish S: See Kumar P.
Haroon NN: See Krishnamoorthy S
Hashemi SMA, Sanaei N, Fattahi MR, Hosseini SAM, Hosseini SY, Sarvari J : Investigation of Hepatitis B Virus X Gene Mutations in Patients with and without Cirrhosis/Hepatocellular Carcinoma, (OA),120(9):12-6.
106
Vol 120, No 12, December 2022Journal of the Indian Medical Association
Hassan Y, Rather AA: The Standard of Hand Written Operative Notes; A Long Campaign towards Refinement — A Complete Audit Loop Study in a Teaching Hospital, (OA), 120(11):16-9.
Hati A: See Sil A
Hatkar NK: See Rathod KG
Hemalatha G : See Ramesh T.
Hosseini SAM: See Hashemi SMA
Hosseini SY: See Hashemi SMA
I
Irshad: See Saran RK
Iyer NS: See Byadigere M
Iyer RB: See Mathur VN
Jadav V: See Mukhida S
J
Jah M, Desai A: A Pilot Observational Study of Topical Glucosamine and Chondroitin Sulfate in Patients with Knee Osteoarthritis, (DC), 120(11): 72-6.
Jain P, Chauhan P, Uppal V, Debnath E, Gogoi S, Chatterjee P: Quantification of Pre-analytical Quality Indicators in a Clinical Laboratory and Formulating the Lean Six Sigma DMAIC Strategy, (OA), 120(2):17-22.
Jain S: See Banga V
Jain S:See Pawar S
Jankharia B: See Angirish B
Jankharia B:See Angirish B
Jankharia B:See Angirish B
Jankharia B:See Angirish B
Jankharia B:See Angirish B
Jankharia B:See Angirish B.
Jankharia B:See Angirish B.
Jankharia B:See Angirish B.
Jankharia B:See Angirish B.
Jankharia B:See Angirish B.
Jankharia B:See Angirish B.
Jayakrishnan MP:See Tanu.
Jayalal JA: See Mehta KK.
Jayaraj KM:See Tanu.
Jayseela K: See Kumar P
Jayseela K: See Kumar P.
Jena S: See Ghosh T.
Jha H:See Dwivedi A
Jindal SK, Lele J, Ghoshal AG, Nair S, Kant S, Parakh A, Meena, Rekha, Nagda VD, Masurkar T, Joshi SK: Executive Summary of the Recommendations on the Management of Asthma in Primary Care (2022) – New Updates, (RA), 120(12): 57-60.
John B: See Mehta KK.
John JJ:See Pawar S
Joseph J, Anand R, Francis R: Multi Slice Spiral CT Pulmonary Angiography in Dynamic Pitch Mode using Volume Helical Shuttle Technology for the Diagnosis of Pulmonary Embolism, (OA), 120(5):19-25.
Joseph MR: See Bhatt AN
Joshi P: See Mehta KK.
Joshi SK: See Jindal SK
Joshi SR: See Saha D
Kabra R: See Thakkar S
Kagathara JD: See Saini VK
K
Kaliaperumal R, Krishnagopal S, Vinod Babu S, Raghavan SA, Vengatapathy K, Anitha TS: Association of Serum 8isoprostaglandin F2á Levels with Glycemic Control in Type 2
Diabetes Patients with Senile Cataract, (OA), 120(10):34-8.
Kalra S, Dhar M: Sarcopenia : Screening Made Simple, (Ed), 120(7):9-10.
Kannan L: See Srinivasan AV
Kant R, Roy S, Bairwa M: Glycated Haemoglobin : It’s Diagnostic and Prognostic Efficacy in Various Clinical Scenarios, (RA), 120(4):47-51.
Kant S, Royson A: Covid Management Strategy for Third Wave / Omicron Variant in India, (RA), 120(3):56-61.
Kant S: See Bharathi G
Kant S: See Gaur PS
Kant S: See Jindal SK
Kapoor M, Kumar A, Ete T, Pala S, Vanlalmalsawmdangliana, Megeji RD, Beyong T: Electrocardiographic Manifestations in COVID-19 Patients - An Observational Study from a Tertiary Care Centre in North Eastern India, (OA), 120(8):12-6.
Karim R:See Kumari S
Karmakar A: See Bhakat B
Karmakar S: See Mitra K
Khan V, Zala DB, Sanghai AA, Das VK: Typhoid Outbreak during the Pandemic of COVID-19 : A Report, (OA), 120(6):19-22.
Khari S: See Verma A
Khatua I: See Chatterjee N
Khemka S: See Vidyarthi A
Khetarpal S: See Pawar S
Kole AK: See Mandal UK
Koley S, Mukherjee M, Halder P, Bose A, Lahre D, Mukhopadhyay S, Mallik S: Clinico-microbiological Profile of Urinary Tract Infection with Special Reference to Uropathogenic E coli : Antibiotic susceptibility Pattern, Phylogenetic Background and Virulent Factor Distribution from West Bengal, India, (OA), 120(10):48-53.
Krishnagopal S: See Kaliaperumal R
Krishnamoorthy S, Pisharody KK, Menon G, Haroon NN, Venkatesan K: A study on Breakthrough Infections of COVID19 from an Urban Healthcare Centre in Kerala , (OA), 120(6):2933.
Krunal V, Solanki S, Warudkar S, Prajapati H, Sharma M: Assessment of Prescribing Practices in Overactive Bladder Pharmacotherapy across Different Specialties of India : A Prescription Trend Analysis, (DC), 120(12): 74-9.
Kumar A: See Arora Sachdeva R
Kumar A: See Kapoor M
Kumar ARA: See Devi CA
Kumar G: See Magarkar V
Kumar G: See Mathur VN
Kumar G: See Srinivasan AV
Kumar K: See Kunal P
Kumar MS: See Tanu.
Kumar P, Menezes R, Pinto V, Arora D, Jayseela K, Kumar S, Rajdeo D, Harish S, Vinda Z, Tapas D: Safety & Efficacy of a Fixed Dose Combination of Paracetamol (125 mg), Phenylephrine (2.5 mg) and Chlorpheniramine Maleate (1mg) [Flucold Drops] in the Treatment of Common Cold and Flu Syndrome in Children : Postmarketing Surveillance Study, (DC), 120(5):75-9.
Kumar P, Menezes R, Pinto V, Arora D, Jayseela K, Kumar S, Rajdeo D, Harish S, Vinda Z, Tapas D : A Prospective, Interventional, Multicentre, Post-marketing Clinical Study of a fixed-dose combination of Paracetamol (125 mg), Phenylephrine HCL (5 mg), Chlorpheniramine Maleate (1 mg) and Sodium Citrate (60 mg/5 mL) for the Treatment of Common Cold and Flu Syndrome in Children, (DC), 120(10):71-5.
Kumar S: See Das P
Kumar S: See Kumar P
107
Kumar S: See Kumar P.
Kumar V : See Bharathi G
Kumar V: See Bharathi G
Kumaran S: See Unnikrishnan AG
Kumari S, Gunjan, Singh S, Karim R: Comparative Study of Expected Date of Delivery on the basis of Last Menstrual Period and Ultrasonographic Evaluation in Pregnancy, (OA), 120(7):302.
Kumbhar D: See Pandya J
Kunal P, Kumar K, Gupta N: A Comparative Study of Common Bile Duct Drainage by T-tube and Choledochoduodenostomy in Cases of Common Bile Duct Stones, (OA), 120(7):36-40.
Kundu T: See Bhowmick S
Kurien JG: Percutaneous Ostium Secondum Atrial Septal Defect Device Closure in a Pregnant Patient with Transeosophageal Echocardiography Guidance under Total Intravenous Anaesthesia, (CR),120(9): 53-5.
Kushwah B, Patel S, Singh M: Perimortem Caesarean Section : A Guideline-based Management of Maternal Cardiac Arrest, (CR), 120(6):56-7.
L
Lahariya C: See Singh Bhadoria A
Lahoti RC: Tearful Homage : Late Justice Lahoti A Messiah for Medical Professionals in India, (Obituary), 120(4):97.
Lahre D: See Koley S
Lal P: Current Status of Postgraduate Medical Education in India : SomeThoughts, (VE), 120(2):60-3.
Lalitha DL: See Begum J
Lalla R: See Srinivasan AV
Lele J: See Jindal SK
Lele J: See Mehta KK.
Lingappa L: See Srinivasan AV
M
Mada P, Shyamala R, Parmar P, Yadukul S, Reddy Pannala D: Implementation of Competency-based Medical Education in Forensic Medicine and Toxicology in Indian Medical Education — A Viewpoint on Challenges and Way Forward, (RA), 120(11): 46-9.
Madhusudhan BK: See Srinivasan AV
Magarkar V, Bafna A , Gupta A, Motiramani N, Sharma S , Kumar G : Positioning of the fixed dose combination of Rosuvastatin + Clopidogrel + Aspirin in the Treatment of Cardiovascular Diseases, (DC), 120(11): 63-8.
Mahajan A: See Chrungoo I
Mahanta P: See Verma A
Mahapatra U: See Ghosh S
Maindarkar A: See Borawake AG
Maitra S: See Bhowmick S
Maity A: See Mukherjee A
Maity S: See Dwivedi A
Maji S, Saha D: A Rare Case of Yolk Sac Tumour in Postmenopausal Lady, (CR), 120(11): 57-8.
Majumder A, Roy Chaudhuri S: Screening for Peripheral Artery Disease : Putting Prevention into Practice, (Ed), 120(2):11-2.
Majumder B: See Bagchi C
Malhotra J: See Malhotra N
Malhotra N, Malhotra N, Garg R, Malhotra J : COVID and Women’s Health in India, (OA), 120(3):48-52.
Malhotra N: See Malhotra N
Mallick SI: See Bhakat B
Mallik S: See Koley S
Mallik S: See Sur S
Mammen AC, Binukuttan PV, Varghese RG, Sasidharan S : p.ARG142Ter Variant Causing Ift52 Gene Mutation Resulting in Asphyxiating Thoracic Dystrophy (Juene Syndrome) — A Rare Case Report, (CR),120(9): 51-2.
Mandal A, Chakraborty S, Ghosh B, Chatterjee N: Mortality of Elderly Patients Supported by Mechanical Ventilation at a General Critical Care Unit in a Tertiary Care Centre, (OA), 120(11): 42-5.
Mandal A: See Bharathi G
Mandal PK: See Pramanik S
Mandal S: See Mandal UK
Mandal T: Russian invasion of Ukraine and it’s effect on Public Health, (C), 120(3):81
Mandal UK, Biswas PK, Mandal S, Kole AK : A Study on Prevalence, Clinical Features and Organ Damage in Systemic Lupus Erythematosus (SLE) with Special Reference to Metabolic Profile, (OA), 120(4):19-22.
Masariya BKD: See Prabhu SR
Masurkar T: See Jindal SK
Mathai D: See Rao MVR
Mathur G: See Sharma V
Mathur VN, Momin M, Iyer RB, Kumar G, Brahma S : Brivaracetam Intravenous Formulation in Epilepsy Management in India : A Position Statement, , (DC), 120(4):79-81.
Mazumder MA, Gulati S, Sengar A: Telemedicine in Paediatric Subspecialty : A Low Cost Model for Developing Countries during the COVID-19 Pandemic, (OA), 120(7):11-5.
Meena: See Jindal SK
Megeji RD: See Kapoor M
Mehta A: See Bhatia Shah S
Mehta KK, Jayalal JA, Lele J, Joshi P, Rekha S, Vora A, John B: A Stepwise Guide for Differential Diagnosis and Management of Acute Fever in Primary Care : An Indian Perspective, (Fever Guidelines), 120( 4):91-6.
Mehta V: See Patel S
Menezes R: See Kumar P
Menon G: See Krishnamoorthy S
Mirdha K: See Saran RK
Misra AK: See Sur S
Mitra A: See Borse AG.
Mitra K, Bandyopadhyay S, Mukhopadhyay S, Karmakar S: A Study to Estimate the Magnitude of Dry Eye Disease among Adolescent Population using Visual Display Terminals in Lockdown Period — A Crosssectional Observational Hospital Based Study, (OA), 120(2):32-6.
Mitra KK: See Borse AG.
Mitra KR: See Dhok AP
Mitra PK: See Chaudhuri A
MK Srivastava: See Singh S
Modi MY: See Patni BB
Mohapatra SK, Dha SP: Modified Trendelenburg Procedure for Varicose Vein, (RA), 120(11): 54-6.
Momin M: See Mathur VN
Mondal S: See Som Sengupta R
Mony SP: See Ghosh S
Motiramani N: See Magarkar V
Moulick A :see Mukherjee S
Mugundhan K: See Muralidharan K
Mugundhan K:see Sivaroja Y
Mugundhan K:See Tanu.
Mukherjee A, Bhattacharya P, Sarkar S, Maity A, Roy MK Pal SK: A Clinical Correlation of EEG Changes in Relation to Ischaemic Stroke on its Prognosis as per Location, (OA), 120(12):20-2.
Mukherjee M: See Koley S
Mukherjee R: See Sangha R
Vol 120, No 12, December 2022Journal
of the Indian Medical Association
108
Vol 120, No 12, December 2022Journal of the Indian Medical Association
Mukherjee S, Ray S, Moulick A, Sherpa PL : Pulmonary Hypertension in Hemoglobinopathies : A Neglected Entity, (OA), 120(3):24-8.
Mukherjee S: See Saha D
Mukherjee S: See Virmani AK
Mukherjee S: See Chatterjee R
Mukherjee S: See Sinha S.
Mukhida S, Vyawahare C, Das N, Jadav V: National Doctors’ Day-2022 Theme : Is It Appreciating for Past or Preparing for the Future? (C), 120(10):78.
Mukhopadhyay K: See Som Sengupta R
Mukhopadhyay K: See Sinha S.
Mukhopadhyay P: See Ghosh S
Mukhopadhyay S: See Koley S
Mukhopadhyay S: See Mitra K
Munshi R: See Pandya J
Muralidharan K, Mugundhan K, Pal J: CNS Tuberculosis, (RA), 120(6):47-52.
Murugesan M, Ramamurthy S: Monkeypox as a global health emergency — A threat after COVID-19 pandemic, (C), 120(11):80.
N
Nagda VD: See Jindal SK
Nair S: See Jindal SK
Nanda M: See Tiwari S
Nandy M: See Das AK
Nargund A: See Devi CA
Natarajan V: See Chawla R
Nath A: A Study of Malaria in Odisha State, (RA), 120(10):62-3.
Nath A: The Use of Aspirin in Patients Suffering from COVID-19 Disease, (SCom), 120(5):58.
Nath BK: See Borah A
Nath BK: See Bhowmick R.
Nayak AJ, Damor HN, Dave DS, Tank PM, Patel DV: Paediatric Femur Fractures Treated by Ender’s Nail — A Prospective Study of 15 Cases, (OA),120(9):23-6.
Nayak SR: See Yeola (Pate) M
Nimje VV: See Dhok AP
Nindra J, Prabhakar M, Singh Sidhu M, Dogra N: An update on Oral Manifestations of COVID-19 : a Narrative Review, (RA), 120(2) :47-51.
Ouseph S: See Bharathi G
Pahade A: See Bhatia Shah S
O
P
Pal J, Bhattacharjee MS : Challenges in Diagnosis of Extrapulmonary Tuberculosis, (RA), 120(4):56-60.
Pal J: See Bagchi C
Pal J: See Chatterjee N
Pal J: See Muralidharan K
Pal J: See Roy S
Pal J: See Saha D
Pal J: See Virmani AK
Pal J:See Bhattacharyya A
Pal J:see Chandra A
Pal J:See Chatterjee R
Pal P: See Chatterjee N
Pal S: See Chatterjee S.
Pal S: See Chatterjee S.
Pal S: See Saha Roy S
Pal S: See Saha U
Pal SK: See Mukherjee A
Pal SK: See Saha U
Pala S: See Kapoor M
Panchal D:see Saini VK
Panda M: See Begum J
Pandya J, Munshi R, Ambre SR, Kumbhar D : COVID-19 Infection Rate following COVID-19 Vaccination among Healthcare Professionals at a Tertiary Care Public hospital in City of Mumbai, (RA),120(9):34-8.
Panigrahy S See Ghosh T.
Panigrahy S, Behera AR, Reddy Basava SP, Samatha P, Begum J, Chandra Sekhar PB, Tripathy S : Study on Bacteriological Profile and Antibiotic Susceptibility Pattern of Clinical Isolates Obtained from Covid-19 Patients with Secondary Infection, (OA), 120(3):29-32.
Parakh A: See Jindal SK
Parakh P: See Goyal N
Parekh D, Shah TG, Dave VK: Evaluating Contraceptive Use among Women in Gujarat, India, (C), 120(8):77.
Parida R, Roy Chowdhury S, Goswami D, Subramaniam R:Can a Neonate Shiver ? — A perioperative.Diagnostic Dilemma and a Short literature Review, (CR), 120(3):68-70.
Parkash A: See Bhatia Shah S
Parmar H: See Patel S
Parmar P: See Mada P
Patel DV: See Nayak AJ
Patel RV, Correia RC : Laparoscopic repair of a symptomatic direct inguinal hernia in an apparently healthy boy, (C), 120(11) :80-1
Patel S, Mehta V, Parmar H, Shah A : Study of Neurodevelopmental Outcome of Preterm Babies Using Risk Stratification Score at a Tertiary Care Hospital, (OA), 120(5):3942.
Patel S: See Kushwah B
Pathak VK: See Singh Bhadoria A
Patil A: See Udgiri RS
Patil AS: See Devi CA , Patil Okaly GV: See Devi CA
Patni BB, Purohit AP, Modi MY, Prajapati VB: Correlation of Red Blood Cell Indices and RBC Histogram with Peripheral Blood Smear Findings in Anemia, (OA), 120(1):17-21.
Patra A: See Das AK
Paul R: Medicine in Art, (MH),120(7):82.
Paul B,Yasmin M: Prevention and Care of Non-communicable Diseases among Youth : Call for Action, (Ed), 120(4):11-3.
Paul G: See Dutta SK
Paul R, Som K: New Symptoms of COVID in the 3rd wave : Some Observations from Eastern India, (C), 120(6):68.
Paul R: A man with back pain, (PCME), 120(11): 77.
Paul R: A Man with Rash, (PCNE), 120(12): 91.
Paul R: COVID-19 Infection and Myocardial Infarction: Report of Two Cases from Eastern India, (C), 120(8):70 &78.
Paul R: How was the MBBS Examination during British Times? (MH), 120(10):77.
Paul R: Jivaka : The Legendary Physician of Ancient India, (MH), 120(2):66.
Paul R: John Keats : The Doctor and the Poet, (MH), 120(9):64.
Paul R: PET-CT Scan Appearance in Aortoarteritis, (PCME) 120(3):77.
Paul R: Those white Spots in the Brain, (PCME), 120(5):62.
Paul R: Ancient Indian Medical Teaching, (MH), 120(4):89.
Paul S: See Bhowmick S
Pawar S, Bhowmick S , John JJ , Khetarpal S , Hans JM , Dalui A, Jain S: Consensus Statement : The Need for Tobacco Harm Reduction in India, (DC), 120(12): 85-90.
Pebbili KK, Pendurthi B, Bhagat S : A Prospective, Crosssectional, Multicenter, Observational, Questionnaire-based
109
Vol 120, No 12, December 2022Journal of the Indian Medical Association
Survey to assess the Knowledge, Awareness, Attitude and Practice of Physicians while Prescribing Proton Pump Inhibitor (PPI) Drugs for Acid Peptic Disease, (DC), 120(7):67-74.
Pendurthi B: See Pebbili KK
Philip AJ, Chand A, Ramdas A, Punnooran JJ: A Rare Case of Peripheral Cysticercosis in a Young Female from South India, (CR), 120(4):62-3.
Pillai S: See Bharathi G
Pillai SM: See Tanu.
Pinto V: See Kumar P
Pinto V: See Kumar P.
Pisharody KK:See Krishnamoorthy S
Porwal K, Desai A: Exploring Multi-dimensional Approach for Treating and Preventing Hair Loss with Nutraceuticals. (DC),120(9): 56-61.
Poswal L: See Goyal N
Prabhakar M: See Nindra J
Prabhu SR, Bavishi MP, Masariya BKD, Steward EN : Management of Giant Mandibular Ameloblastoma — A Case Report, (CR), 120(6):53-5.
Prajapati AC : See Saini VK
Prajapati AC:see Saini VK
Prajapati H: See Krunal V
Prajapati VB: See Patni BB
Pramanik S, Mandal PK, Bandyopadhyay A, Das SK, Dey AK: In Hospital Mortality in Patients with Impaired Fasting Glucose and Acute Myocardial Infarction in a Tertiary Care Centre of Rural Bengal, (OA), 120(3):16-8.
Prasath C: See Ramesh T.
PS, Singh CB, (OA), 120(3):12-5.
Punnooran JJ: See Philip AJ
Puri S, Grover A, Choudhary PN, Gupta AP: Amitraz Poisoning: A Case Report of an Unusual Pesticide Poisoning. (C), 120(5):82.
Purkayastha SK: See Bhowmick S
Purohit AP: See Patni BB
Purohit D: See Biswas KD
R
Raghavan SA: See Kaliaperumal R
Rahman M: See Sur S
Rajasekar R, Sankar MG: Artificial Intelligence in Medicine Avatar — A Promise for Healthcare, (SA), 120(5):63-6.
Rajdeo D: See Kumar P
Rajdeo D: See Kumar P
Ram R: See Sai SN
Ramamurthy S :See Murugesan M
Ramanathan T: See Ramesh T.
Ramdas A: See Philip AJ
Ramesh T, Ramanathan T, Hemalatha G, Appendraj S, Prasath C, Sakthidasan S: Correlation between Laboratory Findings and Clinical Severity among the COVID-19 Patients in the Tertiary Care Centre, (OA),120(10):24-30.
Ranjan K: See Vidyarthi A
Rao MVR, Mathai D, Chennamchetty VK, Reddy VR, Dass M: Strike Omicron before you Captures It ! (Spl C), 120(7):56-60.
Rao SP, Vijayaraghavalu S: Online Classes Design and Delivery Based on Student Responses, (OA), 120(12): 48-56.
Raol K: See Thakkar S
Rather AA: See Hassan Y
Rathod KG, Azam MUurRM, Suroshe BB, Hatkar NK: Sociology of Child Health Care Practices in Nanded District of Maharashtra, Central India — A Single Centre Hospital-based Cross-sectional Study, (OA), 120(10):44-7.
Raut A, Raut R: A More Hygienic Method for Measuring Blood Pressur, (Spl C), 120(2):57-8.
Raut M: See Goyal N
Raut R: See Raut A
Ravikeerthy M, Samajdar SS: A Single Centre Experience of Spontaneous Bacterial Peritonitis in Ascites with Cirrhosis : A Record Based Observational Study, (OA), 120(12): 30-2.
Rawekar A: See Gupta S
Rawekar A: See Gupta S
Ray K: See Bhowmick S
Ray MK: See Chatterjee S
Ray S: See Mukherjee S
Ray Y: Perspectives of COVID-19 — Epidemiology, Prevention, Surgery and Medical Education, (Ed), 120(5):09-10.
Reddy Basava SP:see Panigrahy S
Reddy Pannala D: See Mada P
Reddy VR: See Rao MVR
Rekha S: See Mehta KK.
Rekha: See Jindal SK
Roy Chaudhuri S: See Majumder A
Roy Chowdhuri A: See Das A
Roy Chowdhury S: See Ansar M
Roy Chowdhury S: See Chakrabarti A
Roy Chowdhury S:see Parida R
Roy D : Kala azar — Aneglected Notifiable Disease, (Spl C), 120( 4):78
Roy H, Das BB: JIMA — September, 2021, (C), 120(3):81
Roy MK: See Chatterjee S.
Roy MK: See Mukherjee A
Roy S, Sekhar S, Pal J : Comparative Study of Outcome of Treatment of Fracture Shaft of Femur by Open Intramedullary Kuntscher’s Nail and Closed Intramedullary Interlocking Nail, (RA),120(9): 44-8.
Roy S: See Borse AG.
Roy S: See Kant R
Roy S: See De S
Roy T: See Bandyopadhyay M
Roy T: See Borse AG.
Royson A:see Kant S
Sadhukhan K: See Bharathi G
Safwan M, Haridas M, Ali Khan SLS : Acute Compartment Syndrome of the Forearm and Hand due to Extravasation of Computed Tomography Contrast Material, (CR), 120(11): 5962.
Saha A: see Ghosh S.
Saha B: Dengue : How do we manage, (Ed),120(10):13-4.
Saha B: See Chatterjee N
Saha BK, Sharma R: Mixed Germ Cell Ovarian Tumour in an 8year-old Child — A Case Report, (CR), 120(12): 67—9.
Saha BK, Vijayvargiya M: Primary Leiomyosarcoma of Liver — Case Report of a Rare Cancer, (CR), 120(4):64-6.
Saha D, Samajdar SS, Begum SA, Mukherjee S, Tripathi SK, Pal J, Joshi SR: Anticholinergic Burden in Geriatric Patients Attending Clinical Pharmacology Clinic — A Descriptive Crosssectional Study in Eastern India, (OA), 120(10):39-43.
Saha D: See Maji S
Saha Roy S, Pal S, Saha S, Gayen R, Ghosh M, Sengupta S, Das HN: Serum Ferritin as a Marker of Psychiatric Disorders, (OA), 120(8): 45-9.
Saha S, Bhaumik DP , Deb S: Clinico-demographic Profile and Outcome of Scrub Typhus in North Eastern State of India, (OA), 120(12): 39-43.
Saha S: See Saha Roy S
Saha U, Chatterjee S, Pal S, Debnath N, Pal SK: An Uncommon Presentation of a Common Etiology : Tubercular Cerebral Abscess in Pulmonary TB, (CR), 120(12): 64-6.
Saha U: See Chatterjee S.
110
Sai SN, Sangeetha LB, Aishwarya LP, Ram R, Siva KV : Knowledge of Chronic Kidney Disease among MD Medicine Postgraduates and Residents (OA), 120(11):24-8.
Saikia M, Devi J : Prevalence of Malignancy and Incidental Carcinoma in Routine Histopathology of Gall Bladder after Cholecystectomy for Gall Stones in the Age Group 30-60 Years, (OA), 120(7):16-20.
Saikia SK: See Baruah MP
Saini VK, DN Panchal, Prajapati AC, Chaudhary KD ; A Retrospective Study to find out Factors Affecting Maternal Mortality in a Tertiary Care Hospital in Ahmedabad City, Gujarat, (OA), 120(8): 23-7.
Saini VK, Panchal D, Kagathara JD, Prajapati AC: Proportion of Consanguineous Marriages in Community and Factors Affecting Pregnancy Outcome : A Hospital based Study in Ahmedabad City, Gujarat, (OA), 120(3):33-5.
Sakthidasan S : See Ramesh T.
Sakthivelayutham S: See Tanu.
Samajdar SS: See Ravikeerthy M
Samajdar SS: See Saha D
Samajdar SS: See Virmani AK
Samajdar SS:See Chatterjee R
Samanta S: See Chatterjee S.
Samar N: See Goyal N
Samatha P: See Panigrahy S
Sanaei N: See Hashemi SMA
Sangeetha LB: See Sai SN
Sangha R, Mukherjee R: Jejunal GIST — An Obscure Cause of Melaena, (CR), 120(1):43-5.
Sanghai AA: See Khan V
Sankar MG: See Rajasekar R
Sanki PK, Basu Roy S, Basu Roy S: Repair of Atrial Septal Defect Using Pedicled Right Atrial Wall Flap — A Retrospective Observational Study of a Novel Surgical Technique in a Tertiary Care Hospital in Eastern India, (OA), 120(1):14-6.
Santra R: Chaudhuri A
Sanyal D: Diabetes in India at 75 : Crossroads with History and Future, (Ed), 120(8):9-11.
Saran RK. Mirdha, Sanya Saran, Irshad, Aishwary: Benign Retrovesical Pelvic Mass in Men : Diagnostic and Management Dilemma, (OA), 120(12): 23-9.
Saran S: See Saran RK
Saravanan RV, :See Tanu.
Sarkar P: See Basu Roy S
Sarkar S: Overview of END TB Programme, (RA),120(3):62-5.
Sarkar S: See Chatterjee S
Sarkar S : See Mukherjee A
Sarvari J: See Hashemi SMA
Sasidharan S: See Mammen AC
Sathish KM: See Sivaroja Y
Sekhar S: See Roy S
Sen MK: See Arora Sachdeva R
Sen P: See Das A
Sen SS: See Ghosh S
Sengar A: See MazumderMA
Sengupta S: See Saha Roy S
Sengupta U: See Som Sengupta R
Sethi RK See Ghosh T.
Shah A: See Patel S
Shah N: See Borawake AG
Shah S: See Srinivasan AV
Shah TG: See Parekh D
Sharma K: See Sharma V
Sharma K: See Thakkar S
Sharma M: See Krunal V
Sharma R: See Sharma V
Sharma R:See Saha BK
Sharma S, Gupta M, Singla N, Singh Lehl S, Gaba S: Seasonal, Regional and Demographic Trends in Patients with Acute Undifferentiated Fever in Northern India, (OA), 120(5):33-8.
Sharma S: See Chawla R
Sharma S: See Magarkar V
Sharma V, Sharma R, Tiwari T, Goyal S, Sharma K,Chugh S, Mathur G: Recent Cyclones Causing an Increased Incidence of Intracranial Haemorrhage in India — A Cross-sectional Study,(OA),120(10):15-8.
Sherpa PL : See Mukherjee S
Shyamala R: See Mada P
Siddalingaiah HS: Chaudhuri A
Sil A, Biswas P, Chandra A, Chakraborty U, Hati A: Impact of COVID-19 on Postgraduate Residency Curriculum of Internal Medicine and Allied Specialities : Outcomes from A Web-based Cross-sectional Study from India, (OA), 120(1):26-31.
Sil A: See Chatterjee A
Singh AK: See Yeola (Pate) M
Singh Bali H: See Chrungoo I
Singh Bhadoria A, Pathak VK, Lahariya C: Non-alcoholic Fatty Liver Disease (NAFLD) in India : Challenges and the Ways Forward, (RA), 120(4): 52-5.
Singh CB: See Ganganahalli PS
Singh J: See Verma A
Singh Lehl S: See Galhotra A
Singh Lehl S: See Sharma S
Singh M: See Kushwah B
Singh N: See Yeola (Pate) M
Singh P, Anand R: Association Dietary Protein on Level of Anti Mullerian Hormone (AMH) and Antral Follicle Count (AFC) in Patients of Infertility, (OA), 120(12): 15-9.
Singh S, Srivastava MK: Dengue — What is Essential to Know, (C), 120(6):68-9, Singh S, MK Srivastava: COVID SECOND WAVE — The Guiding Principles, (C) 120(2):68-9.
Singh S: See Kumari S
Singh Sidhu M: See Nindra J
Singh T, Anshu : Princples of Assessment in Medical, (Book Review) 120(2):67.
Singla N: See Sharma S Sinha R: See Dwivedi A
Sinha S, Mukhopadhyay K, Som Sengupta R, Mukherjee S, Chatterjee C, Borkondaj B : An Observational Study on Pharmacoeconomics and Prescription Pattern of Drugs Used in Diabetes Mellitus (Type II) in a Tertiary Care Hospital of Eastern India, (OA), 120(3):41-7.
Sirohi TR: See Verma A
Siva KV: See Sai SN
Sivaroja Y, Sowmini PR, Sathish KM, Mugundhan K: Bladder Innervation and Types of Neurogenic Bladder, (RA), 120(3):535.
Solanki S: See Krunal V
Som K: See Paul R
Som Sengupta R, Mondal S, Mukhopadhyay K, Sengupta U: A Comparative Study of Clinical Presentation of Scrub Typhus Patients between Pre and Post Monsoon Clusters in a Tertiary Care Hospital in Kolkata, (OA), 120(4):40-6.
Som Sengupta R: See Sinha S.
Sood D : See Galhotra A
Sorganvi V: See Udgiri RS
Sowmini PR: See Sivaroja Y Sowmini PR: See Tanu.
Vol 120, No 12, December 2022Journal of the Indian Medical Association
111
Spoorthy MS, Gupta P: Disulfiram Induced Mania — A Case Report, (Spl C), 120(5):59-61.
Srinivaasan A: See Bharathi G
Srinivasan AV, Kannan L, Gowda VRK, Lingappa L, Utage P, Shah S, Madhusudhan BK, Lalla R, Kumar G, Bandagi RV, Brahma S: Placement of Oral Formulations of Brivaracetam in Various Patient Profiles : An Indian Perspective, (DC), 120(4):826.
Srivastava K: See Gaur PS
Srivastava MK: See Singh S
Steward EN: See Prabhu SR
Subramaniam R: See Parida R
Suma MN: See Devi CA
Sur D: See De S
Sur S, Mallik S, Misra AK, Rahman M, Ghosh P, Goswam RP: Prevalence of Common Infections and Flare-ups in on-treatment SLE Patients Attending Two tertiary Care Hospitals in Kolkata, (OA), 120(1):22-5.
Sur TK: See Ghosh S.
Suroshe BB: See Rathod KG
Swati A: See Arora Sachdeva R T
Tajuddin MdQ: See Gupta S
Taneja J: See Arora Sachdeva R
Tank PM: See Nayak AJ
Tanu, Pillai SM, Jayakrishnan MP, Sowmini PR, Kumar MS, Jayaraj KM, Sakthivelayutham S, Saravanan RV, Mugundhan K: Generalised Myoclonus and Cerebellar Ataxia Associated with Covid-19 : A Case Report, : (CR), 120(1):48-9.
Tapas D: A: See Kumar P.
Tapas D: See Kumar P
Thacker HP, Desai A: Long COVID : New Treatment Perspective Using Nutraceuticals, (DC), 120(5):67-74.
Thakkar S, Desai H, Raol K, Kabra R, Sharma K, Bhanat R: A Study of Changes in Refractive Status Pre and Post Pterygium Surgery among Patients of Tertiary Care Hospital of Ahmedabad City, (OA), 120(6):44-6.
Thalanjeri P: See Begum J
Tiwari S, Nanda M: Stenotrophomonas Maltophila : A Rare cause of Bacteremia in a Patient of Viral Encephalitis, (CR), 120(2):546.
Tiwari T: See Sharma V
Tripathi A: See Gaur PS
Tripathi SK : Pandemics — The Current and the Future, (VE), 120(6):58-9.
Tripathi SK: See Saha D ,
Tripathy S:see Panigrahy S
U
Udgiri R: JIMA September 2021, (C), 120(11):81
Udgiri RS, Patil A, Sorganvi V: Screening for Non-communicable Diseases and Health Education for Lifestyle Modification in Wellness Clinic at a Tertiary Care Hospital, (OA), 120(4):14-8.
Unnikrishnan AG, Kumaran S: Digital Diabetology in Daily Practice, (Ed), 120(6):09-12.
Uppal V: See Jain P.
Utage P: See Srinivasan AV
V
Vangala UK: See Borawake AG
Vanlalmalsawmdangliana : See Kapoor M
Varghese RG: See Mammen AC
Varma A: See Dhasmana M
Vengatapathy K: See Kaliaperumal R
Venkataramu V : See Vidyarthi A
Venkatesan K : See Krishnamoorthy S
Verma A, Mahanta P, Khari S, Singh J, Chaudhary H, Sirohi TR : Rare Possible Complications : Pneumothorax and Subcutaneous Emphysema In Covid-19 Patients, (CR), 120(5):53-5.
Verma L: See Arora Sachdeva R
Vidyarthi A, Venkataramu V, Ranjan K, Khemka S, Dandekar M: A Retrospective Analysis of Disease-free Survival of 2332 Cases of Cancer of the Oral Tongue from a Single Institute in Eastern India from 1998-2017, (OA), 120(3):19-23.
Vijayaraghavalu S : See Rao SP
Vijayvargiya M: See Saha BK
Vinda Z: See Kumar P
Vinda Z: See Kumar P.
Vinod Babu S: See Kaliaperumal R
Virmani AK: Physical Activity — Addressing Effectively a Neglected Issue, (RA),120(9):32-3.
Virmani AK, Pal J, Samajdar SS, Mukherjee S: Stress Levels among Indian Doctors – An Online Survey, (OA), 120(4):38-9.
Vishnudas TV: See Bharathi G
Viswanathan M: Type 2 Diabetes : One Disease or of Many Subtypes? (Ed),120(9):09-11.
Vora A: Clinical Spectrum of Tuberculosis, (RA), 120(5):43-7.
Vora A: See Mehta KK.
Vyas B, Marathe A, Vyas R, Bhonde R : Vast Potential for Clinical Trial Opportunities; Adipose Tissue Derived Mesenchymal Stem Cells, (OA), 120(4):32-7.
Vyas R: See Marathe A
Vyawahare C: See Mukhida S
W
Wankhedar R : Pledging Service to Humanity........, (Spl C), 120(2):59.
Warudkar S: See Krunal V
Wason R, Arora SK, Goel A: Lessons from the Pandemic and Healthcare service Delivery for the Senior Citizens, (RA), 120(1):32-8.
Y
Yadav PK, Ghosh S: Hypokalemic Rhabdomyolysis — A Rare Presentation, (CR), 120(7):54-5.
Yadav TS:See Dhok AP
Yadukul S: See Mada P
Yasmin M, Ghosh S: Ethics in Publication, (Ed), 120(11):13-5.
Yasmin M: See Paul B
Yeola (Pate) M, Nayak SR, Singh N, Singh AK: Iatrogenic Isolated Ruptured Dorsalis Pedis Artery Pseudo Aneurysm : A Rare Case Report, (CR), 120(5):56-7.
Z
Zala DB: See Khan V
Vol 120, No 12, December 2022Journal of the Indian Medical Association 112